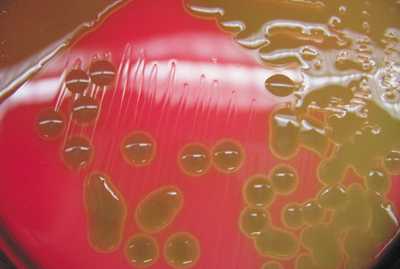

ΠΏΡΠΈΡΠΈΠ½Ρ, ΡΠΈΠΌΠΏΡΠΎΠΌΡ, Π΄ΠΈΠ°Π³Π½ΠΎΡΡΠΈΠΊΠ° ΠΈ Π»Π΅ΡΠ΅Π½ΠΈΠ΅
Π ΠΎΠΆΠ° (ΡΠΎΠΆΠΈΡΡΠΎΠ΅ Π²ΠΎΡΠΏΠ°Π»Π΅Π½ΠΈΠ΅) ΠΏΡΠ΅Π΄ΡΡΠ°Π²Π»ΡΠ΅Ρ ΡΠΎΠ±ΠΎΠΉ ΠΈΠ½ΡΠ΅ΠΊΡΠΈΠΎΠ½Π½ΠΎΠ΅ Π·Π°Π±ΠΎΠ»Π΅Π²Π°Π½ΠΈΠ΅, Π²ΡΠ·ΡΠ²Π°Π΅ΠΌΠΎΠ΅ ΡΡΡΠ΅ΠΏΡΠΎΠΊΠΎΠΊΠΊΠΎΠΌ Π³ΡΡΠΏΠΏΡ Π, ΠΏΡΠ΅ΠΈΠΌΡΡΠ΅ΡΡΠ²Π΅Π½Π½ΠΎ ΠΏΠΎΡΠ°ΠΆΠ°ΡΡΠ΅Π΅ ΠΊΠΎΠΆΠ½ΡΠ΅ ΠΏΠΎΠΊΡΠΎΠ²Ρ ΠΈ ΡΠ»ΠΈΠ·ΠΈΡΡΡΠ΅ ΠΎΠ±ΠΎΠ»ΠΎΡΠΊΠΈ, Ρ Π°ΡΠ°ΠΊΡΠ΅ΡΠΈΠ·ΡΡΡΠ΅Π΅ΡΡ Π²ΠΎΠ·Π½ΠΈΠΊΠ½ΠΎΠ²Π΅Π½ΠΈΠ΅ΠΌ ΠΎΠ³ΡΠ°Π½ΠΈΡΠ΅Π½Π½ΠΎΠ³ΠΎ ΡΠ΅ΡΠΎΠ·Π½ΠΎΠ³ΠΎ ΠΈΠ»ΠΈ ΡΠ΅ΡΠΎΠ·Π½ΠΎ-Π³Π΅ΠΌΠΎΡΡΠ°Π³ΠΈΡΠ΅ΡΠΊΠΎΠ³ΠΎ Π²ΠΎΡΠΏΠ°Π»Π΅Π½ΠΈΡ, ΡΠΎΠΏΡΠΎΠ²ΠΎΠΆΠ΄Π°ΡΡΠ΅Π³ΠΎΡΡ Π»ΠΈΡ ΠΎΡΠ°Π΄ΠΊΠΎΠΉ ΠΈ ΠΎΠ±ΡΠ΅ΠΉ ΠΈΠ½ΡΠΎΠΊΡΠΈΠΊΠ°ΡΠΈΠ΅ΠΉ. Π ΠΎΠΆΠ° Π²Ρ ΠΎΠ΄ΠΈΡ Π² ΡΠΈΡΠ»ΠΎ ΡΠ°ΠΌΡΡ ΡΠ°ΡΠΏΡΠΎΡΡΡΠ°Π½Π΅Π½Π½ΡΡ Π±Π°ΠΊΡΠ΅ΡΠΈΠ°Π»ΡΠ½ΡΡ ΠΈΠ½ΡΠ΅ΠΊΡΠΈΠΉ.
Π₯Π°ΡΠ°ΠΊΡΠ΅ΡΠΈΡΡΠΈΠΊΠ° Π²ΠΎΠ·Π±ΡΠ΄ΠΈΡΠ΅Π»Ρ
Π ΠΎΠΆΡ Π²ΡΠ·ΡΠ²Π°Π΅Ρ Π±Π΅ΡΠ°-Π³Π΅ΠΌΠΎΠ»ΠΈΡΠΈΡΠ΅ΡΠΊΠΈΠΉ ΡΡΡΠ΅ΠΏΡΠΎΠΊΠΎΠΊΠΊ Π³ΡΡΠΏΠΏΡ Π, ΡΠ°ΡΠ΅ Π²ΡΠ΅Π³ΠΎ Π²ΠΈΠ΄Π° Streptococcus pyogenes, ΠΈΠΌΠ΅ΡΡΠΈΠΉ ΡΠ°Π·Π½ΠΎΠΎΠ±ΡΠ°Π·Π½ΡΠΉ Π½Π°Π±ΠΎΡ Π°Π½ΡΠΈΠ³Π΅Π½ΠΎΠ², ΡΠ΅ΡΠΌΠ΅Π½ΡΠΎΠ², ΡΠ½Π΄ΠΎ- ΠΈ ΡΠΊΠ·ΠΎΡΠΎΠΊΡΠΈΠ½ΠΎΠ². ΠΡΠΎΡ ΠΌΠΈΠΊΡΠΎΠΎΡΠ³Π°Π½ΠΈΠ·ΠΌ ΠΌΠΎΠΆΠ΅Ρ Π±ΡΡΡ ΡΠΎΡΡΠ°Π²Π»ΡΡΡΠ΅ΠΉ ΡΠ°ΡΡΡΡ Π½ΠΎΡΠΌΠ°Π»ΡΠ½ΠΎΠΉ ΡΠ»ΠΎΡΡ ΡΠΎΡΠΎΠ³Π»ΠΎΡΠΊΠΈ, ΠΏΡΠΈΡΡΡΡΡΠ²ΠΎΠ²Π°ΡΡ Π½Π° ΠΊΠΎΠΆΠ½ΡΡ ΠΏΠΎΠΊΡΠΎΠ²Π°Ρ Π·Π΄ΠΎΡΠΎΠ²ΡΡ Π»ΡΠ΄Π΅ΠΉ. Π Π΅Π·Π΅ΡΠ²ΡΠ°ΡΠΎΠΌ ΠΈ ΠΈΡΡΠΎΡΠ½ΠΈΠΊΠΎΠΌ ΡΠΎΠΆΠ΅Π²ΠΎΠΉ ΠΈΠ½ΡΠ΅ΠΊΡΠΈΠΈ ΡΠ²Π»ΡΠ΅ΡΡΡ ΡΠ΅Π»ΠΎΠ²Π΅ΠΊ, ΠΊΠ°ΠΊ ΡΡΡΠ°Π΄Π°ΡΡΠΈΠΉ ΠΎΠ΄Π½ΠΎΠΉ ΠΈΠ· ΡΠΎΡΠΌ ΡΡΡΠ΅ΠΏΡΠΎΠΊΠΎΠΊΠΊΠΎΠ²ΠΎΠΉ ΠΈΠ½ΡΠ΅ΠΊΡΠΈΠΈ, ΡΠ°ΠΊ ΠΈ Π·Π΄ΠΎΡΠΎΠ²ΡΠΉ Π½ΠΎΡΠΈΡΠ΅Π»Ρ.
Π ΠΎΠΆΠ° ΠΏΠ΅ΡΠ΅Π΄Π°Π΅ΡΡΡ ΠΏΠΎ Π°ΡΡΠΎΠ·ΠΎΠ»ΡΠ½ΠΎΠΌΡ ΠΌΠ΅Ρ Π°Π½ΠΈΠ·ΠΌΡ ΠΏΡΠ΅ΠΈΠΌΡΡΠ΅ΡΡΠ²Π΅Π½Π½ΠΎ Π²ΠΎΠ·Π΄ΡΡΠ½ΠΎ-ΠΊΠ°ΠΏΠ΅Π»ΡΠ½ΡΠΌ, ΠΈΠ½ΠΎΠ³Π΄Π° ΠΊΠΎΠ½ΡΠ°ΠΊΡΠ½ΡΠΌ ΠΏΡΡΠ΅ΠΌ. ΠΡ ΠΎΠ΄Π½ΡΠΌΠΈ Π²ΠΎΡΠΎΡΠ°ΠΌΠΈ Π΄Π»Ρ ΡΡΠΎΠΉ ΠΈΠ½ΡΠ΅ΠΊΡΠΈΠΈ ΡΠ»ΡΠΆΠ°Ρ ΠΏΠΎΠ²ΡΠ΅ΠΆΠ΄Π΅Π½ΠΈΡ ΠΈ ΠΌΠΈΠΊΡΠΎΡΡΠ°Π²ΠΌΡ ΠΊΠΎΠΆΠΈ ΠΈ ΡΠ»ΠΈΠ·ΠΈΡΡΡΡ ΠΎΠ±ΠΎΠ»ΠΎΡΠ΅ΠΊ ΡΠΎΡΠΎΠ²ΠΎΠΉ ΠΏΠΎΠ»ΠΎΡΡΠΈ, Π½ΠΎΡΠ°, ΠΏΠΎΠ»ΠΎΠ²ΡΡ ΠΎΡΠ³Π°Π½ΠΎΠ². ΠΠΎΡΠΊΠΎΠ»ΡΠΊΡ ΡΡΡΠ΅ΠΏΡΠΎΠΊΠΎΠΊΠΊΠΈ Π½Π΅ΡΠ΅Π΄ΠΊΠΎ ΠΎΠ±ΠΈΡΠ°ΡΡ Π½Π° ΠΏΠΎΠ²Π΅ΡΡ Π½ΠΎΡΡΠΈ ΠΊΠΎΠΆΠΈ ΠΈ ΡΠ»ΠΈΠ·ΠΈΡΡΡΡ ΠΎΠ±ΠΎΠ»ΠΎΡΠ΅ΠΊ Π·Π΄ΠΎΡΠΎΠ²ΡΡ Π»ΡΠ΄Π΅ΠΉ, ΠΎΠΏΠ°ΡΠ½ΠΎΡΡΡ Π·Π°ΡΠ°ΠΆΠ΅Π½ΠΈΡ ΠΏΡΠΈ Π½Π΅ΡΠΎΠ±Π»ΡΠ΄Π΅Π½ΠΈΠΈ ΠΏΡΠ°Π²ΠΈΠ» ΡΠ»Π΅ΠΌΠ΅Π½ΡΠ°ΡΠ½ΠΎΠΉ Π³ΠΈΠ³ΠΈΠ΅Π½Ρ ΠΊΡΠ°ΠΉΠ½Π΅ Π²Π΅Π»ΠΈΠΊΠ°. Π Π°Π·Π²ΠΈΡΠΈΡ ΠΈΠ½ΡΠ΅ΠΊΡΠΈΠΈ ΡΠΏΠΎΡΠΎΠ±ΡΡΠ²ΡΡΡ ΡΠ°ΠΊΡΠΎΡΡ ΠΈΠ½Π΄ΠΈΠ²ΠΈΠ΄ΡΠ°Π»ΡΠ½ΠΎΠΉ ΠΏΡΠ΅Π΄ΡΠ°ΡΠΏΠΎΠ»ΠΎΠΆΠ΅Π½Π½ΠΎΡΡΠΈ.
ΠΠ΅Π½ΡΠΈΠ½Ρ Π·Π°Π±ΠΎΠ»Π΅Π²Π°ΡΡ ΡΠ°ΡΠ΅ ΠΌΡΠΆΡΠΈΠ½, Π²ΠΎΡΠΏΡΠΈΠΈΠΌΡΠΈΠ²ΠΎΡΡΡ ΠΏΠΎΠ²ΡΡΠ°Π΅ΡΡΡ ΠΏΡΠΈ ΠΏΡΠΎΠ΄ΠΎΠ»ΠΆΠΈΡΠ΅Π»ΡΠ½ΠΎΠΌ ΠΏΡΠΈΠ΅ΠΌΠ΅ ΠΏΡΠ΅ΠΏΠ°ΡΠ°ΡΠΎΠ² Π³ΡΡΠΏΠΏΡ ΡΡΠ΅ΡΠΎΠΈΠ΄Π½ΡΡ Π³ΠΎΡΠΌΠΎΠ½ΠΎΠ². ΠΡΡΠ΅ Π² 5-6 ΡΠ°Π· ΡΠΈΡΠΊ ΡΠ°Π·Π²ΠΈΡΠΈΡ ΡΠΎΠΆΠΈ Ρ Π»ΠΈΡ, ΡΡΡΠ°Π΄Π°ΡΡΠΈΡ Ρ ΡΠΎΠ½ΠΈΡΠ΅ΡΠΊΠΈΠΌ ΡΠΎΠ½Π·ΠΈΠ»Π»ΠΈΡΠΎΠΌ, Π΄ΡΡΠ³ΠΈΠΌΠΈ ΡΡΡΠ΅ΠΏΡΠΎΠΊΠΎΠΊΠΊΠΎΠ²ΡΠΌΠΈ ΠΈΠ½ΡΠ΅ΠΊΡΠΈΡΠΌΠΈ. Π ΠΎΠΆΠ° Π»ΠΈΡΠ° ΡΠ°ΡΠ΅ ΡΠ°Π·Π²ΠΈΠ²Π°Π΅ΡΡΡ Ρ Π»ΡΠ΄Π΅ΠΉ Ρ Ρ ΡΠΎΠ½ΠΈΡΠ΅ΡΠΊΠΈΠΌΠΈ Π·Π°Π±ΠΎΠ»Π΅Π²Π°Π½ΠΈΡΠΌΠΈ ΠΏΠΎΠ»ΠΎΡΡΠΈ ΡΡΠ°, ΠΠΠ -ΠΎΡΠ³Π°Π½ΠΎΠ², ΠΊΠ°ΡΠΈΠ΅ΡΠΎΠΌ. ΠΠΎΡΠ°ΠΆΠ΅Π½ΠΈΠ΅ Π³ΡΡΠ΄Π½ΠΎΠΉ ΠΊΠ»Π΅ΡΠΊΠΈ ΠΈ ΠΊΠΎΠ½Π΅ΡΠ½ΠΎΡΡΠ΅ΠΉ Π½Π΅ΡΠ΅Π΄ΠΊΠΎ Π²ΠΎΠ·Π½ΠΈΠΊΠ°Π΅Ρ Ρ Π±ΠΎΠ»ΡΠ½ΡΡ Ρ Π»ΠΈΠΌΡΠΎΠ²Π΅Π½ΠΎΠ·Π½ΠΎΠΉ Π½Π΅Π΄ΠΎΡΡΠ°ΡΠΎΡΠ½ΠΎΡΡΡΡ, Π»ΠΈΠΌΡΠ΅Π΄Π΅ΠΌΠΎΠΉ, ΠΎΡΠ΅ΠΊΠ°ΠΌΠΈ ΡΠ°Π·Π½ΠΎΠΎΠ±ΡΠ°Π·Π½ΠΎΠ³ΠΎ ΠΏΡΠΎΠΈΡΡ ΠΎΠΆΠ΄Π΅Π½ΠΈΡ, ΠΏΡΠΈ Π³ΡΠΈΠ±ΠΊΠΎΠ²ΡΡ ΠΏΠΎΡΠ°ΠΆΠ΅Π½ΠΈΡΡ ΡΡΠΎΠΏ, Π½Π°ΡΡΡΠ΅Π½ΠΈΡΡ ΡΡΠΎΡΠΈΠΊΠΈ. ΠΠ½ΡΠ΅ΠΊΡΠΈΡ ΠΌΠΎΠΆΠ΅Ρ ΡΠ°Π·Π²ΠΈΡΡΡΡ Π² ΠΎΠ±Π»Π°ΡΡΠΈ ΠΏΠΎΡΡΡΡΠ°Π²ΠΌΠ°ΡΠΈΡΠ΅ΡΠΊΠΈΡ ΠΈ ΠΏΠΎΡΡΠΎΠΏΠ΅ΡΠ°ΡΠΈΠΎΠ½Π½ΡΡ ΡΡΠ±ΡΠΎΠ². ΠΡΠΌΠ΅ΡΠ°Π΅ΡΡΡ Π½Π΅ΠΊΠΎΡΠΎΡΠ°Ρ ΡΠ΅Π·ΠΎΠ½Π½ΠΎΡΡΡ: ΠΏΠΈΠΊ Π·Π°Π±ΠΎΠ»Π΅Π²Π°Π΅ΠΌΠΎΡΡΠΈ ΠΏΡΠΈΡ ΠΎΠ΄ΠΈΡΡΡ Π½Π° Π²ΡΠΎΡΡΡ ΠΏΠΎΠ»ΠΎΠ²ΠΈΠ½Ρ Π»Π΅ΡΠ° β Π½Π°ΡΠ°Π»ΠΎ ΠΎΡΠ΅Π½ΠΈ.
ΠΠΎΠ·Π±ΡΠ΄ΠΈΡΠ΅Π»Ρ ΠΌΠΎΠΆΠ΅Ρ ΠΏΠΎΠΏΠ°Π΄Π°ΡΡ Π² ΠΎΡΠ³Π°Π½ΠΈΠ·ΠΌ ΡΠ΅ΡΠ΅Π· ΠΏΠΎΠ²ΡΠ΅ΠΆΠ΄Π΅Π½Π½ΡΠ΅ ΠΏΠΎΠΊΡΠΎΠ²Π½ΡΠ΅ ΡΠΊΠ°Π½ΠΈ, Π»ΠΈΠ±ΠΎ ΠΏΡΠΈ ΠΈΠΌΠ΅ΡΡΠ΅ΠΉΡΡ Ρ ΡΠΎΠ½ΠΈΡΠ΅ΡΠΊΠΎΠΉ ΠΈΠ½ΡΠ΅ΠΊΡΠΈΠΈ ΠΏΡΠΎΠ½ΠΈΠΊΠ°ΡΡ Π² ΠΊΠ°ΠΏΠΈΠ»Π»ΡΡΡ ΠΊΠΎΠΆΠΈ Ρ ΡΠΎΠΊΠΎΠΌ ΠΊΡΠΎΠ²ΠΈ. Π‘ΡΡΠ΅ΠΏΡΠΎΠΊΠΎΠΊΠΊ ΡΠ°Π·ΠΌΠ½ΠΎΠΆΠ°Π΅ΡΡΡ Π² Π»ΠΈΠΌΡΠ°ΡΠΈΡΠ΅ΡΠΊΠΈΡ ΠΊΠ°ΠΏΠΈΠ»Π»ΡΡΠ°Ρ Π΄Π΅ΡΠΌΡ ΠΈ ΡΠΎΡΠΌΠΈΡΡΠ΅Ρ ΠΎΡΠ°Π³ ΠΈΠ½ΡΠ΅ΠΊΡΠΈΠΈ, ΠΏΡΠΎΠ²ΠΎΡΠΈΡΡΡ Π°ΠΊΡΠΈΠ²Π½ΠΎΠ΅ Π²ΠΎΡΠΏΠ°Π»Π΅Π½ΠΈΠ΅, Π»ΠΈΠ±ΠΎ Π»Π°ΡΠ΅Π½ΡΠ½ΠΎΠ΅ Π½ΠΎΡΠΈΡΠ΅Π»ΡΡΡΠ²ΠΎ. ΠΠΊΡΠΈΠ²Π½ΠΎΠ΅ ΡΠ°Π·ΠΌΠ½ΠΎΠΆΠ΅Π½ΠΈΠ΅ Π±Π°ΠΊΡΠ΅ΡΠΈΠΉ ΡΠΏΠΎΡΠΎΠ±ΡΡΠ²ΡΠ΅Ρ ΠΌΠ°ΡΡΠΈΡΠΎΠ²Π°Π½Π½ΠΎΠΌΡ Π²ΡΠ΄Π΅Π»Π΅Π½ΠΈΡ Π² ΠΊΡΠΎΠ²ΡΠ½ΠΎΠ΅ ΡΡΡΠ»ΠΎ ΠΏΡΠΎΠ΄ΡΠΊΡΠΎΠ² ΠΈΡ ΠΆΠΈΠ·Π½Π΅Π΄Π΅ΡΡΠ΅Π»ΡΠ½ΠΎΡΡΠΈ (ΡΠΊΠ·ΠΎΡΠΎΠΊΡΠΈΠ½ΠΎΠ², ΡΠ΅ΡΠΌΠ΅Π½ΡΠΎΠ², Π°Π½ΡΠΈΠ³Π΅Π½ΠΎΠ²). Π‘Π»Π΅Π΄ΡΡΠ²ΠΈΠ΅ΠΌ ΡΡΠΎΠ³ΠΎ ΡΡΠ°Π½ΠΎΠ²ΠΈΡΡΡ ΠΈΠ½ΡΠΎΠΊΡΠΈΠΊΠ°ΡΠΈΡ, Π»ΠΈΡ ΠΎΡΠ°Π΄ΠΊΠ°, Π²Π΅ΡΠΎΡΡΠ½ΠΎ ΡΠ°Π·Π²ΠΈΡΠΈΠ΅ ΡΠΎΠΊΡΠΈΠΊΠΎ-ΠΈΠ½ΡΠ΅ΠΊΡΠΈΠΎΠ½Π½ΠΎΠ³ΠΎ ΡΠΎΠΊΠ°.
ΠΠ»Π°ΡΡΠΈΡΠΈΠΊΠ°ΡΠΈΡ ΡΠΎΠΆΠΈ
Π ΠΎΠΆΠ° ΠΊΠ»Π°ΡΡΠΈΡΠΈΡΠΈΡΡΠ΅ΡΡΡ ΠΏΠΎ Π½Π΅ΡΠΊΠΎΠ»ΡΠΊΠΈΠΌ ΠΏΡΠΈΠ·Π½Π°ΠΊΠ°ΠΌ: ΠΏΠΎ Ρ Π°ΡΠ°ΠΊΡΠ΅ΡΡ ΠΌΠ΅ΡΡΠ½ΡΡ ΠΏΡΠΎΡΠ²Π»Π΅Π½ΠΈΡ (ΡΡΠΈΡΠ΅ΠΌΠ°ΡΠΎΠ·Π½Π°Ρ, ΡΡΠΈΡΠ΅ΠΌΠ°ΡΠΎΠ·Π½ΠΎ-Π±ΡΠ»Π»Π΅Π·Π½Π°Ρ, ΡΡΠΈΡΠ΅ΠΌΠ°ΡΠΎΠ·Π½ΠΎ-Π³Π΅ΠΌΠΎΡΡΠ°Π³ΠΈΡΠ΅ΡΠΊΠ°Ρ ΠΈ Π±ΡΠ»Π»Π΅Π·Π½ΠΎ-Π³Π΅ΠΌΠΎΡΡΠ°Π³ΠΈΡΠ΅ΡΠΊΠ°Ρ ΡΠΎΡΠΌΡ), ΠΏΠΎ ΡΡΠΆΠ΅ΡΡΠΈ ΡΠ΅ΡΠ΅Π½ΠΈΡ (Π»Π΅Π³ΠΊΠ°Ρ, ΡΡΠ΅Π΄Π½Π΅ΡΡΠΆΠ΅Π»Π°Ρ ΠΈ ΡΡΠΆΠ΅Π»Π°Ρ ΡΠΎΡΠΌΡ Π² Π·Π°Π²ΠΈΡΠΈΠΌΠΎΡΡΠΈ ΠΎΡ Π²ΡΡΠ°ΠΆΠ΅Π½Π½ΠΎΡΡΠΈ ΠΈΠ½ΡΠΎΠΊΡΠΈΠΊΠ°ΡΠΈΠΈ), ΠΏΠΎ ΡΠ°ΡΠΏΡΠΎΡΡΡΠ°Π½Π΅Π½Π½ΠΎΡΡΠΈ ΠΏΡΠΎΡΠ΅ΡΡΠ° (Π»ΠΎΠΊΠ°Π»ΠΈΠ·ΠΎΠ²Π°Π½Π½Π°Ρ, ΡΠ°ΡΠΏΡΠΎΡΡΡΠ°Π½Π΅Π½Π½Π°Ρ, ΠΌΠΈΠ³ΡΠΈΡΡΡΡΠ°Ρ (Π±Π»ΡΠΆΠ΄Π°ΡΡΠ°Ρ, ΠΏΠΎΠ»Π·ΡΡΠ°Ρ) ΠΈ ΠΌΠ΅ΡΠ°ΡΡΠ°ΡΠΈΡΠ΅ΡΠΊΠ°Ρ). ΠΡΠΎΠΌΠ΅ ΡΠΎΠ³ΠΎ, Π²ΡΠ΄Π΅Π»ΡΡΡ ΠΏΠ΅ΡΠ²ΠΈΡΠ½ΡΡ, ΠΏΠΎΠ²ΡΠΎΡΠ½ΡΡ ΠΈ ΡΠ΅ΡΠΈΠ΄ΠΈΠ²ΠΈΡΡΡΡΡΡ ΡΠΎΠΆΡ.
Π Π΅ΡΠΈΠ΄ΠΈΠ²ΠΈΡΡΡΡΠ°Ρ ΡΠΎΠΆΠ° ΠΏΡΠ΅Π΄ΡΡΠ°Π²Π»ΡΠ΅Ρ ΡΠΎΠ±ΠΎΠΉ ΠΏΠΎΠ²ΡΠΎΡΡΡΡΠΈΠΉΡΡ ΡΠ»ΡΡΠ°ΠΉ Π² ΠΏΠ΅ΡΠΈΠΎΠ΄ ΠΎΡ Π΄Π²ΡΡ Π΄Π½Π΅ΠΉ Π΄ΠΎ Π΄Π²ΡΡ Π»Π΅Ρ ΠΏΠΎΡΠ»Π΅ ΠΏΡΠ΅Π΄ΡΠ΄ΡΡΠ΅Π³ΠΎ ΡΠΏΠΈΠ·ΠΎΠ΄Π°, Π»ΠΈΠ±ΠΎ ΡΠ΅ΡΠΈΠ΄ΠΈΠ² ΠΏΡΠΎΠΈΡΡ ΠΎΠ΄ΠΈΡ ΠΏΠΎΠ·Π΄Π½Π΅Π΅, Π½ΠΎ Π²ΠΎΡΠΏΠ°Π»Π΅Π½ΠΈΠ΅ Π½Π΅ΠΎΠ΄Π½ΠΎΠΊΡΠ°ΡΠ½ΠΎ ΡΠ°Π·Π²ΠΈΠ²Π°Π΅ΡΡΡ Π² ΡΠΎΠΉ ΠΆΠ΅ ΠΎΠ±Π»Π°ΡΡΠΈ. ΠΠΎΠ²ΡΠΎΡΠ½Π°Ρ ΡΠΎΠΆΠ° Π²ΠΎΠ·Π½ΠΈΠΊΠ°Π΅Ρ Π½Π΅ ΡΠ°Π½Π΅Π΅ ΡΠ΅ΠΌ ΡΠ΅ΡΠ΅Π· Π΄Π²Π° Π³ΠΎΠ΄Π°, Π»ΠΈΠ±ΠΎ Π»ΠΎΠΊΠ°Π»ΠΈΠ·ΡΠ΅ΡΡΡ Π² ΠΎΡΠ»ΠΈΡΠ½ΠΎΠΌ ΠΎΡ ΠΏΡΠ΅Π΄ΡΠ΄ΡΡΠ΅Π³ΠΎ ΡΠΏΠΈΠ·ΠΎΠ΄Π° ΠΌΠ΅ΡΡΠ΅.
ΠΠΎΠΊΠ°Π»ΠΈΠ·ΠΎΠ²Π°Π½Π½Π°Ρ ΡΠΎΠΆΠ° Ρ Π°ΡΠ°ΠΊΡΠ΅ΡΠΈΠ·ΡΠ΅ΡΡΡ ΠΎΠ³ΡΠ°Π½ΠΈΡΠ΅Π½ΠΈΠ΅ΠΌ ΠΈΠ½ΡΠ΅ΠΊΡΠΈΠΈ ΠΌΠ΅ΡΡΠ½ΡΠΌ ΠΎΡΠ°Π³ΠΎΠΌ Π²ΠΎΡΠΏΠ°Π»Π΅Π½ΠΈΡ Π² ΠΎΠ΄Π½ΠΎΠΉ Π°Π½Π°ΡΠΎΠΌΠΈΡΠ΅ΡΠΊΠΎΠΉ ΠΎΠ±Π»Π°ΡΡΠΈ. ΠΡΠΈ Π²ΡΡ ΠΎΠ΄Π΅ ΠΎΡΠ°Π³Π° Π·Π° Π³ΡΠ°Π½ΠΈΡΡ Π°Π½Π°ΡΠΎΠΌΠΈΡΠ΅ΡΠΊΠΎΠΉ ΠΎΠ±Π»Π°ΡΡΠΈ Π·Π°Π±ΠΎΠ»Π΅Π²Π°Π½ΠΈΠ΅ ΡΡΠΈΡΠ°Π΅ΡΡΡ ΡΠ°ΡΠΏΡΠΎΡΡΡΠ°Π½Π΅Π½Π½ΡΠΌ. ΠΡΠΈΡΠΎΠ΅Π΄ΠΈΠ½Π΅Π½ΠΈΠ΅ ΡΠ»Π΅Π³ΠΌΠΎΠ½Ρ ΠΈΠ»ΠΈ Π½Π΅ΠΊΡΠΎΡΠΈΡΠ΅ΡΠΊΠΈΠ΅ ΠΈΠ·ΠΌΠ΅Π½Π΅Π½ΠΈΡ Π² ΠΏΠΎΡΠ°ΠΆΠ΅Π½Π½ΡΡ ΡΠΊΠ°Π½ΡΡ ΡΡΠΈΡΠ°ΡΡΡΡ ΠΎΡΠ»ΠΎΠΆΠ½Π΅Π½ΠΈΡΠΌΠΈ ΠΎΡΠ½ΠΎΠ²Π½ΠΎΠ³ΠΎ Π·Π°Π±ΠΎΠ»Π΅Π²Π°Π½ΠΈΡ.
Π‘ΠΈΠΌΠΏΡΠΎΠΌΡ ΡΠΎΠΆΠΈΡΡΠΎΠ³ΠΎ Π²ΠΎΡΠΏΠ°Π»Π΅Π½ΠΈΡ
ΠΠ½ΠΊΡΠ±Π°ΡΠΈΠΎΠ½Π½ΡΠΉ ΠΏΠ΅ΡΠΈΠΎΠ΄ ΠΎΠΏΡΠ΅Π΄Π΅Π»ΡΠ΅ΡΡΡ ΡΠΎΠ»ΡΠΊΠΎ Π² ΡΠ»ΡΡΠ°Π΅ ΠΏΠΎΡΡΡΡΠ°Π²ΠΌΠ°ΡΠΈΡΠ΅ΡΠΊΠΎΠΉ ΡΠΎΠΆΠΈ ΠΈ ΡΠΎΡΡΠ°Π²Π»ΡΠ΅Ρ ΠΎΡ Π½Π΅ΡΠΊΠΎΠ»ΡΠΊΠΈΡ ΡΠ°ΡΠΎΠ² Π΄ΠΎ ΠΏΡΡΠΈ Π΄Π½Π΅ΠΉ. Π ΠΏΠΎΠ΄Π°Π²Π»ΡΡΡΠ΅ΠΌ Π±ΠΎΠ»ΡΡΠΈΠ½ΡΡΠ²Π΅ ΡΠ»ΡΡΠ°Π΅Π² (Π±ΠΎΠ»Π΅Π΅ 90%) ΡΠΎΠΆΠ° ΠΈΠΌΠ΅Π΅Ρ ΠΎΡΡΡΠΎΠ΅ Π½Π°ΡΠ°Π»ΠΎ (Π²ΡΠ΅ΠΌΡ ΠΏΠΎΡΠ²Π»Π΅Π½ΠΈΡ ΠΊΠ»ΠΈΠ½ΠΈΡΠ΅ΡΠΊΠΈΡ ΡΠΈΠΌΠΏΡΠΎΠΌΠΎΠ² ΠΎΡΠΌΠ΅ΡΠ°Π΅ΡΡΡ Ρ ΡΠΎΡΠ½ΠΎΡΡΡΡ Π΄ΠΎ ΡΠ°ΡΠΎΠ²), Π±ΡΡΡΡΠΎ ΡΠ°Π·Π²ΠΈΠ²Π°Π΅ΡΡΡ Π»ΠΈΡ ΠΎΡΠ°Π΄ΠΊΠ°, ΡΠΎΠΏΡΠΎΠ²ΠΎΠΆΠ΄Π°ΡΡΠ°ΡΡΡ ΡΠΈΠΌΠΏΡΠΎΠΌΠ°ΠΌΠΈ ΠΈΠ½ΡΠΎΠΊΡΠΈΠΊΠ°ΡΠΈΠΈ (ΠΎΠ·Π½ΠΎΠ±, Π³ΠΎΠ»ΠΎΠ²Π½Π°Ρ Π±ΠΎΠ»Ρ, ΡΠ»Π°Π±ΠΎΡΡΡ, Π»ΠΎΠΌΠΎΡΠ° Π² ΡΠ΅Π»Π΅). Π’ΡΠΆΠ΅Π»ΠΎΠ΅ ΡΠ΅ΡΠ΅Π½ΠΈΠ΅ Ρ Π°ΡΠ°ΠΊΡΠ΅ΡΠΈΠ·ΡΠ΅ΡΡΡ Π²ΠΎΠ·Π½ΠΈΠΊΠ½ΠΎΠ²Π΅Π½ΠΈΠ΅ΠΌ ΡΠ²ΠΎΡΡ ΡΠ΅Π½ΡΡΠ°Π»ΡΠ½ΠΎΠ³ΠΎ Π³Π΅Π½Π΅Π·Π°, ΡΡΠ΄ΠΎΡΠΎΠ³, Π±ΡΠ΅Π΄Π°. Π‘ΠΏΡΡΡΡ Π½Π΅ΡΠΊΠΎΠ»ΡΠΊΠΎ ΡΠ°ΡΠΎΠ² (ΠΈΠ½ΠΎΠ³Π΄Π° Π½Π° ΡΠ»Π΅Π΄ΡΡΡΠΈΠΉ Π΄Π΅Π½Ρ) ΠΏΡΠΎΡΠ²Π»ΡΡΡΡΡ ΠΌΠ΅ΡΡΠ½ΡΠ΅ ΡΠΈΠΌΠΏΡΠΎΠΌΡ: Π½Π° ΠΎΠ³ΡΠ°Π½ΠΈΡΠ΅Π½Π½ΠΎΠΌ ΡΡΠ°ΡΡΠΊΠ΅ ΠΊΠΎΠΆΠΈ ΠΈΠ»ΠΈ ΡΠ»ΠΈΠ·ΠΈΡΡΠΎΠΉ ΠΏΠΎΡΠ²Π»ΡΠ΅ΡΡΡ ΠΆΠΆΠ΅Π½ΠΈΠ΅, Π·ΡΠ΄, ΡΡΠ²ΡΡΠ²ΠΎ ΡΠ°ΡΠΏΠΈΡΠ°Π½ΠΈΡ ΠΈ ΡΠΌΠ΅ΡΠ΅Π½Π½Π°Ρ Π±ΠΎΠ»Π΅Π·Π½Π΅Π½Π½ΠΎΡΡΡ ΠΏΡΠΈ ΠΎΡΡΠΏΡΠ²Π°Π½ΠΈΠΈ, Π½Π°Π΄Π°Π²Π»ΠΈΠ²Π°Π½ΠΈΠΈ. ΠΡΡΠ°ΠΆΠ΅Π½Π½Π°Ρ Π±ΠΎΠ»Ρ Ρ Π°ΡΠ°ΠΊΡΠ΅ΡΠ½Π° ΠΏΡΠΈ ΡΠΎΠΆΠΈΡΡΠΎΠΌ Π²ΠΎΡΠΏΠ°Π»Π΅Π½ΠΈΠΈ Π²ΠΎΠ»ΠΎΡΠΈΡΡΠΎΠΉ ΡΠ°ΡΡΠΈ Π³ΠΎΠ»ΠΎΠ²Ρ. ΠΠΎΠΆΠ΅Ρ ΠΎΡΠΌΠ΅ΡΠ°ΡΡΡΡ Π±ΠΎΠ»Π΅Π·Π½Π΅Π½Π½ΠΎΡΡΡ ΡΠ΅Π³ΠΈΠΎΠ½Π°ΡΠ½ΡΡ Π»ΠΈΠΌΡΠΎΡΠ·Π»ΠΎΠ² ΠΏΡΠΈ ΠΏΠ°Π»ΡΠΏΠ°ΡΠΈΠΈ ΠΈ Π΄Π²ΠΈΠΆΠ΅Π½ΠΈΠΈ. Π ΠΎΠ±Π»Π°ΡΡΠΈ ΠΎΡΠ°Π³Π° ΠΏΠΎΡΠ²Π»ΡΠ΅ΡΡΡ ΡΡΠΈΡΠ΅ΠΌΠ° ΠΈ ΠΎΡΠ΅ΡΠ½ΠΎΡΡΡ.ΠΠ΅ΡΠΈΠΎΠ΄ ΡΠ°Π·Π³Π°ΡΠ° Ρ Π°ΡΠ°ΠΊΡΠ΅ΡΠΈΠ·ΡΠ΅ΡΡΡ ΠΏΡΠΎΠ³ΡΠ΅ΡΡΠΈΠ΅ΠΉ ΠΈΠ½ΡΠΎΠΊΡΠΈΠΊΠ°ΡΠΈΠΈ, Π°ΠΏΠ°ΡΠΈΠ΅ΠΉ, Π±Π΅ΡΡΠΎΠ½Π½ΠΈΡΠ΅ΠΉ, ΡΠΎΡΠ½ΠΎΡΠΎΠΉ ΠΈ ΡΠ²ΠΎΡΠΎΠΉ, ΡΠΈΠΌΠΏΡΠΎΠΌΠ°ΡΠΈΠΊΠΎΠΉ ΡΠΎ ΡΡΠΎΡΠΎΠ½Ρ Π¦ΠΠ‘ (ΠΏΠΎΡΠ΅ΡΡ ΡΠΎΠ·Π½Π°Π½ΠΈΡ, Π±ΡΠ΅Π΄). ΠΠ±Π»Π°ΡΡΡ ΠΎΡΠ°Π³Π° ΠΏΡΠ΅Π΄ΡΡΠ°Π²Π»ΡΠ΅Ρ ΡΠΎΠ±ΠΎΠΉ ΠΏΠ»ΠΎΡΠ½ΠΎΠ΅ ΡΡΠΊΠΎ-ΠΊΡΠ°ΡΠ½ΠΎΠ΅ ΠΏΡΡΠ½ΠΎ Ρ ΡΠ΅ΡΠΊΠΎ ΠΎΡΠ΅ΡΡΠ΅Π½Π½ΡΠΌΠΈ Π½Π΅ΡΠΎΠ²Π½ΡΠΌΠΈ Π³ΡΠ°Π½ΠΈΡΠ°ΠΌΠΈ (ΡΠΈΠΌΠΏΡΠΎΠΌ Β«ΡΠ·ΡΠΊΠΎΠ² ΠΏΠ»Π°ΠΌΠ΅Π½ΠΈΒ» ΠΈΠ»ΠΈ Β«Π³Π΅ΠΎΠ³ΡΠ°ΡΠΈΡΠ΅ΡΠΊΠΎΠΉ ΠΊΠ°ΡΡΡΒ»), Ρ Π²ΡΡΠ°ΠΆΠ΅Π½Π½ΡΠΌ ΠΎΡΠ΅ΠΊΠΎΠΌ. Π¦Π²Π΅Ρ ΡΡΠΈΡΠ΅ΠΌΡ ΠΌΠΎΠΆΠ΅Ρ ΠΊΠΎΠ»Π΅Π±Π°ΡΡΡΡ ΠΎΡ ΡΠΈΠ°Π½ΠΎΡΠΈΡΠ½ΠΎΠ³ΠΎ (ΠΏΡΠΈ Π»ΠΈΠΌΡΠΎΡΡΠ°Π·Π΅) Π΄ΠΎ Π±ΡΡΠΎΠ²Π°ΡΠΎΠ³ΠΎ (ΠΏΡΠΈ Π½Π°ΡΡΡΠ΅Π½ΠΈΠΈ ΡΡΠΎΡΠΈΠΊΠΈ). ΠΡΠΌΠ΅ΡΠ°Π΅ΡΡΡ ΠΊΡΠ°ΡΠΊΠΎΠ²ΡΠ΅ΠΌΠ΅Π½Π½ΠΎΠ΅ (1-2 Ρ) ΠΈΡΡΠ΅Π·Π½ΠΎΠ²Π΅Π½ΠΈΠ΅ ΠΏΠΎΠΊΡΠ°ΡΠ½Π΅Π½ΠΈΡ ΠΏΠΎΡΠ»Π΅ Π½Π°Π΄Π°Π²Π»ΠΈΠ²Π°Π½ΠΈΡ. Π Π±ΠΎΠ»ΡΡΠΈΠ½ΡΡΠ²Π΅ ΡΠ»ΡΡΠ°Π΅Π² ΠΎΠ±Π½Π°ΡΡΠΆΠΈΠ²Π°ΡΡ ΡΠΏΠ»ΠΎΡΠ½Π΅Π½ΠΈΠ΅, ΠΎΠ³ΡΠ°Π½ΠΈΡΠ΅Π½ΠΈΠ΅ ΠΏΠΎΠ΄Π²ΠΈΠΆΠ½ΠΎΡΡΠΈ ΠΈ Π±ΠΎΠ»Π΅Π·Π½Π΅Π½Π½ΠΎΡΡΡ ΠΏΡΠΈ ΠΏΠ°Π»ΡΠΏΠ°ΡΠΈΠΈ ΡΠ΅Π³ΠΈΠΎΠ½Π°ΡΠ½ΡΡ Π»ΠΈΠΌΡΠΎΡΠ·Π»ΠΎΠ².
ΠΠΈΡ ΠΎΡΠ°Π΄ΠΊΠ° ΠΈ ΠΈΠ½ΡΠΎΠΊΡΠΈΠΊΠ°ΡΠΈΡ ΡΠΎΡ ΡΠ°Π½ΡΠ΅ΡΡΡ ΠΎΠΊΠΎΠ»ΠΎ Π½Π΅Π΄Π΅Π»ΠΈ, ΠΏΠΎΡΠ»Π΅ ΡΠ΅Π³ΠΎ ΡΠ΅ΠΌΠΏΠ΅ΡΠ°ΡΡΡΠ° Π½ΠΎΡΠΌΠ°Π»ΠΈΠ·ΡΠ΅ΡΡΡ, ΡΠ΅Π³ΡΠ΅ΡΡ ΠΊΠΎΠΆΠ½ΡΡ ΡΠΈΠΌΠΏΡΠΎΠΌΠΎΠ² ΠΏΡΠΎΠΈΡΡ ΠΎΠ΄ΠΈΡ Π½Π΅ΡΠΊΠΎΠ»ΡΠΊΠΎ ΠΏΠΎΠ·Π΄Π½Π΅Π΅. ΠΡΠΈΡΠ΅ΠΌΠ° ΠΎΡΡΠ°Π²Π»ΡΠ΅Ρ ΠΏΠΎΡΠ»Π΅ ΡΠ΅Π±Ρ ΠΌΠ΅Π»ΠΊΠΎΡΠ΅ΡΡΠΉΡΠ°ΡΠΎΠ΅ ΡΠ΅Π»ΡΡΠ΅Π½ΠΈΠ΅, ΠΈΠ½ΠΎΠ³Π΄Π° β ΠΏΠΈΠ³ΠΌΠ΅Π½ΡΠ°ΡΠΈΡ. Π Π΅Π³ΠΈΠΎΠ½Π°ΡΠ½ΡΠΉ Π»ΠΈΠΌΡΠ°Π΄Π΅Π½ΠΈΡ ΠΈ ΠΈΠ½ΡΠΈΠ»ΡΡΡΠ°ΡΠΈΡ ΠΊΠΎΠΆΠΈ Π² Π½Π΅ΠΊΠΎΡΠΎΡΡΡ ΡΠ»ΡΡΠ°ΡΡ ΠΌΠΎΠΆΠ΅Ρ ΡΠΎΡ ΡΠ°Π½ΡΡΡΡΡ Π΄Π»ΠΈΡΠ΅Π»ΡΠ½ΠΎΠ΅ Π²ΡΠ΅ΠΌΡ, ΡΡΠΎ ΡΠ²Π»ΡΠ΅ΡΡΡ ΠΏΡΠΈΠ·Π½Π°ΠΊΠΎΠΌ Π²Π΅ΡΠΎΡΡΠ½ΠΎΠ³ΠΎ ΡΠ°Π½Π½Π΅Π³ΠΎ ΡΠ΅ΡΠΈΠ΄ΠΈΠ²Π°. Π‘ΡΠΎΠΉΠΊΠΈΠΉ ΠΎΡΠ΅ΠΊ ΡΠ²Π»ΡΠ΅ΡΡΡ ΡΠΈΠΌΠΏΡΠΎΠΌΠΎΠΌ ΡΠ°Π·Π²ΠΈΠ²Π°ΡΡΠ΅Π³ΠΎΡΡ Π»ΠΈΠΌΡΠΎΡΡΠ°Π·Π°. Π ΠΎΠΆΠ° ΡΠ°ΡΠ΅ Π²ΡΠ΅Π³ΠΎ Π»ΠΎΠΊΠ°Π»ΠΈΠ·ΡΠ΅ΡΡΡ Π½Π° Π½ΠΈΠΆΠ½ΠΈΡ ΠΊΠΎΠ½Π΅ΡΠ½ΠΎΡΡΡΡ , Π·Π°ΡΠ΅ΠΌ ΠΏΠΎ ΡΠ°ΡΡΠΎΡΠ΅ ΡΠ°Π·Π²ΠΈΡΠΈΡ ΠΈΠ΄Π΅Ρ ΡΠΎΠΆΠ° Π»ΠΈΡΠ°, Π²Π΅ΡΡ Π½ΠΈΡ ΠΊΠΎΠ½Π΅ΡΠ½ΠΎΡΡΠ΅ΠΉ, Π³ΡΡΠ΄Π½ΠΎΠΉ ΠΊΠ»Π΅ΡΠΊΠΈ (ΡΠΎΠΆΠΈΡΡΠΎΠ΅ Π²ΠΎΡΠΏΠ°Π»Π΅Π½ΠΈΠ΅ Π³ΡΡΠ΄Π½ΠΎΠΉ ΠΊΠ»Π΅ΡΠΊΠΈ Π½Π°ΠΈΠ±ΠΎΠ»Π΅Π΅ Ρ Π°ΡΠ°ΠΊΡΠ΅ΡΠ½ΠΎ ΠΏΡΠΈ ΡΠ°Π·Π²ΠΈΡΠΈΠΈ Π»ΠΈΠΌΡΠΎΡΡΠ°Π·Π° Π² ΠΎΠ±Π»Π°ΡΡΠΈ ΠΏΠΎΡΠ»Π΅ΠΎΠΏΠ΅ΡΠ°ΡΠΈΠΎΠ½Π½ΠΎΠ³ΠΎ ΡΡΠ±ΡΠ°).
ΠΡΠΈΡΠ΅ΠΌΠ°ΡΠΎΠ·Π½ΠΎ-Π³Π΅ΠΌΠΎΡΡΠ°Π³ΠΈΡΠ΅ΡΠΊΠ°Ρ ΡΠΎΠΆΠ° ΠΎΡΠ»ΠΈΡΠ°Π΅ΡΡΡ ΠΏΡΠΈΡΡΡΡΡΠ²ΠΈΠ΅ΠΌ Ρ ΠΎΠ±Π»Π°ΡΡΠΈ ΠΌΠ΅ΡΡΠ½ΠΎΠ³ΠΎ ΠΎΡΠ°Π³Π° Π½Π° ΡΠΎΠ½Π΅ ΠΎΠ±ΡΠ΅ΠΉ ΡΡΠΈΡΠ΅ΠΌΡ ΠΊΡΠΎΠ²ΠΎΠΈΠ·Π»ΠΈΡΠ½ΠΈΠΉ: ΠΎΡ ΠΌΠ΅Π»ΠΊΠΈΡ (ΠΏΠ΅ΡΠ΅Ρ ΠΈΠΉ) Π΄ΠΎ ΠΎΠ±ΡΠΈΡΠ½ΡΡ , ΡΠ»ΠΈΠ²Π½ΡΡ . ΠΠΈΡ ΠΎΡΠ°Π΄ΠΊΠ° ΠΏΡΠΈ ΡΡΠΎΠΉ ΡΠΎΡΠΌΠ΅ Π·Π°Π±ΠΎΠ»Π΅Π²Π°Π½ΠΈΡ ΠΎΠ±ΡΡΠ½ΠΎ Π±ΠΎΠ»Π΅Π΅ Π΄Π»ΠΈΡΠ΅Π»ΡΠ½Π°Ρ (Π΄ΠΎ Π΄Π²ΡΡ Π½Π΅Π΄Π΅Π»Ρ) ΠΈ ΡΠ΅Π³ΡΠ΅ΡΡ ΠΊΠ»ΠΈΠ½ΠΈΡΠ΅ΡΠΊΠΈΡ ΠΏΡΠΎΡΠ²Π»Π΅Π½ΠΈΠΉ ΠΏΡΠΎΠΈΡΡ ΠΎΠ΄ΠΈΡ Π·Π°ΠΌΠ΅ΡΠ½ΠΎ ΠΌΠ΅Π΄Π»Π΅Π½Π½Π΅Π΅. ΠΡΠΎΠΌΠ΅ ΡΠΎΠ³ΠΎ, ΡΠ°ΠΊΠ°Ρ ΡΠΎΡΠΌΠ° ΡΠΎΠΆΠΈΡΡΠΎΠ³ΠΎ Π²ΠΎΡΠΏΠ°Π»Π΅Π½ΠΈΡ ΠΌΠΎΠΆΠ΅Ρ ΠΎΡΠ»ΠΎΠΆΠ½ΡΡΡΡΡ Π½Π΅ΠΊΡΠΎΠ·ΠΎΠΌ ΠΌΠ΅ΡΡΠ½ΡΡ ΡΠΊΠ°Π½Π΅ΠΉ.
ΠΡΠΈ ΡΡΠΈΡΠ΅ΠΌΠ°ΡΠΎΠ·Π½ΠΎ-Π±ΡΠ»Π»Π΅Π·Π½ΠΎΠΉ ΡΠΎΡΠΌΠ΅ Π² ΠΎΠ±Π»Π°ΡΡΠΈ ΡΡΠΈΡΠ΅ΠΌΡ ΠΎΠ±ΡΠ°Π·ΡΡΡΡΡ ΠΏΡΠ·ΡΡΡΠΊΠΈ (Π±ΡΠ»Π»Ρ), ΠΊΠ°ΠΊ ΠΌΠ΅Π»ΠΊΠΈΠ΅, ΡΠ°ΠΊ ΠΈ Π΄ΠΎΠ²ΠΎΠ»ΡΠ½ΠΎ ΠΊΡΡΠΏΠ½ΡΠ΅, Ρ ΠΏΡΠΎΠ·ΡΠ°ΡΠ½ΡΠΌ ΡΠΎΠ΄Π΅ΡΠΆΠΈΠΌΡΠΌ ΡΠ΅ΡΠΎΠ·Π½ΠΎΠ³ΠΎ Ρ Π°ΡΠ°ΠΊΡΠ΅ΡΠ°. ΠΡΠ·ΡΡΠΈ Π²ΠΎΠ·Π½ΠΈΠΊΠ°ΡΡ ΡΠ΅ΡΠ΅Π· 2-3 Π΄Π½Ρ ΠΏΠΎΡΠ»Π΅ ΡΠΎΡΠΌΠΈΡΠΎΠ²Π°Π½ΠΈΡ ΡΡΠΈΡΠ΅ΠΌΡ, Π²ΡΠΊΡΡΠ²Π°ΡΡΡΡ ΡΠ°ΠΌΠΎΡΡΠΎΡΡΠ΅Π»ΡΠ½ΠΎ, Π»ΠΈΠ±ΠΎ ΠΈΡ Π²ΡΠΊΡΡΠ²Π°ΡΡ ΡΡΠ΅ΡΠΈΠ»ΡΠ½ΡΠΌΠΈ Π½ΠΎΠΆΠ½ΠΈΡΠ°ΠΌΠΈ. Π ΡΠ±ΡΠΎΠ² Π±ΡΠ»Π»Ρ ΠΏΡΠΈ ΡΠΎΠΆΠ΅ ΠΎΠ±ΡΡΠ½ΠΎ Π½Π΅ ΠΎΡΡΠ°Π²Π»ΡΡΡ. ΠΡΠΈ Π±ΡΠ»Π»Π΅Π·Π½ΠΎ-Π³Π΅ΠΌΠΎΡΡΠ°Π³ΠΈΡΠ΅ΡΠΊΠΎΠΉ ΡΠΎΡΠΌΠ΅ ΡΠΎΠ΄Π΅ΡΠΆΠΈΠΌΠΎΠ΅ ΠΏΡΠ·ΡΡΡΠΊΠΎΠ² Π½ΠΎΡΠΈΡ ΡΠ΅ΡΠΎΠ·Π½ΠΎ-Π³Π΅ΠΌΠΎΡΡΠ°Π³ΠΈΡΠ΅ΡΠΊΠΈΠΉ Ρ Π°ΡΠ°ΠΊΡΠ΅Ρ, ΠΈ, Π½Π΅ΡΠ΅Π΄ΠΊΠΎ, ΠΎΡΡΠ°Π²Π»ΡΡΡ ΠΏΠΎΡΠ»Π΅ Π²ΡΠΊΡΡΡΠΈΡ ΡΡΠΎΠ·ΠΈΠΈ ΠΈ ΠΈΠ·ΡΡΠ·Π²Π»Π΅Π½ΠΈΡ. Π’Π°ΠΊΠ°Ρ ΡΠΎΡΠΌΠ° ΡΠ°ΡΡΠΎ ΠΎΡΠ»ΠΎΠΆΠ½ΡΠ΅ΡΡΡ ΡΠ»Π΅Π³ΠΌΠΎΠ½ΠΎΠΉ ΠΈΠ»ΠΈ Π½Π΅ΠΊΡΠΎΠ·ΠΎΠΌ, ΠΏΠΎΡΠ»Π΅ Π²ΡΠ·Π΄ΠΎΡΠΎΠ²Π»Π΅Π½ΠΈΡ ΠΌΠΎΠ³ΡΡ ΠΎΡΡΠ°Π²Π°ΡΡΡΡ ΡΡΠ±ΡΡ ΠΈ ΡΡΠ°ΡΡΠΊΠΈ ΠΏΠΈΠ³ΠΌΠ΅Π½ΡΠ°ΡΠΈΠΈ.Β
ΠΠ½Π΅ Π·Π°Π²ΠΈΡΠΈΠΌΠΎΡΡΠΈ ΠΎΡ ΡΠΎΡΠΌΡ Π·Π°Π±ΠΎΠ»Π΅Π²Π°Π½ΠΈΡ ΡΠΎΠΆΠ° ΠΈΠΌΠ΅Π΅Ρ ΠΎΡΠΎΠ±Π΅Π½Π½ΠΎΡΡΠΈ ΡΠ΅ΡΠ΅Π½ΠΈΡ Π² ΡΠ°Π·Π»ΠΈΡΠ½ΡΡ Π²ΠΎΠ·ΡΠ°ΡΡΠ½ΡΡ Π³ΡΡΠΏΠΏΠ°Ρ . Π ΠΏΠΎΠΆΠΈΠ»ΠΎΠΌ Π²ΠΎΠ·ΡΠ°ΡΡΠ΅ ΠΏΠ΅ΡΠ²ΠΈΡΠ½ΠΎΠ΅ ΠΈ ΠΏΠΎΠ²ΡΠΎΡΠ½ΠΎΠ΅ Π²ΠΎΡΠΏΠ°Π»Π΅Π½ΠΈΠ΅ ΠΏΡΠΎΡΠ΅ΠΊΠ°Π΅Ρ, ΠΊΠ°ΠΊ ΠΏΡΠ°Π²ΠΈΠ»ΠΎ, Π±ΠΎΠ»Π΅Π΅ ΡΡΠΆΠ΅Π»ΠΎ, Ρ ΡΠ΄Π»ΠΈΠ½Π΅Π½Π½ΡΠΌ ΠΏΠ΅ΡΠΈΠΎΠ΄ΠΎΠΌ Π»ΠΈΡ ΠΎΡΠ°Π΄ΠΊΠΈ (Π²ΠΏΠ»ΠΎΡΡ Π΄ΠΎ ΠΌΠ΅ΡΡΡΠ°) ΠΈ ΠΎΠ±ΠΎΡΡΡΠ΅Π½ΠΈΠ΅ΠΌ ΠΈΠΌΠ΅ΡΡΠΈΡ ΡΡ Ρ ΡΠΎΠ½ΠΈΡΠ΅ΡΠΊΠΈΡ Π·Π°Π±ΠΎΠ»Π΅Π²Π°Π½ΠΈΠΉ. ΠΠΎΡΠΏΠ°Π»Π΅Π½ΠΈΠ΅ ΡΠ΅Π³ΠΈΠΎΠ½Π°ΡΠ½ΡΡ Π»ΠΈΠΌΡΠΎΡΠ·Π»ΠΎΠ² ΠΎΠ±ΡΡΠ½ΠΎ Π½Π΅ ΠΎΡΠΌΠ΅ΡΠ°Π΅ΡΡΡ. Π‘ΡΠΈΡ Π°Π½ΠΈΠ΅ ΠΊΠ»ΠΈΠ½ΠΈΡΠ΅ΡΠΊΠΎΠΉ ΡΠΈΠΌΠΏΡΠΎΠΌΠ°ΡΠΈΠΊΠΈ ΠΏΡΠΎΠΈΡΡ ΠΎΠ΄ΠΈΡ ΠΌΠ΅Π΄Π»Π΅Π½Π½ΠΎ, Π½Π΅ΡΠ΅Π΄ΠΊΠΈ ΡΠ΅ΡΠΈΠ΄ΠΈΠ²Ρ: ΡΠ°Π½Π½ΠΈΠ΅ (Π² ΠΏΠ΅ΡΠ²ΡΠ΅ ΠΏΠΎΠ» Π³ΠΎΠ΄Π°) ΠΈ ΠΏΠΎΠ·Π΄Π½ΠΈΠ΅. Π§Π°ΡΡΠΎΡΠ° ΡΠ΅ΡΠΈΠ΄ΠΈΠ²ΠΎΠ² ΡΠ°ΠΊ ΠΆΠ΅ Π²Π°ΡΡΠΈΡΡΠ΅ΡΡΡ ΠΎΡ ΡΠ΅Π΄ΠΊΠΈΡ ΡΠΏΠΈΠ·ΠΎΠ΄ΠΎΠ², Π΄ΠΎ ΡΠ°ΡΡΡΡ (3 ΠΈ Π±ΠΎΠ»Π΅Π΅ ΡΠ°Π· Π·Π° Π³ΠΎΠ΄) ΠΎΠ±ΠΎΡΡΡΠ΅Π½ΠΈΠΉ. Π§Π°ΡΡΠΎ ΡΠ΅ΡΠΈΠ΄ΠΈΠ²ΠΈΡΡΡΡΠ°Ρ ΡΠΎΠΆΠ° ΡΡΠΈΡΠ°Π΅ΡΡΡ Ρ ΡΠΎΠ½ΠΈΡΠ΅ΡΠΊΠΎΠΉ, ΠΏΡΠΈ ΡΡΠΎΠΌ ΠΈΠ½ΡΠΎΠΊΡΠΈΠΊΠ°ΡΠΈΡ, Π·Π°ΡΠ°ΡΡΡΡ, ΡΡΠ°Π½ΠΎΠ²ΠΈΡΡΡ Π΄ΠΎΠ²ΠΎΠ»ΡΠ½ΠΎ ΡΠΌΠ΅ΡΠ΅Π½Π½ΠΎΠΉ, ΡΡΠΈΡΠ΅ΠΌΠ° Π½Π΅ ΠΈΠΌΠ΅Π΅Ρ ΡΠ΅ΡΠΊΠΈΡ Π³ΡΠ°Π½ΠΈΡ ΠΈ Π±ΠΎΠ»Π΅Π΅ Π±Π»Π΅Π΄Π½Π°Ρ, Π»ΠΈΠΌΡΠΎΡΠ·Π»Ρ Π½Π΅ ΠΈΠ·ΠΌΠ΅Π½Π΅Π½Ρ.
ΠΡΠ»ΠΎΠΆΠ½Π΅Π½ΠΈΡ ΡΠΎΠΆΠΈΡΡΠΎΠ³ΠΎ Π²ΠΎΡΠΏΠ°Π»Π΅Π½ΠΈΡ
ΠΠ°ΠΈΠ±ΠΎΠ»Π΅Π΅ ΡΠ°ΡΡΡΠΌΠΈ ΠΎΡΠ»ΠΎΠΆΠ½Π΅Π½ΠΈΡΠΌΠΈ ΡΠΎΠΆΠΈ ΡΠ²Π»ΡΡΡΡΡ Π½Π°Π³Π½ΠΎΠ΅Π½ΠΈΡ: Π°Π±ΡΡΠ΅ΡΡΡ ΠΈ ΡΠ»Π΅Π³ΠΌΠΎΠ½Ρ, Π° ΡΠ°ΠΊΠΆΠ΅ Π½Π΅ΠΊΡΠΎΡΠΈΡΠ΅ΡΠΊΠΈΠ΅ ΠΏΠΎΡΠ°ΠΆΠ΅Π½ΠΈΡ ΠΌΠ΅ΡΡΠ½ΠΎΠ³ΠΎ ΠΎΡΠ°Π³Π°, ΡΠ·Π²Ρ, ΠΏΡΡΡΡΠ»Ρ, Π²ΠΎΡΠΏΠ°Π»Π΅Π½ΠΈΡ Π²Π΅Π½ (ΡΠ»Π΅Π±ΠΈΡΡ ΠΈ ΡΡΠΎΠΌΠ±ΠΎΡΠ»Π΅Π±ΠΈΡΡ). ΠΠ½ΠΎΠ³Π΄Π° ΡΠ°Π·Π²ΠΈΠ²Π°Π΅ΡΡΡ Π²ΡΠΎΡΠΈΡΠ½Π°Ρ ΠΏΠ½Π΅Π²ΠΌΠΎΠ½ΠΈΡ, ΠΏΡΠΈ Π·Π½Π°ΡΠΈΡΠ΅Π»ΡΠ½ΠΎΠΌ ΠΎΡΠ»Π°Π±Π»Π΅Π½ΠΈΠΈ ΠΎΡΠ³Π°Π½ΠΈΠ·ΠΌΠ° Π²ΠΎΠ·ΠΌΠΎΠΆΠ΅Π½ ΡΠ΅ΠΏΡΠΈΡ.
ΠΠ»ΠΈΡΠ΅Π»ΡΠ½ΠΎ ΡΡΡΠ΅ΡΡΠ²ΡΡΡΠΈΠΉ Π·Π°ΡΡΠΎΠΉ Π»ΠΈΠΌΡΡ, Π² ΠΎΡΠΎΠ±Π΅Π½Π½ΠΎΡΡΠΈ ΠΏΡΠΈ ΡΠ΅ΡΠΈΠ΄ΠΈΠ²ΠΈΡΡΡΡΠ΅ΠΉ ΡΠΎΡΠΌΠ΅, ΡΠΏΠΎΡΠΎΠ±ΡΡΠ²ΡΠ΅Ρ Π²ΠΎΠ·Π½ΠΈΠΊΠ½ΠΎΠ²Π΅Π½ΠΈΡ Π»ΠΈΠΌΡΠ΅Π΄Π΅ΠΌΡ ΠΈ ΡΠ»ΠΎΠ½ΠΎΠ²ΠΎΡΡΠΈ. Π ΠΎΡΠ»ΠΎΠΆΠ½Π΅Π½ΠΈΡΠΌ Π»ΠΈΠΌΡΠΎΡΡΠ°Π·Π° ΡΠ°ΠΊΠΆΠ΅ ΠΎΡΠ½ΠΎΡΡΡ Π³ΠΈΠΏΠ΅ΡΠΊΠ΅ΡΠ°ΡΠΎΠ·, ΠΏΠ°ΠΏΠΈΠ»Π»ΠΎΠΌΡ, ΡΠΊΠ·Π΅ΠΌΡ, Π»ΠΈΠΌΡΠΎΡΠ΅Ρ. ΠΠ° ΠΊΠΎΠΆΠ΅ ΠΏΠΎΡΠ»Π΅ ΠΊΠ»ΠΈΠ½ΠΈΡΠ΅ΡΠΊΠΎΠ³ΠΎ Π²ΡΠ·Π΄ΠΎΡΠΎΠ²Π»Π΅Π½ΠΈΡ ΠΌΠΎΠΆΠ΅Ρ ΠΎΡΡΠ°ΡΡΡΡ ΡΡΠΎΠΉΠΊΠ°Ρ ΠΏΠΈΠ³ΠΌΠ΅Π½ΡΠ°ΡΠΈΡ.
ΠΠΈΠ°Π³Π½ΠΎΡΡΠΈΠΊΠ° ΡΠΎΠΆΠΈΡΡΠΎΠ³ΠΎ Π²ΠΎΡΠΏΠ°Π»Π΅Π½ΠΈΡ
ΠΠΈΠ°Π³Π½ΠΎΡΡΠΈΠΊΠ° ΡΠΎΠΆΠΈ ΠΎΠ±ΡΡΠ½ΠΎ ΠΎΡΡΡΠ΅ΡΡΠ²Π»ΡΠ΅ΡΡΡ Π½Π° ΠΎΡΠ½ΠΎΠ²Π°Π½ΠΈΠΈ ΠΊΠ»ΠΈΠ½ΠΈΡΠ΅ΡΠΊΠΎΠΉ ΡΠΈΠΌΠΏΡΠΎΠΌΠ°ΡΠΈΠΊΠΈ. ΠΠ»Ρ Π΄ΠΈΡΡΠ΅ΡΠ΅Π½ΡΠΈΠ°ΡΠΈΠΈ ΡΠΎΠΆΠΈΡΡΠΎΠ³ΠΎ Π²ΠΎΡΠΏΠ°Π»Π΅Π½ΠΈΡ ΠΎΡ Π΄ΡΡΠ³ΠΈΡ ΠΊΠΎΠΆΠ½ΡΡ Π·Π°Π±ΠΎΠ»Π΅Π²Π°Π½ΠΈΠΉ ΠΌΠΎΠΆΠ΅Ρ ΠΏΠΎΡΡΠ΅Π±ΠΎΠ²Π°ΡΡΡΡ ΠΊΠΎΠ½ΡΡΠ»ΡΡΠ°ΡΠΈΡ Π΄Π΅ΡΠΌΠ°ΡΠΎΠ»ΠΎΠ³Π°. ΠΠ°Π±ΠΎΡΠ°ΡΠΎΡΠ½ΡΠ΅ Π°Π½Π°Π»ΠΈΠ·Ρ ΠΏΠΎΠΊΠ°Π·ΡΠ²Π°ΡΡ ΠΏΡΠΈΠ·Π½Π°ΠΊΠΈ Π±Π°ΠΊΡΠ΅ΡΠΈΠ°Π»ΡΠ½ΠΎΠΉ ΠΈΠ½ΡΠ΅ΠΊΡΠΈΠΈ. Π‘ΠΏΠ΅ΡΠΈΡΠΈΡΠ΅ΡΠΊΡΡ Π΄ΠΈΠ°Π³Π½ΠΎΡΡΠΈΠΊΡ ΠΈ Π²ΡΠ΄Π΅Π»Π΅Π½ΠΈΠ΅ Π²ΠΎΠ·Π±ΡΠ΄ΠΈΡΠ΅Π»Ρ, ΠΊΠ°ΠΊ ΠΏΡΠ°Π²ΠΈΠ»ΠΎ, Π½Π΅ ΠΏΡΠΎΠΈΠ·Π²ΠΎΠ΄ΡΡ.
ΠΠ΅ΡΠ΅Π½ΠΈΠ΅ ΡΠΎΠΆΠΈΡΡΠΎΠ³ΠΎ Π²ΠΎΡΠΏΠ°Π»Π΅Π½ΠΈΡ
Π ΠΎΠΆΠΈΡΡΠΎΠ΅ Π²ΠΎΡΠΏΠ°Π»Π΅Π½ΠΈΠ΅ ΠΎΠ±ΡΡΠ½ΠΎ Π»Π΅ΡΠ°Ρ Π°ΠΌΠ±ΡΠ»Π°ΡΠΎΡΠ½ΠΎ. Π ΡΡΠΆΠ΅Π»ΡΡ ΡΠ»ΡΡΠ°ΡΡ , ΠΏΡΠΈ ΡΠ°Π·Π²ΠΈΡΠΈΠΈ Π³Π½ΠΎΠΉΠ½ΠΎ-Π½Π΅ΠΊΡΠΎΡΠΈΡΠ΅ΡΠΊΠΈΡ ΠΎΡΠ»ΠΎΠΆΠ½Π΅Π½ΠΈΠΉ, ΡΠ°ΡΡΡΡ ΡΠ΅ΡΠΈΠ΄ΠΈΠ²ΠΎΠ², Π² ΡΡΠ°ΡΡΠ΅ΡΠΊΠΎΠΌ ΠΈ ΡΠ°Π½Π½Π΅ΠΌ Π΄Π΅ΡΡΠΊΠΎΠΌ Π²ΠΎΠ·ΡΠ°ΡΡΠ΅ ΠΏΠΎΠΊΠ°Π·Π°Π½ΠΎ ΠΏΠΎΠΌΠ΅ΡΠ΅Π½ΠΈΠ΅ Π±ΠΎΠ»ΡΠ½ΠΎΠ³ΠΎ Π² ΡΡΠ°ΡΠΈΠΎΠ½Π°Ρ. ΠΡΠΈΠΎΡΡΠΎΠΏΠ½Π°Ρ ΡΠ΅ΡΠ°ΠΏΠΈΡ Π·Π°ΠΊΠ»ΡΡΠ°Π΅ΡΡΡ Π² Π½Π°Π·Π½Π°ΡΠ΅Π½ΠΈΠΈ ΠΊΡΡΡΠ° Π°Π½ΡΠΈΠ±ΠΈΠΎΡΠΈΠΊΠΎΠ² ΡΠ΅ΡΠ°Π»ΠΎΡΠΏΠΎΡΠΈΠ½ΠΎΠ²ΠΎΠ³ΠΎ ΡΡΠ΄Π° ΠΏΠ΅ΡΠ²ΠΎΠ³ΠΎ ΠΈ Π²ΡΠΎΡΠΎΠ³ΠΎ ΠΏΠΎΠΊΠΎΠ»Π΅Π½ΠΈΠΉ, ΠΏΠ΅Π½ΠΈΡΠΈΠ»Π»ΠΈΠ½ΠΎΠ², Π½Π΅ΠΊΠΎΡΠΎΡΡΡ ΠΌΠ°ΠΊΡΠΎΠ»ΠΈΠ΄ΠΎΠ², ΡΡΠΎΡΡ ΠΈΠ½ΠΎΠ»ΠΎΠ½ΠΎΠ² Π΄Π»ΠΈΡΠ΅Π»ΡΠ½ΠΎΡΡΡΡ 7-10 Π΄Π½Π΅ΠΉ Π² ΡΡΠ΅Π΄Π½Π΅ΡΠ΅ΡΠ°ΠΏΠ΅Π²ΡΠΈΡΠ΅ΡΠΊΠΈΡ Π΄ΠΎΠ·ΠΈΡΠΎΠ²ΠΊΠ°Ρ . ΠΡΠΈΡΡΠΎΠΌΠΈΡΠΈΠ½, ΠΎΠ»Π΅Π°Π½Π΄ΠΎΠΌΠΈΡΠΈΠ½, Π½ΠΈΡΡΠΎΡΡΡΠ°Π½Ρ ΠΈ ΡΡΠ»ΡΡΠ°Π½ΠΈΠ»Π°ΠΌΠΈΠ΄Ρ ΠΌΠ΅Π½Π΅Π΅ ΡΡΡΠ΅ΠΊΡΠΈΠ²Π½Ρ.
ΠΡΠΈ ΡΠ°ΡΡΡΡ ΡΠ΅ΡΠΈΠ΄ΠΈΠ²Π°Ρ ΡΠ΅ΠΊΠΎΠΌΠ΅Π½Π΄ΠΎΠ²Π°Π½ΠΎ ΠΏΠΎΡΠ»Π΅Π΄ΠΎΠ²Π°ΡΠ΅Π»ΡΠ½ΠΎΠ΅ Π½Π°Π·Π½Π°ΡΠ΅Π½ΠΈΠ΅ Π΄Π²ΡΡ Π²ΠΈΠ΄ΠΎΠ² Π°Π½ΡΠΈΠ±ΠΈΠΎΡΠΈΠΊΠΎΠ² ΡΠ°Π·Π½ΡΡ Π³ΡΡΠΏΠΏ: ΠΏΠΎΡΠ»Π΅ Π±Π΅ΡΠ°-Π»Π°ΠΊΡΠ°ΠΌΠΎΠ² ΠΏΡΠΈΠΌΠ΅Π½ΡΡΡ Π»ΠΈΠ½ΠΊΠΎΠΌΠΈΡΠΈΠ½. ΠΠ°ΡΠΎΠ³Π΅Π½Π΅ΡΠΈΡΠ΅ΡΠΊΠΎΠ΅ Π»Π΅ΡΠ΅Π½ΠΈΠ΅ Π²ΠΊΠ»ΡΡΠ°Π΅Ρ Π΄Π΅Π·ΠΈΠ½ΡΠΎΠΊΡΠΈΠΊΠ°ΡΠΈΠΎΠ½Π½ΡΡ ΠΈ Π²ΠΈΡΠ°ΠΌΠΈΠ½ΠΎΡΠ΅ΡΠ°ΠΏΠΈΡ, Π°Π½ΡΠΈΠ³ΠΈΡΡΠ°ΠΌΠΈΠ½Π½ΡΠ΅ ΡΡΠ΅Π΄ΡΡΠ²Π°. ΠΡΠΈ Π±ΡΠ»Π»Π΅Π·Π½ΡΡ ΡΠΎΡΠΌΠ°Ρ ΡΠΎΠΆΠΈ ΠΏΡΠΎΠΈΠ·Π²ΠΎΠ΄ΡΡ Π²ΡΠΊΡΡΡΠΈΠ΅ ΠΏΡΠ·ΡΡΠ΅ΠΉ ΠΈ Π½Π°ΠΊΠ»Π°Π΄ΡΠ²Π°ΡΡ ΡΠ°ΡΡΠΎ ΡΠΌΠ΅Π½ΡΠ΅ΠΌΡΠ΅ ΠΌΠ°ΡΠ»Π΅Π²ΡΠ΅ ΡΠ°Π»ΡΠ΅ΡΠΊΠΈ Ρ Π°Π½ΡΠΈΡΠ΅ΠΏΡΠΈΡΠ΅ΡΠΊΠΈΠΌΠΈ ΡΡΠ΅Π΄ΡΡΠ²Π°ΠΌΠΈ. ΠΠ°Π·ΠΈ Π½Π΅ ΠΏΡΠΎΠΏΠΈΡΡΠ²Π°ΡΡ, ΡΡΠΎΠ±Ρ Π»ΠΈΡΠ½ΠΈΠΉ ΡΠ°Π· Π½Π΅ ΡΠ°Π·Π΄ΡΠ°ΠΆΠ°ΡΡ ΠΊΠΎΠΆΡ ΠΈ Π½Π΅ Π·Π°ΠΌΠ΅Π΄Π»ΡΡΡ Π·Π°ΠΆΠΈΠ²Π»Π΅Π½ΠΈΠ΅. ΠΠΎΠ³ΡΡ Π±ΡΡΡ ΡΠ΅ΠΊΠΎΠΌΠ΅Π½Π΄ΠΎΠ²Π°Π½Ρ ΠΏΡΠ΅ΠΏΠ°ΡΠ°ΡΡ ΠΌΠ΅ΡΡΠ½ΠΎΠ³ΠΎ ΠΏΡΠΈΠΌΠ΅Π½Π΅Π½ΠΈΡ: Π΄Π΅ΠΊΡΠΏΠ°Π½ΡΠ΅Π½ΠΎΠ», ΡΡΠ»ΡΡΠ°Π΄ΠΈΠ°Π·ΠΈΠ½ ΡΠ΅ΡΠ΅Π±ΡΠ°. Π ΠΊΠ°ΡΠ΅ΡΡΠ²Π΅ ΡΡΠ΅Π΄ΡΡΠ²Π°, ΡΠΏΠΎΡΠΎΠ±ΡΡΠ²ΡΡΡΠ΅Π³ΠΎ ΡΡΠΊΠΎΡΠ΅Π½ΠΈΡ ΡΠ΅Π³ΡΠ΅ΡΡΠ° ΠΊΠΎΠΆΠ½ΡΡ ΠΏΡΠΎΡΠ²Π»Π΅Π½ΠΈΠΉ, ΡΠ΅ΠΊΠΎΠΌΠ΅Π½Π΄ΠΎΠ²Π°Π½Π° ΡΠΈΠ·ΠΈΠΎΡΠ΅ΡΠ°ΠΏΠΈΡ (Π£ΠΠ§, Π£Π€Π, ΠΏΠ°ΡΠ°ΡΠΈΠ½, ΠΎΠ·ΠΎΠΊΠ΅ΡΠΈΡ ΠΈ Ρ. Π΄.).
Π Π½Π΅ΠΊΠΎΡΠΎΡΡΡ ΡΠ»ΡΡΠ°ΡΡ ΡΠ΅ΡΠΈΠ΄ΠΈΠ²ΠΈΡΡΡΡΠΈΡ ΡΠΎΡΠΌ Π±ΠΎΠ»ΡΠ½ΡΠΌ Π½Π°Π·Π½Π°ΡΠ°ΡΡ ΠΊΡΡΡΡ ΠΏΡΠΎΡΠΈΠ²ΠΎΡΠ΅ΡΠΈΠ΄ΠΈΠ²Π½ΠΎΠ³ΠΎ Π»Π΅ΡΠ΅Π½ΠΈΡ Π±Π΅Π½Π·ΠΈΠ»ΠΏΠ΅Π½ΠΈΡΠΈΠ»Π»ΠΈΠ½ΠΎΠΌ Π²Π½ΡΡΡΠΈΠΌΡΡΠ΅ΡΠ½ΠΎ ΡΠ°Π· Π² ΡΡΠΈ Π½Π΅Π΄Π΅Π»ΠΈ. Π£ΠΏΠΎΡΠ½ΠΎ ΡΠ΅ΡΠΈΠ΄ΠΈΠ²ΠΈΡΡΡΡΠ°Ρ ΡΠΎΠΆΠ° Π½Π΅ΡΠ΅Π΄ΠΊΠΎ Π»Π΅ΡΠΈΡΡΡ ΠΊΡΡΡΠ°ΠΌΠΈ ΠΈΠ½ΡΠ΅ΠΊΡΠΈΠΉ Π½Π° ΠΏΡΠΎΡΡΠΆΠ΅Π½ΠΈΠΈ Π΄Π²ΡΡ Π»Π΅Ρ. ΠΡΠΈ ΠΈΠΌΠ΅ΡΡΠΈΡ ΡΡ ΠΎΡΡΠ°ΡΠΎΡΠ½ΡΡ ΡΠ²Π»Π΅Π½ΠΈΡΡ ΠΏΠΎΡΠ»Π΅ Π²ΡΠΏΠΈΡΠΊΠΈ Π±ΠΎΠ»ΡΠ½ΡΠΌ ΠΌΠΎΠ³ΡΡ Π½Π°Π·Π½Π°ΡΠ°ΡΡ ΠΊΡΡΡ Π°Π½ΡΠΈΠ±ΠΈΠΎΡΠΈΠΊΠΎΡΠ΅ΡΠ°ΠΏΠΈΠΈ Π½Π° ΡΡΠΎΠΊ Π΄ΠΎ ΠΏΠΎΠ»ΡΠ³ΠΎΠ΄Π°.
ΠΡΠΎΠ³Π½ΠΎΠ· ΠΈ ΠΏΡΠΎΡΠΈΠ»Π°ΠΊΡΠΈΠΊΠ° ΡΠΎΠΆΠΈΡΡΠΎΠ³ΠΎ Π²ΠΎΡΠΏΠ°Π»Π΅Π½ΠΈΡ
Π ΠΎΠΆΠΈΡΡΠΎΠ΅ Π²ΠΎΡΠΏΠ°Π»Π΅Π½ΠΈΠ΅ ΡΠΈΠΏΠΈΡΠ½ΠΎΠ³ΠΎ ΡΠ΅ΡΠ΅Π½ΠΈΡ ΠΎΠ±ΡΡΠ½ΠΎ ΠΈΠΌΠ΅Π΅Ρ Π±Π»Π°Π³ΠΎΠΏΡΠΈΡΡΠ½ΡΠΉ ΠΏΡΠΎΠ³Π½ΠΎΠ· ΠΈ ΠΏΡΠΈ Π°Π΄Π΅ΠΊΠ²Π°ΡΠ½ΠΎΠΉ ΡΠ΅ΡΠ°ΠΏΠΈΠΈ Π·Π°ΠΊΠ°Π½ΡΠΈΠ²Π°Π΅ΡΡΡ Π²ΡΠ·Π΄ΠΎΡΠΎΠ²Π»Π΅Π½ΠΈΠ΅ΠΌ. ΠΠ΅Π½Π΅Π΅ Π±Π»Π°Π³ΠΎΠΏΡΠΈΡΡΠ½ΡΠΉ ΠΏΡΠΎΠ³Π½ΠΎΠ· Π±ΡΠ²Π°Π΅Ρ Π² ΡΠ»ΡΡΠ°Π΅ ΡΠ°Π·Π²ΠΈΡΠΈΡ ΠΎΡΠ»ΠΎΠΆΠ½Π΅Π½ΠΈΠΉ, ΡΠ»ΠΎΠ½ΠΎΠ²ΠΎΡΡΠΈ ΠΈ ΡΠ°ΡΡΡΡ ΡΠ΅ΡΠΈΠ΄ΠΈΠ²Π°Ρ . Π£Ρ ΡΠ΄ΡΠ°Π΅ΡΡΡ ΠΏΡΠΎΠ³Π½ΠΎΠ· ΠΈ Ρ ΠΎΡΠ»Π°Π±Π»Π΅Π½Π½ΡΡ Π±ΠΎΠ»ΡΠ½ΡΡ , Π»ΠΈΡ ΡΡΠ°ΡΡΠ΅ΡΠΊΠΎΠ³ΠΎ Π²ΠΎΠ·ΡΠ°ΡΡΠ°, Π»ΡΠ΄Π΅ΠΉ, ΡΡΡΠ°Π΄Π°ΡΡΠΈΡ Π°Π²ΠΈΡΠ°ΠΌΠΈΠ½ΠΎΠ·Π°ΠΌΠΈ, Ρ ΡΠΎΠ½ΠΈΡΠ΅ΡΠΊΠΈΠΌΠΈ Π·Π°Π±ΠΎΠ»Π΅Π²Π°Π½ΠΈΡΠΌΠΈ Ρ ΠΈΠ½ΡΠΎΠΊΡΠΈΠΊΠ°ΡΠΈΠ΅ΠΉ, ΡΠ°ΡΡΡΡΠΎΠΉΡΡΠ²Π°ΠΌΠΈ ΠΏΠΈΡΠ΅Π²Π°ΡΠ΅Π½ΠΈΡ ΠΈ Π»ΠΈΠΌΡΠΎΠ²Π΅Π½ΠΎΠ·Π½ΠΎΠ³ΠΎ Π°ΠΏΠΏΠ°ΡΠ°ΡΠ°, ΠΈΠΌΠΌΡΠ½ΠΎΠ΄Π΅ΡΠΈΡΠΈΡΠΎΠΌ.
ΠΠ±ΡΠ°Ρ ΠΏΡΠΎΡΠΈΠ»Π°ΠΊΡΠΈΠΊΠ° ΡΠΎΠΆΠΈ Π²ΠΊΠ»ΡΡΠ°Π΅Ρ ΠΌΠ΅ΡΡ ΠΏΠΎ ΡΠ°Π½ΠΈΡΠ°ΡΠ½ΠΎ-Π³ΠΈΠ³ΠΈΠ΅Π½ΠΈΡΠ΅ΡΠΊΠΎΠΌΡ ΡΠ΅ΠΆΠΈΠΌΡ Π»Π΅ΡΠ΅Π±Π½ΠΎ-ΠΏΡΠΎΡΠΈΠ»Π°ΠΊΡΠΈΡΠ΅ΡΠΊΠΈΡ ΡΡΡΠ΅ΠΆΠ΄Π΅Π½ΠΈΠΉ, ΡΠΎΠ±Π»ΡΠ΄Π΅Π½ΠΈΠ΅ ΠΏΡΠ°Π²ΠΈΠ» Π°ΡΠ΅ΠΏΡΠΈΠΊΠΈ ΠΈ Π°Π½ΡΠΈΡΠ΅ΠΏΡΠΈΠΊΠΈ ΠΏΡΠΈ ΠΎΠ±ΡΠ°Π±ΠΎΡΠΊΠ΅ ΡΠ°Π½ ΠΈ ΡΡΠ°Π΄ΠΈΠ½, ΠΏΡΠΎΡΠΈΠ»Π°ΠΊΡΠΈΠΊΡ ΠΈ Π»Π΅ΡΠ΅Π½ΠΈΠ΅ Π³Π½ΠΎΠΉΠ½ΠΈΡΠΊΠΎΠ²ΡΡ Π·Π°Π±ΠΎΠ»Π΅Π²Π°Π½ΠΈΠΉ, ΠΊΠ°ΡΠΈΠ΅ΡΠ°, ΡΡΡΠ΅ΠΏΡΠΎΠΊΠΎΠΊΠΊΠΎΠ²ΡΡ ΠΈΠ½ΡΠ΅ΠΊΡΠΈΠΉ. ΠΠ½Π΄ΠΈΠ²ΠΈΠ΄ΡΠ°Π»ΡΠ½Π°Ρ ΠΏΡΠΎΡΠΈΠ»Π°ΠΊΡΠΈΠΊΠ° Π·Π°ΠΊΠ»ΡΡΠ°Π΅ΡΡΡ Π² ΡΠΎΠ±Π»ΡΠ΄Π΅Π½ΠΈΠΈ Π»ΠΈΡΠ½ΠΎΠΉ Π³ΠΈΠ³ΠΈΠ΅Π½Ρ ΠΈ ΡΠ²ΠΎΠ΅Π²ΡΠ΅ΠΌΠ΅Π½Π½ΠΎΠΉ ΠΎΠ±ΡΠ°Π±ΠΎΡΠΊΠ΅ ΠΏΠΎΠ²ΡΠ΅ΠΆΠ΄Π΅Π½ΠΈΠΉ ΠΊΠΎΠΆΠΈ Π΄Π΅Π·ΠΈΠ½ΡΠΈΡΠΈΡΡΡΡΠΈΠΌΠΈ ΡΡΠ΅Π΄ΡΡΠ²Π°ΠΌΠΈ.
www.krasotaimedicina.ru
Π ΠΎΠΆΠΈΡΡΠΎΠ΅ Π²ΠΎΡΠΏΠ°Π»Π΅Π½ΠΈΠ΅ (Π ΠΎΠΆΠ°) Π½Π° Π½ΠΎΠ³Π΅, ΡΡΠΊΠ΅, Π»ΠΈΡΠ΅. ΠΠΎΠ·Π±ΡΠ΄ΠΈΡΠ΅Π»Ρ. Π‘ΠΈΠΌΠΏΡΠΎΠΌΡ. Π€ΠΎΡΠΌΡ. ΠΠ½ΠΎΠ³ΠΎ ΡΠΎΡΠΎ
Π‘ΡΠ°ΡΡΠΈ ΡΠ°Π·Π΄Π΅Π»Π° «Π ΠΎΠΆΠΈΡΡΠΎΠ΅ Π²ΠΎΡΠΏΠ°Π»Π΅Π½ΠΈΠ΅ (ΡΠΎΠΆΠ°)»
ΒΠ ΠΎΠΆΠΈΡΡΠΎΠ΅ Π²ΠΎΡΠΏΠ°Π»Π΅Π½ΠΈΠ΅ ΠΈΠ»ΠΈ ΡΠΎΠΆΠ° (ΠΎΡ ΠΏΠΎΠ»ΡΡΠΊΠΎΠ³ΠΎ rΓ³ΕΌa) β ΡΡΠΎ ΠΈΠ½ΡΠ΅ΠΊΡΠΈΠΎΠ½Π½ΠΎΠ΅, Π΄ΠΎΠ²ΠΎΠ»ΡΠ½ΠΎ ΡΠ°ΡΠΏΡΠΎΡΡΡΠ°Π½Π΅Π½Π½ΠΎΠ΅ Π·Π°Π±ΠΎΠ»Π΅Π²Π°Π½ΠΈΠ΅ ΠΊΠΎΠΆΠΈ ΠΈ ΡΠ»ΠΈΠ·ΠΈΡΡΡΡ ΠΎΠ±ΠΎΠ»ΠΎΡΠ΅ΠΊ. ΠΠ° Π»Π°ΡΠΈΠ½ΡΠΊΠΎΠΌ ΡΠ·ΡΠΊΠ΅ β erysipelas (erythros Π² ΠΏΠ΅ΡΠ΅Π²ΠΎΠ΄Π΅ Ρ Π³ΡΠ΅ΡΠ΅ΡΠΊΠΎΠ³ΠΎ β ΠΊΡΠ°ΡΠ½ΡΠΉ, pellis β ΠΊΠΎΠΆΠ°). Π‘ΡΠ΅Π΄ΠΈ Π²ΡΠ΅Ρ ΠΈΠ½ΡΠ΅ΠΊΡΠΈΠΎΠ½Π½ΡΡ Π·Π°Π±ΠΎΠ»Π΅Π²Π°Π½ΠΈΠΉ ΡΠΎΠΆΠΈΡΡΠΎΠ΅ Π²ΠΎΡΠΏΠ°Π»Π΅Π½ΠΈΠ΅ Π·Π°Π½ΠΈΠΌΠ°Π΅Ρ ΡΠ΅ΡΠ²Π΅ΡΡΠΎΠ΅ ΠΌΠ΅ΡΡΠΎ ΠΈ ΡΠ΅Π³ΠΎΠ΄Π½Ρ ΡΠ²Π»ΡΠ΅ΡΡΡ ΠΎΠ΄Π½ΠΎΠΉ ΠΈΠ· Π°ΠΊΡΡΠ°Π»ΡΠ½ΡΡ ΠΏΡΠΎΠ±Π»Π΅ΠΌ Π² Π·Π΄ΡΠ°Π²ΠΎΠΎΡ ΡΠ°Π½Π΅Π½ΠΈΠΈ. ΠΡΠΈΡΠΈΠ½ΠΎΠΉ ΡΠΎΠΆΠΈΡΡΠΎΠ³ΠΎ Π²ΠΎΡΠΏΠ°Π»Π΅Π½ΠΈΡ ΡΠ²Π»ΡΠ΅ΡΡΡ Π±Π΅ΡΠ°-Π³Π΅ΠΌΠΎΠ»ΠΈΡΠΈΡΠ΅ΡΠΊΠΈΠΉ ΡΡΡΠ΅ΠΏΡΠΎΠΊΠΎΠΊΠΊ Π³ΡΡΠΏΠΏΡ Π. ΠΠΎΠ»ΡΠ½ΡΠ΅ Π»ΠΈΡΠ° ΠΈ Π·Π΄ΠΎΡΠΎΠ²ΡΠ΅ Π½ΠΎΡΠΈΡΠ΅Π»ΠΈ ΡΠ²Π»ΡΡΡΡΡ ΠΈΡΡΠΎΡΠ½ΠΈΠΊΠ°ΠΌΠΈ ΠΈΠ½ΡΠ΅ΠΊΡΠΈΠΈ. ΠΠ°Π±ΠΎΠ»Π΅Π²Π°Π½ΠΈΠ΅ Ρ Π°ΡΠ°ΠΊΡΠ΅ΡΠΈΠ·ΡΠ΅ΡΡΡ Π²ΡΡΠ°ΠΆΠ΅Π½Π½ΠΎΠΉ Π»ΠΈΡ ΠΎΡΠ°Π΄ΠΊΠΎΠΉ, ΡΠΈΠΌΠΏΡΠΎΠΌΠ°ΠΌΠΈ ΠΈΠ½ΡΠΎΠΊΡΠΈΠΊΠ°ΡΠΈΠΈ ΠΈ ΠΏΠΎΡΠ²Π»Π΅Π½ΠΈΠ΅ΠΌ Π½Π° ΠΊΠΎΠΆΠ½ΡΡ ΠΏΠΎΠΊΡΠΎΠ²Π°Ρ ΠΈΠ»ΠΈ ΡΠ»ΠΈΠ·ΠΈΡΡΡΡ ΠΎΠ±ΠΎΠ»ΠΎΡΠΊΠ°Ρ ΡΡΠ°ΡΡΠΊΠΎΠ² Π²ΠΎΡΠΏΠ°Π»Π΅Π½ΠΈΡ ΡΡΠΊΠΎ ΠΊΡΠ°ΡΠ½ΠΎΠ³ΠΎ ΡΠ²Π΅ΡΠ°.
ΠΡΠ»ΠΎΠΆΠ½Π΅Π½Π½ΡΠ΅ ΡΠΎΡΠΌΡ ΡΠΎΠΆΠΈΡΡΠΎΠ³ΠΎ Π²ΠΎΡΠΏΠ°Π»Π΅Π½ΠΈΡ ΡΠ²Π»ΡΡΡΡΡ ΡΠ°ΠΌΡΠΌΠΈ ΡΡΠΆΠ΅Π»ΡΠΌΠΈ ΠΈΠ½ΡΠ΅ΠΊΡΠΈΡΠΌΠΈ ΠΌΡΠ³ΠΊΠΈΡ ΡΠΊΠ°Π½Π΅ΠΉ. ΠΠ½ΠΈ Ρ Π°ΡΠ°ΠΊΡΠ΅ΡΠΈΠ·ΡΡΡΡΡ Π±ΡΡΡΡΡΠΌ Π½Π°ΡΠ°Π»ΠΎΠΌ, ΡΡΡΠ΅ΠΌΠΈΡΠ΅Π»ΡΠ½ΡΠΌ ΠΏΡΠΎΠ³ΡΠ΅ΡΡΠΈΡΠΎΠ²Π°Π½ΠΈΠ΅ΠΌ ΠΈ ΡΡΠΆΠ΅Π»ΠΎΠΉ ΠΈΠ½ΡΠΎΠΊΡΠΈΠΊΠ°ΡΠΈΠ΅ΠΉ.
ΠΠΎΠ»ΡΠ½ΠΎΠΉ Ρ ΡΠΎΠΆΠΈΡΡΡΠΌ Π²ΠΎΡΠΏΠ°Π»Π΅Π½ΠΈΠ΅ΠΌ ΠΌΠ°Π»ΠΎΠ·Π°ΡΠ°Π·Π΅Π½. ΠΠ°Π±ΠΎΠ»Π΅Π²Π°ΡΡ ΡΠ°ΡΠ΅ ΠΆΠ΅Π½ΡΠΈΠ½Ρ Π² ΠΏΠ΅ΡΠΈΠΎΠ΄ ΡΠ³Π°ΡΠ°Π½ΠΈΡ ΡΠ΅ΠΏΡΠΎΠ΄ΡΠΊΡΠΈΠ²Π½ΠΎΠΉ ΡΡΠ½ΠΊΡΠΈΠΈ. Π£ ΡΡΠ΅ΡΠ΅ΠΉ ΡΠ°ΡΡΠΈ Π±ΠΎΠ»ΡΠ½ΡΡ Π·Π°Π±ΠΎΠ»Π΅Π²Π°Π½ΠΈΠ΅ ΠΏΡΠΈΠΎΠ±ΡΠ΅ΡΠ°Π΅Ρ ΡΠ΅ΡΠΈΠ΄ΠΈΠ²ΠΈΡΡΡΡΠ΅Π΅ ΡΠ΅ΡΠ΅Π½ΠΈΠ΅.
Π ΠΎΠΆΠ° ΠΈΠ·Π²Π΅ΡΡΠ½Π° Ρ Π΄Π°Π²Π½ΠΈΡ Π²ΡΠ΅ΠΌΠ΅Π½. ΠΠ΅ ΠΎΠΏΠΈΡΠ°Π½ΠΈΠ΅ ΠΎΠ±Π½Π°ΡΡΠΆΠ΅Π½ΠΎ ΠΏΡΠΎΠΈΠ·Π²Π΅Π΄Π΅Π½ΠΈΡΡ Π°Π½ΡΠΈΡΠ½ΡΡ Π°Π²ΡΠΎΡΠΎΠ². Π§ΠΈΡΡΠ°Ρ ΠΊΡΠ»ΡΡΡΡΠ° Π²ΠΎΠ·Π±ΡΠ΄ΠΈΡΠ΅Π»Ρ ΡΠΎΠΆΠΈΡΡΠΎΠ³ΠΎ Π²ΠΎΡΠΏΠ°Π»Π΅Π½ΠΈΡ Π²ΡΠ΄Π΅Π»Π΅Π½Π° Π² 1882 Π³ΠΎΠ΄Ρ F. Felleisen. ΠΠ³ΡΠΎΠΌΠ½ΡΠΉ Π²ΠΊΠ»Π°Π΄ Π² ΠΈΠ·ΡΡΠ΅Π½ΠΈΠ΅ Π·Π°Π±ΠΎΠ»Π΅Π²Π°Π½ΠΈΡ Π²Π½Π΅ΡΠ»ΠΈ ΡΠΎΡΡΠΈΠΉΡΠΊΠΈΠ΅ ΡΡΠ΅Π½ΡΠ΅ Π. Π. ΠΠ°Π»ΡΠΏΠ΅ΡΠΈΠ½ ΠΈ Π. Π. Π§Π΅ΡΠΊΠ°ΡΠΎΠ².

Π ΠΈΡ. 1. Π ΠΎΠΆΠ° (erysipelas) Π½Π° Π½ΠΎΠ³Π΅ (ΡΠΎΠΆΠΈΡΡΠΎΠ΅ Π²ΠΎΡΠΏΠ°Π»Π΅Π½ΠΈΠ΅ Π³ΠΎΠ»Π΅Π½ΠΈ).
ΠΠΎΠ·Π±ΡΠ΄ΠΈΡΠ΅Π»Ρ ΡΠΎΠΆΠΈ
Π‘ΡΡΠ΅ΡΡΠ²ΡΠ΅Ρ 20 ΡΠΈΠΏΠΎΠ² (ΡΠ΅ΡΠΎΠ³ΡΡΠΏΠΏ) ΡΡΡΠ΅ΠΏΡΠΎΠΊΠΎΠΊΠΊΠΎΠ². ΠΠ°ΠΈΠ±ΠΎΠ»Π΅Π΅ Π·Π½Π°ΡΠΈΠΌΡΠΌΠΈ ΠΈΠ· Π½ΠΈΡ ΡΠ²Π»ΡΡΡΡΡ ΡΡΡΠ΅ΠΏΡΠΎΠΊΠΎΠΊΠΊΠΈ ΡΠ΅ΡΠΎΠ³ΡΡΠΏΠΏΡ A, B, C, D ΠΈ G. ΠΠ΅ΡΠ°-Π³Π΅ΠΌΠΎΠ»ΠΈΡΠΈΡΠ΅ΡΠΊΠΈΠ΅ ΡΡΡΠ΅ΠΏΡΠΎΠΊΠΎΠΊΠΊΠΈ Π³ΡΡΠΏΠΏΡ Π (Streptococcus pyogenes) ΡΠ²Π»ΡΡΡΡΡ ΠΏΡΠΈΡΠΈΠ½ΠΎΠΉ ΠΌΠ½ΠΎΠΆΠ΅ΡΡΠ²Π° ΠΎΠΏΠ°ΡΠ½ΡΡ Π·Π°Π±ΠΎΠ»Π΅Π²Π°Π½ΠΈΠΉ Ρ ΡΠ΅Π»ΠΎΠ²Π΅ΠΊΠ° β Π³Π½ΠΎΠΉΠ½ΠΈΡΠΊΠΎΠ²ΡΡ Π·Π°Π±ΠΎΠ»Π΅Π²Π°Π½ΠΈΠΉ ΠΊΠΎΠΆΠΈ ΠΈ ΠΌΡΠ³ΠΊΠΈΡ ΡΠΊΠ°Π½Π΅ΠΉ (Π°Π±ΡΡΠ΅ΡΡΡ, ΡΠ»Π΅Π³ΠΌΠΎΠ½Ρ, ΡΡΡΡΠ½ΠΊΡΠ»Ρ ΠΈ ΠΎΡΡΠ΅ΠΎΠΌΠΈΠ΅Π»ΠΈΡ), Π°Π½Π³ΠΈΠ½ ΠΈ ΡΠ°ΡΠΈΠ½Π³ΠΈΡΠΎΠ², Π±ΡΠΎΠ½Ρ ΠΈΡΠΎΠ², ΡΠ΅Π²ΠΌΠ°ΡΠΈΠ·ΠΌΠ°, ΡΠΊΠ°ΡΠ»Π°ΡΠΈΠ½Ρ ΠΈ ΡΠΎΠΊΡΠΈΡΠ΅ΡΠΊΠΎΠ³ΠΎ ΡΠΎΠΊΠ°. ΠΡΠΈΡΠΈΠ½ΠΎΠΉ ΡΠΎΠΆΠΈΡΡΠΎΠ³ΠΎ Π²ΠΎΡΠΏΠ°Π»Π΅Π½ΠΈΡ ΠΌΠΎΠΆΠ΅Ρ ΡΡΠ°ΡΡ Π»ΡΠ±ΠΎΠΉ ΡΠΈΠΏ ΡΡΡΠ΅ΠΏΡΠΎΠΊΠΎΠΊΠΊΠΎΠ² Π³ΡΡΠΏΠΏΡ Π.
ΠΠ°ΠΊΡΠ΅ΡΠΈΠΈ ΠΈΠΌΠ΅ΡΡ ΠΎΠΊΡΡΠ³Π»ΡΡ ΡΠΎΡΠΌΡ. Π Π°ΡΠΏΠΎΠ»Π°Π³Π°ΡΡΡΡ ΡΠ°ΡΠ΅ ΡΠ΅ΠΏΠΎΡΠΊΠ°ΠΌΠΈ, ΡΠ΅ΠΆΠ΅ β ΠΏΠΎΠΏΠ°ΡΠ½ΠΎ. Π Π°Π·ΠΌΠ½ΠΎΠΆΠ°ΡΡΡΡ ΠΏΡΡΠ΅ΠΌ Π΄Π΅Π»Π΅Π½ΠΈΡ Π½Π°Π΄Π²ΠΎΠ΅.
- ΠΠΎ Π²Π½Π΅ΡΠ½Π΅ΠΉ ΡΡΠ΅Π΄Π΅, Π² ΡΠΎΠΌ ΡΠΈΡΠ»Π΅ ΠΌΠΎΠΊΡΠΎΡΠ΅ ΠΈ Π³Π½ΠΎΠ΅, Π±Π°ΠΊΡΠ΅ΡΠΈΠΈ ΡΠΎΡ ΡΠ°Π½ΡΡΡΡΡ ΠΌΠ΅ΡΡΡΠ°ΠΌΠΈ ΠΈ Π²ΡΠΆΠΈΠ²Π°ΡΡ ΠΏΡΠΈ Π½ΠΈΠ·ΠΊΠΈΡ ΡΠ΅ΠΌΠΏΠ΅ΡΠ°ΡΡΡΠ°Ρ ΠΈ Π·Π°ΠΌΠΎΡΠΎΠ·ΠΊΠ΅.
- ΠΡΡΠΎΠΊΠ°Ρ ΡΠ΅ΠΌΠΏΠ΅ΡΠ°ΡΡΡΠ°, ΡΠΎΠ»Π½Π΅ΡΠ½ΡΠΉ ΡΠ²Π΅Ρ ΠΈ Π΄Π΅Π·ΠΈΠ½ΡΠΈΡΠΈΡΡΡΡΠΈΠ΅ ΡΠ°ΡΡΠ²ΠΎΡΡ Π³ΡΠ±ΠΈΡΠ΅Π»ΡΠ½ΠΎ Π΄Π΅ΠΉΡΡΠ²ΡΡΡ Π½Π° ΠΌΠΈΠΊΡΠΎΠ±Ρ.
- Π‘ΡΡΠ΅ΠΏΡΠΎΠΊΠΎΠΊΠΊΠΈ ΠΏΡΠΎΡΠ²Π»ΡΡΡ Π²ΡΡΠΎΠΊΡΡ ΡΡΠ²ΡΡΠ²ΠΈΡΠ΅Π»ΡΠ½ΠΎΡΡΡ ΠΊ Π°Π½ΡΠΈΠ±ΠΈΠΎΡΠΈΠΊΠ°ΠΌ, ΡΡΡΠΎΠΉΡΠΈΠ²ΠΎΡΡΡ ΠΊ ΠΊΠΎΡΠΎΡΡΠΌ Ρ Π½ΠΈΡ Π²ΡΡΠ°Π±Π°ΡΡΠ²Π°Π΅ΡΡΡ ΠΌΠ΅Π΄Π»Π΅Π½Π½ΠΎ.
Π‘ΡΡΠ΅ΠΏΡΠΎΠΊΠΎΠΊΠΊΠΈ Π²ΡΠ΄Π΅Π»ΡΡΡ ΡΠ΅Π»ΡΠΉ ΡΡΠ΄ ΡΠ½Π΄ΠΎ- ΠΈ ΡΠΊΠ·ΠΎΡΠΎΠΊΡΠΈΠ½ΠΎΠ² ΠΈ ΡΠ΅ΡΠΌΠ΅Π½ΡΠΎΠ², ΠΊΠΎΡΠΎΡΡΠ΅ ΠΎΠ±ΡΡΠ»Π°Π²Π»ΠΈΠ²Π°ΡΡ ΠΈΡ ΠΏΠΎΠ²ΡΠ΅ΠΆΠ΄Π°ΡΡΠ΅Π΅ Π΄Π΅ΠΉΡΡΠ²ΠΈΠ΅.

Π ΠΈΡ. 2. Π‘ΡΡΠ΅ΠΏΡΠΎΠΊΠΎΠΊΠΊΠΈ ΠΈΠΌΠ΅ΡΡ ΠΎΠΊΡΡΠ³Π»ΡΡ ΡΠΎΡΠΌΡ. Π Π°ΡΠΏΠΎΠ»Π°Π³Π°ΡΡΡΡ ΡΠ°ΡΠ΅ ΡΠ΅ΠΏΠΎΡΠΊΠ°ΠΌΠΈ, ΡΠ΅ΠΆΠ΅ β ΠΏΠΎΠΏΠ°ΡΠ½ΠΎ.
Π ΠΈΡ. 3. ΠΠ΅ΡΠ°-Π³Π΅ΠΌΠΎΠ»ΠΈΡΠΈΡΠ΅ΡΠΊΠΈΠ΅ ΡΡΡΠ΅ΠΏΡΠΎΠΊΠΎΠΊΠΊΠΈ Π³ΡΡΠΏΠΏΡ Π ΠΏΡΠΈ ΡΠΎΡΡΠ΅ Π½Π° ΠΊΡΠΎΠ²ΡΠ½ΠΎΠΌ Π°Π³Π°ΡΠ΅ ΠΎΠ±ΡΠ°Π·ΡΡΡ Π·ΠΎΠ½Ρ Π³Π΅ΠΌΠΎΠ»ΠΈΠ·Π° (ΡΠ²Π΅ΡΠ»ΡΡ ΠΎΡΠ΅ΠΎΠ»ΠΎΠ²), ΠΏΡΠ΅Π²ΡΡΠ°ΡΡΠΈΠ΅ Π² 2 β 4 ΡΠ°Π·Π° Π΄ΠΈΠ°ΠΌΠ΅ΡΡ ΡΠ°ΠΌΠΈΡ ΠΊΠΎΠ»ΠΎΠ½ΠΈΠΉ.
Π ΠΈΡ. 4. ΠΡΠΈ ΡΠΎΡΡΠ΅ Π½Π° ΠΏΠΈΡΠ°ΡΠ΅Π»ΡΠ½ΡΡ ΡΡΠ΅Π΄Π°Ρ ΠΊΠΎΠ»ΠΎΠ½ΠΈΠΈ ΡΡΡΠ΅ΠΏΡΠΎΠΊΠΎΠΊΠΊΠΎΠ² Π±ΡΠ²Π°ΡΡ Π±Π»Π΅ΡΡΡΡΠΈΠΌΠΈ, ΠΏΠΎ ΡΠΎΡΠΌΠ΅ Π½Π°ΠΏΠΎΠΌΠΈΠ½Π°ΡΡΠΈΠ΅ ΠΊΠ°ΠΏΠ»Ρ, ΠΈΠ»ΠΈ ΡΠ΅ΡΡΠΌΠΈ, ΠΌΠ°ΡΠΎΠ²ΡΠΌΠΈ ΠΈ Π·Π΅ΡΠ½ΠΈΡΡΡΠΌΠΈ Ρ Π½Π΅ΡΠΎΠ²Π½ΡΠΌΠΈ ΠΊΡΠ°ΡΠΌΠΈ, ΠΈΠ»ΠΈ Π²ΡΠΏΡΠΊΠ»ΡΠΌΠΈ ΠΈ ΠΏΡΠΎΠ·ΡΠ°ΡΠ½ΡΠΌΠΈ.
ΠΊ ΡΠΎΠ΄Π΅ΡΠΆΠ°Π½ΠΈΡ βΠΠΏΠΈΠ΄Π΅ΠΌΠΈΠΎΠ»ΠΎΠ³ΠΈΡ Π·Π°Π±ΠΎΠ»Π΅Π²Π°Π½ΠΈΡ
Π Π΅Π·Π΅ΡΠ²ΡΠ°ΡΠΎΠΌ ΠΈ ΠΈΡΡΠΎΡΠ½ΠΈΠΊΠΎΠΌ Π±Π΅ΡΠ°-Π³Π΅ΠΌΠΎΠ»ΠΈΡΠΈΡΠ΅ΡΠΊΠΈΡ ΡΡΡΠ΅ΠΏΡΠΎΠΊΠΎΠΊΠΊΠΎΠ² ΡΠ²Π»ΡΡΡΡΡ Π±ΠΎΠ»ΡΠ½ΡΠ΅ ΠΈ Β«Π·Π΄ΠΎΡΠΎΠ²ΡΠ΅Β» Π±Π°ΠΊΡΠ΅ΡΠΈΠΎΠ½ΠΎΡΠΈΡΠ΅Π»ΠΈ. ΠΠ°ΠΊΡΠ΅ΡΠΈΠΈ ΠΏΡΠΎΠ½ΠΈΠΊΠ°ΡΡ Π² ΠΊΠΎΠΆΡ ΠΈΠ·Π²Π½Π΅ ΠΈΠ»ΠΈ ΠΈΠ· ΠΎΡΠ°Π³ΠΎΠ² Ρ ΡΠΎΠ½ΠΈΡΠ΅ΡΠΊΠΎΠΉ ΠΈΠ½ΡΠ΅ΠΊΡΠΈΠΈ. Π ΠΎΠΆΠΈΡΡΠΎΠ΅ Π²ΠΎΡΠΏΠ°Π»Π΅Π½ΠΈΠ΅ Ρ Π»ΠΈΡ Ρ ΠΏΡΠΎΡΠ²Π»Π΅Π½ΠΈΡΠΌΠΈ ΡΡΡΠ΅ΠΏΡΠΎΠΊΠΎΠΊΠΊΠΎΠ²ΠΎΠΉ ΠΈΠ½ΡΠ΅ΠΊΡΠΈΠΈ (Ρ ΡΠΎΠ½ΠΈΡΠ΅ΡΠΊΠΈΠΉ ΡΠΎΠ½Π·ΠΈΠ»Π»ΠΈΡ, ΠΊΠ°ΡΠΈΠ΅Ρ, Π·Π°Π±ΠΎΠ»Π΅Π²Π°Π½ΠΈΡ ΠΠΠ -ΠΎΡΠ³Π°Π½ΠΎΠ² ΠΈ Π΄Ρ.) Π²ΡΡΡΠ΅ΡΠ°Π΅ΡΡΡ Π² 5 β 6 ΡΠ°Π· ΡΠ°ΡΠ΅. ΠΠ»ΠΈΡΠ΅Π»ΡΠ½ΡΠΉ ΠΏΡΠΈΠ΅ΠΌ ΡΡΠ΅ΡΠΎΠΈΠ΄Π½ΡΡ Π³ΠΎΡΠΌΠΎΠ½ΠΎΠ² ΡΠ²Π»ΡΠ΅ΡΡΡ ΠΏΡΠ΅Π΄ΡΠ°ΡΠΏΠΎΠ»Π°ΡΡΠΈΠΌ ΡΠ°ΠΊΡΠΎΡΠΎΠΌ ΡΠ°Π·Π²ΠΈΡΠΈΡ Π·Π°Π±ΠΎΠ»Π΅Π²Π°Π½ΠΈΡ.
ΠΠ΅Π»ΠΊΠΈΠ΅ ΡΡΠ°Π²ΠΌΡ, ΡΡΠ΅ΡΠΈΠ½Ρ, ΠΏΠΎΡΠ΅ΡΡΠΎΡΡΠΈ, ΡΡΠ°Π΄ΠΈΠ½Ρ ΠΈ ΡΠ°Π½Ρ Π½Π° ΠΊΠΎΠΆΠ½ΡΡ ΠΏΠΎΠΊΡΠΎΠ²Π°Ρ ΠΈ ΡΠ»ΠΈΠ·ΠΈΡΡΡΡ ΠΎΠ±ΠΎΠ»ΠΎΡΠΊΠ°Ρ Π½ΠΎΡΠ°, ΠΏΠΎΠ»ΠΎΠ²ΡΡ ΠΎΡΠ³Π°Π½Π°Ρ ΠΈ Π΄Ρ. ΡΠ²Π»ΡΡΡΡΡ Π²Ρ ΠΎΠ΄Π½ΡΠΌΠΈ Π²ΠΎΡΠΎΡΠ°ΠΌΠΈ Π΄Π»Ρ ΠΈΠ½ΡΠ΅ΠΊΡΠΈΠΈ. ΠΠΎΠ½ΡΠ°ΠΊΡΠ½ΡΠΉ ΠΈ Π²ΠΎΠ·Π΄ΡΡΠ½ΠΎ-ΠΊΠ°ΠΏΠ΅Π»ΡΠ½ΡΠΉ β ΠΎΡΠ½ΠΎΠ²Π½ΡΠ΅ ΠΏΡΡΠΈ Π·Π°ΡΠ°ΠΆΠ΅Π½ΠΈΡ.
Π‘ΡΡΠ΅ΠΏΡΠΎΠΊΠΎΠΊΠΊΠΈ Π³ΡΡΠΏΠΏΡ Π ΡΠ°ΡΡΠΎ ΠΎΠ±ΠΈΡΠ°ΡΡ Π½Π° ΠΊΠΎΠΆΠ΅ ΠΈ ΡΠ»ΠΈΠ·ΠΈΡΡΡΡ ΠΎΠ±ΠΎΠ»ΠΎΡΠΊΠ°Ρ ΡΠ΅Π»ΠΎΠ²Π΅ΠΊΠ° ΠΈ Π½Π΅ Π²ΡΠ·ΡΠ²Π°ΡΡ Π·Π°Π±ΠΎΠ»Π΅Π²Π°Π½ΠΈΡ. Π’Π°ΠΊΠΈΠ΅ Π»ΠΈΡΠ° Π½Π°Π·ΡΠ²Π°ΡΡΡΡ Π±Π°ΠΊΡΠ΅ΡΠΈΠΎΠ½ΠΎΡΠΈΡΠ΅Π»ΡΠΌΠΈ. Π ΠΎΠΆΠ° ΡΠ°ΡΠ΅ ΡΠ΅Π³ΠΈΡΡΡΠΈΡΡΠ΅ΡΡΡ Ρ ΠΆΠ΅Π½ΡΠΈΠ½ Π² ΠΏΠ΅ΡΠΈΠΎΠ΄ ΡΠ³Π°ΡΠ°Π½ΠΈΡ ΡΠ΅ΠΏΡΠΎΠ΄ΡΠΊΡΠΈΠ²Π½ΠΎΠΉ ΡΡΠ½ΠΊΡΠΈΠΈ. Π£ ΡΠ°ΡΡΠΈ Π±ΠΎΠ»ΡΠ½ΡΡ ΡΠΎΠΆΠΈΡΡΠΎΠ΅ Π²ΠΎΡΠΏΠ°Π»Π΅Π½ΠΈΠ΅ Π½ΠΎΡΠΈΡ ΡΠ΅ΡΠΈΠ΄ΠΈΠ²ΠΈΡΡΡΡΠΈΠΉ Ρ Π°ΡΠ°ΠΊΡΠ΅Ρ ΡΡΠΎ, ΠΏΠΎ-Π²ΠΈΠ΄ΠΈΠΌΠΎΠΌΡ, ΡΠ²ΡΠ·Π°Π½ΠΎ Ρ Π³Π΅Π½Π΅ΡΠΈΡΠ΅ΡΠΊΠΎΠΉ ΠΏΡΠ΅Π΄ΡΠ°ΡΠΏΠΎΠ»ΠΎΠΆΠ΅Π½Π½ΠΎΡΡΡΡ.
ΠΠ°Π±ΠΎΠ»Π΅Π²Π°Π½ΠΈΠ΅ ΡΠ°ΡΠ΅ ΡΠ°Π·Π²ΠΈΠ²Π°Π΅ΡΡΡ ΠΏΡΠΈ Π»ΠΈΠΌΡΠΎΡΡΠ°Π·Π΅ ΠΈ Π²Π΅Π½ΠΎΠ·Π½ΠΎΠΉ Π½Π΅Π΄ΠΎΡΡΠ°ΡΠΎΡΠ½ΠΎΡΡΠΈ, ΠΎΡΠ΅ΠΊΠ°Ρ ΡΠ°Π·Π½ΠΎΠ³ΠΎ ΠΏΡΠΎΠΈΡΡ ΠΎΠΆΠ΄Π΅Π½ΠΈΡ, ΡΡΠΎΡΠΈΡΠ΅ΡΠΊΠΈΡ ΡΠ·Π²Π°Ρ ΠΈ Π³ΡΠΈΠ±ΠΊΠΎΠ²ΠΎΠΌ ΠΏΠΎΡΠ°ΠΆΠ΅Π½ΠΈΠΈ ΡΡΠΎΠΏ.

Π ΠΈΡ. 5. Π€Π»Π΅Π³ΠΌΠΎΠ½Π° ΠΈ Π³Π°Π½Π³ΡΠ΅Π½Π° β Π³ΡΠΎΠ·Π½ΡΠ΅ ΠΎΡΠ»ΠΎΠΆΠ½Π΅Π½ΠΈΡ ΡΠΎΠΆΠΈΡΡΠΎΠ³ΠΎ Π²ΠΎΡΠΏΠ°Π»Π΅Π½ΠΈΡ.
ΠΊ ΡΠΎΠ΄Π΅ΡΠΆΠ°Π½ΠΈΡ βΠΠ°ΠΊ Π²ΠΎΠ·Π½ΠΈΠΊΠ°Π΅Ρ ΡΠΎΠΆΠ° (ΠΏΠ°ΡΠΎΠ³Π΅Π½Π΅Π· ΡΠΎΠΆΠΈΡΡΠΎΠ³ΠΎ Π²ΠΎΡΠΏΠ°Π»Π΅Π½ΠΈΡ)
ΠΠΎΡΠΏΠ°Π»Π΅Π½ΠΈΠ΅ ΠΏΡΠΈ ΡΠΎΠΆΠΈΡΡΠΎΠΌ Π²ΠΎΡΠΏΠ°Π»Π΅Π½ΠΈΠΈ Π»ΠΎΠΊΠ°Π»ΠΈΠ·ΡΠ΅ΡΡΡ ΡΠ°ΡΠ΅ Π²ΡΠ΅Π³ΠΎ Π½Π° Π»ΠΈΡΠ΅ ΠΈ Π³ΠΎΠ»Π΅Π½ΡΡ , ΡΠ΅ΠΆΠ΅ Π½Π° ΡΡΠΊΠ°Ρ , ΡΡΠ»ΠΎΠ²ΠΈΡΠ΅, ΠΌΠΎΡΠΎΠ½ΠΊΠ΅, ΠΎΠ±Π»Π°ΡΡΠΈ ΠΏΡΠΎΠΌΠ΅ΠΆΠ½ΠΎΡΡΠΈ ΠΈ ΡΠ»ΠΈΠ·ΠΈΡΡΡΡ ΠΎΠ±ΠΎΠ»ΠΎΡΠΊΠ°Ρ . ΠΠΎΡΠΏΠ°Π»ΠΈΡΠ΅Π»ΡΠ½ΡΠΌ ΠΏΡΠΎΡΠ΅ΡΡΠΎΠΌ ΠΏΡΠΈ Π·Π°Π±ΠΎΠ»Π΅Π²Π°Π½ΠΈΠΈ Π·Π°ΡΡΠ°Π³ΠΈΠ²Π°Π΅ΡΡΡ ΠΎΡΠ½ΠΎΠ²Π½ΠΎΠΉ ΡΠ»ΠΎΠΉ ΠΊΠΎΠΆΠΈ, Π΅Π΅ ΠΊΠ°ΡΠΊΠ°Ρ β Π΄Π΅ΡΠΌΠ°. ΠΠ½Π° Π²ΡΠΏΠΎΠ»Π½ΡΠ΅Ρ ΠΎΠΏΠΎΡΠ½ΡΡ ΠΈ ΡΡΠΎΡΠΈΡΠ΅ΡΠΊΡΡ ΡΡΠ½ΠΊΡΠΈΠΈ. Π Π΄Π΅ΡΠΌΠ΅ Π½Π°Ρ ΠΎΠ΄ΠΈΡΡΡ ΠΌΠ½ΠΎΠΆΠ΅ΡΡΠ²ΠΎ ΠΊΠ°ΠΏΠΈΠ»Π»ΡΡΠΎΠ² ΠΈ Π²ΠΎΠ»ΠΎΠΊΠΎΠ½.
ΠΠΎΡΠΏΠ°Π»Π΅Π½ΠΈΠ΅ ΠΏΡΠΈ ΡΠΎΠΆΠ΅ Π½ΠΎΡΠΈΡ ΠΈΠ½ΡΠ΅ΠΊΡΠΈΠΎΠ½Π½ΡΠΉ ΠΈ Π°Π»Π»Π΅ΡΠ³ΠΈΡΠ΅ΡΠΊΠΈΠΉ Ρ Π°ΡΠ°ΠΊΡΠ΅Ρ.
- ΠΡΠΎΠ΄ΡΠΊΡΡ ΠΆΠΈΠ·Π½Π΅Π΄Π΅ΡΡΠ΅Π»ΡΠ½ΠΎΡΡΠΈ ΠΈ Π²Π΅ΡΠ΅ΡΡΠ²Π°, Π²ΡΠ΄Π΅Π»ΡΠ΅ΠΌΡΠ΅ ΠΏΡΠΈ Π³ΠΈΠ±Π΅Π»ΠΈ Π±Π°ΠΊΡΠ΅ΡΠΈΠΉ, ΡΡΠ°Π½ΠΎΠ²ΡΡΡΡ ΠΏΡΠΈΡΠΈΠ½ΠΎΠΉ ΡΠ°Π·Π²ΠΈΡΠΈΡ ΡΠΎΠΊΡΠΈΠΊΠΎΠ·Π° ΠΈ Π»ΠΈΡ ΠΎΡΠ°Π΄ΠΊΠΈ.
- ΠΡΠΈΡΠΈΠ½ΠΎΠΉ ΡΠ°Π·Π²ΠΈΡΠΈΡ Π²ΠΎΡΠΏΠ°Π»ΠΈΡΠ΅Π»ΡΠ½ΠΎΠ³ΠΎ ΠΏΡΠΎΡΠ΅ΡΡΠ° ΡΠ²Π»ΡΠ΅ΡΡΡ Π²ΠΎΠ·Π΄Π΅ΠΉΡΡΠ²ΠΈΠ΅ Π½Π° ΡΠΊΠ°Π½ΠΈ ΡΠΎΠΊΡΠΈΠ½ΠΎΠ², ΡΠ΅ΡΠΌΠ΅Π½ΡΠΎΠ² ΠΈ Π°Π½ΡΠΈΠ³Π΅Π½ΠΎΠ² Π³Π΅ΠΌΠΎΠ»ΠΈΡΠΈΡΠ΅ΡΠΊΠΈΡ ΡΡΡΠ΅ΠΏΡΠΎΠΊΠΎΠΊΠΊΠΎΠ², Π° ΡΠ°ΠΊΠΆΠ΅ Π±ΠΈΠΎΠ»ΠΎΠ³ΠΈΡΠ΅ΡΠΊΠΈ Π°ΠΊΡΠΈΠ²Π½ΡΡ Π²Π΅ΡΠ΅ΡΡΠ². ΠΠΎΠ²ΡΠ΅ΠΆΠ΄Π°ΡΡΡΡ ΠΌΠ΅Π»ΠΊΠΈΠ΅ Π°ΡΡΠ΅ΡΠΈΠΈ, Π²Π΅Π½Ρ ΠΈ Π»ΠΈΠΌΡΠ°ΡΠΈΡΠ΅ΡΠΊΠΈΠ΅ ΡΠΎΡΡΠ΄Ρ. ΠΠΎΡΠΏΠ°Π»Π΅Π½ΠΈΠ΅ Π½ΠΎΡΠΈΡ ΡΠ΅ΡΠΎΠ·Π½ΡΠΉ ΠΈΠ»ΠΈ ΡΠ΅ΡΠΎΠ·Π½ΠΎ-Π³Π΅ΠΌΠΎΡΡΠ°Π³ΠΈΡΠ΅ΡΠΊΠΈΠΉ Ρ Π°ΡΠ°ΠΊΡΠ΅Ρ.
- ΠΠ½ΡΠΈΠ³Π΅Π½Ρ ΠΊΠΎΠΆΠΈ ΡΠ΅Π»ΠΎΠ²Π΅ΠΊΠ° ΠΏΠΎ ΡΠ²ΠΎΠ΅ΠΉ ΡΡΡΡΠΊΡΡΡΠ΅ ΡΡ ΠΎΠΆΠΈ ΡΠΎ ΡΡΡΠ΅ΠΏΡΠΎΠΊΠΎΠΊΠΊΠΎΠ²ΡΠΌΠΈ ΠΏΠΎΠ»ΠΈΡΠ°Ρ Π°ΡΠΈΠ΄Π°ΠΌΠΈ, ΡΡΠΎ ΠΏΡΠΈΠ²ΠΎΠ΄ΠΈΡ ΠΊ ΡΠ°Π·Π²ΠΈΡΠΈΡ Π°ΡΡΠΎΠΈΠΌΠΌΡΠ½Π½ΡΡ ΠΏΡΠΎΡΠ΅ΡΡΠΎΠ², ΠΊΠΎΠ³Π΄Π° Π°Π½ΡΠΈΡΠ΅Π»Π° Π±ΠΎΠ»ΡΠ½ΠΎΠ³ΠΎ Π½Π°ΡΠΈΠ½Π°ΡΡ Π°ΡΠ°ΠΊΠΎΠ²Π°ΡΡ ΡΠ²ΠΎΠΈ ΡΠΊΠ°Π½ΠΈ. ΠΠΌΠΌΡΠ½Π½ΡΠ΅ ΠΈ Π°ΡΡΠΎΠΈΠΌΠΌΡΠ½Π½ΡΠ΅ ΠΊΠΎΠΌΠΏΠ»Π΅ΠΊΡΡ Π²ΡΠ·ΡΠ²Π°ΡΡ ΠΏΠΎΡΠ°ΠΆΠ΅Π½ΠΈΠ΅ ΠΊΠΎΠΆΠΈ ΠΈ ΡΠΎΡΡΠ΄ΠΎΠ². Π Π°Π·Π²ΠΈΠ²Π°Π΅ΡΡΡ Π²Π½ΡΡΡΠΈΡΠΎΡΡΠ΄ΠΈΡΡΠΎΠ΅ ΡΠ²Π΅ΡΡΡΠ²Π°Π½ΠΈΠ΅ ΠΊΡΠΎΠ²ΠΈ, Π½Π°ΡΡΡΠ°Π΅ΡΡΡ ΡΠ΅Π»ΠΎΡΡΠ½ΠΎΡΡΡ ΡΡΠ΅Π½ΠΎΠΊ ΠΊΠ°ΠΏΠΈΠ»Π»ΡΡΠΎΠ², ΡΠΎΡΠΌΠΈΡΡΠ΅ΡΡΡ ΠΌΠ΅ΡΡΠ½ΡΠΉ Π³Π΅ΠΌΠΎΡΡΠ°Π³ΠΈΡΠ΅ΡΠΊΠΈΠΉ ΡΠΈΠ½Π΄ΡΠΎΠΌ. Π ΡΠ΅Π·ΡΠ»ΡΡΠ°ΡΠ΅ ΡΠ°ΡΡΠΈΡΠ΅Π½ΠΈΡ ΡΠΎΡΡΠ΄ΠΎΠ² Π½Π° ΠΊΠΎΠΆΠ΅ ΠΏΠΎΡΠ²Π»ΡΠ΅ΡΡΡ ΠΎΡΠ°Π³ Π³ΠΈΠΏΠ΅ΡΠ΅ΠΌΠΈΠΈ ΠΈ ΠΏΡΠ·ΡΡΡΠΊΠΈ, ΡΠΎΠ΄Π΅ΡΠΆΠΈΠΌΠΎΠ΅ ΠΊΠΎΡΠΎΡΡΡ Π½ΠΎΡΠΈΡ ΡΠ΅ΡΠΎΠ·Π½ΡΠΉ ΠΈΠ»ΠΈ Π³Π΅ΠΌΠΎΡΡΠ°Π³ΠΈΡΠ΅ΡΠΊΠΈΠΉ Ρ Π°ΡΠ°ΠΊΡΠ΅Ρ.
- Π ΠΊΡΠΎΠ²Π΅Π½ΠΎΡΠ½ΠΎΠ΅ ΡΡΡΠ»ΠΎ Π² Π±ΠΎΠ»ΡΡΠΎΠΌ ΠΊΠΎΠ»ΠΈΡΠ΅ΡΡΠ²Π΅ ΠΏΠΎΠΏΠ°Π΄Π°ΡΡ Π±ΠΈΠΎΠ»ΠΎΠ³ΠΈΡΠ΅ΡΠΊΠΈ Π°ΠΊΡΠΈΠ²Π½ΡΠ΅ Π²Π΅ΡΠ΅ΡΡΠ²Π°, Π² ΡΠΎΠΌ ΡΠΈΡΠ»Π΅ Π³ΠΈΡΡΠ°ΠΌΠΈΠ½, ΠΊΠΎΡΠΎΡΡΠΉ ΠΏΡΠΈΡΠ°ΡΡΠ΅Π½ ΠΊ ΡΠ°Π·Π²ΠΈΡΠΈΡ Π³Π΅ΠΌΠΎΡΡΠ°Π³ΠΈΡΠ΅ΡΠΊΠΈΡ ΡΠΎΡΠΌ ΡΠΎΠΆΠΈΡΡΠΎΠ³ΠΎ Π²ΠΎΡΠΏΠ°Π»Π΅Π½ΠΈΡ.
- ΠΠ΅Π΄ΠΎΡΡΠ°ΡΠΎΡΠ½ΠΎΡΡΡ Π»ΠΈΠΌΡΠΎΠΎΠ±ΡΠ°ΡΠ΅Π½ΠΈΡ ΠΏΡΠΎΡΠ²Π»ΡΠ΅ΡΡΡ ΠΎΡΠ΅ΠΊΠ°ΠΌΠΈ Π½ΠΈΠΆΠ½ΠΈΡ ΠΊΠΎΠ½Π΅ΡΠ½ΠΎΡΡΠ΅ΠΉ. Π‘ΠΎ Π²ΡΠ΅ΠΌΠ΅Π½Π΅ΠΌ ΠΏΠΎΠ²ΡΠ΅ΠΆΠ΄Π΅Π½Π½ΡΠ΅ Π»ΠΈΠΌΡΠ°ΡΠΈΡΠ΅ΡΠΊΠΈΠ΅ ΡΠΎΡΡΠ΄Ρ Π·Π°ΠΌΠ΅ΡΠ°ΡΡΡΡ ΡΠΈΠ±ΡΠΎΠ·Π½ΠΎΠΉ ΡΠΊΠ°Π½ΡΡ,ΡΡΠΎ ΠΏΡΠΈΠ²ΠΎΠ΄ΠΈΡ ΠΊ ΡΠ°Π·Π²ΠΈΡΠΈΡ ΡΠ»ΠΎΠ½ΠΎΠ²ΠΎΡΡΠΈ.
- ΠΡΠ°Π³ ΠΈΠ½ΡΠ΅ΠΊΡΠΈΠΎΠ½Π½ΠΎ-Π°Π»Π»Π΅ΡΠ³ΠΈΡΠ΅ΡΠΊΠΎΠ³ΠΎ Π²ΠΎΡΠΏΠ°Π»Π΅Π½ΠΈΡ ΠΏΠΎΡΡΠ΅Π±Π»ΡΠ΅Ρ Π±ΠΎΠ»ΡΡΠΎΠ΅ ΠΊΠΎΠ»ΠΈΡΠ΅ΡΡΠ²ΠΎ Π³Π»ΡΠΊΠΎΠΊΠΎΡΡΠΈΠΊΠΎΠΈΠ΄ΠΎΠ². ΠΡΠΎ ΠΏΡΠΈΠ²ΠΎΠ΄ΠΈΡ ΠΊ ΡΠ°Π·Π²ΠΈΡΠΈΡ Π²Π½Π΅Π½Π°Π΄ΠΏΠΎΡΠ΅ΡΠ½ΠΈΠΊΠΎΠ²ΠΎΠΉ Π½Π΅Π΄ΠΎΡΡΠ°ΡΠΎΡΠ½ΠΎΡΡΠΈ. ΠΠ°ΡΡΡΠ°ΡΡΡΡ Π±Π΅Π»ΠΊΠΎΠ²ΡΠΉ ΠΈ Π²ΠΎΠ΄Π½ΠΎ-ΡΠΎΠ»Π΅Π²ΠΎΠΉ ΠΎΠ±ΠΌΠ΅Π½Ρ.

Π ΠΈΡ. 6. ΠΠΎΡΠΏΠ°Π»ΠΈΡΠ΅Π»ΡΠ½ΡΠΌ ΠΏΡΠΎΡΠ΅ΡΡΠΎΠΌ ΠΏΡΠΈ Π·Π°Π±ΠΎΠ»Π΅Π²Π°Π½ΠΈΠΈ Π·Π°ΡΡΠ°Π³ΠΈΠ²Π°Π΅ΡΡΡ ΠΎΡΠ½ΠΎΠ²Π½ΠΎΠΉ ΡΠ»ΠΎΠΉ ΠΊΠΎΠΆΠΈ, Π΅Π΅ ΠΊΠ°ΡΠΊΠ°Ρ β Π΄Π΅ΡΠΌΠ°.
ΠΊ ΡΠΎΠ΄Π΅ΡΠΆΠ°Π½ΠΈΡ βΠ€Π°ΠΊΡΠΎΡΡ, Π²Π»ΠΈΡΡΡΠΈΠ΅ Π½Π° ΡΠ°Π·Π²ΠΈΡΠΈΠ΅ ΡΠΎΠΆΠΈΡΡΠΎΠ³ΠΎ Π²ΠΎΡΠΏΠ°Π»Π΅Π½ΠΈΡ
ΠΠ° ΡΠ°Π·Π²ΠΈΡΠΈΠ΅ ΡΠΎΠΆΠΈΡΡΠΎΠ³ΠΎ Π²ΠΎΡΠΏΠ°Π»Π΅Π½ΠΈΡ ΠΎΠΊΠ°Π·ΡΠ²Π°ΡΡ Π²Π»ΠΈΡΠ½ΠΈΠ΅ ΡΠ»Π΅Π΄ΡΡΡΠΈΠ΅ ΡΠ°ΠΊΡΠΎΡΡ:
- ΠΠ½Π΄ΠΈΠ²ΠΈΠ΄ΡΠ°Π»ΡΠ½Π°Ρ ΠΏΡΠ΅Π΄ΡΠ°ΡΠΏΠΎΠ»ΠΎΠΆΠ΅Π½Π½ΠΎΡΡΡ ΠΊ Π·Π°Π±ΠΎΠ»Π΅Π²Π°Π½ΠΈΡ, ΡΡΠΎ ΠΎΠ±ΡΡΠ»ΠΎΠ²Π»Π΅Π½ΠΎ Π³Π΅Π½Π΅ΡΠΈΡΠ΅ΡΠΊΠΎΠΉ ΠΏΡΠ΅Π΄ΡΠ°ΡΠΏΠΎΠ»ΠΎΠΆΠ΅Π½Π½ΠΎΡΡΡΡ ΠΈΠ»ΠΈ ΠΏΠΎΠ²ΡΡΠ΅Π½Π½ΠΎΠΉ ΡΡΠ²ΡΡΠ²ΠΈΡΠ΅Π»ΡΠ½ΠΎΡΡΡΡ ΠΊ Π°Π»Π»Π΅ΡΠ³Π΅Π½Π°ΠΌ ΡΡΡΠ΅ΠΏΡΠΎΠΊΠΎΠΊΠΊΠΎΠ² ΠΈ ΡΡΠ°ΡΠΈΠ»ΠΎΠΊΠΎΠΊΠΊΠΎΠ².
- Π‘Π½ΠΈΠΆΠ΅Π½ΠΈΠ΅ Π°ΠΊΡΠΈΠ²Π½ΠΎΡΡΠΈ Π·Π°ΡΠΈΡΠ½ΡΡ ΡΠ΅Π°ΠΊΡΠΈΠΉ ΠΎΡΠ³Π°Π½ΠΈΠ·ΠΌΠ° β Π½Π΅ΡΠΏΠ΅ΡΠΈΡΠΈΡΠ΅ΡΠΊΠΈΡ ΡΠ°ΠΊΡΠΎΡΠΎΠ², Π³ΡΠΌΠΎΡΠ°Π»ΡΠ½ΠΎΠ³ΠΎ, ΠΊΠ»Π΅ΡΠΎΡΠ½ΠΎΠ³ΠΎ ΠΈ ΠΌΠ΅ΡΡΠ½ΠΎΠ³ΠΎ ΠΈΠΌΠΌΡΠ½ΠΈΡΠ΅ΡΠ°.
- Π Π°ΡΡΡΡΠΎΠΉΡΡΠ²Π° Π½Π΅ΠΉΡΠΎΡΠ½Π΄ΠΎΠΊΡΠΈΠ½Π½ΠΎΠΉ ΡΠΈΡΡΠ΅ΠΌΡ ΠΈ Π΄ΠΈΡΠ±Π°Π»Π°Π½Ρ Π±ΠΈΠΎΠ»ΠΎΠ³ΠΈΡΠ΅ΡΠΊΠΈ Π°ΠΊΡΠΈΠ²Π½ΡΡ Π²Π΅ΡΠ΅ΡΡΠ².
ΠΠ»Π°ΡΡΠΈΡΠΈΠΊΠ°ΡΠΈΡ ΡΠΎΠΆΠΈ
- ΠΡΠ΄Π΅Π»ΡΡΡ ΡΡΠΈΡΠ΅ΠΌΠ°ΡΠΎΠ·Π½ΡΡ, ΡΡΠΈΡΠ΅ΠΌΠ°ΡΠΎΠ·Π½ΠΎ-Π±ΡΠ»Π»Π΅Π·Π½ΡΡ, ΡΡΠΈΡΠ΅ΠΌΠ°ΡΠΎΠ·Π½ΠΎ-Π³Π΅ΠΌΠΎΡΡΠ°Π³ΠΈΡΠ΅ΡΠΊΡΡ ΠΈ Π±ΡΠ»Π»Π΅Π·Π½ΠΎ-Π³Π΅ΠΌΠΎΡΡΠ°Π³ΠΈΡΠ΅ΡΠΊΡΡ (Π½Π΅ΠΎΡΠ»ΠΎΠΆΠ½Π΅Π½Π½ΡΠ΅) ΠΈ Π°Π±ΡΡΠ΅Π΄ΠΈΡΡΡΡΡΡ, ΡΠ»Π΅Π³ΠΌΠΎΠ½ΠΎΠ·Π½ΡΡ ΠΈ Π½Π΅ΠΊΡΠΎΡΠΈΡΠ΅ΡΠΊΡΡ (ΠΎΡΠ»ΠΎΠΆΠ½Π΅Π½Π½ΡΠ΅) ΡΠΎΡΠΌΡ ΡΠΎΠΆΠΈΡΡΠΎΠ³ΠΎ Π²ΠΎΡΠΏΠ°Π»Π΅Π½ΠΈΡ. ΠΠ°Π½Π½Π°Ρ ΠΊΠ»Π°ΡΡΠΈΡΠΈΠΊΠ°ΡΠΈΡ ΡΠΎΠΆΠΈ ΠΎΡΠ½ΠΎΠ²Π°Π½Π° Π½Π° Ρ Π°ΡΠ°ΠΊΡΠ΅ΡΠ΅ ΠΌΠ΅ΡΡΠ½ΡΡ ΠΏΠΎΡΠ°ΠΆΠ΅Π½ΠΈΠΉ.
- ΠΠΎ ΡΡΠ΅ΠΏΠ΅Π½ΠΈ ΡΡΠΆΠ΅ΡΡΠΈ ΡΠ΅ΡΠ΅Π½ΠΈΡ ΡΠΎΠΆΠΈΡΡΠΎΠ΅ Π²ΠΎΡΠΏΠ°Π»Π΅Π½ΠΈΠ΅ ΠΏΠΎΠ΄ΡΠ°Π·Π΄Π΅Π»ΡΠ΅ΡΡΡ Π½Π° Π»Π΅Π³ΠΊΠΎΠ΅, ΡΡΠ΅Π΄Π½Π΅ΠΉ ΡΡΠΆΠ΅ΡΡΠΈ ΠΈ ΡΡΠΆΠ΅Π»ΠΎΠ΅.
- ΠΠΎ ΠΊΡΠ°ΡΠ½ΠΎΡΡΠΈ ΠΏΡΠΎΡΠ²Π»Π΅Π½ΠΈΡ ΡΠΎΠΆΠ° ΠΏΠΎΠ΄ΡΠ°Π·Π΄Π΅Π»ΡΠ΅ΡΡΡ Π½Π° ΠΏΠ΅ΡΠ²ΠΈΡΠ½ΡΡ, ΠΏΠΎΠ²ΡΠΎΡΠ½ΡΡ ΠΈ ΡΠ΅ΡΠΈΠ΄ΠΈΠ²ΠΈΡΡΡΡΡΡ.
- ΠΡΠ΄Π΅Π»ΡΡΡ Π»ΠΎΠΊΠ°Π»ΠΈΠ·ΠΎΠ²Π°Π½Π½ΡΡ, ΡΠ°ΡΠΏΡΠΎΡΡΡΠ°Π½Π΅Π½Π½ΡΡ, ΠΌΠΈΠ³ΡΠΈΡΡΡΡΡΡ ΠΈ ΠΌΠ΅ΡΠ°ΡΡΠ°ΡΠΈΡΠ΅ΡΠΊΡΡ ΡΠΎΡΠΌΡ ΡΠΎΠΆΠΈΡΡΠΎΠ³ΠΎ Π²ΠΎΡΠΏΠ°Π»Π΅Π½ΠΈΡ.
ΠΠΎ ΡΠ°ΡΠΏΡΠΎΡΡΡΠ°Π½Π΅Π½Π½ΠΎΡΡΠΈ
- ΠΡΠΈ ΠΏΠΎΡΠ²Π»Π΅Π½ΠΈΠΈ Π½Π° ΠΊΠΎΠΆΠ΅ ΠΎΠ³ΡΠ°Π½ΠΈΡΠ΅Π½Π½ΠΎΠ³ΠΎ ΡΡΠ°ΡΡΠΊΠ° ΠΏΠΎΡΠ°ΠΆΠ΅Π½ΠΈΡ Π³ΠΎΠ²ΠΎΡΡΡ ΠΎ Π»ΠΎΠΊΠ°Π»ΠΈΠ·ΠΎΠ²Π°Π½Π½ΠΎΠΉ ΡΠΎΡΠΌΠ΅ ΡΠΎΠΆΠΈ.
- ΠΡΡ ΠΎΠ΄ ΠΎΡΠ°Π³Π° Π·Π° ΠΏΡΠ΅Π΄Π΅Π»Ρ Π°Π½Π°ΡΠΎΠΌΠΈΡΠ΅ΡΠΊΠΎΠΉ ΠΎΠ±Π»Π°ΡΡΠΈ ΡΠ°ΡΡΠ΅Π½ΠΈΠ²Π°Π΅ΡΡΡ ΠΊΠ°ΠΊ ΡΠ°ΡΠΏΡΠΎΡΡΡΠ°Π½Π΅Π½Π½Π°Ρ ΡΠΎΡΠΌΠ°.
- ΠΡΠΈ ΠΏΠΎΡΠ²Π»Π΅Π½ΠΈΠΈ Π²Π±Π»ΠΈΠ·ΠΈ ΠΎΡ ΠΏΠ΅ΡΠ²ΠΈΡΠ½ΠΎΠ³ΠΎ ΠΎΡΠ°Π³Π° ΠΏΠΎΡΠ°ΠΆΠ΅Π½ΠΈΡ ΠΎΠ΄Π½ΠΎΠ³ΠΎ ΠΈΠ»ΠΈ Π½Π΅ΡΠΊΠΎΠ»ΡΠΊΠΈΡ Π½ΠΎΠ²ΡΡ ΡΡΠ°ΡΡΠΊΠΎΠ², ΡΠΎΠ΅Π΄ΠΈΠ½ΡΡΡΠΈΡ ΡΡ Β«ΠΌΠΎΡΡΠΈΠΊΠ°ΠΌΠΈΒ», Π³ΠΎΠ²ΠΎΡΡΡ ΠΎ ΠΌΠΈΠ³ΡΠΈΡΡΡΡΠ΅ΠΉ ΡΠΎΡΠΌΠ΅ ΡΠΎΠΆΠΈΡΡΠΎΠ³ΠΎ Π²ΠΎΡΠΏΠ°Π»Π΅Π½ΠΈΡ.
- ΠΡΠΈ ΠΏΠΎΡΠ²Π»Π΅Π½ΠΈΠΈ Π½ΠΎΠ²ΡΡ ΠΎΡΠ°Π³ΠΎΠ² Π²ΠΎΡΠΏΠ°Π»Π΅Π½ΠΈΡ Π²Π΄Π°Π»ΠΈ ΠΎΡ ΠΏΠ΅ΡΠ²ΠΈΡΠ½ΠΎΠ³ΠΎ ΠΎΡΠ°Π³Π° Π³ΠΎΠ²ΠΎΡΡΡ ΠΎ ΠΌΠ΅ΡΠ°ΡΡΠ°ΡΠΈΡΠ΅ΡΠΊΠΎΠΉ ΡΠΎΡΠΌΠ΅ Π·Π°Π±ΠΎΠ»Π΅Π²Π°Π½ΠΈΡ. Π‘ΡΡΠ΅ΠΏΡΠΎΠΊΠΎΠΊΠΊΠΈ ΠΏΡΠΈ ΡΡΠΎΠΌ ΡΠ°ΡΠΏΡΠΎΡΡΡΠ°Π½ΡΡΡΡΡ Π³Π΅ΠΌΠ°ΡΠΎΠ³Π΅Π½Π½ΡΠΌ ΠΏΡΡΠ΅ΠΌ. ΠΠ°Π±ΠΎΠ»Π΅Π²Π°Π½ΠΈΠ΅ ΠΏΡΠΎΡΠ΅ΠΊΠ°Π΅Ρ ΡΡΠΆΠ΅Π»ΠΎ ΠΈ Π΄Π»ΠΈΡΠ΅Π»ΡΠ½ΠΎ, ΡΠ°ΡΡΠΎ ΠΎΡΠ»ΠΎΠΆΠ½ΡΠ΅ΡΡΡ ΡΠ°Π·Π²ΠΈΡΠΈΠ΅ΠΌ ΡΠ΅ΠΏΡΠΈΡΠ°.
ΠΠΎ ΠΊΡΠ°ΡΠ½ΠΎΡΡΠΈ Π²ΠΎΠ·Π½ΠΈΠΊΠ½ΠΎΠ²Π΅Π½ΠΈΡ
- Π ΠΎΠΆΠΈΡΡΠΎΠ΅ Π²ΠΎΡΠΏΠ°Π»Π΅Π½ΠΈΠ΅, Π²ΠΎΠ·Π½ΠΈΠΊΡΠ΅Π΅ Π²ΠΏΠ΅ΡΠ²ΡΠ΅, Π½Π°Π·ΡΠ²Π°Π΅ΡΡΡ ΠΏΠ΅ΡΠ²ΠΈΡΠ½ΡΠΌ.
- ΠΡΠΈ Π²ΠΎΠ·Π½ΠΈΠΊΠ½ΠΎΠ²Π΅Π½ΠΈΠΈ ΠΏΠΎΠ²ΡΠΎΡΠ½ΠΎΠ³ΠΎ ΡΠ»ΡΡΠ°Ρ Π·Π°Π±ΠΎΠ»Π΅Π²Π°Π½ΠΈΡ Π½Π° ΠΎΠ΄Π½ΠΎΠΌ ΠΈ ΡΠΎΠΌ ΠΆΠ΅ ΠΌΠ΅ΡΡΠ΅, Π½ΠΎ Π½Π΅ ΡΠ°Π½Π΅Π΅, ΡΠ΅ΠΌ ΡΠ΅ΡΠ΅Π· 2 Π³ΠΎΠ΄Π° ΠΏΠΎΡΠ»Π΅ ΠΏΠ΅ΡΠ²ΠΎΠ³ΠΎ ΡΠ»ΡΡΠ°Ρ ΠΈΠ»ΠΈ ΠΏΡΠΈ Π²ΠΎΠ·Π½ΠΈΠΊΠ½ΠΎΠ²Π΅Π½ΠΈΠΈ ΠΏΠΎΠ²ΡΠΎΡΠ½ΠΎΠ³ΠΎ Π·Π°Π±ΠΎΠ»Π΅Π²Π°Π½ΠΈΡ, Π²ΠΎΠ·Π½ΠΈΠΊΡΠ΅Π³ΠΎ Π½Π° Π΄ΡΡΠ³ΠΎΠΌ ΠΌΠ΅ΡΡΠ΅ ΡΠ°Π½Π΅Π΅ ΡΡΠΎΠ³ΠΎ ΡΡΠΎΠΊΠ°, Π³ΠΎΠ²ΠΎΡΡΡ ΠΎ ΠΏΠΎΠ²ΡΠΎΡΠ½ΠΎΠΉ ΡΠΎΠΆΠ΅.
- Π ΠΎΠΆΠΈΡΡΠΎΠ΅ Π²ΠΎΡΠΏΠ°Π»Π΅Π½ΠΈΠ΅, Π²ΠΎΠ·Π½ΠΈΠΊΠ°ΡΡΠ΅Π΅ ΠΌΠ½ΠΎΠ³ΠΎΠΊΡΠ°ΡΠ½ΠΎ Π½Π° ΠΎΠ΄Π½ΠΎΠΌ ΠΈ ΡΠΎΠΌ ΠΆΠ΅ ΠΌΠ΅ΡΡΠ΅, Π½ΠΎΡΠΈΡ ΡΠ΅ΡΠΈΠ΄ΠΈΠ²ΠΈΡΡΡΡΠΈΠΉ Ρ Π°ΡΠ°ΠΊΡΠ΅Ρ.
ΠΠΎ ΡΡΠ΅ΠΏΠ΅Π½ΠΈ ΡΡΠΆΠ΅ΡΡΠΈ
- ΠΠ΅Π³ΠΊΠ°Ρ ΡΡΠ΅ΠΏΠ΅Π½Ρ ΡΡΠΆΠ΅ΡΡΠΈ Π·Π°Π±ΠΎΠ»Π΅Π²Π°Π½ΠΈΡ Ρ Π°ΡΠ°ΠΊΡΠ΅ΡΠΈΠ·ΡΠ΅ΡΡΡ Π½Π΅ΠΏΡΠΎΠ΄ΠΎΠ»ΠΆΠΈΡΠ΅Π»ΡΠ½ΠΎΠΉ Π»ΠΈΡ ΠΎΡΠ°Π΄ΠΊΠΎΠΉ ΠΈ ΡΠ»Π°Π±ΠΎ Π²ΡΡΠ°ΠΆΠ΅Π½Π½ΡΠΌΠΈ ΡΠΈΠΌΠΏΡΠΎΠΌΠ°ΠΌΠΈ ΠΈΠ½ΡΠΎΠΊΡΠΈΠΊΠ°ΡΠΈΠΈ, ΡΡΠΎ Ρ Π°ΡΠ°ΠΊΡΠ΅ΡΠ½ΠΎ Π΄Π»Ρ ΡΡΠΈΡΠ΅ΠΌΠ°ΡΠΎΠ·Π½ΠΎΠΉ ΡΠΎΡΠΌΡ ΡΠΎΠΆΠΈ.
- Π‘ΡΠ΅Π΄Π½ΡΡ ΡΡΠ΅ΠΏΠ΅Π½Ρ ΡΡΠΆΠ΅ΡΡΠΈ Ρ Π°ΡΠ°ΠΊΡΠ΅ΡΠΈΠ·ΡΠ΅ΡΡΡ Π±ΠΎΠ»Π΅Π΅ Π΄Π»ΠΈΡΠ΅Π»ΡΠ½ΠΎΠΉ (Π΄ΠΎ 5-ΠΈ Π΄Π½Π΅ΠΉ) Π»ΠΈΡ ΠΎΡΠ°Π΄ΠΊΠΎΠΉ ΠΈ Π±ΠΎΠ»Π΅Π΅ Π²ΡΡΠ°ΠΆΠ΅Π½Π½ΡΠΌΠΈ ΡΠΈΠΌΠΏΡΠΎΠΌΠ°ΠΌΠΈ ΠΈΠ½ΡΠΎΠΊΡΠΈΠΊΠ°ΡΠΈΠΈ, ΡΡΠΎ Ρ Π°ΡΠ°ΠΊΡΠ΅ΡΠ½ΠΎ Π΄Π»Ρ ΡΡΠΈΡΠ΅ΠΌΠ°ΡΠΎΠ·Π½ΠΎΠΉ ΠΈ ΡΡΠΈΡΠ΅ΠΌΠ°ΡΠΎΠ·Π½ΠΎ-Π±ΡΠ»Π»Π΅Π·Π½ΠΎΠΉ ΡΠΎΡΠΌΡ Π·Π°Π±ΠΎΠ»Π΅Π²Π°Π½ΠΈΡ.
- Π’ΡΠΆΠ΅Π»ΠΎΠ΅ ΡΠ΅ΡΠ΅Π½ΠΈΠ΅ ΡΠΎΠΆΠΈΡΡΠΎΠ³ΠΎ Π²ΠΎΡΠΏΠ°Π»Π΅Π½ΠΈΡ Ρ Π°ΡΠ°ΠΊΡΠ΅ΡΠ½ΠΎ Π΄Π»Ρ Π³Π΅ΠΌΠΎΡΡΠ°Π³ΠΈΡΠ΅ΡΠΊΠΈΡ ΠΈ ΠΎΡΠ»ΠΎΠΆΠ½Π΅Π½Π½ΡΡ ΡΠΎΡΠΌ Π·Π°Π±ΠΎΠ»Π΅Π²Π°Π½ΠΈΡ, ΠΊΠΎΡΠΎΡΡΠ΅ ΠΏΡΠΎΡΠ΅ΠΊΠ°ΡΡ Ρ Π²ΡΡΠΎΠΊΠΎΠΉ (Π΄ΠΎ 400Π‘) ΡΠ΅ΠΌΠΏΠ΅ΡΠ°ΡΡΡΠΎΠΉ ΡΠ΅Π»Π°, ΡΠΈΠ»ΡΠ½Π΅ΠΉΡΠ΅ΠΉ ΠΈΠ½ΡΠΎΠΊΡΠΈΠΊΠ°ΡΠΈΠ΅ΠΉ, ΡΠ°Π·Π²ΠΈΡΠΈΠ΅ΠΌ Π² Π½Π΅ΠΊΠΎΡΠΎΡΡΡ ΡΠ»ΡΡΠ°ΡΡ ΠΈΠ½ΡΠ΅ΠΊΡΠΈΠΎΠ½Π½ΠΎ-ΡΠΎΠΊΡΠΈΡΠ΅ΡΠΊΠΎΠ³ΠΎ ΡΠΎΠΊΠ° ΠΈ ΡΠ΅ΠΏΡΠΈΡΠ°. Π’ΡΠΆΠ΅Π»ΠΎΠ΅ ΡΠ΅ΡΠ΅Π½ΠΈΠ΅ ΠΎΡΠΌΠ΅ΡΠ°Π΅ΡΡΡ ΠΏΡΠΈ ΠΌΠΈΠ³ΡΠΈΡΡΡΡΠ΅ΠΉ ΠΈ ΠΌΠ΅ΡΠ°ΡΡΠ°ΡΠΈΡΠ΅ΡΠΊΠΎΠΉ ΡΠΎΡΠΌΠ°Ρ Π·Π°Π±ΠΎΠ»Π΅Π²Π°Π½ΠΈΡ.
Π‘ΡΠ΅ΡΡΡΠ΅ ΠΈΠ»ΠΈ Π°Π±ΠΎΡΡΠΈΠ²Π½ΡΠ΅ ΡΠΎΡΠΌΡ Π·Π°Π±ΠΎΠ»Π΅Π²Π°Π½ΠΈΡ ΠΎΡΠΌΠ΅ΡΠ°ΡΡΡΡ ΠΏΡΠΈ Π°Π΄Π΅ΠΊΠ²Π°ΡΠ½ΠΎΠΌ, ΡΠ²ΠΎΠ΅Π²ΡΠ΅ΠΌΠ΅Π½Π½ΠΎ Π½Π°ΡΠ°ΡΠΎΠΌ Π»Π΅ΡΠ΅Π½ΠΈΠΈ. ΠΡΡΡΠ΅ΡΠ°ΡΡΡΡ ΡΠ΅Π΄ΠΊΠΎ.

Π ΠΈΡ. 7. ΠΠ° ΡΠΎΡΠΎ ΡΠΎΠΆΠΈΡΡΠΎΠ΅ Π²ΠΎΡΠΏΠ°Π»Π΅Π½ΠΈΠ΅ ΠΊΠΎΠΆΠΈ.
ΠΊ ΡΠΎΠ΄Π΅ΡΠΆΠ°Π½ΠΈΡ βΠΡΠΈΠ·Π½Π°ΠΊΠΈ ΠΈ ΡΠΈΠΌΠΏΡΠΎΠΌΡ ΡΠΎΠΆΠΈ ΠΏΡΠΈ ΡΠ°Π·Π½ΡΡ ΡΠΎΡΠΌΠ°Ρ Π·Π°Π±ΠΎΠ»Π΅Π²Π°Π½ΠΈΡ
ΠΡΠΈΠ·Π½Π°ΠΊΠΈ ΠΈ ΡΠΈΠΌΠΏΡΠΎΠΌΡ ΡΠΎΠΆΠΈΡΡΠΎΠ³ΠΎ Π²ΠΎΡΠΏΠ°Π»Π΅Π½ΠΈΡ Π² ΠΈΠ½ΠΊΡΠ±Π°ΡΠΈΠΎΠ½Π½ΡΠΉ ΠΏΠ΅ΡΠΈΠΎΠ΄
ΠΠ½ΠΊΡΠ±Π°ΡΠΈΠΎΠ½Π½ΡΠΉ ΠΏΠ΅ΡΠΈΠΎΠ΄ ΠΏΡΠΈ ΡΠΎΠΆΠΈΡΡΠΎΠΌ Π²ΠΎΡΠΏΠ°Π»Π΅Π½ΠΈΠΈ ΠΊΠΎΠΆΠΈ Π² ΡΠ»ΡΡΠ°Π΅ ΠΏΠΎΠΏΠ°Π΄Π°Π½ΠΈΡ ΠΈΠ½ΡΠ΅ΠΊΡΠΈΠΈ ΠΈΠ·Π²Π½Π΅ ΡΠΎΡΡΠ°Π²Π»ΡΠ΅Ρ ΠΎΡ 3 Π΄ΠΎ 5 ΡΡΡΠΎΠΊ. ΠΠ°ΠΊ ΠΏΡΠ°Π²ΠΈΠ»ΠΎ, Π·Π°Π±ΠΎΠ»Π΅Π²Π°Π½ΠΈΠ΅ Π½Π°ΡΠΈΠ½Π°Π΅ΡΡΡ ΠΎΡΡΡΠΎ, Ρ ΡΠΎΡΠ½ΠΎΠ³ΠΎ ΡΠΊΠ°Π·Π°Π½ΠΈΡ ΡΠ°ΡΠ° Π²ΠΎΠ·Π½ΠΈΠΊΠ½ΠΎΠ²Π΅Π½ΠΈΡ ΠΏΠ΅ΡΠ²ΡΡ ΡΠΈΠΌΠΏΡΠΎΠΌΠΎΠ² ΠΈ ΠΏΡΠΈΠ·Π½Π°ΠΊΠΎΠ². ΠΠΎΠ»ΠΎΠ²Π½Π°Ρ Π±ΠΎΠ»Ρ, ΠΎΠ±ΡΠ°Ρ ΡΠ»Π°Π±ΠΎΡΡΡ, ΠΏΠΎΠ²ΡΡΠ΅Π½ΠΈΠ΅ ΡΠ΅ΠΌΠΏΠ΅ΡΠ°ΡΡΡΡ ΡΠ΅Π»Π° Π΄ΠΎ 39 β 40Β°Π‘, ΠΎΠ·Π½ΠΎΠ±, ΠΌΡΡΠ΅ΡΠ½ΡΠ΅ ΠΈ ΡΡΡΡΠ°Π²Π½ΡΠ΅ Π±ΠΎΠ»ΠΈ, ΡΠ°ΡΡΠΎ ΡΠΎΡΠ½ΠΎΡΠ° ΠΈ ΡΠ²ΠΎΡΠ°, ΡΠ΅ΠΆΠ΅ ΡΡΠ΄ΠΎΡΠΎΠ³ΠΈ ΠΈ ΡΠ°ΡΡΡΡΠΎΠΉΡΡΠ²Π° ΡΠΎΠ·Π½Π°Π½ΠΈΡ β ΠΎΡΠ½ΠΎΠ²Π½ΡΠ΅ ΠΏΡΠΈΠ·Π½Π°ΠΊΠΈ ΠΈ ΡΠΈΠΌΠΏΡΠΎΠΌΡ ΡΠΎΠΆΠΈ Π² ΡΡΠΎΡ ΠΏΠ΅ΡΠΈΠΎΠ΄. ΠΠ½ΡΠΎΠΊΡΠΈΠΊΠ°ΡΠΈΡ ΠΏΡΠΈ ΡΠΎΠΆΠΈΡΡΠΎΠΌ Π²ΠΎΡΠΏΠ°Π»Π΅Π½ΠΈΠΈ ΡΠ°Π·Π²ΠΈΠ²Π°Π΅ΡΡΡ Π² ΡΠ΅Π·ΡΠ»ΡΡΠ°ΡΠ΅ Π²ΡΡ ΠΎΠ΄Π° Π² ΠΊΡΠΎΠ²ΡΠ½ΠΎΠ΅ ΡΡΡΠ»ΠΎ ΡΠΎΠΊΡΠΈΠ½ΠΎΠ² ΡΡΡΠ΅ΠΏΡΠΎΠΊΠΎΠΊΠΊΠΎΠ².
ΠΠ΄Π½ΠΎΠ²ΡΠ΅ΠΌΠ΅Π½Π½ΠΎ Ρ ΡΡΠΈΠΌ ΠΏΠΎΡΠ²Π»ΡΡΡΡΡ ΠΏΠ΅ΡΠ²ΡΠ΅ ΠΏΡΠΈΠ·Π½Π°ΠΊΠΈ ΠΌΠ΅ΡΡΠ½ΠΎΠ³ΠΎ ΠΏΠΎΡΠ°ΠΆΠ΅Π½ΠΈΡ. ΠΠ½ΠΎΠ³Π΄Π° ΠΌΠ΅ΡΡΠ½ΡΠ΅ ΡΠΈΠΌΠΏΡΠΎΠΌΡ ΡΠ°Π·Π²ΠΈΠ²Π°ΡΡΡΡ ΡΠΏΡΡΡΡ 6 -10 ΡΠ°ΡΠΎΠ² ΠΎΡ Π½Π°ΡΠ°Π»Π° Π·Π°Π±ΠΎΠ»Π΅Π²Π°Π½ΠΈΡ.
Π‘ΡΡΠ΅ΠΏΡΠΎΠΊΠΎΠΊΠΊΠΈ ΠΎΠ±Π»Π°Π΄Π°ΡΡ ΡΡΠΎΠΏΠ½ΠΎΡΡΡΡ ΠΊ Π»ΠΈΠΌΡΠ°ΡΠΈΡΠ΅ΡΠΊΠΎΠΉ ΡΠΈΡΡΠ΅ΠΌΠ΅, Π³Π΄Π΅ ΠΎΠ½ΠΈ Π±ΡΡΡΡΠΎ ΡΠ°Π·ΠΌΠ½ΠΎΠΆΠ°ΡΡΡΡ ΠΈ ΡΠ°ΡΠΏΡΠΎΡΡΡΠ°Π½ΡΡΡΡΡ Π² ΡΠ΅Π³ΠΈΠΎΠ½Π°Π»ΡΠ½ΡΠ΅ Π»ΠΈΠΌΡΠ°ΡΠΈΡΠ΅ΡΠΊΠΈΠ΅ ΡΠ·Π»Ρ, ΠΊΠΎΡΠΎΡΡΠ΅ Π² ΡΠ΅Π·ΡΠ»ΡΡΠ°ΡΠ΅ ΡΠ°Π·Π²ΠΈΠ²ΡΠ΅Π³ΠΎΡΡ Π²ΠΎΡΠΏΠ°Π»Π΅Π½ΠΈΡ ΡΠ²Π΅Π»ΠΈΡΠΈΠ²Π°ΡΡΡΡ. ΠΠΈΡ ΠΎΡΠ°Π΄ΠΊΠ° ΠΈ ΡΠΎΠΊΡΠΈΠΊΠΎΠ· ΡΠΎΡ ΡΠ°Π½ΡΡΡΡΡ Π΄ΠΎ 7-ΠΈ Π΄Π½Π΅ΠΉ, ΡΠ΅ΠΆΠ΅ β Π΄ΠΎΠ»ΡΡΠ΅.
ΠΡΠ΅ ΡΠΎΡΠΌΡ ΡΠΎΠΆΠΈΡΡΠΎΠ³ΠΎ Π²ΠΎΡΠΏΠ°Π»Π΅Π½ΠΈΡ ΡΠΎΠΏΡΠΎΠ²ΠΎΠΆΠ΄Π°ΡΡΡΡ Π²ΠΎΡΠΏΠ°Π»Π΅Π½ΠΈΠ΅ΠΌ Π»ΠΈΠΌΡΠ°ΡΠΈΡΠ΅ΡΠΊΠΈΡ ΡΠΎΡΡΠ΄ΠΎΠ² ΠΈ Π»ΠΈΠΌΡΠ°ΡΠΈΡΠ΅ΡΠΊΠΈΡ ΡΠ·Π»ΠΎΠ².

Π ΠΈΡ. 8. ΠΠ° ΡΠΎΡΠΎ ΡΠΎΠΆΠ° (erysipelas) Ρ Π΄Π΅ΡΠ΅ΠΉ (ΡΠΎΠΆΠΈΡΡΠΎΠ΅ Π²ΠΎΡΠΏΠ°Π»Π΅Π½ΠΈΠ΅ Π»ΠΈΡΠ°).
ΠΡΠΈΠ·Π½Π°ΠΊΠΈ ΠΈ ΡΠΈΠΌΠΏΡΠΎΠΌΡ ΡΠΎΠΆΠΈΡΡΠΎΠ³ΠΎ Π²ΠΎΡΠΏΠ°Π»Π΅Π½ΠΈΡ ΠΊΠΎΠΆΠΈ ΠΏΡΠΈ ΡΡΠΈΡΠ΅ΠΌΠ°ΡΠΎΠ·Π½ΠΎΠΉ ΡΠΎΡΠΌΠ΅ Π·Π°Π±ΠΎΠ»Π΅Π²Π°Π½ΠΈΡ
Π§ΡΠ²ΡΡΠ²ΠΎ ΠΆΠΆΠ΅Π½ΠΈΡ ΠΈ ΡΠ°ΡΠΏΠΈΡΠ°ΡΡΠ°Ρ Π±ΠΎΠ»Ρ Π½Π° ΠΌΠ΅ΡΡΠ΅ ΠΏΠΎΡΠ°ΠΆΠ΅Π½ΠΈΡ β ΠΏΠ΅ΡΠ²ΡΠ΅ ΡΠΈΠΌΠΏΡΠΎΠΌΡ ΡΠΎΠΆΠΈ. ΠΠΎΠΊΡΠ°ΡΠ½Π΅Π½ΠΈΠ΅ ΠΈ ΠΎΡΠ΅ΠΊ β ΠΏΠ΅ΡΠ²ΡΠ΅ ΠΏΡΠΈΠ·Π½Π°ΠΊΠΈ Π·Π°Π±ΠΎΠ»Π΅Π²Π°Π½ΠΈΡ. Π ΠΎΠ±Π»Π°ΡΡΠΈ ΠΏΠΎΡΠ°ΠΆΠ΅Π½ΠΈΡ ΠΊΠΎΠΆΠ° Π³ΠΎΡΡΡΠ°Ρ Π½Π° ΠΎΡΡΠΏΡ ΠΈ Π½Π°ΠΏΡΡΠΆΠ΅Π½Π°. ΠΠΎΡΠΏΠ°Π»ΠΈΡΠ΅Π»ΡΠ½ΡΠΉ ΠΎΡΠ°Π³ Π±ΡΡΡΡΠΎ ΡΠ²Π΅Π»ΠΈΡΠΈΠ²Π°Π΅ΡΡΡ Π² ΡΠ°Π·ΠΌΠ΅ΡΠ°Ρ . Π ΠΎΠΆΠΈΡΡΠ°Ρ Π±Π»ΡΡΠΊΠ° ΠΎΡΠ³ΡΠ°Π½ΠΈΡΠ΅Π½Π° ΠΎΡ ΠΎΠΊΡΡΠΆΠ°ΡΡΠΈΡ ΡΠΊΠ°Π½Π΅ΠΉ Π²Π°Π»ΠΈΠΊΠΎΠΌ, ΠΈΠΌΠ΅Π΅Ρ Π·ΡΠ±ΡΠ°ΡΡΠ΅ ΠΊΡΠ°Ρ ΠΈ Π½Π°ΠΏΠΎΠΌΠΈΠ½Π°Π΅Ρ ΡΠ·ΡΠΊΠΈ ΠΏΠ»Π°ΠΌΠ΅Π½ΠΈ. Π ΡΠΊΠ°Π½ΡΡ ΠΈ ΠΊΠ°ΠΏΠΈΠ»Π»ΡΡΠ°Ρ Π·ΠΎΠ½Ρ ΠΏΠΎΡΠ°ΠΆΠ΅Π½ΠΈΡ Π½Π°Ρ ΠΎΠ΄ΠΈΡΡΡ ΠΌΠ½ΠΎΠΆΠ΅ΡΡΠ²ΠΎ ΡΡΡΠ΅ΠΏΡΠΎΠΊΠΎΠΊΠΊΠΎΠ², ΠΊΠΎΡΠΎΡΡΠ΅ ΠΌΠΎΠΆΠ½ΠΎ Π²ΡΡΠ²ΠΈΡΡ ΠΏΡΠΈ ΠΏΡΠΎΡΡΠΎΠΉ ΠΌΠΈΠΊΡΠΎΡΠΊΠΎΠΏΠΈΠΈ ΠΌΠ°Π·ΠΊΠ°. ΠΡΠΎΡΠ΅ΡΡ ΠΏΡΠΎΠ΄ΠΎΠ»ΠΆΠ°Π΅ΡΡΡ Π΄ΠΎ 1 β 2 Π½Π΅Π΄Π΅Π»Ρ. ΠΠΎΠΊΡΠ°ΡΠ½Π΅Π½ΠΈΠ΅ ΠΈΡΡΠ΅Π·Π°Π΅Ρ ΠΏΠΎΡΡΠ΅ΠΏΠ΅Π½Π½ΠΎ, ΠΊΡΠ°Ρ ΡΡΠΈΡΠ΅ΠΌΡ ΡΠ°Π·ΠΌΡΠ²Π°ΡΡΡΡ, ΡΠΏΠ°Π΄Π°Π΅Ρ ΠΎΡΠ΅ΠΊ. ΠΠ΅ΡΡ Π½ΠΈΠΉ ΡΠ»ΠΎΠΉ ΡΠΏΠΈΠ΄Π΅ΡΠΌΠΈΡΠ° ΡΠ»ΡΡΠΈΠ²Π°Π΅ΡΡΡ ΠΈ ΡΠΏΠ»ΠΎΡΠ½ΡΠ΅ΡΡΡ, ΠΈΠ½ΠΎΠ³Π΄Π° ΠΏΠΎΡΠ²Π»ΡΡΡΡΡ ΠΏΠΈΠ³ΠΌΠ΅Π½ΡΠ½ΡΠ΅ ΠΏΡΡΠ½Π°. Π‘ΡΠΎΠΉΠΊΠΈΠΉ ΠΎΡΠ΅ΠΊ Π³ΠΎΠ²ΠΎΡΠΈΡ ΠΎ ΡΠ°Π·Π²ΠΈΡΠΈΠΈ Π»ΠΈΠΌΡΠΎΡΡΠ°Π·Π°.
Π ΠΈΡ. 9. ΠΠ° ΡΠΎΡΠΎ ΡΡΠΈΡΠ΅ΠΌΠ°ΡΠΎΠ·Π½Π°Ρ ΡΠΎΡΠΌΠ° ΡΠΎΠΆΠΈ Π½Π° Π½ΠΎΠ³Π΅.
ΠΡΠΈΠ·Π½Π°ΠΊΠΈ ΠΈ ΡΠΈΠΌΠΏΡΠΎΠΌΡ ΡΠΎΠΆΠΈΡΡΠΎΠ³ΠΎ Π²ΠΎΡΠΏΠ°Π»Π΅Π½ΠΈΡ ΠΊΠΎΠΆΠΈ ΠΏΡΠΈ ΡΡΠΈΡΠ΅ΠΌΠ°ΡΠΎΠ·Π½ΠΎ-Π±ΡΠ»Π»Π΅Π·Π½ΠΎΠΉ ΡΠΎΡΠΌΠ΅ Π·Π°Π±ΠΎΠ»Π΅Π²Π°Π½ΠΈΡ
ΠΡΠΈΡΠ΅ΠΌΠ°ΡΠΎΠ·Π½ΠΎ-Π±ΡΠ»Π»Π΅Π·Π½ΠΎΠΉ ΡΠΎΡΠΌΠ° Π·Π°Π±ΠΎΠ»Π΅Π²Π°Π½ΠΈΡ Ρ Π°ΡΠ°ΠΊΡΠ΅ΡΠΈΠ·ΡΠ΅ΡΡΡ ΠΏΠΎΡΠ²Π»Π΅Π½ΠΈΠ΅ΠΌ ΠΏΡΠ·ΡΡΡΠΊΠΎΠ² ΠΈ ΠΏΡΠ·ΡΡΠ΅ΠΉ Π½Π° ΠΏΠΎΡΠ°ΠΆΠ΅Π½Π½ΠΎΠΌ ΡΡΠ°ΡΡΠΊΠ΅ ΠΊΠΎΠΆΠΈ. ΠΡΠ»Π»Π΅Π·Π½ΡΠ΅ ΡΠ»Π΅ΠΌΠ΅Π½ΡΡ ΡΠΎΠ΄Π΅ΡΠΆΠ°Ρ ΡΠ²Π΅ΡΠ»ΡΡ ΠΏΡΠΎΠ·ΡΠ°ΡΠ½ΡΡ ΠΆΠΈΠ΄ΠΊΠΎΡΡΡ (ΡΠΊΡΡΡΠ΄Π°Ρ). ΠΠ½ΠΎΠ³Π΄Π° ΡΠΊΡΡΡΠ΄Π°Ρ ΡΡΠ°Π½ΠΎΠ²ΠΈΡΡΡ ΠΌΡΡΠ½ΡΠΌ, Π° ΠΏΡΠ·ΡΡΡΠΊΠΈ ΠΏΡΠ΅Π²ΡΠ°ΡΠ°ΡΡΡΡ Π² ΠΏΡΡΡΡΠ»Ρ. Π‘ΠΎ Π²ΡΠ΅ΠΌΠ΅Π½Π΅ΠΌ ΠΏΡΠ·ΡΡΠΈ ΡΠΏΠ°Π΄Π°ΡΡΡΡ, Π½Π° ΠΈΡ ΠΌΠ΅ΡΡΠ΅ ΠΎΠ±ΡΠ°Π·ΡΡΡΡΡ ΠΊΠΎΡΠΊΠΈ Π±ΡΡΠΎΠ³ΠΎ ΡΠ²Π΅ΡΠ°, ΠΏΠ»ΠΎΡΠ½ΡΠ΅ Π½Π° ΠΎΡΡΠΏΡ. Π§Π΅ΡΠ΅Π· 2 β 3 Π½Π΅Π΄Π΅Π»ΠΈ ΠΊΠΎΡΠΊΠΈ ΠΎΡΡΠΎΡΠ³Π°ΡΡΡΡ, ΠΎΠ±Π½Π°ΠΆΠ°Ρ ΡΡΠΎΠ·ΠΈΠ²Π½ΡΡ ΠΏΠΎΠ²Π΅ΡΡ Π½ΠΎΡΡΡ. Π£ Π½Π΅ΠΊΠΎΡΠΎΡΡΡ Π±ΠΎΠ»ΡΠ½ΡΡ ΠΏΠΎΡΠ²Π»ΡΡΡΡΡ ΡΡΠΎΡΠΈΡΠ΅ΡΠΊΠΈΠ΅ ΡΠ·Π²Ρ. ΠΠΏΠΈΡΠ΅Π»ΠΈΠ·Π°ΡΠΈΡ ΠΏΠΎΡΠ°ΠΆΠ΅Π½Π½ΠΎΠΉ ΠΏΠΎΠ²Π΅ΡΡ Π½ΠΎΡΡΠΈ ΠΏΡΠΎΠΈΡΡ ΠΎΠ΄ΠΈΡ ΠΌΠ΅Π΄Π»Π΅Π½Π½ΠΎ.

Π ΠΈΡ. 10. ΠΡΠΈ ΡΡΠΈΡΠ΅ΠΌΠ°ΡΠΎΠ·Π½ΠΎ-Π±ΡΠ»Π»Π΅Π·Π½ΠΎΠΉ ΡΠΎΡΠΌΠ΅ ΡΠΎΠΆΠΈΡΡΠΎΠ³ΠΎ Π²ΠΎΡΠΏΠ°Π»Π΅Π½ΠΈΡ Π½Π° ΠΌΠ΅ΡΡΠ΅ ΡΠΏΠ°Π²ΡΠΈΡ ΡΡ ΠΏΡΠ·ΡΡΡΠΊΠΎΠ² ΠΎΠ±ΡΠ°Π·ΡΡΡΡΡ ΠΊΠΎΡΠΊΠΈ Π±ΡΡΠΎΠ³ΠΎ ΠΈΠ»ΠΈ ΡΠ΅ΡΠ½ΠΎΠ³ΠΎ ΡΠ²Π΅ΡΠ°.
ΠΡΠΈΠ·Π½Π°ΠΊΠΈ ΠΈ ΡΠΈΠΌΠΏΡΠΎΠΌΡ ΡΠΎΠΆΠΈ ΠΏΡΠΈ ΡΡΠΈΡΠ΅ΠΌΠ°ΡΠΎΠ·Π½ΠΎ-Π³Π΅ΠΌΠΎΡΡΠ°Π³ΠΈΡΠ΅ΡΠΊΠΎΠΉ ΡΠΎΡΠΌΠ΅ Π·Π°Π±ΠΎΠ»Π΅Π²Π°Π½ΠΈΡ
ΠΠ°Π½Π½Π°Ρ ΡΠΎΡΠΌΠ° ΡΠΎΠΆΠΈΡΡΠΎΠ³ΠΎ Π²ΠΎΡΠΏΠ°Π»Π΅Π½ΠΈΡ ΠΊΠΎΠΆΠΈ Π²ΡΡΡΠ΅ΡΠ°Π΅ΡΡΡ Π²ΡΠ΅ ΡΠ°ΡΠ΅ Π² ΠΏΠΎΡΠ»Π΅Π΄Π½Π΅Π΅ Π²ΡΠ΅ΠΌΡ, Π° Π² Π½Π΅ΠΊΠΎΡΠΎΡΡΡ ΡΠ΅Π³ΠΈΠΎΠ½Π°Ρ Π½Π°ΡΠ΅ΠΉ ΡΡΡΠ°Π½Ρ ΠΎΠ½Π° Π·Π°Π½ΠΈΠΌΠ°Π΅Ρ ΠΏΠ΅ΡΠ²ΠΎΠ΅ ΠΌΠ΅ΡΡΠΎ ΡΡΠ΅Π΄ΠΈ Π²ΡΠ΅Ρ ΡΠΎΡΠΌ Π΄Π°Π½Π½ΠΎΠ³ΠΎ Π·Π°Π±ΠΎΠ»Π΅Π²Π°Π½ΠΈΡ.
Π§ΡΠ²ΡΡΠ²ΠΎ ΠΆΠΆΠ΅Π½ΠΈΡ ΠΈ ΡΠ°ΡΠΏΠΈΡΠ°ΡΡΠ°Ρ Π±ΠΎΠ»Ρ, ΠΏΠΎΠΊΡΠ°ΡΠ½Π΅Π½ΠΈΠ΅, ΠΎΡΠ΅ΠΊ ΠΈ ΠΌΠ΅Π»ΠΊΠΎΡΠΎΡΠ΅ΡΠ½ΡΠ΅ (Π΄ΠΎ 3-Ρ ΠΌΠΌ) ΠΊΡΠΎΠ²ΠΎΠΈΠ·Π»ΠΈΡΠ½ΠΈΡ (ΠΏΠ΅ΡΠ΅Ρ ΠΈΠΈ) β ΠΎΡΠ½ΠΎΠ²Π½ΡΠ΅ ΠΏΡΠΈΠ·Π½Π°ΠΊΠΈ ΠΈ ΡΠΈΠΌΠΏΡΠΎΠΌΡ ΠΏΡΠΈ ΡΡΠΈΡΠ΅ΠΌΠ°ΡΠΎΠ·Π½ΠΎ-Π³Π΅ΠΌΠΎΡΡΠ°Π³ΠΈΡΠ΅ΡΠΊΠΎΠΉ ΡΠΎΡΠΌΠ΅ Π·Π°Π±ΠΎΠ»Π΅Π²Π°Π½ΠΈΡ. ΠΡΠΎΠ²ΠΎΠΈΠ·Π»ΠΈΡΠ½ΠΈΡ Π½Π° ΡΡΠ°ΡΡΠΊΠ΅ ΠΏΠΎΡΠ°ΠΆΠ΅Π½ΠΈΡ ΡΠ²Π»ΡΡΡΡΡ ΡΠ»Π΅Π΄ΡΡΠ²ΠΈΠ΅ΠΌ Π²ΡΡ ΠΎΠ΄Π° ΠΊΡΠΎΠ²ΠΈ ΠΈΠ· ΠΏΠΎΠ²ΡΠ΅ΠΆΠ΄Π΅Π½Π½ΡΡ ΠΌΠ΅Π»ΠΊΠΈΡ ΠΊΡΠΎΠ²Π΅Π½ΠΎΡΠ½ΡΡ ΡΠΎΡΡΠ΄ΠΎΠ² Π² ΠΌΠ΅ΠΆΠΊΠ»Π΅ΡΠΎΡΠ½ΠΎΠ΅ ΠΏΡΠΎΡΡΡΠ°Π½ΡΡΠ²ΠΎ.
ΠΠ»Ρ Π·Π°Π±ΠΎΠ»Π΅Π²Π°Π½ΠΈΡ Ρ Π°ΡΠ°ΠΊΡΠ΅ΡΠ½Π° Π±ΠΎΠ»Π΅Π΅ Π΄Π»ΠΈΡΠ΅Π»ΡΠ½Π°Ρ (Π΄ΠΎ 2-Ρ Π½Π΅Π΄Π΅Π»Ρ) Π»ΠΈΡ ΠΎΡΠ°Π΄ΠΊΠ° ΠΈ ΠΌΠ΅Π΄Π»Π΅Π½Π½ΠΎΠ΅ ΠΎΠ±ΡΠ°ΡΠ½ΠΎΠ΅ ΡΠ°Π·Π²ΠΈΡΠΈΠ΅. Π‘ΡΠ΅Π΄ΠΈ ΠΎΡΠ»ΠΎΠΆΠ½Π΅Π½ΠΈΠΉ ΠΈΠ½ΠΎΠ³Π΄Π° ΠΎΡΠΌΠ΅ΡΠ°Π΅ΡΡΡ Π½Π΅ΠΊΡΠΎΠ· ΠΊΠΎΠΆΠΈ.

Π ΠΈΡ. 11. Π ΠΎΠΆΠΈΡΡΠΎΠ΅ Π²ΠΎΡΠΏΠ°Π»Π΅Π½ΠΈΠ΅ ΡΡΠΊΠΈ. ΠΠ΅Π»ΠΊΠΎΡΠΎΡΠ΅ΡΠ½ΡΠ΅ ΠΊΡΠΎΠ²ΠΎΠΈΠ·Π»ΠΈΡΠ½ΠΈΡ (ΠΏΠ΅ΡΠ΅Ρ ΠΈΠΈ) β ΠΎΡΠ½ΠΎΠ²Π½ΠΎΠΉ ΠΏΡΠΈΠ·Π½Π°ΠΊ ΡΡΠΈΡΠ΅ΠΌΠ°ΡΠΎΠ·Π½ΠΎ-Π³Π΅ΠΌΠΎΡΡΠ°Π³ΠΈΡΠ΅ΡΠΊΠΎΠΉ ΡΠΎΡΠΌΡ ΡΠΎΠΆΠΈ.
ΠΡΠΈΠ·Π½Π°ΠΊΠΈ ΠΈ ΡΠΈΠΌΠΏΡΠΎΠΌΡ ΡΠΎΠΆΠΈ ΠΏΡΠΈ Π±ΡΠ»Π»Π΅Π·Π½ΠΎ -Π³Π΅ΠΌΠΎΡΡΠ°Π³ΠΈΡΠ΅ΡΠΊΠΎΠΉ ΡΠΎΡΠΌΠ΅ Π·Π°Π±ΠΎΠ»Π΅Π²Π°Π½ΠΈΡ
ΠΡΠ»Π»Π΅Π·Π½ΠΎ-Π³Π΅ΠΌΠΎΡΡΠ°Π³ΠΈΡΠ΅ΡΠΊΠ°Ρ ΡΠΎΡΠΌΠ° ΡΠΎΠΆΠΈΡΡΠΎΠ³ΠΎ Π²ΠΎΡΠΏΠ°Π»Π΅Π½ΠΈΡ ΠΊΠΎΠΆΠΈ Ρ Π°ΡΠ°ΠΊΡΠ΅ΡΠΈΠ·ΡΠ΅ΡΡΡ ΠΏΠΎΡΠ²Π»Π΅Π½ΠΈΠ΅ΠΌ Π½Π° ΡΠΎΠ½Π΅ Π³ΠΈΠΏΠ΅ΡΠ΅ΠΌΠΈΠΈ ΠΏΡΠ·ΡΡΠ΅ΠΉ Ρ ΡΠ΅ΡΠΎΠ·Π½ΠΎ-Π³Π΅ΠΌΠΎΡΡΠ°Π³ΠΈΡΠ΅ΡΠΊΠΈΠΌ ΡΠΎΠ΄Π΅ΡΠΆΠΈΠΌΡΠΌ. ΠΡΡΠ΅ΡΠ΅Π½ΠΈΠ΅ ΠΊΡΠΎΠ²ΠΈ ΡΠ²ΡΠ·Π°Π½ΠΎ Ρ Π³Π»ΡΠ±ΠΎΠΊΠΈΠΌ ΠΏΠΎΠ²ΡΠ΅ΠΆΠ΄Π΅Π½ΠΈΠ΅ΠΌ ΠΊΠ°ΠΏΠΈΠ»Π»ΡΡΠΎΠ². ΠΠΎΡΠ»Π΅ ΡΠΏΠ°Π΄Π°Π½ΠΈΡ ΠΏΡΠ·ΡΡΠ΅ΠΉ ΠΎΠ±Π½Π°ΠΆΠ°Π΅ΡΡΡ ΡΡΠΎΠ·ΠΈΠ²Π½Π°Ρ ΠΏΠΎΠ²Π΅ΡΡ Π½ΠΎΡΡΡ, Π½Π° ΠΊΠΎΡΠΎΡΠΎΠΉ ΡΠ°ΡΠΏΠΎΠ»Π°Π³Π°ΡΡΡΡ ΠΊΠΎΡΠΊΠΈ ΡΠ΅ΡΠ½ΠΎΠ³ΠΎ ΡΠ²Π΅ΡΠ°. ΠΠ°ΠΆΠΈΠ²Π»Π΅Π½ΠΈΠ΅ ΠΏΡΠΎΠΈΡΡ ΠΎΠ΄ΠΈΡ ΠΌΠ΅Π΄Π»Π΅Π½Π½ΠΎ. ΠΠ°Π±ΠΎΠ»Π΅Π²Π°Π½ΠΈΠ΅ ΡΠ°ΡΡΠΎ ΠΎΡΠ»ΠΎΠΆΠ½ΡΠ΅ΡΡΡ Π½Π΅ΠΊΡΠΎΠ·ΠΎΠΌ ΠΊΠΎΠΆΠΈ ΠΈ Π²ΠΎΡΠΏΠ°Π»Π΅Π½ΠΈΠ΅ΠΌ ΠΏΠΎΠ΄ΠΊΠΎΠΆΠ½ΠΎΠΉ ΠΆΠΈΡΠΎΠ²ΠΎΠΉ ΠΊΠ»Π΅ΡΡΠ°ΡΠΊΠΈ. ΠΠΎΡΠ»Π΅ Π·Π°ΠΆΠΈΠ²Π»Π΅Π½ΠΈΡ ΠΎΡΡΠ°ΡΡΡΡ ΡΡΠ±ΡΡ ΠΈ ΠΏΠΈΠ³ΠΌΠ΅Π½ΡΠ°ΡΠΈΡ.
Π ΠΈΡ. 12. ΠΠ° ΡΠΎΡΠΎ Π³Π°Π½Π³ΡΠ΅Π½Π° Π½ΠΈΠΆΠ½Π΅ΠΉ ΠΊΠΎΠ½Π΅ΡΠ½ΠΎΡΡΠΈ, ΠΊΠ°ΠΊ ΡΠ΅Π·ΡΠ»ΡΡΠ°Ρ ΠΎΡΠ»ΠΎΠΆΠ½Π΅Π½ΠΈΡ Π±ΡΠ»Π»Π΅Π·Π½ΠΎ-Π³Π΅ΠΌΠΎΡΡΠ°Π³ΠΈΡΠ΅ΡΠΊΠΎΠΉ ΡΠΎΡΠΌΡ ΡΠΎΠΆΠΈΡΡΠΎΠ³ΠΎ Π²ΠΎΡΠΏΠ°Π»Π΅Π½ΠΈΡ.
ΠΊ ΡΠΎΠ΄Π΅ΡΠΆΠ°Π½ΠΈΡ βΠΡΠ»Π»Π΅Π·Π½ΡΠ΅ ΠΈ Π³Π΅ΠΌΠΎΡΡΠ°Π³ΠΈΡΠ΅ΡΠΊΠΈΠ΅ ΡΠΎΡΠΌΡ Π·Π°Π±ΠΎΠ»Π΅Π²Π°Π½ΠΈΡ ΠΏΡΠΈΠ²ΠΎΠ΄ΡΡ ΠΊ ΡΠ°Π·Π²ΠΈΡΠΈΡ Π»ΠΈΠΌΡΠΎΡΡΠ°Π·Π°.
ΠΡΠΈΠ·Π½Π°ΠΊΠΈ ΠΈ ΡΠΈΠΌΠΏΡΠΎΠΌΡ ΠΎΡΠ»ΠΎΠΆΠ½Π΅Π½Π½ΡΡ ΡΠΎΡΠΌ ΡΠΎΠΆΠΈΡΡΠΎΠ³ΠΎ Π²ΠΎΡΠΏΠ°Π»Π΅Π½ΠΈΡ
Π€Π»Π΅Π³ΠΌΠΎΠ½ΠΎΠ·Π½Π°Ρ ΠΈ Π½Π΅ΠΊΡΠΎΡΠΈΡΠ΅ΡΠΊΠ°Ρ ΡΠΎΡΠΌΡ ΡΠΎΠΆΠΈΡΡΠΎΠ³ΠΎ Π²ΠΎΡΠΏΠ°Π»Π΅Π½ΠΈΡ ΠΊΠΎΠΆΠΈ ΡΠ°ΡΡΠ΅Π½ΠΈΠ²Π°ΡΡΡΡ, ΠΊΠ°ΠΊ ΠΎΡΠ»ΠΎΠΆΠ½Π΅Π½ΠΈΡ Π·Π°Π±ΠΎΠ»Π΅Π²Π°Π½ΠΈΡ.
ΠΡΠΈ ΡΠ°ΡΠΏΡΠΎΡΡΡΠ°Π½Π΅Π½ΠΈΠΈ Π²ΠΎΡΠΏΠ°Π»Π΅Π½ΠΈΡ Π½Π° ΠΏΠΎΠ΄ΠΊΠΎΠΆΠ½ΡΡ ΠΆΠΈΡΠΎΠ²ΡΡ ΠΊΠ»Π΅ΡΡΠ°ΡΠΊΡ ΠΈ ΡΠΎΠ΅Π΄ΠΈΠ½ΠΈΡΠ΅Π»ΡΠ½ΡΡ ΡΠΊΠ°Π½Ρ ΡΠ°Π·Π²ΠΈΠ²Π°Π΅ΡΡΡ ΡΠ»Π΅Π³ΠΌΠΎΠ½ΠΎΠ·Π½ΠΎΠ΅ Π²ΠΎΡΠΏΠ°Π»Π΅Π½ΠΈΠ΅. ΠΠ° ΠΏΠΎΡΠ°ΠΆΠ΅Π½Π½ΠΎΠΌ ΡΡΠ°ΡΡΠΊΠ΅ ΠΊΠΎΠΆΠΈ ΠΏΠΎΡΠ²Π»ΡΡΡΡΡ ΠΏΡΠ·ΡΡΠΈ, Π½Π°ΠΏΠΎΠ»Π½Π΅Π½Π½ΡΡ Π³Π½ΠΎΠ΅ΠΌ. ΠΠ°Π±ΠΎΠ»Π΅Π²Π°Π½ΠΈΠ΅ ΠΏΡΠΎΡΠ΅ΠΊΠ°Π΅Ρ ΡΡΠΆΠ΅Π»ΠΎ, Ρ Π²ΡΡΠ°ΠΆΠ΅Π½Π½ΠΎΠΉ ΠΈΠ½ΡΠΎΠΊΡΠΈΠΊΠ°ΡΠΈΠ΅ΠΉ. ΠΠΎΡΠ°ΠΆΠ΅Π½Π½ΡΠΉ ΡΡΠ°ΡΡΠΎΠΊ ΠΊΠΎΠΆΠΈ ΡΠ°ΡΡΠΎ ΠΈΠ½ΡΠΈΡΠΈΡΡΠ΅ΡΡΡ ΡΡΠ°ΡΠΈΠ»ΠΎΠΊΠΎΠΊΠΊΠ°ΠΌΠΈ. Π€Π»Π΅Π³ΠΌΠΎΠ½ΠΎΠ·Π½Π°Ρ ΡΠΎΡΠΌΠ° ΡΠΎΠΆΠΈ Π½Π΅ΡΠ΅Π΄ΠΊΠΎ ΡΡΠ°Π½ΠΎΠ²ΠΈΡΡΡ ΠΏΡΠΈΡΠΈΠ½ΠΎΠΉ ΡΠ΅ΠΏΡΠΈΡΠ°.
ΠΠ΅ΠΊΡΠΎΡΠΈΡΠ΅ΡΠΊΠ°Ρ (Π³Π°Π½Π³ΡΠ΅Π½ΠΎΠ·Π½Π°Ρ) ΡΠΎΡΠΌΠ° ΡΠΎΠΆΠΈΡΡΠΎΠ³ΠΎ Π²ΠΎΡΠΏΠ°Π»Π΅Π½ΠΈΡ ΡΠ°Π·Π²ΠΈΠ²Π°Π΅ΡΡΡ Ρ Π»ΠΈΡ Ρ Π½ΠΈΠ·ΠΊΠΈΠΌ ΠΈΠΌΠΌΡΠ½ΠΈΡΠ΅ΡΠΎΠΌ. ΠΡΠ³ΠΊΠΈΠ΅ ΡΠΊΠ°Π½ΠΈ ΠΏΠΎΠ΄Π²Π΅ΡΠ³Π°ΡΡΡΡ Π½Π΅ΠΊΡΠΎΠ·Ρ (ΠΏΠΎΠ»Π½ΠΎΠΌΡ ΡΠ°Π·ΡΡΡΠ΅Π½ΠΈΡ). ΠΠΎΠ»Π΅Π·Π½Ρ Π½Π°ΡΠΈΠ½Π°Π΅ΡΡΡ ΡΡΡΠ΅ΠΌΠΈΡΠ΅Π»ΡΠ½ΠΎ, ΠΏΡΠΎΡΠ΅ΠΊΠ°Π΅Ρ Ρ Π²ΡΡΠ°ΠΆΠ΅Π½Π½ΠΎΠΉ ΠΈΠ½ΡΠΎΠΊΡΠΈΠΊΠ°ΡΠΈΠ΅ΠΉ, Π±ΡΡΡΡΠΎ ΠΏΡΠΎΠ³ΡΠ΅ΡΡΠΈΡΡΠ΅Ρ. ΠΠΎΡΠ»Π΅ Π·Π°ΠΆΠΈΠ²Π»Π΅Π½ΠΈΡ ΠΎΡΡΠ°ΡΡΡΡ ΠΎΠ±Π΅Π·Π·Π°ΡΠ°ΠΆΠΈΠ²Π°ΡΡΠΈΠ΅ ΡΡΠ±ΡΡ.
ΠΠ΅ΡΠΈΠΎΠ΄ Π²ΠΎΡΡΡΠ°Π½ΠΎΠ²Π»Π΅Π½ΠΈΡ ΠΏΡΠΈ ΡΡΠΆΠ΅Π»ΡΡ ΠΈ ΠΎΡΠ»ΠΎΠΆΠ½Π΅Π½Π½ΡΡ ΡΠΎΡΠΌΠ°Ρ ΡΠΎΠΆΠΈΡΡΠΎΠ³ΠΎ Π²ΠΎΡΠΏΠ°Π»Π΅Π½ΠΈΡ ΠΏΡΠΎΡΠ΅ΠΊΠ°Π΅Ρ ΠΌΠ΅Π΄Π»Π΅Π½Π½ΠΎ. ΠΡΡΠ΅Π½ΠΈΡΠ΅ΡΠΊΠΈΠΉ ΡΠΈΠ½Π΄ΡΠΎΠΌ ΠΏΠΎΡΠ»Π΅ Π²ΡΠ·Π΄ΠΎΡΠΎΠ²Π»Π΅Π½ΠΈΡ ΡΠΎΡ ΡΠ°Π½ΡΠ΅ΡΡΡ ΠΌΠ½ΠΎΠ³ΠΈΠ΅ ΠΌΠ΅ΡΡΡΡ.
Π ΠΈΡ. 13. ΠΠ° ΡΠΎΡΠΎ erysipelas (ΡΠΎΠΆΠ°), ΡΠ»Π΅Π³ΠΌΠΎΠ½ΠΎΠ·Π½ΠΎ-Π½Π΅ΠΊΡΠΎΡΠΈΡΠ΅ΡΠΊΠ°Ρ ΡΠΎΡΠΌΠ° Π·Π°Π±ΠΎΠ»Π΅Π²Π°Π½ΠΈΡ.
ΠΊ ΡΠΎΠ΄Π΅ΡΠΆΠ°Π½ΠΈΡ βΠΡΠΎΠ±Π΅Π½Π½ΠΎΡΡΠΈ ΡΠΎΠΆΠΈΡΡΠΎΠ³ΠΎ Π²ΠΎΡΠΏΠ°Π»Π΅Π½ΠΈΠ΅ Π½Π° ΠΎΡΠ΄Π΅Π»ΡΠ½ΡΡ ΡΡΠ°ΡΡΠΊΠ°Ρ ΡΠ΅Π»Π°
Π§Π°ΡΠ΅ Π²ΡΠ΅Π³ΠΎ ΡΠΎΠΆΠΈΡΡΠΎΠ΅ Π²ΠΎΡΠΏΠ°Π»Π΅Π½ΠΈΠ΅ ΡΠ΅Π³ΠΈΡΡΡΠΈΡΡΠ΅ΡΡΡ Π½Π° ΠΊΠΎΠΆΠ΅ Π½ΠΈΠΆΠ½ΠΈΡ ΠΊΠΎΠ½Π΅ΡΠ½ΠΎΡΡΠ΅ΠΉ, Π½Π΅ΡΠΊΠΎΠ»ΡΠΊΠΎ ΡΠ΅ΠΆΠ΅ β Π½Π° Π²Π΅ΡΡ Π½ΠΈΡ ΠΊΠΎΠ½Π΅ΡΠ½ΠΎΡΡΡΡ ΠΈ Π»ΠΈΡΠ΅, ΡΠ΅Π΄ΠΊΠΎ β Π½Π° ΡΡΠ»ΠΎΠ²ΠΈΡΠ΅, ΡΠ»ΠΈΠ·ΠΈΡΡΡΡ ΠΎΠ±ΠΎΠ»ΠΎΡΠΊΠ°Ρ , ΠΌΠΎΠ»ΠΎΡΠ½ΠΎΠΉ ΠΆΠ΅Π»Π΅Π·Π΅, ΠΌΠΎΡΠΎΠ½ΠΊΠ΅ ΠΈ Π·ΠΎΠ½Π΅ ΠΏΡΠΎΠΌΠ΅ΠΆΠ½ΠΎΡΡΠΈ.
Π ΠΎΠΆΠ° Π½Π° Π½ΠΎΠ³Π΅
Π ΠΎΠΆΠ° Π½Π° Π½ΠΎΠ³Π΅ ΡΠ°Π·Π²ΠΈΠ²Π°Π΅ΡΡΡ Π²ΡΠ»Π΅Π΄ΡΡΠ²ΠΈΠ΅ Π½Π°ΡΡΡΠ΅Π½ΠΈΡ ΡΠ΅Π»ΠΎΡΡΠ½ΠΎΡΡΠΈ ΠΊΠΎΠΆΠ½ΡΡ ΠΏΠΎΠΊΡΠΎΠ²ΠΎΠ², Π²ΠΎΠ·Π½ΠΈΠΊΠ½ΠΎΠ²Π΅Π½ΠΈΠ΅ ΠΊΠΎΡΠΎΡΠΎΠΉ ΡΠ²ΡΠ·Π°Π½ΠΎ Ρ ΡΡΠ°Π²ΠΌΠ°ΠΌΠΈ ΠΈ ΡΡΠΈΠ±Π°ΠΌΠΈ. Π§Π°ΡΡΠΎ Π·Π°Π±ΠΎΠ»Π΅Π²Π°Π½ΠΈΠ΅ ΡΠ°Π·Π²ΠΈΠ²Π°Π΅ΡΡΡ Ρ Π±ΠΎΠ»ΡΠ½ΡΡ Ρ Π³ΡΠΈΠ±ΠΊΠΎΠ²ΡΠΌ ΠΏΠΎΡΠ°ΠΆΠ΅Π½ΠΈΠ΅ΠΌ ΡΡΠΎΠΏ ΠΈ Π½ΠΎΠ³ΡΠ΅ΠΉ Π½Π° Π½ΠΎΠ³Π°Ρ , Π½Π°ΡΡΡΠ΅Π½ΠΈΠ΅ΠΌ ΠΊΡΠΎΠ²ΠΎΠΎΠ±ΡΠ°ΡΠ΅Π½ΠΈΡ Π² Π½ΠΈΠΆΠ½ΠΈΡ ΠΊΠΎΠ½Π΅ΡΠ½ΠΎΡΡΡΡ , ΡΠ°Π·Π²ΠΈΠ²ΡΠΈΠΌΡΡ Π² ΡΠ΅Π·ΡΠ»ΡΡΠ°ΡΠ΅ ΡΠ°Ρ Π°ΡΠ½ΠΎΠ³ΠΎ Π΄ΠΈΠ°Π±Π΅ΡΠ°, Π²Π°ΡΠΈΠΊΠΎΠ·Π½ΠΎΠ³ΠΎ ΡΠ°ΡΡΠΈΡΠ΅Π½ΠΈΡ Π²Π΅Π½, ΠΊΡΡΠ΅Π½ΠΈΡ ΠΈ ΠΈΠ·Π±ΡΡΠΎΡΠ½ΠΎΠ³ΠΎ Π²Π΅ΡΠ°. ΠΡΡΠΎΡΠ½ΠΈΠΊΠΎΠΌ ΠΈΠ½ΡΠ΅ΠΊΡΠΈΠΈ ΡΠ°ΠΊ ΠΆΠ΅ ΡΠ²Π»ΡΡΡΡΡ ΠΎΡΠ°Π³ΠΈ Ρ ΡΠΎΠ½ΠΈΡΠ΅ΡΠΊΠΎΠΉ ΠΈΠ½ΡΠ΅ΠΊΡΠΈΠΈ Π² ΠΎΡΠ³Π°Π½ΠΈΠ·ΠΌΠ΅ Π±ΠΎΠ»ΡΠ½ΠΎΠ³ΠΎ.
Π§ΡΠ²ΡΡΠ²ΠΎ ΠΆΠΆΠ΅Π½ΠΈΡ, ΡΠ°ΡΠΏΠΈΡΠ°ΡΡΠ°Ρ Π±ΠΎΠ»Ρ Π½Π° ΠΌΠ΅ΡΡΠ΅ ΠΏΠΎΡΠ°ΠΆΠ΅Π½ΠΈΡ, ΠΏΠΎΠΊΡΠ°ΡΠ½Π΅Π½ΠΈΠ΅ ΠΈ ΠΎΡΠ΅ΠΊ β ΠΏΠ΅ΡΠ²ΡΠ΅ ΠΏΡΠΈΠ·Π½Π°ΠΊΠΈ ΠΈ ΡΠΈΠΌΠΏΡΠΎΠΌΡ ΡΠΎΠΆΠΈ Π½Π° Π½ΠΎΠ³Π°Ρ .
Π ΠΎΠΆΠΈΡΡΠΎΠ΅ Π²ΠΎΡΠΏΠ°Π»Π΅Π½ΠΈΠ΅ Π½Π° Π½ΠΎΠ³Π°Ρ ΡΠ°ΡΠ΅ Π½ΠΎΡΠΈΡ ΡΠ΅ΡΠΈΠ΄ΠΈΠ²ΠΈΡΡΡΡΠΈΠΉ Ρ Π°ΡΠ°ΠΊΡΠ΅Ρ. ΠΠ΅ΠΏΡΠ°Π²ΠΈΠ»ΡΠ½ΠΎΠ΅ Π»Π΅ΡΠ΅Π½ΠΈΠ΅ ΠΈ Π½Π°Π»ΠΈΡΠΈΠ΅ ΠΎΡΠ°Π³ΠΎΠ² Ρ ΡΠΎΠ½ΠΈΡΠ΅ΡΠΊΠΎΠΉ ΠΈΠ½ΡΠ΅ΠΊΡΠΈΠΈ ΡΠΏΠΎΡΠΎΠ±ΡΡΠ²ΡΡΡ ΡΠ°Π·Π²ΠΈΡΠΈΡ ΡΠ΅ΡΠΈΠ΄ΠΈΠ²ΠΈΡΡΡΡΠ΅ΠΉ ΡΠΎΡΠΌΡ Π·Π°Π±ΠΎΠ»Π΅Π²Π°Π½ΠΈΡ.
Π§Π°ΡΡΡΠ΅ ΡΠ΅ΡΠΈΠ΄ΠΈΠ²Ρ ΠΏΡΠΈΠ²ΠΎΠ΄ΡΡ ΠΊ ΡΠ°Π·Π²ΠΈΡΠΈΡ ΡΠΈΠ±ΡΠΎΠ·Π½ΡΡ ΠΈΠ·ΠΌΠ΅Π½Π΅Π½ΠΈΠΉ Π² Π΄Π΅ΡΠΌΠ΅ ΠΈ ΠΏΠΎΠ΄ΠΊΠΎΠΆΠ½ΠΎΠΉ ΠΊΠ»Π΅ΡΡΠ°ΡΠΊΠ΅ Ρ ΠΏΠΎΡΠ»Π΅Π΄ΡΡΡΠΈΠΌ ΡΠ°Π·Π²ΠΈΡΠΈΠ΅ΠΌ Π»ΠΈΠΌΡΠΎΡΡΠ°Π·Π° ΠΈ ΡΠ»ΠΎΠ½ΠΎΠ²ΠΎΡΡΠΈ.

Π ΠΈΡ. 14. ΠΠ° ΡΠΎΡΠΎ ΡΠΎΠΆΠΈΡΡΠΎΠ΅ Π²ΠΎΡΠΏΠ°Π»Π΅Π½ΠΈΠ΅ Π½ΠΎΠ³.
Π ΠΎΠΆΠΈΡΡΠΎΠ΅ Π²ΠΎΡΠΏΠ°Π»Π΅Π½ΠΈΠ΅ Π½Π° ΡΡΠΊΠ΅
Π ΠΎΠΆΠ° Π½Π° ΡΡΠΊΠ°Ρ ΡΠ°ΡΡΠΎ ΡΠ°Π·Π²ΠΈΠ²Π°Π΅ΡΡΡ Ρ Π½Π°ΡΠΊΠΎΠΌΠ°Π½ΠΎΠ² Π²ΡΠ»Π΅Π΄ΡΡΠ²ΠΈΠ΅ Π²Π½ΡΡΡΠΈΠ²Π΅Π½Π½ΠΎΠ³ΠΎ Π²Π²Π΅Π΄Π΅Π½ΠΈΡ Π½Π°ΡΠΊΠΎΡΠΈΠΊΠΎΠ² ΠΈ Ρ ΠΆΠ΅Π½ΡΠΈΠ½ Π½Π° ΡΠΎΠ½Π΅ Π·Π°ΡΡΠΎΡ Π»ΠΈΠΌΡΡ, ΠΊΠ°ΠΊ ΡΠ»Π΅Π΄ΡΡΠ²ΠΈΡ ΠΏΠ΅ΡΠ΅Π½Π΅ΡΠ΅Π½Π½ΠΎΠΉ ΡΠ°Π΄ΠΈΠΊΠ°Π»ΡΠ½ΠΎΠΉ ΠΌΠ°ΡΡΡΠΊΡΠΎΠΌΠΈΠΈ.
Π ΠΈΡ. 15. Π ΠΎΠΆΠ° Π½Π° ΠΊΠΈΡΡΡΡ ΡΡΠΊ.

Π ΠΈΡ. 16. ΠΠ° ΡΠΎΡΠΎ ΡΠΎΠΆΠΈΡΡΠΎΠ΅ Π²ΠΎΡΠΏΠ°Π»Π΅Π½ΠΈΠ΅ ΡΡΠΊΠΈ.
Π ΠΎΠΆΠ° Π½Π° Π»ΠΈΡΠ΅
Π§Π°ΡΠ΅ Π²ΡΠ΅Π³ΠΎ Π½Π° Π»ΠΈΡΠ΅ Π²ΠΎΠ·Π½ΠΈΠΊΠ°Π΅Ρ ΠΏΠ΅ΡΠ²ΠΈΡΠ½Π°Ρ ΡΡΠΈΡΠ΅ΠΌΠ°ΡΠΎΠ·Π½Π°Ρ ΡΠΎΡΠΌΠ° ΡΠΎΠΆΠΈΡΡΠΎΠ³ΠΎ Π²ΠΎΡΠΏΠ°Π»Π΅Π½ΠΈΡ. ΠΠΎΠΊΡΠ°ΡΠ½Π΅Π½ΠΈΠ΅ ΡΠ°ΡΡΠΎ Π·Π°Ρ Π²Π°ΡΡΠ²Π°Π΅Ρ ΠΎΠ±Π»Π°ΡΡΡ ΡΠ΅ΠΊ ΠΈ Π½ΠΎΡΠ° (ΠΏΠΎ ΡΠΈΠΏΡ Π±Π°Π±ΠΎΡΠΊΠΈ) ΠΈ, ΠΊΡΠΎΠΌΠ΅ ΠΎΡΠ΅ΠΊΠ° ΠΈ Π·ΡΠ΄Π°, ΡΠ°ΡΡΠΎ ΡΠΎΠΏΡΠΎΠ²ΠΎΠΆΠ΄Π°Π΅ΡΡΡ ΡΠΈΠ»ΡΠ½ΡΠΌΠΈ Π±ΠΎΠ»ΡΠΌΠΈ. ΠΠ½ΠΎΠ³Π΄Π° ΠΎΡΠ°Π³ Π²ΠΎΡΠΏΠ°Π»Π΅Π½ΠΈΡ ΡΠ°ΡΠΏΡΠΎΡΡΡΠ°Π½ΡΠ΅ΡΡΡ Π½Π° Π²ΡΠ΅ Π»ΠΈΡΠΎ, Π²ΠΎΠ»ΠΎΡΠΈΡΡΡΡ ΡΠ°ΡΡΡ Π³ΠΎΠ»ΠΎΠ²Ρ, ΠΎΠ±Π»Π°ΡΡΡ Π·Π°ΡΡΠ»ΠΊΠ° ΠΈ ΡΠ΅ΠΈ. Π£ ΡΠ°ΡΡΠΈ Π±ΠΎΠ»ΡΠ½ΡΡ Π·Π°Π±ΠΎΠ»Π΅Π²Π°Π½ΠΈΠ΅ ΠΎΡΠ»ΠΎΠΆΠ½ΡΠ΅ΡΡΡ ΡΠ°Π·Π²ΠΈΡΠΈΠ΅ΠΌ Π°Π±ΡΡΠ΅ΡΡΠΎΠ² Π² ΡΠΎΠ»ΡΠ΅ Π²Π΅ΠΊ ΠΈ ΡΠΊΠΎΠΏΠ»Π΅Π½ΠΈΠ΅ΠΌ Π³Π½ΠΎΡ ΠΏΠΎΠ΄ Π²ΠΎΠ»ΠΎΡΠΈΡΡΠΎΠΉ ΡΠ°ΡΡΡΡ Π³ΠΎΠ»ΠΎΠ²Ρ. ΠΡΠΈ ΡΠ°ΡΠΏΡΠΎΡΡΡΠ°Π½Π΅Π½ΠΈΠΈ ΠΈΠ½ΡΠ΅ΠΊΡΠΈΠΈ Π² ΠΏΠΎΠ΄ΠΊΠΎΠΆΠ½ΡΡ ΠΆΠΈΡΠΎΠ²ΡΡ ΠΊΠ»Π΅ΡΡΠ°ΡΠΊΡ ΡΠ°Π·Π²ΠΈΠ²Π°Π΅ΡΡΡ ΡΠ»Π΅Π³ΠΌΠΎΠ½Π°. Π£ ΠΎΡΠ»Π°Π±Π»Π΅Π½Π½ΡΡ Π»ΠΈΡ ΠΈ ΡΡΠ°ΡΠΈΠΊΠΎΠ² ΠΌΠΎΠΆΠ΅Ρ ΡΠ°Π·Π²ΠΈΡΡΡΡ Π³Π°Π½Π³ΡΠ΅Π½Π°.
ΠΡΡΠΎΡΠ½ΠΈΠΊΠΎΠΌ ΠΈΠ½ΡΠ΅ΠΊΡΠΈΠΈ ΠΏΡΠΈ ΡΠΎΠΆΠΈΡΡΠΎΠΌ Π²ΠΎΡΠΏΠ°Π»Π΅Π½ΠΈΠΈ Π½Π° Π»ΠΈΡΠ΅ ΡΠ°ΡΡΠΎ ΡΠ²Π»ΡΠ΅ΡΡΡ ΡΡΡΠ΅ΠΏΡΠΎΠΊΠΎΠΊΠΊΠΎΠ²Π°Ρ ΠΈΠ½ΡΠ΅ΠΊΡΠΈΡ ΠΏΠ°Π·ΡΡ Π½ΠΎΡΠ° ΠΈ ΡΡΡΡΠ½ΠΊΡΠ»Ρ. ΠΡΡΠΎΡΠ½ΠΈΠΊΠΎΠΌ ΠΈΠ½ΡΠ΅ΠΊΡΠΈΠΈ ΠΏΡΠΈ ΡΠΎΠΆΠΈΡΡΠΎΠΌ Π²ΠΎΡΠΏΠ°Π»Π΅Π½ΠΈΠΈ Π³Π»Π°Π·Π½ΠΈΡΡ ΡΠ²Π»ΡΠ΅ΡΡΡ ΡΡΡΠ΅ΠΏΡΠΎΠΊΠΎΠΊΠΊΠΎΠ²ΡΠΉ ΠΊΠΎΠ½ΡΡΠ½ΠΊΡΠΈΠ²ΠΈΡ.
ΠΡΠΈ ΡΡΡΠ΅ΠΏΡΠΎΠΊΠΎΠΊΠΊΠΎΠ²ΠΎΠΌ ΠΎΡΠΈΡΠ΅ ΠΈΠ½ΠΎΠ³Π΄Π° ΡΠ°Π·Π²ΠΈΠ²Π°Π΅ΡΡΡ ΡΠΎΠΆΠΈΡΡΠΎΠ΅ Π²ΠΎΡΠΏΠ°Π»Π΅Π½ΠΈΠ΅ ΡΡΠ½ΠΎΠΉ ΡΠ°ΠΊΠΎΠ²ΠΈΠ½Ρ, Π½Π΅ΡΠ΅Π΄ΠΊΠΎ Π²ΠΎΡΠΏΠ°Π»ΠΈΡΠ΅Π»ΡΠ½ΡΠΉ ΠΏΡΠΎΡΠ΅ΡΡ ΡΠ°ΡΠΏΡΠΎΡΡΡΠ°Π½ΡΠ΅ΡΡΡ Π½Π° Π²ΠΎΠ»ΠΎΡΠΈΡΡΡΡ ΡΠ°ΡΡΡ Π³ΠΎΠ»ΠΎΠ²Ρ ΠΈ ΡΠ΅Ρ.

Π ΠΈΡ. 17. ΠΠ° Π»ΠΈΡΠ΅ ΡΠ°ΡΠ΅ Π²ΠΎΠ·Π½ΠΈΠΊΠ°Π΅Ρ ΡΡΠΈΡΠ΅ΠΌΠ°ΡΠΎΠ·Π½Π°Ρ ΡΠΎΡΠΌΠ° ΡΠΎΠΆΠΈΡΡΠΎΠ³ΠΎ Π²ΠΎΡΠΏΠ°Π»Π΅Π½ΠΈΡ.

Π ΠΈΡ. 18. Π ΠΎΠΆΠ° Π½Π° Π»ΠΈΡΠ΅. ΠΠΎΠΊΡΠ°ΡΠ½Π΅Π½ΠΈΠ΅ ΡΠ°ΡΡΠΎ Π·Π°Ρ Π²Π°ΡΡΠ²Π°Π΅Ρ ΠΎΠ±Π»Π°ΡΡΡ ΡΠ΅ΠΊ ΠΈ Π½ΠΎΡΠ° (ΠΏΠΎ ΡΠΈΠΏΡ Π±Π°Π±ΠΎΡΠΊΠΈ).

Π ΠΈΡ. 19. ΠΠ½ΠΎΠ³Π΄Π° ΠΎΡΠ°Π³ Π²ΠΎΡΠΏΠ°Π»Π΅Π½ΠΈΡ ΡΠ°ΡΠΏΡΠΎΡΡΡΠ°Π½ΡΠ΅ΡΡΡ Π½Π° Π²ΡΠ΅ Π»ΠΈΡΠΎ, Π²ΠΎΠ»ΠΎΡΠΈΡΡΡΡ ΡΠ°ΡΡΡ Π³ΠΎΠ»ΠΎΠ²Ρ, ΠΎΠ±Π»Π°ΡΡΡ Π·Π°ΡΡΠ»ΠΊΠ° ΠΈ ΡΠ΅ΠΈ.

Π ΠΈΡ. 20. ΠΠ° ΡΠΎΡΠΎ ΡΠΎΠΆΠΈΡΡΠΎΠ΅ Π²ΠΎΡΠΏΠ°Π»Π΅Π½ΠΈΠ΅ ΡΡΠΊΠΈ.
Π ΠΎΠΆΠΈΡΡΠΎΠ΅ Π²ΠΎΡΠΏΠ°Π»Π΅Π½ΠΈΠ΅ ΡΡΠ»ΠΎΠ²ΠΈΡΠ°
Π ΠΎΠΆΠΈΡΡΠΎΠ΅ Π²ΠΎΡΠΏΠ°Π»Π΅Π½ΠΈΠ΅ ΠΈΠ½ΠΎΠ³Π΄Π° ΡΠ°Π·Π²ΠΈΠ²Π°Π΅ΡΡΡ Π² ΠΎΠ±Π»Π°ΡΡΠΈ Ρ ΠΈΡΡΡΠ³ΠΈΡΠ΅ΡΠΊΠΈΡ ΡΠ²ΠΎΠ² ΠΏΡΠΈ Π½Π΅ΡΠΎΠ±Π»ΡΠ΄Π΅Π½ΠΈΠΈ ΠΏΡΠ°Π²ΠΈΠ» Π°ΡΠ΅ΠΏΡΠΈΠΊΠΈ. Π’ΡΠΆΠ΅Π»ΠΎ ΠΏΡΠΎΡΠ΅ΠΊΠ°Π΅Ρ ΡΠΎΠΆΠ° ΠΏΡΠΈ ΠΏΡΠΎΠ½ΠΈΠΊΠ½ΠΎΠ²Π΅Π½ΠΈΠΈ ΡΡΡΠ΅ΠΏΡΠΎΠΊΠΎΠΊΠΊΠΎΠ² Π² ΠΏΡΠΏΠΎΡΠ½ΡΡ ΡΠ°Π½ΠΊΡ Π½ΠΎΠ²ΠΎΡΠΎΠΆΠ΄Π΅Π½Π½ΠΎΠ³ΠΎ. Π ΠΎΠΆΠΈΡΡΠΎΠ΅ Π²ΠΎΡΠΏΠ°Π»Π΅Π½ΠΈΠ΅ ΠΌΠΎΠ»ΠΎΡΠ½ΠΎΠΉ ΠΆΠ΅Π»Π΅Π·Ρ ΡΠ°Π·Π²ΠΈΠ²Π°Π΅ΡΡΡ Π½Π° ΡΠΎΠ½Π΅ ΠΌΠ°ΡΡΠΈΡΠ°. Π Π°Π·Π²ΠΈΡΠΈΠ΅ Π³Π°Π½Π³ΡΠ΅Π½Ρ ΠΌΠΎΠΆΠ΅Ρ ΠΏΡΠΈΠ²Π΅ΡΡΠΈ ΠΊ ΡΡΠ±ΡΠ΅Π²Π°Π½ΠΈΡ Ρ ΠΏΠΎΡΠ»Π΅Π΄ΡΡΡΠΈΠΌ Π½Π°ΡΡΡΠ΅Π½ΠΈΠ΅ΠΌ ΡΡΠ½ΠΊΡΠΈΠΈ ΠΎΡΠ³Π°Π½Π°.
Π ΠΎΠΆΠ° ΠΏΠΎΠ»ΠΎΠ²ΡΡ ΠΎΡΠ³Π°Π½ΠΎΠ² ΠΈ ΠΏΡΠΎΠΌΠ΅ΠΆΠ½ΠΎΡΡΠΈ
ΠΡΠΈ ΡΠΎΠΆΠ΅ ΠΌΠΎΡΠΎΠ½ΠΊΠΈ, ΠΏΠΎΠ»ΠΎΠ²ΠΎΠ³ΠΎ ΡΠ»Π΅Π½Π°, ΠΆΠ΅Π½ΡΠΊΠΈΡ ΠΏΠΎΠ»ΠΎΠ²ΡΡ ΠΎΡΠ³Π°Π½ΠΎΠ² ΠΈ ΠΏΡΠΎΠΌΠ΅ΠΆΠ½ΠΎΡΡΠΈ ΡΠ°ΡΠ΅ Π²ΡΠ΅Π³ΠΎ ΡΠ°Π·Π²ΠΈΠ²Π°Π΅ΡΡΡ ΡΡΠΈΡΠ΅ΠΌΠ°ΡΠΎΠ·Π½Π°Ρ ΡΠΎΡΠΌΠ° Π·Π°Π±ΠΎΠ»Π΅Π²Π°Π½ΠΈΡ Ρ ΡΠ΅Π·ΠΊΠΎ Π²ΡΡΠ°ΠΆΠ΅Π½Π½ΡΠΌ ΠΎΡΠ΅ΠΊΠΎΠΌ ΠΏΠΎΠ΄Π»Π΅ΠΆΠ°ΡΠΈΡ ΡΠΊΠ°Π½Π΅ΠΉ. Π Π°Π·Π²ΠΈΠ²ΡΠΈΠΉΡΡ Π½Π΅ΠΊΡΠΎΠ· ΡΠΊΠ°Π½ΠΈ Ρ ΠΏΠΎΡΠ»Π΅Π΄ΡΡΡΠΈΠΌ ΡΡΠ±ΡΠ΅Π²Π°Π½ΠΈΠ΅ΠΌ ΠΏΡΠΈΠ²ΠΎΠ΄ΠΈΡ ΠΊ Π°ΡΡΠΎΡΠΈΠΈ ΡΠΈΡΠ΅ΠΊ. Π ΠΎΠΆΠ° Ρ ΡΠΎΠΆΠ΅Π½ΠΈΡ ΠΏΡΠΎΡΠ΅ΠΊΠ°Π΅Ρ ΠΊΡΠ°ΠΉΠ½Π΅ ΡΡΠΆΠ΅Π»ΠΎ. ΠΠΎΡΠΏΠ°Π»ΠΈΡΠ΅Π»ΡΠ½ΡΠΉ ΠΏΡΠΎΡΠ΅ΡΡ ΡΠ°ΡΡΠΎ Π·Π°ΡΡΠ°Π³ΠΈΠ²Π°Π΅Ρ Π²Π½ΡΡΡΠ΅Π½Π½ΠΈΠ΅ ΠΏΠΎΠ»ΠΎΠ²ΡΠ΅ ΠΎΡΠ³Π°Π½Ρ.
Π ΠΎΠΆΠΈΡΡΠΎΠ΅ Π²ΠΎΡΠΏΠ°Π»Π΅Π½ΠΈΠ΅ ΡΠ»ΠΈΠ·ΠΈΡΡΡΡ ΠΎΠ±ΠΎΠ»ΠΎΡΠ΅ΠΊ
ΠΡΠΈ ΡΠΎΠΆΠΈΡΡΠΎΠΌ Π²ΠΎΡΠΏΠ°Π»Π΅Π½ΠΈΠΈ ΡΠ»ΠΈΠ·ΠΈΡΡΡΡ ΠΎΠ±ΠΎΠ»ΠΎΡΠ΅ΠΊ ΡΠ°ΡΠ΅ ΠΏΠΎΡΠ°ΠΆΠ°ΡΡΡΡ Π·Π΅Π², Π³ΠΎΡΡΠ°Π½Ρ, ΠΏΠΎΠ»ΠΎΡΡΡ ΡΡΠ° ΠΈ ΡΠ»ΠΈΠ·ΠΈΡΡΠ°Ρ ΠΎΠ±ΠΎΠ»ΠΎΡΠΊΠ° Π½ΠΎΡΠ°. ΠΡΠΈ ΠΏΠΎΡΠ°ΠΆΠ΅Π½ΠΈΠΈ ΡΠ»ΠΈΠ·ΠΈΡΡΡΡ ΠΎΠ±ΠΎΠ»ΠΎΡΠ΅ΠΊ ΡΠ°Π·Π²ΠΈΠ²Π°Π΅ΡΡΡ ΡΡΠΈΡΠ΅ΠΌΠ°ΡΠΎΠ·Π½Π°Ρ ΡΠΎΡΠΌΠ° Π·Π°Π±ΠΎΠ»Π΅Π²Π°Π½ΠΈΡ. Π ΠΎΠ±Π»Π°ΡΡΠΈ Π²ΠΎΡΠΏΠ°Π»Π΅Π½ΠΈΡ ΡΠ°Π·Π²ΠΈΠ²Π°Π΅ΡΡΡ Π³ΠΈΠΏΠ΅ΡΠ΅ΠΌΠΈΡ ΠΈ Π·Π½Π°ΡΠΈΡΠ΅Π»ΡΠ½ΡΠΉ ΠΎΡΠ΅ΠΊ, Π½Π΅ΡΠ΅Π΄ΠΊΠΎ Ρ ΠΎΡΠ°Π³Π°ΠΌΠΈ Π½Π΅ΠΊΡΠΎΠ·Π°.

Π ΠΈΡ. 21. ΠΠ° ΡΠΎΡΠΎ ΡΠΎΠΆΠΈΡΡΠΎΠ΅ Π²ΠΎΡΠΏΠ°Π»Π΅Π½ΠΈΠ΅ ΡΠ»ΠΈΠ·ΠΈΡΡΠΎΠΉ ΠΎΠ±ΠΎΠ»ΠΎΡΠΊΠΈ ΠΏΠΎΠ»ΠΎΡΡΠΈ ΡΡΠ°.
ΠΊ ΡΠΎΠ΄Π΅ΡΠΆΠ°Π½ΠΈΡ βΠ Π΅ΡΠΈΠ΄ΠΈΠ²Ρ Π·Π°Π±ΠΎΠ»Π΅Π²Π°Π½ΠΈΡ
Π ΠΎΠΆΠΈΡΡΠΎΠ΅ Π²ΠΎΡΠΏΠ°Π»Π΅Π½ΠΈΠ΅, Π²ΠΎΠ·Π½ΠΈΠΊΠ°ΡΡΠ΅Π΅ ΠΌΠ½ΠΎΠ³ΠΎΠΊΡΠ°ΡΠ½ΠΎ Π½Π° ΠΎΠ΄Π½ΠΎΠΌ ΠΈ ΡΠΎΠΌ ΠΆΠ΅ ΠΌΠ΅ΡΡΠ΅, Π½ΠΎΡΠΈΡ Ρ Π°ΡΠ°ΠΊΡΠ΅Ρ ΡΠ΅ΡΠΈΠ΄ΠΈΠ²ΠΈΡΡΡΡΠ΅Π³ΠΎ. Π Π΅ΡΠΈΠ΄ΠΈΠ²Ρ ΠΏΠΎΠ΄ΡΠ°Π·Π΄Π΅Π»ΡΡΡΡΡ Π½Π° ΡΠ°Π½Π½ΠΈΠ΅ ΠΈ ΠΏΠΎΠ·Π΄Π½ΠΈΠ΅. Π Π°Π½Π½ΠΈΠΌΠΈ ΡΠ΅ΡΠΈΠ΄ΠΈΠ²Π°ΠΌΠΈ ΡΡΠΈΡΠ°ΡΡΡΡ ΠΏΠΎΠ²ΡΠΎΡΠ½ΡΠ΅ ΡΠΏΠΈΠ·ΠΎΠ΄Ρ Π·Π°Π±ΠΎΠ»Π΅Π²Π°Π½ΠΈΡ, Π²ΠΎΠ·Π½ΠΈΠΊΠ°ΡΡΠΈΠ΅ Π΄ΠΎ 6-ΠΈ ΠΌΠ΅ΡΡΡΠ΅Π², ΠΏΠΎΠ·Π΄Π½ΠΈΠΌΠΈ β Π±ΠΎΠ»Π΅Π΅ 6-ΠΈ ΠΌΠ΅ΡΡΡΠ΅Π².
ΠΡΡΠΎΡΠ½ΠΈΠΊΠΎΠΌ ΠΈΠ½ΡΠ΅ΠΊΡΠΈΠΈ ΡΠ²Π»ΡΡΡΡΡ ΠΎΡΠ°Π³ΠΈ Ρ ΡΠΎΠ½ΠΈΡΠ΅ΡΠΊΠΎΠΉ ΠΈΠ½ΡΠ΅ΠΊΡΠΈΠΈ, ΠΈΠ· ΠΊΠΎΡΠΎΡΡΡ ΡΡΡΠ΅ΠΏΡΠΎΠΊΠΎΠΊΠΊΠΈ Ρ ΠΊΡΠΎΠ²ΡΡ ΡΠ°ΡΠΏΡΠΎΡΡΡΠ°Π½ΡΡΡΡΡ ΠΏΠΎ Π²ΡΠ΅ΠΌΡ ΠΎΡΠ³Π°Π½ΠΈΠ·ΠΌΡ, Π° ΡΠ°ΠΊΠΆΠ΅ Π»Π°ΡΠ΅Π½ΡΠ½ΡΠ΅ (ΡΠΊΡΡΡΡΠ΅) ΠΎΡΠ°Π³ΠΈ ΠΈΠ½ΡΠ΅ΠΊΡΠΈΠΈ Π² Π΄Π΅ΡΠΌΠ΅, Π³Π΄Π΅ ΡΡΡΠ΅ΠΏΡΠΎΠΊΠΎΠΊΠΊΠΈ Π² ΠΏΠ΅ΡΠΈΠΎΠ΄ Π·Π°ΡΠΈΡΡΡ ΠΏΡΠ΅Π²ΡΠ°ΡΠ°ΡΡΡΡ Π² ΠΏΠ°ΡΠ°Π·ΠΈΡΠΈΡΠ΅ΡΠΊΡΡ L-ΡΠΎΡΠΌΡ.
Π‘ΠΏΠΎΡΠΎΠ±ΡΡΠ²ΡΡΡ ΡΠ΅ΡΠΈΠ΄ΠΈΠ²ΠΈΡΠΎΠ²Π°Π½ΠΈΡ Ρ ΡΠΎΠ½ΠΈΡΠ΅ΡΠΊΠ°Ρ Π²Π΅Π½ΠΎΠ·Π½Π°Ρ Π½Π΅Π΄ΠΎΡΡΠ°ΡΠΎΡΠ½ΠΎΡΡΡ, Π»ΠΈΠΌΡΠΎΡΡΠ°Π·, ΡΠ°Ρ Π°ΡΠ½ΡΠΉ Π΄ΠΈΠ°Π±Π΅Ρ ΠΈ Π½Π΅ΠΏΡΠ°Π²ΠΈΠ»ΡΠ½ΠΎΠ΅ Π»Π΅ΡΠ΅Π½ΠΈΠ΅ Π·Π°Π±ΠΎΠ»Π΅Π²Π°Π½ΠΈΡ. Π Π΅ΡΠΈΠ΄ΠΈΠ²Ρ ΡΠ°ΡΡΠΎ ΠΎΡΠΌΠ΅ΡΠ°ΡΡΡΡ Ρ Π±ΠΎΠ»ΡΠ½ΡΡ , ΡΠ°Π±ΠΎΡΠ°ΡΡΠΈΡ Π² Π½Π΅Π±Π»Π°Π³ΠΎΠΏΡΠΈΡΡΠ½ΡΡ ΡΡΠ»ΠΎΠ²ΠΈΡΡ ΠΈ Ρ ΠΏΠΎΠΆΠΈΠ»ΡΡ Π»ΡΠ΄Π΅ΠΉ.
ΠΡΠΈ ΡΠ°Π·ΠΌΠ½ΠΎΠΆΠ΅Π½ΠΈΠΈ Π² Π»ΠΈΠΌΡΠ°ΡΠΈΡΠ΅ΡΠΊΠΈΡ ΠΊΠ°ΠΏΠΈΠ»Π»ΡΡΠ°Ρ ΠΊΠΎΠΆΠΈ, ΡΡΡΠ΅ΠΏΡΠΎΠΊΠΎΠΊΠΊΠΈ ΠΎΠ±ΡΠ°Π·ΡΡΡ Π²ΠΎΡΠΏΠ°Π»ΠΈΡΠ΅Π»ΡΠ½ΡΠΉ ΠΎΡΠ°Π³ Π² Π΄Π΅ΡΠΌΠ΅. Π§Π°ΡΡΡΠ΅ ΡΠ΅ΡΠΈΠ΄ΠΈΠ²Ρ ΠΏΡΠΎΡΠ΅ΠΊΠ°ΡΡ Ρ Π½Π΅Π±ΠΎΠ»ΡΡΠΎΠΉ ΡΠ΅ΠΌΠΏΠ΅ΡΠ°ΡΡΡΠΎΠΉ ΡΠ΅Π»Π° ΠΈ ΡΠΌΠ΅ΡΠ΅Π½Π½ΠΎ Π²ΡΡΠ°ΠΆΠ΅Π½Π½ΡΠΌΠΈ ΡΠΈΠΌΠΏΡΠΎΠΌΠ°ΠΌΠΈ ΠΈΠ½ΡΠΎΠΊΡΠΈΠΊΠ°ΡΠΈΠΈ. ΠΠ° ΠΊΠΎΠΆΠ½ΡΡ ΠΏΠΎΠΊΡΠΎΠ²Π°Ρ ΠΏΠΎΡΠ²Π»ΡΠ΅ΡΡΡ ΠΆΠΈΡΠ½Π°Ρ ΡΡΠΈΡΠ΅ΠΌΠ° ΠΈ ΠΎΡΠ΅ΠΊ. ΠΡΠ³ΡΠ°Π½ΠΈΡΠ΅Π½ΠΈΠ΅ ΠΎΡ Π·Π΄ΠΎΡΠΎΠ²ΡΡ ΡΡΠ°ΡΡΠΊΠΎΠ² ΡΠ»Π°Π±ΠΎ Π²ΡΡΠ°ΠΆΠ΅Π½ΠΎ.
Π§Π°ΡΡΡΠ΅ ΡΠ΅ΡΠΈΠ΄ΠΈΠ²Ρ ΠΏΡΠΈΠ²ΠΎΠ΄ΡΡ ΠΊ ΡΠ°Π·Π²ΠΈΡΠΈΡ ΡΠΈΠ±ΡΠΎΠ·Π½ΡΡ ΠΈΠ·ΠΌΠ΅Π½Π΅Π½ΠΈΠΉ Π² Π΄Π΅ΡΠΌΠ΅ ΠΈ ΠΏΠΎΠ΄ΠΊΠΎΠΆΠ½ΠΎΠΉ ΠΊΠ»Π΅ΡΡΠ°ΡΠΊΠ΅ Ρ ΠΏΠΎΡΠ»Π΅Π΄ΡΡΡΠΈΠΌ ΡΠ°Π·Π²ΠΈΡΠΈΠ΅ΠΌ ΡΠ»ΠΎΠ½ΠΎΠ²ΠΎΡΡΠΈ.
Π ΠΈΡ. 22. ΠΠ° ΡΠΎΡΠΎ erysipelas (ΡΠΎΠΆΠ°) ΡΠ΅Π΄ΠΊΠΎΠΉ Π»ΠΎΠΊΠ°Π»ΠΈΠ·Π°ΡΠΈΠΈ.
ΠΊ ΡΠΎΠ΄Π΅ΡΠΆΠ°Π½ΠΈΡ βΠ ΠΎΠΆΠ° Ρ ΠΏΠΎΠΆΠΈΠ»ΡΡ Π»ΡΠ΄Π΅ΠΉ
Π ΠΎΠΆΠ° Ρ ΠΏΠΎΠΆΠΈΠ»ΡΡ Π»ΡΠ΄Π΅ΠΉ ΡΠ°ΡΠ΅ Π²ΠΎΠ·Π½ΠΈΠΊΠ°Π΅Ρ Π½Π° Π»ΠΈΡΠ΅. ΠΠ°Π±ΠΎΠ»Π΅Π²Π°Π½ΠΈΠ΅ ΡΠΎΠΏΡΠΎΠ²ΠΎΠΆΠ΄Π°Π΅ΡΡΡ ΡΠΈΠ»ΡΠ½ΡΠΌΠΈ Π±ΠΎΠ»ΡΠΌΠΈ. ΠΠ½ΠΎΠ³Π΄Π° ΡΠ°Π·Π²ΠΈΠ²Π°Π΅ΡΡΡ Π³Π°Π½Π³ΡΠ΅Π½Π°. Π ΠΎΠΆΠΈΡΡΠΎΠ΅ Π²ΠΎΡΠΏΠ°Π»Π΅Π½ΠΈΠ΅ ΠΈΠΌΠ΅Π΅Ρ Π·Π°ΡΡΠΆΠ½ΠΎΠ΅ ΡΠ΅ΡΠ΅Π½ΠΈΠ΅ ΠΈ ΠΌΠ΅Π΄Π»Π΅Π½Π½ΠΎ ΡΠ΅Π³ΡΠ΅ΡΡΠΈΡΡΠ΅Ρ.

Π ΠΈΡ. 23. Π ΠΎΠΆΠΈΡΡΠΎΠ΅ Π²ΠΎΡΠΏΠ°Π»Π΅Π½ΠΈΠ΅ Π½Π° Π»ΠΈΡΠ΅ Ρ ΠΏΠΎΠΆΠΈΠ»ΡΡ Π»ΡΠ΄Π΅ΠΉ.
ΠΊ ΡΠΎΠ΄Π΅ΡΠΆΠ°Π½ΠΈΡ βΠ ΠΎΠΆΠ° Ρ Π΄Π΅ΡΠ΅ΠΉ
Π ΠΎΠΆΠ° Ρ Π΄Π΅ΡΠ΅ΠΉ Π²ΡΡΡΠ΅ΡΠ°Π΅ΡΡΡ ΡΠ΅Π΄ΠΊΠΎ. Π£ Π΄Π΅ΡΠ΅ΠΉ ΡΡΠ°ΡΡΠ΅Π³ΠΎ Π²ΠΎΠ·ΡΠ°ΡΡΠ° Π·Π°Π±ΠΎΠ»Π΅Π²Π°Π½ΠΈΠ΅ ΠΏΡΠΎΡΠ΅ΠΊΠ°Π΅Ρ Π² Π»Π΅Π³ΠΊΠΎΠΉ ΡΠΎΡΠΌΠ΅. ΠΡΠ°Π³ ΡΠΎΠΆΠΈΡΡΠΎΠ³ΠΎ Π²ΠΎΡΠΏΠ°Π»Π΅Π½ΠΈΡ ΠΌΠΎΠΆΠ΅Ρ Π²ΠΎΠ·Π½ΠΈΠΊΠ½ΡΡΡ Π² ΡΠ°Π·Π½ΡΡ ΠΌΠ΅ΡΡΠ°Ρ . Π§Π°ΡΠ΅ ΡΠ°Π·Π²ΠΈΠ²Π°Π΅ΡΡΡ ΡΡΠΈΡΠ΅ΠΌΠ°ΡΠΎΠ·Π½Π°Ρ ΡΠΎΡΠΌΠ°. ΠΡΠΎΠ³Π½ΠΎΠ· Π±Π»Π°Π³ΠΎΠΏΡΠΈΡΡΠ½ΡΠΉ.
Π£ Π΄Π΅ΡΠ΅ΠΉ Π΄ΠΎ ΠΎΠ΄Π½ΠΎΠ³ΠΎ Π³ΠΎΠ΄Π° ΡΠΎΠΆΠ° ΠΏΡΠΎΡΠ΅ΠΊΠ°Π΅Ρ ΡΡΠΆΠ΅Π»Π΅Π΅. ΠΡΠ°Π³ΠΈ Π²ΠΎΡΠΏΠ°Π»Π΅Π½ΠΈΡ ΡΠ°ΡΠ΅ ΠΏΠΎΡΠ²Π»ΡΡΡΡΡ Π² ΠΌΠ΅ΡΡΠ°Ρ ΠΎΠΏΡΠ΅Π»ΠΎΡΡΠ΅ΠΉ ΠΈ Π½Π° Π»ΠΈΡΠ΅, ΠΈΠ½ΠΎΠ³Π΄Π° ΡΠ°ΡΠΏΡΠΎΡΡΡΠ°Π½ΡΡΡΡΡ Π½Π° Π΄ΡΡΠ³ΠΈΠ΅ ΡΡΠ°ΡΡΠΊΠΈ ΡΠ΅Π»Π°. ΠΡΠΈ ΡΠ»Π΅Π³ΠΌΠΎΠ½ΠΎΠ·Π½ΠΎΠΉ ΡΠΎΡΠΌΠ΅ Π·Π°Π±ΠΎΠ»Π΅Π²Π°Π½ΠΈΡ ΠΌΠΎΠΆΠ΅Ρ ΡΠ°Π·Π²ΠΈΡΡΡΡ ΡΠ΅ΠΏΡΠΈΡ, ΠΏΡΠΈ ΡΠΎΠΆΠΈΡΡΠΎΠΌ Π²ΠΎΡΠΏΠ°Π»Π΅Π½ΠΈΠΈ Π»ΠΈΡΠ° β ΠΌΠ΅Π½ΠΈΠ½Π³ΠΈΡ.
Π’ΡΠΆΠ΅Π»ΠΎ ΠΏΡΠΎΡΠ΅ΠΊΠ°Π΅Ρ ΡΠΎΠΆΠ° ΠΏΡΠΈ ΠΏΡΠΎΠ½ΠΈΠΊΠ½ΠΎΠ²Π΅Π½ΠΈΠΈ ΡΡΡΠ΅ΠΏΡΠΎΠΊΠΎΠΊΠΊΠΎΠ² Π² ΠΏΡΠΏΠΎΡΠ½ΡΡ ΡΠ°Π½ΠΊΡ Ρ Π½ΠΎΠ²ΠΎΡΠΎΠΆΠ΄Π΅Π½Π½ΡΡ . ΠΡΠΎΡΠ΅ΡΡ Π±ΡΡΡΡΠΎ ΡΠ°ΡΠΏΡΠΎΡΡΡΠ°Π½ΡΠ΅ΡΡΡ Π½Π° ΡΠΏΠΈΠ½Ρ, ΡΠ³ΠΎΠ΄ΠΈΡΡ ΠΈ ΠΊΠΎΠ½Π΅ΡΠ½ΠΎΡΡΠΈ ΡΠ΅Π±Π΅Π½ΠΊΠ°. ΠΠ°ΡΠ°ΡΡΠ°Π΅Ρ ΠΈΠ½ΡΠΎΠΊΡΠΈΠΊΠ°ΡΠΈΡ, Π·Π½Π°ΡΠΈΡΠ΅Π»ΡΠ½ΠΎ ΠΏΠΎΠ²ΡΡΠ°Π΅ΡΡΡ ΡΠ΅ΠΌΠΏΠ΅ΡΠ°ΡΡΡΠ° ΡΠ΅Π»Π°, ΠΏΠΎΡΠ²Π»ΡΡΡΡΡ ΡΡΠ΄ΠΎΡΠΎΠ³ΠΈ. Π£ ΡΠ°ΡΡΠΈ Π±ΠΎΠ»ΡΠ½ΡΡ ΡΠ°Π·Π²ΠΈΠ²Π°Π΅ΡΡΡ ΡΠ΅ΠΏΡΠΈΡ. ΠΠ΅ΡΠ°Π»ΡΠ½ΠΎΡΡΡ ΠΏΡΠΈ ΡΠΎΠΆΠ΅ Ρ Π½ΠΎΠ²ΠΎΡΠΎΠΆΠ΄Π΅Π½Π½ΡΡ ΠΊΡΠ°ΠΉΠ½Π΅ Π²Π΅Π»ΠΈΠΊΠ°.
Π ΠΈΡ. 24. ΠΠ° ΡΠΎΡΠΎ ΡΠΎΠΆΠ° Ρ Π΄Π΅ΡΠ΅ΠΉ.
ΠΊ ΡΠΎΠ΄Π΅ΡΠΆΠ°Π½ΠΈΡ βΠΡΠ»ΠΎΠΆΠ½Π΅Π½ΠΈΡ ΡΠΎΠΆΠΈ
ΠΡΠ»ΠΎΠΆΠ½Π΅Π½ΠΈΡ ΡΠΎΠΆΠΈ Π²ΡΡΡΠ΅ΡΠ°ΡΡΡΡ Π² 4 β 8% ΡΠ»ΡΡΠ°Π΅Π². Π‘Π½ΠΈΠΆΠ΅Π½ΠΈΠ΅ Π°ΠΊΡΠΈΠ²Π½ΠΎΡΡΠΈ Π·Π°ΡΠΈΡΠ½ΡΡ ΡΠ΅Π°ΠΊΡΠΈΠΉ ΠΎΡΠ³Π°Π½ΠΈΠ·ΠΌΠ° ΠΈ Π½Π΅Π°Π΄Π΅ΠΊΠ²Π°ΡΠ½ΠΎΠ΅ Π»Π΅ΡΠ΅Π½ΠΈΠ΅ ΠΏΡΠΈΠ²ΠΎΠ΄ΡΡ ΠΊ ΡΠ°Π·Π²ΠΈΡΠΈΡ:
- Π»ΠΈΠΌΡΠΎΡΠ΅ΠΈ β ΠΈΡΡΠ΅ΡΠ΅Π½ΠΈΡ Π»ΠΈΠΌΡΡ ΠΈΠ· ΠΏΠΎΠ²ΡΠ΅ΠΆΠ΄Π΅Π½Π½ΡΡ Π»ΠΈΠΌΡΠ°ΡΠΈΡΠ΅ΡΠΊΠΈΡ ΡΠΎΡΡΠ΄ΠΎΠ²,
- ΡΠ·Π² β Π³Π»ΡΠ±ΠΎΠΊΠΈΡ Π΄Π΅ΡΠ΅ΠΊΡΠΎΠ² ΠΊΠΎΠΆΠΈ,
- Π°Π±ΡΡΠ΅ΡΡΠ° β Π³Π½ΠΎΠΉΠ½ΠΈΠΊΠ°, ΠΎΠΊΡΡΠΆΠ΅Π½Π½ΠΎΠ³ΠΎ ΠΏΠ»ΠΎΡΠ½ΠΎΠΉ ΠΊΠ°ΠΏΡΡΠ»ΠΎΠΉ,
- ΡΠ»Π΅Π³ΠΌΠΎΠ½Ρ, ΠΊΠΎΠ³Π΄Π° Π²ΠΎΡΠΏΠ°Π»Π΅Π½ΠΈΠ΅ ΡΠ°ΡΠΏΡΠΎΡΡΡΠ°Π½ΡΠ΅ΡΡΡ Π½Π° ΠΏΠΎΠ΄ΠΊΠΎΠΆΠ½ΡΡ ΠΆΠΈΡΠΎΠ²ΡΡ ΠΊΠ»Π΅ΡΡΠ°ΡΠΊΡ ΠΈ ΡΠΎΠ΅Π΄ΠΈΠ½ΠΈΡΠ΅Π»ΡΠ½ΡΡ ΡΠΊΠ°Π½Ρ,
- Π³Π°Π½Π³ΡΠ΅Π½Ρ β ΠΏΠΎΠ»Π½ΠΎΠ³ΠΎ ΡΠ°Π·ΡΡΡΠ΅Π½ΠΈΡ ΡΠΊΠ°Π½Π΅ΠΉ, Π·Π°ΡΡΠΎΠ½ΡΡΡΡ Π²ΠΎΡΠΏΠ°Π»Π΅Π½ΠΈΠ΅ΠΌ,
- ΡΡΠΎΠΌΠ±ΠΎΡΠ»Π΅Π±ΠΈΡΠ° β Π²ΠΎΡΠΏΠ°Π»Π΅Π½ΠΈΡ Π²Π΅Π½ΠΎΠ·Π½ΡΡ ΡΡΠ΅Π½ΠΎΠΊ Ρ ΠΎΠ±ΡΠ°Π·ΠΎΠ²Π°Π½ΠΈΠ΅ΠΌ ΡΡΠΎΠΌΠ±ΠΎΠ²,
- ΠΏΠ½Π΅Π²ΠΌΠΎΠ½ΠΈΠΈ Ρ Π»ΡΠ΄Π΅ΠΉ ΡΡΠ°ΡΡΠ΅ΡΠΊΠΎΠ³ΠΎ Π²ΠΎΠ·ΡΠ°ΡΡΠ°,
- Π»ΠΈΠΌΡΠΎΡΡΠ°Π·Π° (Π»ΠΈΠΌΡΠ΅Π΄Π΅ΠΌΡ), ΡΠ°Π·Π²ΠΈΠ²ΡΠ΅Π³ΠΎΡΡ Π² ΡΠ΅Π·ΡΠ»ΡΡΠ°ΡΠ΅ Π½Π°ΡΡΡΠ΅Π½ΠΈΡ ΠΎΡΡΠΎΠΊΠ° Π»ΠΈΠΌΡΡ ΠΈ ΡΠ»ΠΎΠ½ΠΎΠ²ΠΎΡΡΠΈ (ΡΠΈΠ±ΡΠ΅Π΄Π΅ΠΌΡ),
- ΠΈΠ½ΡΠ΅ΠΊΡΠΈΠΎΠ½Π½ΠΎΠ³ΠΎ ΠΏΡΠΈΡ ΠΎΠ·Π°,
- Π½Π° ΠΌΠ΅ΡΡΠ΅ Π²ΠΎΡΠΏΠ°Π»Π΅Π½ΠΈΡ ΡΠ°ΡΡΠΎ ΠΏΡΠΈ Π΄Π»ΠΈΡΠ΅Π»ΡΠ½ΠΎΠΌ ΠΈΠ»ΠΈ ΡΠ΅ΡΠΈΠ΄ΠΈΠ²ΠΈΡΡΡΡΠ΅ΠΌ ΡΠ΅ΡΠ΅Π½ΠΈΠΈ ΡΠ°Π·Π²ΠΈΠ²Π°Π΅ΡΡΡ Π³ΠΈΠΏΠ΅ΡΠΊΠ΅ΡΠ°ΡΠΎΠ·, ΡΠΊΠ·Π΅ΠΌΠ°, ΠΏΠΎΡΠ²Π»ΡΠ΅ΡΡΡ ΠΏΠΈΠ³ΠΌΠ΅Π½ΡΠ°ΡΠΈΡ.
ΠΠΌΠΌΡΠ½ΠΈΡΠ΅Ρ ΠΏΠΎΡΠ»Π΅ ΠΏΠ΅ΡΠ΅Π½Π΅ΡΠ΅Π½Π½ΠΎΠ³ΠΎ ΡΠΎΠΆΠΈΡΡΠΎΠ³ΠΎ Π²ΠΎΡΠΏΠ°Π»Π΅Π½ΠΈΡ Π½Π΅ ΡΠ°Π·Π²ΠΈΠ²Π°Π΅ΡΡΡ.

Π ΠΈΡ. 25. ΠΠΈΠΌΡΠΎΡΡΠ°Π· ΠΈ ΡΠ»ΠΎΠ½ΠΎΠ²ΠΎΡΡΡ ΠΏΡΠΈ ΡΠΎΠΆΠ΅ ΡΠ°ΡΡΠΎ ΠΏΡΠΈΠ²ΠΎΠ΄ΡΡ Π±ΠΎΠ»ΡΠ½ΠΎΠ³ΠΎ ΠΊ ΠΈΠ½Π²Π°Π»ΠΈΠ΄Π½ΠΎΡΡΠΈ.
Π ΠΈΡ. 26. ΠΡΠΎΠ·Π½ΠΎΠ΅ ΠΎΡΠ»ΠΎΠΆΠ½Π΅Π½ΠΈΠ΅ ΡΠΎΠΆΠΈ β ΡΠ»Π΅Π³ΠΌΠΎΠ½Π°.

Π ΠΈΡ. 27. ΠΠ° ΡΠΎΡΠΎ Π³Π°Π½Π³ΡΠ΅Π½Π° Π½ΠΈΠΆΠ½Π΅ΠΉ ΠΊΠΎΠ½Π΅ΡΠ½ΠΎΡΡΠΈ β ΠΎΡΠ»ΠΎΠΆΠ½Π΅Π½ΠΈΠ΅ Π±ΡΠ»Π»Π΅Π·Π½ΠΎ-Π³Π΅ΠΌΠΎΡΡΠ°Π³ΠΈΡΠ΅ΡΠΊΠΎΠΉ ΡΠΎΡΠΌΡ ΡΠΎΠΆΠΈΡΡΠΎΠ³ΠΎ Π²ΠΎΡΠΏΠ°Π»Π΅Π½ΠΈΡ.
ΠΊ ΡΠΎΠ΄Π΅ΡΠΆΠ°Π½ΠΈΡ βΠΡΠΎΠ³Π½ΠΎΠ·
- ΠΠΎΠ»ΡΡΠΈΠ½ΡΡΠ²ΠΎ ΡΠ»ΡΡΠ°Π΅Π² ΡΠΎΠΆΠΈΡΡΠΎΠ³ΠΎ Π²ΠΎΡΠΏΠ°Π»Π΅Π½ΠΈΡ Π·Π°ΠΊΠ°Π½ΡΠΈΠ²Π°Π΅ΡΡΡ ΠΏΠΎΠ»Π½ΡΠΌ ΠΈΠ·Π»Π΅ΡΠ΅Π½ΠΈΠ΅ΠΌ.
- Π£ ΡΡΠ΅ΡΠ΅ΠΉ ΡΠ°ΡΡΠΈ Π±ΠΎΠ»ΡΠ½ΡΡ Π·Π°Π±ΠΎΠ»Π΅Π²Π°Π½ΠΈΠ΅ ΠΏΡΠΈΠΎΠ±ΡΠ΅ΡΠ°Π΅Ρ ΡΠ΅ΡΠΈΠ΄ΠΈΠ²ΠΈΡΡΡΡΠ΅Π΅ ΡΠ΅ΡΠ΅Π½ΠΈΠ΅.
- Π ΡΡΠ΄Π΅ ΡΠ»ΡΡΠ°Π΅Π² Ρ ΡΠ°ΡΡΠΈ Π±ΠΎΠ»ΡΠ½ΡΡ Π»ΠΈΠΌΡΠΎΡΡΠ°Π· ΠΈ ΡΠ»ΠΎΠ½ΠΎΠ²ΠΎΡΡΡ ΡΡΠ°Π½ΠΎΠ²ΡΡΡΡ ΠΏΡΠΈΡΠΈΠ½ΠΎΠΉ ΠΈΠ½Π²Π°Π»ΠΈΠ΄Π½ΠΎΡΡΠΈ.
- ΠΠ΅ΡΠ°Π»ΡΠ½ΠΎΡΡΡ Π½Π΅Π±ΠΎΠ»ΡΡΠ°Ρ β 0,2 β 0,5%. ΠΠ°ΠΊ ΠΏΡΠ°Π²ΠΈΠ»ΠΎ, Π³ΠΈΠ±Π΅Π»Ρ Π±ΠΎΠ»ΡΠ½ΠΎΠ³ΠΎ ΡΠ²ΡΠ·Π°Π½Π° Ρ ΡΠ°Π·Π²ΠΈΡΠΈΠ΅ΠΌ ΡΡΠΆΠ΅Π»ΡΡ ΠΎΡΠ»ΠΎΠΆΠ½Π΅Π½ΠΈΠΉ β ΡΠ»Π΅Π³ΠΌΠΎΠ½Ρ ΠΈ Π³Π°Π½Π³ΡΠ΅Π½Ρ.
microbak.ru
ΠΏΡΠΈΡΠΈΠ½Ρ, ΡΠΎΡΠΌΡ, ΡΠΈΠΌΠΏΡΠΎΠΌΡ ΠΈ Π»Π΅ΡΠ΅Π½ΠΈΠ΅
Π§ΡΠΎ ΡΠ°ΠΊΠΎΠ΅ Π±ΠΎΠ»Π΅Π·Π½Ρ ΡΠΎΠΆΠ°
Π ΠΎΠΆΠ° β ΡΡΠΎ ΠΈΠ½ΡΠ΅ΠΊΡΠΈΠΎΠ½Π½ΠΎΠ΅ ΠΏΠΎΡΠ°ΠΆΠ΅Π½ΠΈΠ΅ ΠΊΠΎΠΆΠ½ΡΡ ΠΏΠΎΠΊΡΠΎΠ²ΠΎΠ², ΠΊΠΎΡΠΎΡΠΎΠ΅ ΠΏΡΠΎΠΈΡΡ ΠΎΠ΄ΠΈΡ Π² ΡΠ΅Π·ΡΠ»ΡΡΠ°ΡΠ΅ ΡΡΠ°Π²ΠΌΠΈΡΠΎΠ²Π°Π½ΠΈΡ ΠΈΠ»ΠΈ ΠΌΠ΅Ρ Π°Π½ΠΈΡΠ΅ΡΠΊΠΎΠ³ΠΎ ΠΏΠΎΠ²ΡΠ΅ΠΆΠ΄Π΅Π½ΠΈΡ ΠΊΠΎΠΆΠΈ ΠΈ Π·Π°ΡΠ΅Π»Π΅Π½ΠΈΡ Π² ΡΠ°Π½Π΅ Π±Π°ΠΊΡΠ΅ΡΠΈΠΈ ΡΡΡΠ΅ΠΏΡΠΎΠΊΠΎΠΊΠΊΠ°. ΠΠ΅ΡΠΌΠΎΡΡΡ Π½Π° ΠΈΠ½ΡΠ΅ΠΊΡΠΈΠΎΠ½Π½ΡΡ ΠΏΡΠΈΡΠΎΠ΄Ρ, Π±ΠΎΠ»ΡΠ½ΡΠ΅ Ρ ΡΠ°ΠΊΠΈΠΌ Π½Π΅Π΄ΡΠ³ΠΎΠΌ ΠΏΡΠ°ΠΊΡΠΈΡΠ΅ΡΠΊΠΈ Π½Π΅ Π·Π°ΡΠ°Π·Π½Ρ ΠΈ Π½Π΅ ΠΏΡΠ΅Π΄ΡΡΠ°Π²Π»ΡΡΡ ΠΎΡΠΎΠ±ΠΎΠΉ ΠΎΠΏΠ°ΡΠ½ΠΎΡΡΠΈ Π΄Π»Ρ ΠΎΠΊΡΡΠΆΠ°ΡΡΠΈΡ . Π‘ΡΡΠ°Π΄Π°ΡΡ ΠΎΡ Π½Π΅Π΄ΡΠ³Π° ΡΠ°ΡΠ΅ ΠΆΠ΅Π½ΡΠΈΠ½Ρ. ΠΡΡΠ²Π»ΡΠ΅ΡΡΡ ΡΠΎΠΆΠ°, ΠΊΠ°ΠΊ ΠΏΡΠ°Π²ΠΈΠ»ΠΎ, Ρ Π»ΡΠ΄Π΅ΠΉ ΡΡΠ°ΡΡΠ΅ 40 Π»Π΅Ρ. ΠΡΠΎΠ±Π΅Π½Π½ΠΎ ΡΠ°ΡΡΠΎ Π½Π΅Π΄ΡΠ³ Π²ΡΡΡΠ΅ΡΠ°Π΅ΡΡΡ Π² ΠΎΡΠ΅Π½Π½Π΅-Π»Π΅ΡΠ½ΠΈΠΉ ΠΏΠ΅ΡΠΈΠΎΠ΄.
ΠΡΠΈΡΠΈΠ½Ρ Π±ΠΎΠ»Π΅Π·Π½ΠΈ ΡΠΎΠΆΠΈ
ΠΡΠ½ΠΎΠ²Π½ΠΎΠΉ ΠΏΡΠΈΡΠΈΠ½ΠΎΠΉ ΡΠ°Π·Π²ΠΈΡΠΈΡ Π·Π°Π±ΠΎΠ»Π΅Π²Π°Π½ΠΈΡ ΡΠ²Π»ΡΠ΅ΡΡΡ ΠΏΠΎΠΏΠ°Π΄Π°Π½ΠΈΠ΅ Π±Π°ΠΊΡΠ΅ΡΠΈΠΈ ΡΡΡΠ΅ΠΏΡΠΎΠΊΠΎΠΊΠΊΠ° Π² ΡΠ°Π½Ρ β ΡΠ°ΡΠ°ΠΏΠΈΠ½Ρ, ΠΏΡΠΎΠΊΠΎΠ», ΡΡΠ°Π΄ΠΈΠ½Ρ, ΡΠ°ΡΡΠ΅Ρ ΠΈΠ»ΠΈ ΠΎΠΆΠΎΠ³. ΠΠ½Π° ΠΌΠΎΠΆΠ΅Ρ Π΄Π»ΠΈΡΠ΅Π»ΡΠ½ΠΎΠ΅ Π²ΡΠ΅ΠΌΡ Π½Π°Ρ
ΠΎΠ΄ΠΈΡΡΡ Π² ΠΎΡΠ³Π°Π½ΠΈΠ·ΠΌΠ΅ Π½ΠΈΠΊΠ°ΠΊ ΡΠ΅Π±Ρ Π½Π΅ ΠΏΡΠΎΡΠ²Π»ΡΡ, ΠΏΠΎΡΡΠΎΠΌΡ ΠΌΠ½ΠΎΠ³ΠΈΠ΅ Π»ΡΠ΄ΠΈ Π½Π΅ ΠΏΠΎΠ΄ΠΎΠ·ΡΠ΅Π²Π°ΡΡ, ΡΡΠΎ ΠΏΠΎΠ΄Π²Π΅ΡΠΆΠ΅Π½Ρ ΡΠΈΡΠΊΡ ΡΠ°Π·Π²ΠΈΡΠΈΡ ΡΠΎΠΆΠΈ. ΠΠΊΡΠΈΠ²ΠΈΠ·ΠΈΡΡΠ΅ΡΡΡ ΡΡΡΠ΅ΠΏΡΠΎΠΊΠΎΠΊΠΊ ΠΏΠΎΠ΄ Π²ΠΎΠ·Π΄Π΅ΠΉΡΡΠ²ΠΈΠ΅ΠΌ Π±Π»Π°Π³ΠΎΠΏΡΠΈΡΡΠ½ΡΡ
ΡΠ°ΠΊΡΠΎΡΠΎΠ²:
- ΠΠ΅ΡΠ΅ΠΎΡ Π»Π°ΠΆΠ΄Π΅Π½ΠΈΠ΅ ΠΈΠ»ΠΈ ΠΏΠ΅ΡΠ΅Π³ΡΠ΅Π².
- Π‘ΡΡΠ΅ΡΡ, ΡΠΌΠΎΡΠΈΠΎΠ½Π°Π»ΡΠ½ΡΠ΅ ΠΏΠ΅ΡΠ΅ΠΆΠΈΠ²Π°Π½ΠΈΡ.
- Π£ΡΠΈΠ±Ρ ΠΈΠ»ΠΈ ΡΡΠ°Π²ΠΌΡ.
- ΠΠΎΠ·Π΄Π΅ΠΉΡΡΠ²ΠΈΠ΅ ΡΠ»ΡΡΡΠ°ΡΠΈΠΎΠ»Π΅ΡΠΎΠ²ΡΡ Π»ΡΡΠ΅ΠΉ, Π·Π°Π³Π°Ρ.
Π ΠΎΡΠΎΠ±ΡΡ Π³ΡΡΠΏΠΏΡ ΡΠΈΡΠΊΠ° ΠΏΠΎΠΏΠ°Π΄Π°ΡΡ Π»ΡΠ΄ΠΈ, ΡΡΡΠ°Π΄Π°ΡΡΠΈΠ΅ ΠΎΠΆΠΈΡΠ΅Π½ΠΈΠ΅ΠΌ, ΡΠ°Ρ Π°ΡΠ½ΡΠΌ Π΄ΠΈΠ°Π±Π΅ΡΠΎΠΌ, Π°Π»ΠΊΠΎΠ³ΠΎΠ»ΠΈΠ·ΠΌΠΎΠΌ, Π³ΡΠΈΠ±ΠΊΠΎΠ²ΡΠΌΠΈ Π±ΠΎΠ»Π΅Π·Π½ΡΠΌΠΈ, Π²Π°ΡΠΈΠΊΠΎΠ·Π½ΡΠΌ ΡΠ°ΡΡΠΈΡΠ΅Π½ΠΈΠ΅ΠΌ Π²Π΅Π½ ΠΈ ΠΎΡΠ»Π°Π±Π»Π΅Π½Π½ΡΠΌ ΠΈΠΌΠΌΡΠ½ΠΈΡΠ΅ΡΠΎΠΌ. Π§Π°ΡΠ΅ Π²ΡΠ΅Π³ΠΎ ΡΡΠΎ Π»ΡΠ΄ΠΈ ΠΏΠΎΠΆΠΈΠ»ΠΎΠ³ΠΎ Π²ΠΎΠ·ΡΠ°ΡΡΠ°.
Π‘ΠΈΠΌΠΏΡΠΎΠΌΡ Π±ΠΎΠ»Π΅Π·Π½ΠΈ ΡΠΎΠΆΠΈ
ΠΠ°Π±ΠΎΠ»Π΅Π²Π°Π½ΠΈΠ΅ ΠΈΠΌΠ΅Π΅Ρ ΠΈΠ½ΠΊΡΠ±Π°ΡΠΈΠΎΠ½Π½ΡΠΉ ΠΏΠ΅ΡΠΈΠΎΠ΄, ΠΊΠΎΡΠΎΡΡΠΉ ΠΎΡ ΠΌΠΎΠΌΠ΅Π½ΡΠ° ΠΏΠΎΡΠ°ΠΆΠ΅Π½ΠΈΡ Π΄ΠΎ ΠΏΠΎΡΠ²Π»Π΅Π½ΠΈΡ ΠΏΠ΅ΡΠ²ΡΡ ΡΠΈΠΌΠΏΡΠΎΠΌΠΎΠ² ΠΌΠΎΠΆΠ΅Ρ Π΄Π»ΠΈΡΡΡΡ ΠΎΡ Π½Π΅ΡΠΊΠΎΠ»ΡΠΊΠΈΡ ΡΠ°ΡΠΎΠ² ΠΈΠ»ΠΈ Π΄ΠΎ 5 Π΄Π½Π΅ΠΉ. ΠΡΠ»ΠΈ ΡΡΠΎ ΡΠ΅ΡΠΈΠ΄ΠΈΠ² Π·Π°Π±ΠΎΠ»Π΅Π²Π°Π½ΠΈΡ, ΡΠΎ ΠΏΡΠΎΡΠ²Π»ΡΠ΅ΡΡΡ ΠΎΠ½ΠΎ ΡΠ°Π½ΡΡΠ΅, Π° ΠΏΡΠΎΠ²ΠΎΡΠΈΡΡΡΡ Π΅Π³ΠΎ, ΠΊΠ°ΠΊ ΠΏΡΠ°Π²ΠΈΠ»ΠΎ, ΡΠΈΠ»ΡΠ½ΡΠΉ ΡΡΡΠ΅ΡΡ ΠΈΠ»ΠΈ ΠΏΠ΅ΡΠ΅ΠΎΡ Π»Π°ΠΆΠ΄Π΅Π½ΠΈΠ΅.
Π ΠΎΠΆΠ° Π²ΡΠ΅Π³Π΄Π° Π½Π°ΡΠΈΠ½Π°Π΅ΡΡΡ ΠΎΡΡΡΠΎ Ρ ΠΏΡΠΎΡΠ²Π»Π΅Π½ΠΈΡ ΠΈΠ½ΡΠΎΠΊΡΠΈΠΊΠ°ΡΠΈΠΈ ΠΎΡΠ³Π°Π½ΠΈΠ·ΠΌΠ° ΠΈ ΠΏΠΎΡΠ²Π»Π΅Π½ΠΈΡ ΡΠ»Π΅Π΄ΡΡΡΠΈΡ ΡΠΈΠΌΠΏΡΠΎΠΌΠΎΠ²:
- Π£Ρ ΡΠ΄ΡΠ΅Π½ΠΈΠ΅ ΠΎΠ±ΡΠ΅Π³ΠΎ ΡΠ°ΠΌΠΎΡΡΠ²ΡΡΠ²ΠΈΡ.
- ΠΠΎΠ»ΠΎΠ²Π½Π°Ρ ΠΈ ΠΌΡΡΠ΅ΡΠ½Π°Ρ Π±ΠΎΠ»Ρ, ΠΎΠ±ΡΠ°Ρ ΡΠ»Π°Π±ΠΎΡΡΡ, ΠΎΠ·Π½ΠΎΠ±.
- Π’ΠΎΡΠ½ΠΎΡΠ°, ΡΠ²ΠΎΡΠ°.
- ΠΠΎΠ²ΡΡΠ΅Π½ΠΈΠ΅ ΡΠ΅ΠΌΠΏΠ΅ΡΠ°ΡΡΡΡ Π΄ΠΎ ΠΎΡΠΌΠ΅ΡΠΊΠΈ 39-40Β°Π‘.
- Π ΠΎΠ±Π»Π°ΡΡΠΈ ΠΏΠΎΡΠ°ΠΆΠ΅Π½ΠΈΡ ΠΊΠΎΠΆΠ½ΡΡ ΠΏΠΎΠΊΡΠΎΠ²ΠΎΠ² ΠΏΠΎΡΠ²Π»ΡΠ΅ΡΡΡ ΡΡΠ²ΡΡΠ²ΠΎ ΠΆΠΆΠ΅Π½ΠΈΡ, ΡΠ°ΡΠΏΠΈΡΠ°Π½ΠΈΡ ΠΈ Π±ΠΎΠ»ΠΈ.
ΠΠΎΡΠ°ΠΆΠ°Π΅Ρ ΡΠΎΠΆΠ°, ΠΊΠ°ΠΊ ΠΏΡΠ°Π²ΠΈΠ»ΠΎ, ΠΊΠΎΠ½Π΅ΡΠ½ΠΎΡΡΠΈ ΠΈΠ»ΠΈ Π»ΠΈΡΠΎ, Π° Π²ΠΎΡ Π½Π° ΡΡΠ»ΠΎΠ²ΠΈΡΠ΅Β ΠΈΒ ΠΏΠΎΠ»ΠΎΠ²ΡΡ ΠΎΡΠ³Π°Π½Π°Ρ Π½Π΅Π΄ΡΠ³ ΠΏΡΠΎΡΠ²Π»ΡΠ΅ΡΡΡ ΠΊΡΠ°ΠΉΠ½Π΅ ΡΠ΅Π΄ΠΊΠΎ. ΠΠ½Π΅ΡΠ½Π΅Π΅ ΠΏΡΠΎΡΠ²Π»Π΅Π½ΠΈΠ΅ Π±ΠΎΠ»Π΅Π·Π½ΠΈ Ρ Π°ΡΠ°ΠΊΡΠ΅ΡΠΈΠ·ΡΠ΅ΡΡΡ ΠΏΠΎΡΠ²Π»Π΅Π½ΠΈΠ΅ΠΌ Π½Π° ΠΊΠΎΠΆΠ΅ Π½Π΅Π±ΠΎΠ»ΡΡΠΎΠ³ΠΎ ΠΏΡΡΠ½ΡΡΠΊΠ° ΡΠΎΠ·ΠΎΠ²ΠΎΠ³ΠΎ ΠΈΠ»ΠΈ ΠΊΡΠ°ΡΠ½ΠΎΠ³ΠΎ ΡΠ²Π΅ΡΠ°, ΠΊΠΎΡΠΎΡΠΎΠ΅ ΡΠΏΡΡΡΡ Π½Π΅ΠΊΠΎΡΠΎΡΠΎΠ΅ Π²ΡΠ΅ΠΌΡ ΡΡΠ°Π½ΡΡΠΎΡΠΌΠΈΡΡΠ΅ΡΡΡ Π² ΡΠΎΠΆΠΈΡΡΠΎΠ΅ ΠΏΠΎΠΊΡΠ°ΡΠ½Π΅Π½ΠΈΠ΅. Π’Π°ΠΊΠΎΠ΅ ΠΎΠ±ΡΠ°Π·ΠΎΠ²Π°Π½ΠΈΠ΅ ΠΈΠΌΠ΅Π΅Ρ Π΄ΠΎΡΡΠ°ΡΠΎΡΠ½ΠΎ ΡΠ΅ΡΠΊΠΈΠ΅ Π³ΡΠ°Π½ΠΈΡΡ Ρ ΡΡΠ±ΡΠ°ΠΌ ΠΏΠΎ ΠΊΡΠ°ΡΠΌ. Π ΠΌΠ΅ΡΡΠ΅ ΠΏΠΎΡΠ°ΠΆΠ΅Π½ΠΈΡ ΠΊΠΎΠΆΠ° Π³ΠΎΡΡΡΠ°Ρ, Π΄ΠΎΡΡΠ°ΡΠΎΡΠ½ΠΎ Π½Π°ΠΏΡΡΠΆΠ΅Π½Π½Π°Ρ ΠΈ Π±ΠΎΠ»Π΅Π·Π½Π΅Π½Π½Π°Ρ Π²ΠΎ Π²ΡΠ΅ΠΌΡ ΠΏΠ°Π»ΡΠΏΠ°ΡΠΈΠΈ. ΠΠ°Π±ΠΎΠ»Π΅Π²Π°Π½ΠΈΠ΅ ΡΠΎΠΏΡΠΎΠ²ΠΎΠΆΠ΄Π°Π΅ΡΡΡ ΠΏΠΎΡΠ²Π»Π΅Π½ΠΈΠ΅ΠΌ ΠΎΡΠ΅ΡΠ½ΠΎΡΡΠΈ, ΠΊΠΎΡΠΎΡΠ°Ρ ΠΌΠΎΠΆΠ΅Ρ ΡΠ°ΡΠΏΡΠΎΡΡΡΠ°Π½ΡΡΡΡ Π·Π° ΠΏΡΠ΅Π΄Π΅Π»Ρ ΠΏΠΎΠΊΡΠ°ΡΠ½Π΅Π½ΠΈΡ.
Π‘Π»Π΅Π΄ΡΡΡΠ΅ΠΉ ΡΡΠ°Π΄ΠΈΠ΅ΠΉ ΡΠ°Π·Π²ΠΈΡΠΈΡ ΡΠΎΠΆΠΈ ΡΠ²Π»ΡΠ΅ΡΡΡ ΠΏΠΎΡΠ²Π»Π΅Π½ΠΈΠ΅ ΠΏΡΠ·ΡΡΠ΅ΠΉ. Π ΡΠ»ΡΡΠ°Π΅ ΠΈΡ ΡΡΠ°Π²ΠΌΠ°ΡΠΈΠ·Π°ΡΠΈΠΈ ΠΏΡΠΎΠΈΡΡ ΠΎΠ΄ΠΈΡ Π²ΡΡΠ΅ΠΊΠ°Π½ΠΈΠ΅ ΠΆΠΈΠ΄ΠΊΠΎΡΡΠΈ ΠΈ ΠΎΠ±ΡΠ°Π·ΠΎΠ²ΡΠ²Π°Π΅ΡΡΡ ΠΏΠΎΠ²Π΅ΡΡ Π½ΠΎΡΡΠ½Π°Ρ ΡΠ°Π½Π°, ΠΊΠΎΡΠΎΡΠ°Ρ ΠΏΠΎΠ΄Π²Π΅ΡΠΆΠ΅Π½Π° Π±ΠΎΠ»ΡΡΠΎΠΌΡ ΡΠΈΡΠΊΡ ΠΈΠ½ΡΠΈΡΠΈΡΠΎΠ²Π°Π½ΠΈΡ. ΠΡΠ»ΠΈ ΡΠΎΡ ΡΠ°Π½ΡΠ΅ΡΡΡ ΡΠ΅Π»ΠΎΡΡΠ½ΠΎΡΡΡ ΠΏΡΠ·ΡΡΠ΅ΠΉ, ΡΠΎ ΡΠΎ Π²ΡΠ΅ΠΌΠ΅Π½Π΅ΠΌ ΠΎΠ½ΠΈ Π·Π°ΡΡΡ Π°ΡΡ, ΠΎΠ±ΡΠ°Π·ΠΎΠ²ΡΠ²Π°Ρ ΠΊΠΎΡΠΈΡΠ½Π΅Π²ΡΡ ΠΊΠΎΡΠΎΡΠΊΡ Π½Π° ΠΏΠΎΠ²Π΅ΡΡ Π½ΠΎΡΡΠΈ.
ΠΠ°Π²Π΅ΡΡΠ°ΡΡΠ°Ρ ΡΡΠ°Π΄ΠΈΡ ΡΠ°Π·Π²ΠΈΡΠΈΡ ΡΠΎΠΆΠΈ ΠΌΠΎΠΆΠ΅Ρ Π΄Π»ΠΈΡΡΡΡ ΠΎΡ Π½Π΅ΡΠΊΠΎΠ»ΡΠΊΠΈΡ Π½Π΅Π΄Π΅Π»Ρ Π΄ΠΎ ΠΏΠ°ΡΡ ΠΌΠ΅ΡΡΡΠ΅Π². ΠΠ»Ρ Π½Π΅Π΅ Ρ Π°ΡΠ°ΠΊΡΠ΅ΡΠ½Π° ΠΎΡΠ΅ΡΠ½ΠΎΡΡΡ ΡΠΊΠ°Π½Π΅ΠΉ, ΠΏΠΈΠ³ΠΌΠ΅Π½ΡΠ°ΡΠΈΡ ΠΊΠΎΠΆΠΈ ΠΈ ΠΎΠ±ΡΠ°Π·ΠΎΠ²Π°Π½ΠΈΠ΅ ΠΊΠΎΡΠΎΠΊ Π½Π° ΠΌΠ΅ΡΡΠ΅ ΠΏΡΠ·ΡΡΠ΅ΠΉ.
Π Π°Π·Π»ΠΈΡΠ°ΡΡ Π½Π΅ΡΠΊΠΎΠ»ΡΠΊΠΎ ΡΠΎΡΠΌ Π·Π°Π±ΠΎΠ»Π΅Π²Π°Π½ΠΈΡ:
- ΠΡΠΈΡΠ΅ΠΌΠ°ΡΠΎΠ·Π½Π°Ρ β ΠΏΠΎΡΠ°ΠΆΠ΅Π½Π½ΡΠΉ ΡΡΠ°ΡΡΠΎΠΊ ΠΊΠΎΠΆΠΈ ΠΊΡΠ°ΡΠ½Π΅Π΅Ρ, ΡΡΠ°Π½ΠΎΠ²ΠΈΡΡΡ ΠΏΡΠΈΠΏΡΡ Π»ΡΠΌ ΠΈ ΡΠ»Π΅Π³ΠΊΠ° Π²ΡΠΏΠΈΡΠ°ΡΡΠΈΠΌ.
- ΠΡΠΈΡΠ΅ΠΌΠ°ΡΠΎΠ·Π½ΠΎ-Π±ΡΠ»Π»Π΅Π·Π½Π°Ρ β Ρ Π°ΡΠ°ΠΊΡΠ΅ΡΠΈΠ·ΡΠ΅ΡΡΡ ΠΏΠΎΡΠ²Π»Π΅Π½ΠΈΠ΅ΠΌ ΠΏΡΠ·ΡΡΠ΅ΠΉ Ρ ΠΏΡΠΎΠ·ΡΠ°ΡΠ½ΠΎΠΉ ΠΆΠΈΠ΄ΠΊΠΎΡΡΡ. ΠΡΠΈ Π½ΠΎΡΠΌΠ°Π»ΡΠ½ΠΎΠΌ ΡΠ΅ΡΠ΅Π½ΠΈΠΈ Π±ΠΎΠ»Π΅Π·Π½ΠΈ ΠΎΠ½ΠΈ Π»ΠΎΠΏΠ°ΡΡΡΡ ΠΈΠ»ΠΈ ΠΏΡΠΎΠΊΠ°Π»ΡΠ²Π°ΡΡΡΡ ΠΈ Π½Π° ΠΈΡ ΠΌΠ΅ΡΡΠ΅ ΠΎΠ±ΡΠ°Π·ΡΠ΅ΡΡΡ ΡΠΎ Π²ΡΠ΅ΠΌΠ΅Π½Π΅ΠΌ ΠΌΠΎΠ»ΠΎΠ΄Π°Ρ ΠΊΠΎΠΆΠ°. Π Π½Π΅Π±Π»Π°Π³ΠΎΠΏΡΠΈΡΡΠ½ΠΎΠΌ ΡΠ»ΡΡΠ°Π΅ Π²Π΅Π»ΠΈΠΊ ΡΠΈΡΠΊ ΡΠ°Π·Π²ΠΈΡΠΈΡ ΡΡΠΎΠ·ΠΈΠΈ ΠΈΠ»ΠΈ ΡΡΠΎΡΠΈΡΠ΅ΡΠΊΠΎΠΉ ΡΠ·Π²Ρ.
- ΠΡΠΈΡΠ΅ΠΌΠ°ΡΠΎΠ·Π½ΠΎ-Π³Π΅ΠΌΠΎΡΡΠ°Π³ΠΈΡΠ΅ΡΠΊΠ°Ρ β ΠΎΡΠ»ΠΈΡΠΈΡΠ΅Π»ΡΠ½ΠΎΠΉ ΠΎΡΠΎΠ±Π΅Π½Π½ΠΎΡΡΡΡ ΡΡΠΎΠΉ ΡΠΎΡΠΌΡ ΡΠ²Π»ΡΠ΅ΡΡΡ Π½Π°Π»ΠΈΡΠΈΠ΅ ΠΊΡΠΎΠ²ΠΎΠΈΠ·Π»ΠΈΡΠ½ΠΈΡ Π² ΠΏΠΎΡΠ°ΠΆΠ΅Π½Π½ΡΠ΅ ΡΡΠ°ΡΡΠΊΠΈ ΠΊΠΎΠΆΠ½ΡΡ ΠΏΠΎΠΊΡΠΎΠ²ΠΎΠ².
- ΠΡΠ»Π»Π΅Π·Π½ΠΎ-Π³Π΅ΠΌΠΎΡΡΠ°Π³ΠΈΡΠ΅ΡΠΊΠ°Ρ β ΡΠΎΡΠΌΠ° ΡΠΎΠΆΠΈ, ΠΏΡΠΈ ΠΊΠΎΡΠΎΡΠΎΠΉ ΠΏΠΎΡΠ²Π»ΡΡΡΡΡ ΠΏΡΠ·ΡΡΠΈ, Π½Π°ΠΏΠΎΠ»Π½Π΅Π½Π½ΡΠ΅ ΠΊΡΠΎΠ²ΡΠ½ΠΈΡΡΠΎΠΉ ΠΆΠΈΠ΄ΠΊΠΎΡΡΡΡ.
ΠΠΈΠ°Π³Π½ΠΎΡΡΠΈΠΊΠ° Π±ΠΎΠ»Π΅Π·Π½ΠΈ
ΠΠ»Ρ Π΄ΠΈΠ°Π³Π½ΠΎΡΡΠΈΡΠΎΠ²Π°Π½ΠΈΡ Π·Π°Π±ΠΎΠ»Π΅Π²Π°Π½ΠΈΡ ΠΎΠ±ΡΠ·Π°ΡΠ΅Π»ΡΠ½ΠΎ ΡΠ»Π΅Π΄ΡΠ΅Ρ ΠΎΠ±ΡΠ°ΡΠΈΡΡΡΡ ΠΊ Π΄Π΅ΡΠΌΠ°ΡΠΎΠ»ΠΎΠ³Ρ ΠΈ ΠΈΠ½ΡΠ΅ΠΊΡΠΈΠΎΠ½ΠΈΡΡΡ. ΠΠΎΡΠ»Π΅ ΡΡΠ°ΡΠ΅Π»ΡΠ½ΠΎΠ³ΠΎ ΠΎΡΠΌΠΎΡΡΠ° Π²ΡΠ°Ρ Π½Π°Π·Π½Π°ΡΠΈΡ Π°Π½Π°Π»ΠΈΠ·Ρ, ΠΊΠΎΡΠΎΡΡΠ΅ ΠΏΠΎΠΌΠΎΠ³ΡΡ ΠΏΠΎΠ΄ΡΠ²Π΅ΡΠ΄ΠΈΡΡ Π΄ΠΈΠ°Π³Π½ΠΎΠ·.
Π ΠΎΡΠ½ΠΎΠ²Π½ΡΠΌ Π΄ΠΈΠ°Π³Π½ΠΎΡΡΠΈΡΠ΅ΡΠΊΠΈΠΌ ΠΏΡΠΎΡΠ΅Π΄ΡΡΠ°ΠΌ ΠΎΡΠ½ΠΎΡΠΈΡΡΡ:
- ΠΠ½Π°Π»ΠΈΠ· ΠΊΡΠΎΠ²ΠΈ Π½Π° Π²ΡΡΠ²Π»Π΅Π½ΠΈΠ΅ Π°Π½ΡΠΈΡΠ΅Π» ΠΊ ΡΡΡΠ΅ΠΏΡΠΎΠΊΠΎΠΊΠΊΡ, Π²ΡΡΠ²Π»Π΅Π½ΠΈΠ΅ ΡΠΈΡΡΠΎΠ² Π°Π½ΡΠΈΡΡΡΠ΅ΠΏΡΠΎΠ»ΠΈΠ·ΠΈΠ½Π°-Π ΠΈ ΡΡΡΠ΅ΠΏΡΠΎΠΊΠΎΠΊΠΊΠ°.
- ΠΠ±ΡΠΈΠΉ Π°Π½Π°Π»ΠΈΠ· ΠΊΡΠΎΠ²ΠΈ, ΠΊΠΎΡΠΎΡΡΠΉ Π½Π΅ΠΎΠ±Ρ ΠΎΠ΄ΠΈΠΌ Π΄Π»Ρ ΠΎΡΠ΅Π½ΠΊΠΈ ΡΠΎΡΡΠΎΡΠ½ΠΈΡ ΠΏΠ°ΡΠΈΠ΅Π½ΡΠ°, Π²ΡΡΠ²Π»Π΅Π½ΠΈΡ Π²ΠΎΡΠΏΠ°Π»ΠΈΡΠ΅Π»ΡΠ½ΡΡ ΠΏΡΠΎΡΠ΅ΡΡΠΎΠ² β ΠΏΠΎΠ²ΡΡΠ΅Π½Π½ΡΠ΅ ΠΏΠΎΠΊΠ°Π·Π°ΡΠ΅Π»ΠΈ Π»Π΅ΠΉΠΊΠΎΡΠΈΡΠΎΠ² ΠΈ Π‘ΠΠ.
ΠΠ΅ΡΠ΅Π½ΠΈΠ΅ Π±ΠΎΠ»Π΅Π·Π½ΠΈ ΡΠΎΠΆΠΈ
ΠΠ΅ΡΠ΅Π½ΠΈΠ΅ ΡΠΎΠΆΠΈ Π½Π°Π·Π½Π°ΡΠ°Π΅Ρ Π²ΡΠ°Ρ, ΡΡΠΈΡΡΠ²Π°Ρ ΠΎΠ±ΡΠ΅Π΅ ΡΠΎΡΡΠΎΡΠ½ΠΈΠ΅ ΠΏΠ°ΡΠΈΠ΅Π½ΡΠ°, ΡΠΎΡΠΌΡ Π·Π°Π±ΠΎΠ»Π΅Π²Π°Π½ΠΈΡ, Π΅Π΅ ΡΡΠΆΠ΅ΡΡΡ ΠΈ ΡΠΊΠΎΡΠΎΡΡΡ ΠΏΡΠΎΠ³ΡΠ΅ΡΡΠΈΡΠΎΠ²Π°Π½ΠΈΡ. ΠΠ°ΠΆΠ½ΡΠΌ ΡΠ°ΠΊΡΠΎΡΠΎΠΌ ΡΠ²Π»ΡΠ΅ΡΡΡ Π½Π°Π»ΠΈΡΠΈΠ΅ Ρ ΡΠΎΠ½ΠΈΡΠ΅ΡΠΊΠΈΡ Π·Π°Π±ΠΎΠ»Π΅Π²Π°Π½ΠΈΠΉ, ΠΏΠΎΡΠ²Π»Π΅Π½ΠΈΠ΅ ΠΎΡΠ»ΠΎΠΆΠ½Π΅Π½ΠΈΠΉ ΠΈΠ»ΠΈ Π΄ΡΡΠ³ΠΈΡ Π½Π΅Π³Π°ΡΠΈΠ²Π½ΡΡ ΠΏΠΎΡΠ»Π΅Π΄ΡΡΠ²ΠΈΠΉ ΠΎΡ Π±ΠΎΠ»Π΅Π·Π½ΠΈ. ΠΡΠΎΠ²ΠΎΠ΄ΠΈΡΡΡ Π»Π΅ΡΠ΅Π½ΠΈΠ΅, ΠΊΠ°ΠΊ ΠΏΡΠ°Π²ΠΈΠ»ΠΎ, Π² Π΄ΠΎΠΌΠ°ΡΠ½ΠΈΡ ΡΡΠ»ΠΎΠ²ΠΈΡΡ , Π³Π΄Π΅ Π±ΠΎΠ»ΡΠ½ΠΎΠΉ Π²ΡΠΏΠΎΠ»Π½ΡΠ΅Ρ Π²ΡΠ΅ ΡΠ΅ΠΊΠΎΠΌΠ΅Π½Π΄Π°ΡΠΈΠΈ Π²ΡΠ°ΡΠ°. Π ΠΎΡΠΎΠ±ΠΎ ΡΠ»ΠΎΠΆΠ½ΡΡ ΡΠ»ΡΡΠ°ΡΡ ΠΏΠ°ΡΠΈΠ΅Π½Ρ ΠΏΠΎΠ΄Π»Π΅ΠΆΠΈΡ Π³ΠΎΡΠΏΠΈΡΠ°Π»ΠΈΠ·Π°ΡΠΈΠΈ: ΡΡΠΆΠ΅Π»ΠΎΠ΅ ΡΠ΅ΡΠ΅Π½ΠΈΠ΅ Π±ΠΎΠ»Π΅Π·Π½ΠΈ, ΡΠ°ΡΡΡΠ΅ ΡΠ΅ΡΠΈΠ΄ΠΈΠ²Ρ, Π½Π°Π»ΠΈΡΠΈΠ΅ ΡΠΎΠΏΡΡΡΡΠ²ΡΡΡΠΈΡ Π·Π°Π±ΠΎΠ»Π΅Π²Π°Π½ΠΈΠΉ ΠΈ Π΅ΡΠ»ΠΈ ΡΠΎΠΆΠ° ΠΏΠΎΡΠ°Π·ΠΈΠ»Π° ΡΠ΅Π±Π΅Π½ΠΊΠ° ΠΈΠ»ΠΈ ΡΡΠ°ΡΠΈΠΊΠ°.
ΠΠ»Ρ Π»Π΅ΡΠ΅Π½ΠΈΡ ΡΠΎΠΆΠΈ ΠΏΡΠΈΠΌΠ΅Π½ΡΠ΅ΡΡΡ ΠΊΠΎΠΌΠΏΠ»Π΅ΠΊΡΠ½Π°Ρ ΡΠ΅ΡΠ°ΠΏΠΈΡ, ΠΊΠΎΡΠΎΡΠΎΠ΅ ΡΠΎΡΡΠΎΠΈΡ Π² ΠΏΡΠΈΠΌΠ΅Π½Π΅Π½ΠΈΠΈ ΠΏΡΠΎΡΠΈΠ²ΠΎΠ³ΡΠΈΠ±ΠΊΠΎΠ²ΡΡ ΠΏΡΠ΅ΠΏΠ°ΡΠ°ΡΠΎΠ², Π²ΠΈΡΠ°ΠΌΠΈΠ½Π½ΡΡ ΠΊΠΎΠΌΠΏΠ»Π΅ΠΊΡΠΎΠ² ΠΈ Π°Π½ΡΠΈΠ±ΠΈΠΎΡΠΈΠΊΠΎΠ². Π§Π°ΡΠ΅ Π²ΡΠ΅Π³ΠΎ Π½Π°Π·Π½Π°ΡΠ°ΡΡ ΡΠ°ΠΊΠΈΠ΅ ΠΏΡΠ΅ΠΏΠ°ΡΠ°ΡΡ: ΠΠΎΠΊΡΠΈΡΠΈΠΊΠ»ΠΈΠ½, ΠΠ»Π΅ΡΠ΅ΡΡΠΈΠ½, ΠΡΠΈΡΡΠΎΠΌΠΈΡΠΈΠ½, Π‘ΠΏΠΈΡΠ°ΠΌΠΈΡΠΈΠ½, Π€ΡΡΠ°Π·ΠΎΠ»ΠΈΠ΄ΠΎΠ½, ΠΠ΅Π»Π°Π³ΠΈΠ» ΠΈ Π΄ΡΡΠ³ΠΈΠ΅.
ΠΠ° ΡΡΠ΄Ρ Ρ Π°Π½ΡΠΈΠ±ΠΈΠΎΡΠΈΠΊΠ°ΠΌΠΈ ΠΏΡΠΈΠΌΠ΅Π½ΡΡΡΡΡ Π΄ΡΡΠ³ΠΈΠ΅ ΡΡΠ΅Π΄ΡΡΠ²Π°:
- ΠΠ΅Π½Π·ΠΈΠ»ΠΏΠ΅Π½ΠΈΡΠΈΠ»Π»ΠΈΠ½. ΠΡΡΡ ΡΠΎΡΡΠ°Π²Π»ΡΠ΅Ρ 10 Π΄Π½Π΅ΠΉ ΠΈ ΠΏΡΠΈΠΌΠ΅Π½ΡΠ΅ΡΡΡ, ΠΊΠ°ΠΊ ΠΏΡΠ°Π²ΠΈΠ»ΠΎ, Π² ΡΡΠ»ΠΎΠ²ΠΈΡΡ ΡΡΠ°ΡΠΈΠΎΠ½Π°ΡΠ°. ΠΡΠΈ ΡΠ°Π·Π²ΠΈΡΠΈΠΈ ΠΎΡΠ»ΠΎΠΆΠ½Π΅Π½ΠΈΠΉ (ΡΠ»Π΅Π³ΠΌΠΎΠ½Π° ΠΈΠ»ΠΈ Π°Π±ΡΡΠ΅ΡΡ) Π΄ΠΎΠΏΠΎΠ»Π½ΠΈΡΠ΅Π»ΡΠ½ΠΎ ΠΈΡΠΏΠΎΠ»ΡΠ·ΡΠ΅ΡΡΡ ΠΠ΅Π½ΡΠ°ΠΌΠΈΡΠΈΠ½.
- ΠΡΡΠ°Π΄ΠΈΠΎΠ½ ΠΈΠ»ΠΈ Π₯Π»ΠΎΡΠ°Π·ΠΎΠ» ΡΠ΅ΠΊΠΎΠΌΠ΅Π½Π΄ΠΎΠ²Π°Π½Ρ ΠΏΡΠΈ ΡΡΠΊΠΎ Π²ΡΡΠ°ΠΆΠ΅Π½Π½ΡΡ Π²ΠΎΡΠΏΠ°Π»ΠΈΡΠ΅Π»ΡΠ½ΡΡ ΠΏΡΠΎΡΠ΅ΡΡΠ°Ρ Π½Π° ΠΊΠΎΠΆΠ΅.
- ΠΡΠΈΠ΅ΠΌ Π²ΠΈΡΠ°ΠΌΠΈΠ½Π½ΡΡ ΠΊΠΎΠΌΠΏΠ»Π΅ΠΊΡΠΎΠ², ΠΊΠΎΡΠΎΡΡΠ΅ ΠΏΠΎΠΌΠΎΠ³ΡΡ Π²ΠΎΡΡΡΠ°Π½ΠΎΠ²ΠΈΡΡ ΡΠΈΠ»Ρ, ΡΠ»ΡΡΡΠ°Ρ ΠΈΠΌΠΌΡΠ½ΠΈΡΠ΅Ρ ΠΈ ΠΎΠΊΠ°ΠΆΡΡ ΠΏΡΠΎΡΠΈΠ»Π°ΠΊΡΠΈΠΊΡ ΡΠ΅ΡΠΈΠ΄ΠΈΠ²Π°.
Π ΡΠ»ΡΡΠ°Π΅ ΡΠΈΠ»ΡΠ½ΠΎΠΉ ΠΈΠ½ΡΠΎΠΊΡΠΈΠΊΠ°ΡΠΈΠΈ ΠΎΡΠ³Π°Π½ΠΈΠ·ΠΌΠ° ΠΏΡΠΎΠ²ΠΎΠ΄ΠΈΡΡΡ Π΄Π΅Π·ΠΈΠ½ΡΠΎΠΊΡΠΈΠΊΠ°ΡΠΈΠΎΠ½Π½Π°Ρ ΡΠ΅ΡΠ°ΠΏΠΈΡ β Π²Π²Π΅Π΄Π΅Π½ΠΈΠ΅ ΡΠ°ΡΡΠ²ΠΎΡΠ° Π³Π»ΡΠΊΠΎΠ·Ρ, Π³Π΅ΠΌΠΎΠ΄Π΅Π·Β ΠΈΠ»ΠΈ ΠΏΡΠΈΠΌΠ΅Π½Π΅Π½ΠΈΠ΅ ΡΠΈΠ·ΠΈΠΎΠ»ΠΎΠ³ΠΈΡΠ΅ΡΠΊΠΎΠ³ΠΎ ΡΠ°ΡΡΠ²ΠΎΡΠ°. ΠΠΎΠΏΠΎΠ»Π½ΠΈΡΠ΅Π»ΡΠ½ΠΎ Π½Π°Π·Π½Π°ΡΠ°ΡΡΡΡ ΠΌΠΎΡΠ΅Π³ΠΎΠ½Π½ΡΠ΅, ΠΆΠ°ΡΠΎΠΏΠΎΠ½ΠΈΠΆΠ°ΡΡΠΈΠ΅, ΠΎΠ±Π΅Π·Π±ΠΎΠ»ΠΈΠ²Π°ΡΡΠΈΠ΅ ΠΏΡΠ΅ΠΏΠ°ΡΠ°ΡΡ ΠΈ ΠΌΠ΅Π΄ΠΈΠΊΠ°ΠΌΠ΅Π½ΡΡ Π΄Π»Ρ ΡΠΊΡΠ΅ΠΏΠ»Π΅Π½ΠΈΡ ΡΠ΅ΡΠ΄Π΅ΡΠ½ΠΎ-ΡΠΎΡΡΠ΄ΠΈΡΡΠΎΠΉ ΡΠΈΡΡΠ΅ΠΌΡ.
ΠΠ΅ΡΠ΅Π½ΠΈΠ΅ ΡΠ΅ΡΠΈΠ΄ΠΈΠ²Π° ΡΠΎΠΆΠΈ ΠΏΡΠΎΠ²ΠΎΠ΄ΠΈΡΡΡ ΡΠΎΠ»ΡΠΊΠΎ Π² ΡΡΠ»ΠΎΠ²ΠΈΡΡ ΡΡΠ°ΡΠΈΠΎΠ½Π°ΡΠ°. Π’Π΅ΡΠ°ΠΏΠΈΡ Π²ΠΊΠ»ΡΡΠ°Π΅Ρ ΠΏΡΠΈΠ΅ΠΌ Π°Π½ΡΠΈΠ±ΠΈΠΎΡΠΈΠΊΠΎΠ², ΠΊΠΎΡΠΎΡΡΠ΅ ΡΠ°Π½Π΅Π΅ Π½Π΅ ΠΈΡΠΏΠΎΠ»ΡΠ·ΠΎΠ²Π°Π»ΠΈΡΡ Π΄Π»Ρ Π»Π΅ΡΠ΅Π½ΠΈΡ Π±ΠΎΠ»Π΅Π·Π½ΠΈ. ΠΠΎΠΏΠΎΠ»Π½ΠΈΡΠ΅Π»ΡΠ½ΠΎ ΠΏΡΠΎΠ²ΠΎΠ΄ΠΈΡΡΡ ΠΊΠΎΡΡΠ΅ΠΊΡΠΈΡ ΠΈΠΌΠΌΡΠ½ΠΈΡΠ΅ΡΠ°. Π‘ ΡΡΠΎΠΉ ΡΠ΅Π»ΡΡ ΠΈΡΠΏΠΎΠ»ΡΠ·ΡΡΡΡΡ ΠΡΠΊΠ»Π΅ΠΈΠ½Π°Ρ Π½Π°ΡΡΠΈΡ, ΠΠ΅ΡΠΈΠ»ΡΡΠ°ΡΠΈΠ», Π’-Π°ΠΊΡΠΈΠ²ΠΈΠ½ ΠΈ Π΄ΡΡΠ³ΠΈΠ΅ ΠΏΡΠ΅ΠΏΠ°ΡΠ°ΡΡ.
Π ΡΠ»ΡΡΠ°Π΅ ΠΏΠΎΡΠ²Π»Π΅Π½ΠΈΡ ΠΏΡΠ·ΡΡΠ΅ΠΉ ΠΏΡΠΎΠ²ΠΎΠ΄ΠΈΡΡΡ ΠΌΠ΅ΡΡΠ½Π°Ρ ΡΠ΅ΡΠ°ΠΏΠΈΡ. Π‘ΡΠΎΠΈΡ ΠΎΡΠΌΠ΅ΡΠΈΡΡ, ΡΡΠΎ ΡΠ°ΠΊΠΎΠ΅ Π»Π΅ΡΠ΅Π½ΠΈΠ΅ Π΄ΠΎΠΏΡΡΡΠΈΠΌΠΎ ΡΠΎΠ»ΡΠΊΠΎ Π² ΡΠΎΠΌ ΡΠ»ΡΡΠ°Π΅, Π΅ΡΠ»ΠΈ ΠΎΡΠ°Π³ Π½Π΅Π΄ΡΠ³Π° Π»ΠΎΠΊΠ°Π»ΠΈΠ·ΡΠ΅ΡΡΡ Π½Π° Π½ΠΈΠΆΠ½ΠΈΡ ΠΊΠΎΠ½Π΅ΡΠ½ΠΎΡΡΡΡ . ΠΠ°ΠΆΠ½ΠΎ ΠΏΠΎΠΌΠ½ΠΈΡΡ, ΡΡΠΎ ΡΡΠΈΡΠ΅ΠΌΠ°ΡΠΎΠ·Π½Π°Ρ ΡΠΎΡΠΌΠ° Π½Π΅ ΡΡΠ΅Π±ΡΠ΅Ρ ΠΏΡΠΈΠΌΠ΅Π½Π΅Π½ΠΈΡ ΠΌΠ΅ΡΡΠ½ΠΎΠΉ ΡΠ΅ΡΠ°ΠΏΠΈΠΈ, Π° Π½Π΅ΠΊΠΎΡΠΎΡΡΠ΅ ΡΡΠ΅Π΄ΡΡΠ²Π° β ΠΌΠ°Π·Ρ ΠΠΈΡΠ½Π΅Π²ΡΠΊΠΎΠ³ΠΎ, ΡΡΠ΅Π΄ΡΡΠ²Π° Ρ Π°Π½ΡΠΈΠ±ΠΈΠΎΡΠΈΠΊΠ°ΠΌΠΈ β ΠΊΠ°ΡΠ΅Π³ΠΎΡΠΈΡΠ΅ΡΠΊΠΈ ΠΏΡΠΎΡΠΈΠ²ΠΎΠΏΠΎΠΊΠ°Π·Π°Π½Ρ.
ΠΡΠΈ ΠΎΡΡΡΠΎΠΌ ΡΠ΅ΡΠ΅Π½ΠΈΠΈ Π±ΠΎΠ»Π΅Π·Π½ΠΈ ΠΏΡΠ·ΡΡΡ Π½Π°Π΄ΡΠ΅Π·Π°Π΅ΡΡΡ ΠΈ ΠΏΠΎΡΠ»Π΅ Π²ΡΡ ΠΎΠ΄Π° ΠΆΠΈΠ΄ΠΊΠΎΡΡΠΈ Π½Π°ΠΊΠ»Π°Π΄ΡΠ²Π°Π΅ΡΡΡ ΠΏΠΎΠ²ΡΠ·ΠΊΠ°, ΡΠΌΠΎΡΠ΅Π½Π½Π°Ρ Π² 0,02% ΡΠ°ΡΡΠ²ΠΎΡΠ΅ Π€ΡΡΠ°ΡΠΈΠ»ΠΈΠ½Π° ΠΈΠ»ΠΈ 0,1% ΡΠ°ΡΡΠ²ΠΎΡΠ΅ Π ΠΈΠ²Π°Π½ΠΎΠ»Π°. ΠΠ΅Π½ΡΡΡ ΠΏΠΎΠ²ΡΠ·ΠΊΡ ΡΡΠΎΠΈΡ Π½Π΅ΡΠΊΠΎΠ»ΡΠΊΠΎ ΡΠ°Π· Π² ΡΡΡΠΊΠΈ, ΠΏΡΠΈ ΡΡΠΎΠΌ ΠΊΠ°ΡΠ΅Π³ΠΎΡΠΈΡΠ΅ΡΠΊΠΈ Π·Π°ΠΏΡΠ΅ΡΠ΅Π½ΠΎ Π΄Π΅Π»Π°ΡΡ ΡΡΠ³ΠΎΠ΅ ΠΏΠ΅ΡΠ΅Π²ΡΠ·ΡΠ²Π°Π½ΠΈΠ΅ ΠΈΠ»ΠΈ Π±ΠΈΠ½ΡΠΎΠ²Π°Π½ΠΈΠ΅. ΠΠΎΠΏΠΎΠ»Π½ΠΈΡΠ΅Π»ΡΠ½ΠΎ ΠΌΠΎΠ³ΡΡ ΠΈΡΠΏΠΎΠ»ΡΠ·ΠΎΠ²Π°ΡΡΡΡ ΡΠ»Π΅Π΄ΡΡΡΠΈΠ΅ ΠΌΠ΅ΡΠΎΠ΄Ρ Π»Π΅ΡΠ΅Π½ΠΈΡ: ΡΠ»ΡΡΡΠ°ΡΠΈΠΎΠ»Π΅ΡΠΎΠ²ΠΎΠ΅ ΠΎΠ±Π»ΡΡΠ΅Π½ΠΈΠ΅, Π»Π°Π·Π΅ΡΠΎΡΠ΅ΡΠ°ΠΏΠΈΡ, ΠΏΠ°ΡΠ°ΡΠΈΠ½ΠΎΡΠ΅ΡΠ°ΠΏΠΈΡ Π΄Π»Ρ ΡΡΡΡΠ°Π½Π΅Π½ΠΈΡ ΠΎΡΠ°Π³ΠΎΠ² Π½Π° Π»ΠΈΡΠ΅, ΡΠΎΠ΄ΠΎΠ²ΡΠ΅ Π²Π°Π½Π½Ρ ΠΈ Π΄ΡΡΠ³ΠΎΠ΅.
Π Π½Π΅ΠΊΠΎΡΠΎΡΡΡ ΡΠ»ΡΡΠ°ΡΡ Π½Π°Π±Π»ΡΠ΄Π°ΡΡΡΡ ΠΎΡΠ»ΠΎΠΆΠ½Π΅Π½ΠΈΡ Π±ΠΎΠ»Π΅Π·Π½ΠΈ: Π°Π±ΡΡΠ΅ΡΡ, ΡΡΠΎΠΌΠ±ΠΎΡΠ»Π΅Π±ΠΈΡ, Π½Π΅ΠΊΡΠΎΠ· ΡΠΊΠ°Π½Π΅ΠΉ, Π½Π°Π³Π½ΠΎΠ΅Π½ΠΈΠ΅ ΠΈ ΠΈΠ½ΡΠΈΡΠΈΡΠΎΠ²Π°Π½ΠΈΠ΅ ΠΏΡΠ·ΡΡΠ΅ΠΉ, Π²ΠΎΡΠΏΠ°Π»Π΅Π½ΠΈΠ΅ Π»ΠΈΠΌΡΠ°ΡΠΈΡΠ΅ΡΠΊΠΈΡ ΡΠ·Π»ΠΎΠ² ΠΈΠ»ΠΈ Π²Π΅Π½. ΠΠ½ΠΎΠ³Π΄Π° Π² ΡΠ΅Π·ΡΠ»ΡΡΠ°ΡΠ΅ ΠΏΠ΅ΡΠ΅Π½Π΅ΡΠ΅Π½Π½ΠΎΠΉ Π±ΠΎΠ»Π΅Π·Π½ΠΈ Π²ΠΎΠ·Π½ΠΈΠΊΠ°ΡΡ ΡΠ΅ΡΠ΄Π΅ΡΠ½ΠΎ-ΡΠΎΡΡΠ΄ΠΈΡΡΡΠ΅ Π±ΠΎΠ»Π΅Π·Π½ΠΈ, ΡΠ΅ΠΏΡΠΈΡ. ΠΡΠΈ ΡΠ²ΠΎΠ΅Π²ΡΠ΅ΠΌΠ΅Π½Π½ΠΎΠΌ ΠΈ ΠΏΡΠ°Π²ΠΈΠ»ΡΠ½ΠΎΠΌ Π»Π΅ΡΠ΅Π½ΠΈΠΈ, ΡΠΎΠ±Π»ΡΠ΄Π΅Π½ΠΈΠΈ Π²ΡΠ΅Ρ ΡΠ΅ΠΊΠΎΠΌΠ΅Π½Π΄Π°ΡΠΈΠΉ Π²ΡΠ°ΡΠ° ΠΌΠΎΠΆΠ½ΠΎ ΠΈΠ·Π±Π΅ΠΆΠ°ΡΡ ΡΡΠΎΠ»Ρ Π½Π΅Π³Π°ΡΠΈΠ²Π½ΡΡ ΠΏΠΎΡΠ»Π΅Π΄ΡΡΠ²ΠΈΠΉ.
ΠΡΠΎΡΠΈΠ»Π°ΠΊΡΠΈΠΊΠ° Π·Π°Π±ΠΎΠ»Π΅Π²Π°Π½ΠΈΡ
ΠΡΠ΅Π΄ΡΠΏΡΠ΅Π΄ΠΈΡΡ ΠΌΠΎΠΆΠ½ΠΎ ΡΠΎΠ»ΡΠΊΠΎ ΡΠ΅ΡΠΈΠ΄ΠΈΠ² Π·Π°Π±ΠΎΠ»Π΅Π²Π°Π½ΠΈΡ, Π΅ΡΠ»ΠΈ Π±ΠΎΠ»ΡΠ½ΠΎΠΉ ΡΡΡΠ°Π΄Π°Π΅Ρ ΡΠ΅ΡΠΈΠ΄ΠΈΠ²ΠΈΡΡΡΡΠ΅ΠΉ ΡΠΎΡΠΌΠΎΠΉ. ΠΠ»Ρ ΡΡΠΎΠ³ΠΎ ΠΏΡΠΈΠΌΠ΅Π½ΡΠ΅ΡΡΡ Π²Π½ΡΡΡΠΈΠΌΡΡΠ΅ΡΠ½ΠΎΠ΅ Π²Π²Π΅Π΄Π΅Π½ΠΈΠ΅ ΠΠΈΡΠΈΠ»Π»ΠΈΠ½Π° ΠΈΠ»ΠΈ Π Π΅ΡΠ°ΡΠΏΠ΅Π½Π°. ΠΡΠ»ΠΈ Π½Π°Π±Π»ΡΠ΄Π°ΡΡΡΡ ΡΠ°ΡΡΡΠ΅ ΡΠ΅ΡΠΈΠ΄ΠΈΠ²Ρ ΡΠ΅ΠΊΠΎΠΌΠ΅Π½Π΄ΠΎΠ²Π°Π½Π° Π½Π΅ΠΏΡΠ΅ΡΡΠ²Π½Π°Ρ ΠΊΡΡΠ³Π»ΠΎΠ³ΠΎΠ΄ΠΈΡΠ½Π°Ρ ΠΏΡΠΎΡΠΈΠ»Π°ΠΊΡΠΈΠΊΠ°. Π ΡΠ»ΡΡΠ°Π΅ ΠΎΠ±ΠΎΡΡΡΠ΅Π½ΠΈΡ Π±ΠΎΠ»Π΅Π·Π½ΠΈ Π² ΠΎΡΠ΅Π½Π½ΠΈΠΉ ΠΏΠ΅ΡΠΈΠΎΠ΄ β ΠΏΡΠ΅Π²Π΅Π½ΡΠΈΠ²Π½ΡΠ΅ ΠΌΠ΅ΡΡ Π½Π°ΡΠΈΠ½Π°ΡΡ ΠΈΡΠΏΠΎΠ»ΡΠ·ΠΎΠ²Π°ΡΡΡΡ Π·Π° ΠΌΠ΅ΡΡΡ Π΄ΠΎ Π½Π°ΡΠ°Π»Π° ΡΠ΅Π·ΠΎΠ½Π°.
ΠΠΊΠΎΠ½ΡΠ°ΠΊΡΠ΅
Google+
24doctor.info
Π ΠΎΠΆΠ° ΡΠΈΠΌΠΏΡΠΎΠΌΡ ΠΈ Π»Π΅ΡΠ΅Π½ΠΈΠ΅| ΠΠ°ΠΊ Π»Π΅ΡΠΈΡΡ ΡΠΎΠΆΡ Π² Π΄ΠΎΠΌΠ°ΡΠ½ΠΈΡ ΡΡΠ»ΠΎΠ²ΠΈΡΡ
Π ΠΎΠΆΠ° β ΡΡΠΎ ΠΈΠ½ΡΠ΅ΠΊΡΠΈΠΎΠ½Π½ΠΎΠ΅ Π·Π°Π±ΠΎΠ»Π΅Π²Π°Π½ΠΈΠ΅ Π²Π΅ΡΡ Π½ΠΈΡ (ΠΏΠΎΠ²Π΅ΡΡ Π½ΠΎΡΡΠ½ΡΡ ) ΡΠ»ΠΎΠ΅Π² ΠΊΠΎΠΆΠΈ, Π²ΡΠ·ΡΠ²Π°Π΅ΠΌΠΎΠ΅ ΡΡΡΠ΅ΠΏΡΠΎΠΊΠΎΠΊΠΊΠΎΠ²ΡΠΌΠΈ Π±Π°ΠΊΡΠ΅ΡΠΈΡΠΌΠΈ. ΠΠ°Π±ΠΎΠ»Π΅Π²Π°Π½ΠΈΠ΅ ΠΌΠΎΠΆΠ΅Ρ Π½Π°ΡΠ°ΡΡΡΡ Ρ Π½Π΅Π·Π½Π°ΡΠΈΡΠ΅Π»ΡΠ½ΠΎΠΉ ΡΡΠ°Π²ΠΌΡ, ΠΊΠ°ΠΊ ΡΡΠΈΠ±, ΠΎΠΆΠΎΠ³, ΡΠ°Π½Π° ΠΈΠ»ΠΈ ΠΏΠΎΡΠ΅Π·. ΠΠ°ΠΊ Π»Π΅ΡΠΈΡΡ ΡΠΎΠΆΡ Π² Π΄ΠΎΠΌΠ°ΡΠ½ΠΈΡ ΡΡΠ»ΠΎΠ²ΠΈΡΡ ? ΠΠ΅ΡΠ΅Π½ΠΈΠ΅ Π½Π°ΡΠΎΠ΄Π½ΡΠΌΠΈ ΡΡΠ΅Π΄ΡΡΠ²Π°ΠΌΠΈ — ΠΎΠ΄ΠΈΠ½ ΠΈΡ ΠΌΠ½ΠΎΠ³ΠΈΡ ΡΡΡΠ΅ΠΊΡΠΈΠ²Π½ΡΡ ΡΠΏΠΎΡΠΎΠ±ΠΎΠ² Π±ΠΎΡΡΠ±Ρ Ρ ΡΡΠΈΠΌ Π½Π΅Π΄ΡΠ³ΠΎΠΌ.
ΠΠ°ΠΊ ΠΏΡΠΎΡΠ²Π»ΡΠ΅ΡΡΡ ΡΠΎΠΆΠ° — ΠΏΡΠΈΠ·Π½Π°ΠΊΠΈ ΠΈ ΡΠΈΠΌΠΏΡΠΎΠΌΡ Π±ΠΎΠ»Π΅Π·Π½ΠΈ
Π ΠΎΠΆΠΈΡΡΠΎΠ΅ Π·Π°Π±ΠΎΠ»Π΅Π²Π°Π½ΠΈΠ΅ ΠΏΡΠΎΡΠ²Π»ΡΠ΅ΡΡΡ Π½Π° ΠΊΠΎΠΆΠ΅ ΡΠ΅Π»ΠΎΠ²Π΅ΠΊΠ° Π²ΠΎΡΠΏΠ°Π»Π΅Π½ΠΈΠ΅ΠΌ ΠΊΡΠ°ΡΠ½ΠΎΠ³ΠΎ ΡΠ²Π΅ΡΠ°, ΡΡΠΎ ΡΠΎΠ±ΡΡΠ²Π΅Π½Π½ΠΎ ΠΈ Π΄Π°Π»ΠΎ ΡΡΠΎΠΉ Π±ΠΎΠ»Π΅Π·Π½ΠΈ ΡΠ°ΠΊΠΎΠ΅ Π½Π°Π·Π²Π°Π½ΠΈΠ΅. Π§Π°ΡΠ΅ Π²ΡΠ΅Π³ΠΎ ΡΠΈΠΌΠΏΡΠΎΠΌΡ ΡΠΎΠΆΠΈ Π²ΠΎΠ·Π½ΠΈΠΊΠ°ΡΡ Π½Π° ΠΊΠΎΠ½Π΅ΡΠ½ΠΎΡΡΡΡ , Π½Π΅ΠΌΠ½ΠΎΠ³ΠΎ ΡΠ΅ΠΆΠ΅ Π½Π° Π»ΠΈΡΠ΅ ΠΈΠ»ΠΈ Π½Π° ΡΠ΅Π»Π΅. ΠΠΎΠ·Π±ΡΠ΄ΠΈΡΠ΅Π»Ρ ΡΡΠΎΠΉ Π±ΠΎΠ»Π΅Π·Π½ΠΈ β Π²ΠΈΡΡΡ ΡΡΡΠ΅ΠΏΡΠΎΠΊΠΎΠΊΠΊ, ΠΊΠΎΡΠΎΡΡΠΉ ΠΏΡΠΎΠ½ΠΈΠΊΠ°Π΅Ρ Π² ΡΠ΅Π»ΠΎ ΡΠ΅Π»ΠΎΠ²Π΅ΠΊΠ° ΡΠ΅ΡΠ΅Π· ΠΏΠΎΡΠ΅Π·Ρ ΠΈΠ»ΠΈ ΡΡΠ°Π΄ΠΈΠ½Ρ, Π° ΡΠ°ΠΊΠΆΠ΅ Π·Π°Π±ΠΎΠ»Π΅Π²Π°Π½ΠΈΠ΅ ΠΌΠΎΠΆΠ΅Ρ ΡΠ°Π·Π²ΠΈΡΡΡΡ ΠΏΠΎΡΠ»Π΅ Ρ ΡΠΎΠ½ΠΈΡΠ΅ΡΠΊΠΈΡ Π±ΠΎΠ»Π΅Π·Π½Π΅ΠΉ.
ΠΠ±ΡΡΠ½ΠΎ ΠΈΠ½ΡΠ΅ΠΊΡΠΈΡ Π² ΠΎΡΠ³Π°Π½ΠΈΠ·ΠΌΠ΅ Π½Π°ΡΠΈΠ½Π°Π΅Ρ ΠΏΡΠΎΠ³ΡΠ΅ΡΡΠΈΡΠΎΠ²Π°ΡΡ ΠΏΡΠΈ ΠΎΡΠ»Π°Π±Π»Π΅Π½Π½ΠΎΠΉ Π·Π°ΡΠΈΡΠ΅ ΠΎΡΠ³Π°Π½ΠΈΠ·ΠΌΠ°, ΠΏΠΎΡΡΠΎΠΌΡ ΡΠΈΠΌΠΏΡΠΎΠΌΡ ΡΠΎΠΆΠΈ Π²ΠΎΠ·Π½ΠΈΠΊΠ°ΡΡ ΠΏΠ°ΡΠ°Π»Π»Π΅Π»ΡΠ½ΠΎ Ρ Π΄ΡΡΠ³ΠΈΠΌΠΈ Π·Π°Π±ΠΎΠ»Π΅Π²Π°Π½ΠΈΡΠΌΠΈ. Π’Π°ΠΊ ΠΊΠ°ΠΊ ΠΈΠ·Π½Π°ΡΠ°Π»ΡΠ½ΠΎ ΠΏΡΠΎΠΈΡΡ ΠΎΠ΄ΠΈΡ ΡΠ΅Π·ΠΊΠΎΠ΅ ΠΏΠΎΠ²ΡΡΠ΅Π½ΠΈΠ΅ ΡΠ΅ΠΌΠΏΠ΅ΡΠ°ΡΡΡΡ Π΄ΠΎ 39-40 Π‘, ΡΠΎ ΡΠΈΠΌΠΏΡΠΎΠΌΡ ΡΠΎΠΆΠΈ Ρ Π°ΡΠ°ΠΊΡΠ΅ΡΠΈΠ·ΡΡΡΡΡ ΠΎΠ·Π½ΠΎΠ±ΠΎΠΌ, Π³ΠΎΠ»ΠΎΠ²Π½ΠΎΠΉ Π±ΠΎΠ»ΡΡ. Π’Π°ΠΊΠΆΠ΅ Π½Π°Π±Π»ΡΠ΄Π°Π΅ΡΡΡ ΡΠ°ΠΊΠΈΠ΅ ΡΠΈΠΌΠΏΡΠΎΠΌΡ ΡΠΎΠΆΠΈ ΠΊΠ°ΠΊ:
1.
ΠΎΠ±ΡΠ°Ρ ΡΠ»Π°Π±ΠΎΡΡΡ,
2.
ΡΠΎΡΠ½ΠΎΡΠ°,
3.
ΡΡΠ°ΡΠ΅Π½ΠΈΠ΅ ΠΏΡΠ»ΡΡΠ°.
ΠΡΠΈ ΡΠ»ΠΎΠΆΠ½ΠΎΠΌ ΡΠ΅ΡΠ΅Π½ΠΈΠΈ ΡΠΎΠΆΠΈ ΠΌΠΎΠ³ΡΡ Π½Π°Π±Π»ΡΠ΄Π°ΡΡΡΡ Π±ΡΠ΅Π΄, ΡΡΠ΄ΠΎΡΠΎΠ³ΠΈ. ΠΠΎ ΠΏΡΠΎΡΠ΅ΡΡΠ²ΠΈΠΈ 12-24 ΡΠ°ΡΠΎΠ² Π½Π°ΡΠΈΠ½Π°Π΅Ρ ΠΏΡΠΎΡΠ²Π»ΡΡΡΡΡ ΠΏΠΎΠΊΡΠ°ΡΠ½Π΅Π½ΠΈΠ΅ ΠΊΠΎΠΆΠΈ, ΠΎΡΠ΅ΠΊ, ΡΡΠ½ΡΡΠ΅Π΅ ΠΎΡΡΡΠ΅Π½ΠΈΠ΅ ΡΡΠ°ΡΡΠΊΠ°, ΠΊΠΎΡΠΎΡΡΠΉ Π±ΡΠ» ΠΏΠΎΡΠ°ΠΆΠ΅Π½ ΠΈΠ½ΡΠ΅ΠΊΡΠΈΠ΅ΠΉ. Π’Π°ΠΊ ΠΊΠ°ΠΊ ΠΌΠ΅ΡΡΠ° ΡΠ°Π·Π½ΠΎΠΎΠ±ΡΠ°Π·Π½Ρ, Π² ΠΊΠΎΡΠΎΡΡΡ Π²ΠΎΠ·Π½ΠΈΠΊΠ°Π΅Ρ ΡΠΎΠΆΠΈΡΡΠΎΠ΅ Π²ΠΎΡΠΏΠ°Π»Π΅Π½ΠΈΠ΅, ΡΠΈΠΌΠΏΡΠΎΠΌΡ Π΅Π³ΠΎ ΡΠΎΠΎΡΠ²Π΅ΡΡΡΠ²Π΅Π½Π½ΠΎ ΡΠΎΠΆΠ΅.
ΠΠΎ ΠΈΡΡΠ΅ΡΠ΅Π½ΠΈΡ Π½Π΅ΠΊΠΎΡΠΎΡΠΎΠ³ΠΎ Π²ΡΠ΅ΠΌΠ΅Π½ΠΈ ΠΈ ΡΡΠ»ΠΎΠΆΠ½Π΅Π½ΠΈΡ Π·Π°Π±ΠΎΠ»Π΅Π²Π°Π½ΠΈΡ ΠΏΡΠΈ Π½Π°Π΄Π°Π²Π»ΠΈΠ²Π°Π½ΠΈΠΈ Π½Π° ΠΏΠΎΡΠ°ΠΆΠ΅Π½Π½ΡΡ ΡΠ°ΡΡΡ ΠΎΡΡΡΠ°Π΅ΡΡΡ Π±ΠΎΠ»Ρ, ΠΆΠΆΠ΅Π½ΠΈΠ΅, Π·ΡΠ΄, ΠΏΠΎΠΊΡΠ°ΡΠ½Π΅Π½ΠΈΡ. ΠΡΠ»ΠΈ Π½Π΅ Π»Π΅ΡΠΈΡΡ Π·Π°Π±ΠΎΠ»Π΅Π²Π°Π½ΠΈΠ΅, ΡΠΎ Π² Π΄Π°Π»ΡΠ½Π΅ΠΉΡΠ΅ΠΌ ΠΊ ΡΠΈΠΌΠΏΡΠΎΠΌΠ°ΠΌ ΡΠΎΠΆΠΈ ΠΏΡΠΈΡΠΎΠ΅Π΄ΠΈΠ½ΡΡΡΡΡ ΡΠ΅Π»ΡΡΠ΅Π½ΠΈΠ΅ ΠΈ ΠΏΠΈΠ³ΠΌΠ΅Π½ΡΠ°ΡΠΈΡ.
Π‘ΠΈΠΌΠΏΡΠΎΠΌΡ ΡΠ°Π·Π½ΡΡ ΡΠΎΡΠΌ ΡΠΎΠΆΠΈ Π½Π° ΠΊΠΎΠΆΠ΅
1.
ΠΡΠΈΡΠ΅ΠΌΠ°ΡΠΎΠ·Π½Π°Ρ ΡΠΎΡΠΌΠ° ΡΠΎΠΆΠΈ
ΠΠΎΡΠΏΠ°Π»Π΅Π½Π½ΠΎΠ΅ ΠΌΠ΅ΡΡΠΎ ΡΠΎΠΏΡΠΎΠ²ΠΎΠΆΠ΄Π°Π΅ΡΡΡ Π±ΠΎΠ»ΡΡ, ΠΎΡΠ΅ΠΊΠΎΠΌ ΠΈ ΠΏΠΎΠΊΡΠ°ΡΠ½Π΅Π½ΠΈΠ΅. Π’Π°ΠΊ ΠΊΠ°ΠΊ Π΅ΡΡΡ ΡΠΈΠΌΠΏΡΠΎΠΌ ΠΎΡΠ΅ΡΠ½ΠΎΡΡΠΈ, ΡΠΎ ΡΠΎΠΆΠ° Π½Π΅ΠΌΠ½ΠΎΠ³ΠΎ Π²ΡΡΡΡΠΏΠ°Π΅Ρ Π½Π°Π΄ ΠΏΠΎΠ²Π΅ΡΡ Π½ΠΎΡΡΡΡ Π·Π΄ΠΎΡΠΎΠ²ΠΎΠΉ ΠΊΠΎΠΆΠΈ, Π° Π³ΡΠ°Π½ΠΈΡΡ Π΅Π΅ ΡΠ΅ΡΠΊΠΈΠ΅, ΠΈ ΠΈΠΌΠ΅ΡΡ Π²ΠΈΠ·ΡΠ°Π»ΡΠ½ΠΎΠ΅ ΡΡ ΠΎΠ΄ΡΡΠ²ΠΎ Ρ ΡΠ·ΡΠΊΠ°ΠΌΠΈ ΠΏΠ»Π°ΠΌΠ΅Π½ΠΈ.
2.
ΠΡΠΈΡΠ΅ΠΌΠ°ΡΠΎΠ·Π½ΠΎ-Π±ΡΠ»Π»Π΅Π·Π½Π°Ρ ΡΠΎΡΠΌΠ° ΡΠΎΠΆΠΈ
ΠΡΠ»ΠΈΡΠ°Π΅ΡΡΡ ΠΎΡ ΠΏΡΠ΅Π΄ΡΠ΄ΡΡΠ΅ΠΉ ΡΠΎΡΠΌΡ ΡΠΎΠΆΠΈ ΡΠ°ΠΊΠΈΠΌ ΡΠΈΠΌΠΏΡΠΎΠΌΠΎΠΌ:, ΡΡΠΎ ΡΠ΅ΡΠ΅Π· 1-3 ΡΡΡΠΎΠΊ Π½Π° ΠΌΠ΅ΡΡΠ΅ ΠΏΠΎΠΊΡΠ°ΡΠ½Π΅Π½ΠΈΡ, Π½Π°ΡΠΈΠ½Π°ΡΡ ΠΏΠΎΡΠ²Π»ΡΡΡΡΡ Π²ΠΎΠ΄ΡΠ½ΠΈΡΡΡΠ΅ ΠΏΡΠ·ΡΡΡΠΊΠΈ. ΠΠ½ΠΈ ΠΏΠΎΠ΄ΡΡΡ Π°ΡΡ, Π»ΠΎΠΏΠ°ΡΡΡΡ, ΠΈ ΠΊΠ°ΠΊ ΠΏΡΠ°Π²ΠΈΠ»ΠΎ, Π½Π° ΠΌΠ΅ΡΡΠ΅ ΠΈΡ ΡΡΡΠ΅ΡΡΠ²ΠΎΠ²Π°Π½ΠΈΡ Π½Π΅ ΠΎΡΡΠ°Π΅ΡΡΡ ΡΡΠ°ΠΌΠΎΠ² ΠΏΠΎΡΠ»Π΅ ΠΏΠΎΠ»Π½ΠΎΠ³ΠΎ ΠΈΡ Π·Π°ΠΆΠΈΠ²Π»Π΅Π½ΠΈΡ. ΠΡΠ΅Π½Ρ ΡΠ΅Π΄ΠΊΠΎ ΠΌΠΎΠΆΠ΅Ρ ΡΠ»ΡΡΠΈΡΡΡΡ, ΡΡΠΎ ΠΎΠ½ΠΈ ΠΌΠΎΠ³ΡΡ ΠΏΠ΅ΡΠ΅ΡΠ°ΡΡΠΈ Π² ΡΠ·Π²ΠΎΡΠΊΠΈ.
3.
ΠΡΠΈΡΠ΅ΠΌΠ°ΡΠΎΠ·Π½ΠΎ-Π³Π΅ΠΌΠΎΡΡΠ°Π³ΠΈΡΠ΅ΡΠΊΠ°Ρ ΡΠΎΡΠΌΠ° ΡΠΎΠΆΠΈ
ΠΡΠ»ΠΈΡΠ°Π΅ΡΡΡ ΠΎΡ ΠΏΠ΅ΡΠ²ΠΎΠΉ ΡΠΎΡΠΌΡ ΡΠΎΠΆΠΈ ΡΠΈΠΌΠΏΡΠΎΠΌΠ°ΠΌΠΈ ΠΊΡΠΎΠ²ΠΎΠΈΠ·Π»ΠΈΡΠ½ΠΈΠΉ.
4.
ΠΡΠ»Π»Π΅Π·Π½ΠΎ-Π³Π΅ΠΌΠΎΡΡΠ°Π³ΠΈΡΠ΅ΡΠΊΠ°Ρ ΡΠΎΡΠΌΠ° ΡΠΎΠΆΠΈ
Π’Π°ΠΊΠΆΠ΅ ΠΊΠ°ΠΊ ΠΏΡΠΈ ΡΡΠΈΡΠ΅ΠΌΠ°ΡΠΎΠ·Π½ΠΎ-Π±ΡΠ»Π»Π΅Π·Π½ΠΎΠΉ ΡΠΎΡΠΌΠ΅, ΠΎΠ±ΡΠ°Π·ΡΡΡΡΡ ΠΏΡΠ·ΡΡΡΠΊΠΈ, Π΅Π΄ΠΈΠ½ΡΡΠ²Π΅Π½Π½ΡΠΌ ΠΎΡΠ»ΠΈΡΠΈΠ΅ΠΌ Π΅ΡΡΡ ΡΠΎ, ΡΡΠΎ Π½Π°ΠΏΠΎΠ»Π½Π΅Π½Ρ ΠΎΠ½ΠΈ Π½Π΅ ΠΏΡΠΎΠ·ΡΠ°ΡΠ½ΠΎΠΉ ΠΆΠΈΠ΄ΠΊΠΎΡΡΡΡ, Π° ΠΊΡΠΎΠ²ΡΠ½ΠΈΡΡΠΎΠΉ.
Π‘ΠΈΠΌΠΏΡΠΎΠΌΡ ΡΠΎΠΆΠΈΡΡΠΎΠ³ΠΎ Π²ΠΎΡΠΏΠ°Π»Π΅Π½ΠΈΡ ΡΠ°Π·Π½ΠΎΠΉ ΡΡΠ΅ΠΏΠ΅Π½ΠΈ ΡΡΠΆΠ΅ΡΡΠΈ
1.
ΠΠ΅Π³ΠΊΠ°Ρ ΡΠΎΡΠΌΠ° ΡΠΎΠΆΠΈ
ΠΡΠΎΡΠ΅ΠΊΠ°Π΅Ρ Ρ ΠΏΡΠΈΠ³Π»ΡΡΠ΅Π½Π½ΡΠΌ ΠΏΡΠΎΡΠ²Π»Π΅Π½ΠΈΠ΅ΠΌ. Π’Π΅ΠΌΠΏΠ΅ΡΠ°ΡΡΡΠ° ΠΏΡΠΈ ΡΡΠΎΠΉ ΡΠΎΡΠΌΠ΅ ΡΠΎΠΆΠΈ Π΄ΠΎ 39 Π‘, ΡΠ»Π°Π±ΠΎΡΡΡ, ΠΈ Π½Π΅Π·Π½Π°ΡΠΈΡΠ΅Π»ΡΠ½ΡΠΌ ΠΏΠΎΡΠ°ΠΆΠ΅Π½ΠΈΠ΅ΠΌ ΠΊΠΎΠΆΠ½ΡΡ ΠΏΠΎΠΊΡΠΎΠ²ΠΎΠ².
2.
Π‘ΡΠ΅Π΄Π½Π΅ΡΡΠΆΠ΅Π»Π°Ρ ΡΠΎΡΠΌΠ° ΠΈΠΌΠ΅Π΅Ρ Π±ΠΎΠ»ΡΡΡΡ Π΄Π»ΠΈΡΠ΅Π»ΡΠ½ΠΎΡΡΡ ΡΠ΅ΡΠ΅Π½ΠΈΡ Π±ΠΎΠ»Π΅Π·Π½ΠΈ, ΠΈ ΠΎΡΡΡΡΠΌΠΈ ΠΏΡΠΎΡΠ²Π»Π΅Π½ΠΈΡΠΌΠΈ Π²ΡΠ΅Ρ ΡΠΈΠΌΠΏΡΠΎΠΌΠΎΠ² ΡΠΎΠΆΠΈ.
3.
Π’ΡΠΆΠ΅Π»Π°Ρ ΡΠΎΡΠΌΠ° Π²ΠΎΡΠΏΠ°Π»Π΅Π½ΠΈΡ, ΠΊΡΠΎΠΌΠ΅ ΠΎΡΡΡΡΡ ΠΏΡΠΎΡΠ²Π»Π΅Π½ΠΈΠΉ Π±ΠΎΠ»Π΅Π·Π½ΠΈ Ρ Π°ΡΠ°ΠΊΡΠ΅ΡΠΈΠ·ΡΠ΅ΡΡΡ Π΄ΠΈΡΠ±Π°Π»Π°Π½ΡΠΎΠΌ ΠΏΡΠΈΡ ΠΈΡΠ΅ΡΠΊΠΎΠ³ΠΎ ΡΠΎΡΡΠΎΡΠ½ΠΈΡ.
4.
Π Π΅ΡΠΈΠ΄ΠΈΠ²ΠΈΡΡΡΡΠ°Ρ
ΠΡΠ»ΠΈ Π»Π΅ΡΠ΅Π½ΠΈΠ΅ ΡΠΎΠΆΠΈ ΠΏΠ΅ΡΠ²ΠΈΡΠ½ΠΎΠ³ΠΎ ΠΈΠ½ΡΠΈΡΠΈΡΠΎΠ²Π°Π½ΠΈΡ Π±ΡΠ»ΠΎ Π½Π΅Π·Π°ΠΊΠΎΠ½ΡΠ΅Π½Π½ΡΠΌ, Π° ΡΠ°ΠΊΠΆΠ΅ ΠΏΡΠΈ Π½Π°Π»ΠΈΡΠΈΠΈ ΡΠ°ΠΊΡΠΎΡΠΎΠ² ΠΎΡΠ»Π°Π±Π»ΡΡΡΠΈΡ ΠΎΡΠ³Π°Π½ΠΈΠ·ΠΌ(ΠΌΠΈΠΊΠΎΠ·Ρ, ΡΠΈΠ½ΡΡΠΈΡΡ ΠΈ Ρ.Π΄.), ΡΠΎ Π²ΠΎΠ·ΠΌΠΎΠΆΠ½ΠΎ ΠΏΠΎΠ²ΡΠΎΡΠ½ΠΎΠ΅ Π΅Π΅ Π²ΠΎΠ·Π½ΠΈΠΊΠ½ΠΎΠ²Π΅Π½ΠΈΠ΅. ΠΡΠ»ΠΈ ΡΡΠΎ ΡΠ»ΡΡΠ°Π΅ΡΡΡ Π² Π±Π»ΠΈΠΆΠ°ΠΉΡΠΈΠ΅ 2 Π³ΠΎΠ΄Π°, ΠΈ Π½ΠΎΠ²ΠΎΠ΅ Π²ΠΎΡΠΏΠ°Π»Π΅Π½ΠΈΠ΅ Π½Π°Ρ ΠΎΠ΄ΠΈΡΡΡ Π½Π° ΠΌΠ΅ΡΡΠ΅ ΡΡΠ°ΡΠΎΠ³ΠΎ, ΡΠΎ ΡΡΠΎ ΡΠ΅ΡΠΈΠ΄ΠΈΠ²ΠΈΡΡΡΡΠ°Ρ ΡΠΎΡΠΌΠ° ΡΠΎΠΆΠΈΡΡΠΎΠ³ΠΎ Π²ΠΎΡΠΏΠ°Π»Π΅Π½ΠΈΡ.
Π‘ΠΈΠΌΠΏΡΠΎΠΌΡ ΠΎΡΠ»ΠΎΠΆΠ½Π΅Π½ΠΈΠΉ ΡΠΎΠΆΠΈ
ΠΡΠ΅Π½Ρ ΡΡΠ°ΡΠ΅Π»ΡΠ½ΠΎ Π½ΡΠΆΠ½ΠΎ Π²ΡΠΏΠΎΠ»Π½ΡΡΡ ΠΏΡΠ΅Π΄ΠΏΠΈΡΠ°Π½ΠΈΡ Π²ΡΠ°ΡΠ°,ΡΡΠΎΠ±Ρ ΠΈΠ·Π±Π΅ΠΆΠ°ΡΡ ΠΎΡΠ»ΠΎΠΆΠ½Π΅Π½ΠΈΠΉ ΡΠΎΠΆΠΈ. Π‘ΠΈΠΌΠΏΡΠΎΠΌΡ ΠΎΡΠ»ΠΎΠΆΠ½Π΅Π½ΠΈΠΉ ΡΠΎΠΆΠΈ ΠΎΠ±ΡΡΠ½ΠΎ Π½ΠΎΡΡΡ ΠΌΠ΅ΡΡΠ½ΡΠΉ Ρ Π°ΡΠ°ΠΊΡΠ΅Ρ:
1.
Π½Π΅ΠΊΡΠΎΠ·Ρ ΠΊΠΎΠΆΠΈ,
2.
Π°Π±ΡΡΠ΅ΡΡΡ,
3.
ΡΠ»Π΅Π³ΠΌΠΎΠ½Ρ,
4.
ΡΡΠΎΠΌΠ±ΠΎΡΠ»Π΅Π±ΠΈΡΡ,
5.
Π»ΠΈΠΌΡΠ°Π½Π³ΠΈΡΡ,
6.
ΠΏΠ΅ΡΠΈΠ°Π΄Π΅Π½ΠΈΡΡ.
ΠΠΈΠ°Π³Π½ΠΎΠ· «ΡΠΎΠΆΠ°» ΡΡΡΠ°Π½Π°Π²Π»ΠΈΠ²Π°ΡΡ Π½Π° ΠΎΡΠ½ΠΎΠ²Π°Π½ΠΈΠΈ ΠΊΠ»ΠΈΠ½ΠΈΡΠ΅ΡΠΊΠΎΠ³ΠΎ ΠΎΠ±ΡΠ»Π΅Π΄ΠΎΠ²Π°Π½ΠΈΡ : ΠΎΡΠΌΠΎΡΡ ,Π°Π½Π°Π»ΠΈΠ· ΠΊΡΠΎΠ²ΠΈ. Π ΠΊΡΠΎΠ²ΠΈ Π±ΠΎΠ»ΡΡΠΈΠ½ΡΡΠ²Π° Π±ΠΎΠ»ΡΠ½ΡΡ ΠΎΡΠΌΠ΅ΡΠ°ΡΡΡΡ ΠΏΠΎΠ²ΡΡΠ΅Π½Π½Π°Ρ Π‘ΠΠ.
ΠΠ΅Π΄ΠΈΠΊΠ°ΠΌΠ΅Π½ΡΠΎΠ·Π½Π°Ρ ΡΠ΅ΡΠ°ΠΏΠΈΡ ΡΠΎΠΆΠΈ
ΠΠΎΡΠΏΠΈΡΠ°Π»ΠΈΠ·ΠΈΡΡΡΡ Π±ΠΎΠ»ΡΠ½ΡΡ ΡΠΎΠ»ΡΠΊΠΎ Π² ΡΡΠΆΠ΅Π»ΡΡ ΡΠ»ΡΡΠ°ΡΡ . ΠΠ΅ΡΠ΅Π½ΠΈΠ΅ ΡΠΎΠΆΠΈ ΠΏΡΠΎΠΈΡΡ ΠΎΠ΄ΠΈΡ Π°ΠΌΠ±ΡΠ»Π°ΡΠΎΡΠ½ΠΎΠΌ ΡΠ΅ΠΆΠΈΠΌΠ΅, Π² ΡΠ»ΡΡΠ°Π΅ Π΅ΡΠ»ΠΈ Π±ΠΎΠ»ΡΠ½ΠΎΠΉ ΠΏΠΎΠΆΠΈΠ»ΠΎΠΉ, ΠΏΡΠΈ ΡΡΠΆΠ΅Π»ΡΡ Π·Π°Π±ΠΎΠ»Π΅Π²Π°Π½ΠΈΡΡ , ΠΊΠΎΡΠΎΡΡΠ΅ ΡΠΎΠΏΡΡΡΡΠ²ΡΡΡ, Π° ΡΠ°ΠΊΠΆΠ΅ ΠΏΡΠΈ ΡΠ°ΡΡΡΡ ΠΏΡΠΎΡΠ²Π»Π΅Π½ΠΈΡΡ ΡΠ΅ΡΠΈΠ΄ΠΈΠ²ΠΎΠ². Π ΠΏΠ΅ΡΠΈΠΎΠ΄ Π»ΠΈΡ ΠΎΡΠ°Π΄ΠΊΠΈ Π²ΡΠ°ΡΠΈ ΡΠ΅ΠΊΠΎΠΌΠ΅Π½Π΄ΡΡΡ ΠΏΡΠΈΠ½ΠΈΠΌΠ°ΡΡ ΠΌΠ½ΠΎΠ³ΠΎ ΠΏΠΈΡΡΡ, Π° ΡΠ°ΠΊΠΆΠ΅ ΠΏΡΠ΅ΠΏΠ°ΡΠ°ΡΡ, ΠΏΡΠ΅Π΄Π½Π°Π·Π½Π°ΡΠ΅Π½Π½ΡΠ΅ Π΄Π»Ρ ΠΏΠΎΠ½ΠΈΠΆΠ΅Π½ΠΈΡ ΡΠ΅ΠΌΠΏΠ΅ΡΠ°ΡΡΡΡ. ΠΡΠ»ΠΈΡΠ½ΠΎ Π²Π»ΠΈΡΡΡ Π½Π° ΡΠ»ΡΡΡΠ΅Π½ΠΈΠ΅ ΡΠ°ΠΌΠΎΡΡΠ²ΡΡΠ²ΠΈΡ ΠΏΡΠΈ Π·Π°Π±ΠΎΠ»Π΅Π²Π°Π½ΠΈΠΈ Π²ΠΈΡΠ°ΠΌΠΈΠ½Ρ. ΠΠ±Π»Π°ΡΡΡ, ΠΏΠΎΡΠ°ΠΆΠ΅Π½Π½ΡΡ Π±Π°ΠΊΡΠ΅ΡΠΈΡΠΌΠΈ, Ρ ΠΏΠ΅ΡΠΈΠΎΠ΄ΠΈΡΠ½ΠΎΡΡΡΡ ΠΎΠ±ΡΠ°Π±Π°ΡΡΠ²Π°ΡΡ Π°Π½ΡΠΈΡΠ΅ΠΏΡΠΈΡΠ΅ΡΠΊΠΈΠΌΠΈ ΡΡΠ΅Π΄ΡΡΠ²Π°ΠΌΠΈ, ΠΈ Π½Π°ΠΊΠ»Π°Π΄ΡΠ²Π°ΡΡ ΠΏΠΎΠ²ΡΠ·ΠΊΡ. ΠΡΠ½ΠΎΠ²Π½ΡΠΌ ΠΏΡΠΈ Π»Π΅ΡΠ΅Π½ΠΈΠΈ ΡΠΎΠΆΠΈ ΡΠ²Π»ΡΠ΅ΡΡΡ ΠΏΡΠΈΠ΅ΠΌ Π°Π½ΡΠΈΠ±ΠΈΠΎΡΠΈΠΊΠΎΠ². ΠΡΡΡ Π»Π΅ΡΠ΅Π½ΠΈΡ Π΄Π»ΠΈΡΡΡ ΠΎΡ ΡΠ΅ΠΌΠΈ Π΄ΠΎ Π΄Π΅ΡΡΡΠΈ Π΄Π½Π΅ΠΉ, Π΅ΡΠ»ΠΈ Π½Π΅Ρ ΠΎΡΠ»ΠΎΠΆΠ½Π΅Π½ΠΈΠΉ.
ΠΠ»Ρ Π»Π΅ΡΠ΅Π½ΠΈΡ ΡΠΎΠΆΠΈΡΡΠΎΠ³ΠΎ Π²ΠΎΡΠΏΠ°Π»Π΅Π½ΠΈΡ Π² Π΄ΠΎΠΌΠ°ΡΠ½ΠΈΡ ΡΡΠ»ΠΎΠ²ΠΈΡΡ ΠΈ Π½Π° Π΄ΠΎΠ³ΠΎΡΠΏΠΈΡΠ°Π»ΡΠ½ΠΎΠΌ ΡΡΠ°ΠΏΠ΅ Π½Π°Π·Π½Π°ΡΠ°ΡΡ Π² ΡΠ΅ΡΠ΅Π½ΠΈΠ΅ 7 β 10 Π΄Π½Π΅ΠΉ Π°Π½ΡΠΈΠ±ΠΈΠΎΡΠΈΠΊΠΈ Π² ΡΠ°Π±Π»Π΅ΡΠΊΠ°Ρ ΠΈ ΠΊΠ°ΠΏΡΡΠ»Π°Ρ : ΠΠ»Π΅ΡΠ΅ΡΡΠΈΠ½ ΠΏΠΎ 0,25 Π³ 4 β 6 ΡΠ°Π· Π² ΡΡΡΠΊΠΈ, ΠΠ΅ΡΠ°ΡΠΈΠΊΠ»ΠΈΠ½Π° Π³ΠΈΠ΄ΡΠΎΡ Π»ΠΎΡΠΈΠ΄ ΠΏΠΎ 0,3 Π³ 2 β 3 ΡΠ°Π·Π° Π² ΡΡΡΠΊΠΈ, ΠΡΠΈΡΡΠΎΠΌΠΈΡΠΈΠ½ ΠΈΠ»ΠΈ ΠΠ»Π΅Π°Π½Π΄ΠΎΠΌΠΈΡΠΈΠ½Π° ΡΠΎΡΡΠ°Ρ Π² ΡΡΡΠΎΡΠ½ΡΡ Π΄ΠΎΠ·Π°Ρ Π΄ΠΎ 2 Π³, ΠΠ°ΠΊΡΡΠΈΠΌ (ΠΠΈΡΠ΅ΠΏΡΠΎΠ»), Π‘ΡΠ»ΡΡΠ°ΡΠΎΠ½ β ΠΏΠΎ 2 ΡΠ°Π±Π»Π΅ΡΠΊΠΈ 2 ΡΠ°Π·Π° Π² Π΄Π΅Π½Ρ ΡΡΡΠΎΠΌ ΠΈ Π²Π΅ΡΠ΅ΡΠΎΠΌ ΠΏΠΎΡΠ»Π΅ Π΅Π΄Ρ. Π ΡΡΠ°ΡΠΈΠΎΠ½Π°ΡΠ΅ ΠΏΡΠΈ Π»Π΅ΡΠ΅Π½ΠΈΠΈ ΡΠΎΠΆΠΈ Π²Π½ΡΡΡΠΈΠΌΡΡΠ΅ΡΠ½ΠΎ Π²Π²ΠΎΠ΄ΡΡ ΠΠ΅Π½Π·ΠΈΠ»ΠΏΠ΅Π½ΠΈΡΠΈΠ»Π»ΠΈΠ½Π°. Π’Π°ΠΊΠΆΠ΅ Π»Π΅ΡΠ΅Π½ΠΈΠ΅ Π²ΠΊΠ»ΡΡΠ°Π΅Ρ Π½Π΅ΡΡΠ΅ΡΠΎΠΈΠ΄Π½ΡΠ΅ ΠΏΡΠΎΡΠΈΠ²ΠΎΠ²ΠΎΡΠΏΠ°Π»ΠΈΡΠ΅Π»ΡΠ½ΡΠ΅ ΠΏΡΠ΅ΠΏΠ°ΡΠ°ΡΡ, ΠΡΠΊΠΎΡΡΡΠΈΠ½, ΠΊΠΎΠΌΠΏΠ»Π΅ΠΊΡ Π²ΠΈΡΠ°ΠΌΠΈΠ½ΠΎΠ².
ΠΠ΅ΡΡΠ½ΠΎΠ΅ Π»Π΅ΡΠ΅Π½ΠΈΠ΅ Π±ΠΎΠ»Π΅Π·Π½ΠΈ ΠΏΡΠΎΠ²ΠΎΠ΄ΠΈΡΡΡ Π»ΠΈΡΡ ΠΏΡΠΈ Π΅Π΅ Π»ΠΎΠΊΠ°Π»ΠΈΠ·Π°ΡΠΈΠΈ Π½Π° ΠΊΠΎΠ½Π΅ΡΠ½ΠΎΡΡΡΡ . ΠΡΠ·ΡΡΠΈ Π½Π°Π΄ΡΠ΅Π·Π°ΡΡ Ρ ΠΎΠ΄Π½ΠΎΠ³ΠΎ ΠΈΠ· ΠΊΡΠ°Π΅Π² ΠΈ Π½Π° ΠΎΡΠ°Π³ Π²ΠΎΡΠΏΠ°Π»Π΅Π½ΠΈΡ Π½Π°ΠΊΠ»Π°Π΄ΡΠ²Π°ΡΡ ΠΏΠΎΠ²ΡΠ·ΠΊΠΈ Ρ ΡΠ°ΡΡΠ²ΠΎΡΠΎΠΌ Π€ΡΡΠ°ΡΠΈΠ»ΠΈΠ½Π° (1:5000), ΠΌΠ΅Π½ΡΡ ΠΈΡ Π½Π΅ΡΠΊΠΎΠ»ΡΠΊΠΎ ΡΠ°Π· Π² Π΄Π΅Π½Ρ. Π ΠΎΡΡΡΠΎΠΌ ΠΏΠ΅ΡΠΈΠΎΠ΄Π΅ ΡΠΎΠΆΠΈ Π² Π»Π΅ΡΠ΅Π½ΠΈΠΈ ΠΏΡΠΈΠΌΠ΅Π½ΡΡΡ ΡΠ°ΠΊΠΆΠ΅ ΡΠ»ΡΡΡΠ°ΡΠΈΠΎΠ»Π΅ΡΠΎΠ²ΠΎΠ΅ ΠΎΠ±Π»ΡΡΠ΅Π½ΠΈΠ΅ ΠΈ Π£ΠΠ§-ΡΠ΅ΡΠ°ΠΏΠΈΡ, Π° ΠΏΠΎΡΠ»Π΅ ΡΡΠΈΡ Π°Π½ΠΈΡ ΠΎΡΡΡΠΎΠ³ΠΎ Π²ΠΎΡΠΏΠ°Π»ΠΈΡΠ΅Π»ΡΠ½ΠΎΠ³ΠΎ ΠΏΡΠΎΡΠ΅ΡΡΠ° ΠΏΠΎΠ²ΡΠ·ΠΊΠΈ Ρ ΡΠ°Π·Π»ΠΈΡΠ½ΡΠΌΠΈ ΠΌΠ°Π·ΡΠΌΠΈ. ΠΠΎΡΠ»Π΅ Π½ΠΎΡΠΌΠ°Π»ΠΈΠ·Π°ΡΠΈΠΈ ΡΠ΅ΠΌΠΏΠ΅ΡΠ°ΡΡΡΡ ΡΠ΅Π»Π° Π±ΠΎΠ»ΡΠ½ΡΡ Π²ΡΠΏΠΈΡΡΠ²Π°ΡΡ ΡΠ΅ΡΠ΅Π· 7 Π΄Π½Π΅ΠΉ ΠΈ ΡΡΠ°Π²ΡΡ Π½Π° ΡΡΠ΅Ρ Π² ΠΊΠ°Π±ΠΈΠ½Π΅Ρ ΠΈΠ½ΡΠ΅ΠΊΡΠΈΠΎΠ½Π½ΡΡ Π±ΠΎΠ»Π΅Π·Π½Π΅ΠΉ Π½Π° 3 ΠΌΠ΅Ρ.
ΠΡΠ»ΠΈ ΠΏΡΠΎΠΈΡΡ ΠΎΠ΄ΠΈΡ ΡΠ΅ΡΠΈΠ΄ΠΈΠ², ΡΠΎ ΠΌΠ΅Π½ΡΠ΅ΡΡΡ Π³ΡΡΠΏΠΏΠ° ΠΏΡΠΈΠΌΠ΅Π½ΡΠ΅ΠΌΡΡ ΠΏΡΠ΅ΠΏΠ°ΡΠ°ΡΠΎΠ², Π΅ΡΠ»ΠΈ ΠΈΠ·Π½Π°ΡΠ°Π»ΡΠ½ΠΎ ΠΈΡΠΏΠΎΠ»ΡΠ·ΠΎΠ²Π°Π»ΡΡ ΠΏΠ΅Π½ΠΈΡΠΈΠ»Π»ΠΈΠ½ΠΎΠ²ΡΠ΅, ΡΠΎ Π΄Π»Ρ Π»Π΅ΡΠ΅Π½ΠΈΡ ΡΠΎΠΆΠΈ Π½Π°Π·Π½Π°ΡΠ°Π΅ΡΡΡ ΠΠΈΠ½ΠΊΠΎΠΌΠΈΡΠΈΠ½, Π° Π΄Π°Π»Π΅Π΅ ΠΎΡ ΠΏΠΎΠ»ΡΠ³ΠΎΠ΄Π° Π΄ΠΎ Π΄Π²ΡΡ Π»Π΅Ρ ΠΏΡΠΎΠΏΠΈΡΡΠ²Π°ΡΡ ΠΠΈΡΠΈΠ»Π»ΠΈΠ½5, Π Π΅ΡΠ°ΡΠΏΠ΅Π½ (ΡΠ°Π· Π² ΡΡΠΈ Π½Π΅Π΄Π΅Π»ΠΈ). Π₯ΠΎΡΠΎΡΠΈΠΌ Π·Π°ΠΆΠΈΠ²Π»ΡΡΡΠΈΠΌ ΡΠ²ΠΎΠΉΡΡΠ²ΠΎΠΌ ΠΎΠ±Π»Π°Π΄Π°ΡΡ ΠΠ΅ΡΠΌΠ°Π·ΠΈΠ½ ΠΈ ΠΠ΅ΠΏΠ°Π½ΡΠ΅Π½.
ΠΠ°ΠΊ Π»Π΅ΡΠΈΡΡ ΡΠΎΠΆΡ Π½Π°ΡΠΎΠ΄Π½ΡΠΌΠΈ ΡΡΠ΅Π΄ΡΡΠ²Π°ΠΌΠΈ Π² Π΄ΠΎΠΌΠ°ΡΠ½ΠΈΡ ΡΡΠ»ΠΎΠ²ΠΈΡΡ ?
1.
ΠΠ°Π±ΠΎΠ»Π΅Π²Π°Π½ΠΈΠ΅ ΡΠΎΠΆΠ° Π½Π°ΡΠΈΠ½Π°Π΅ΡΡΡ ΡΠΎ Π·Π½Π°ΡΠΈΡΠ΅Π»ΡΠ½ΠΎΠ³ΠΎ ΠΏΠΎΠ²ΡΡΠ΅Π½ΠΈΡ ΡΠ΅ΠΌΠΏΠ΅ΡΠ°ΡΡΡΡ, ΠΏΠΎΡΡΠΎΠΌΡ Π½Π΅ ΠΎΠ±ΠΎΠΉΡΠΈΡΡ Π±Π΅Π· Π²ΡΠ·ΠΎΠ²Π° Π½Π° Π΄ΠΎΠΌ Π΄ΠΎΠΊΡΠΎΡΠ°, ΠΊΠΎΡΠΎΡΡΠΉ Π½Π°Π·Π½Π°ΡΠΈΡ Π»Π΅ΡΠ΅Π½ΠΈΠ΅ Π ΠΏΠ΅ΡΠ²ΡΡ ΠΎΡΠ΅ΡΠ΅Π΄Ρ ΠΏΡΠΎΠΏΠΈΡΠ΅Ρ 5-7 Π΄Π½Π΅Π²Π½ΡΠΉ ΠΊΡΡΡ Π»Π΅ΡΠ΅Π½ΠΈΡ Π°Π½ΡΠΈΠ±ΠΈΠΎΡΠΈΠΊΠ°ΠΌΠΈ (ΠΡΠΈΡΡΠΎΠΌΠΈΡΠΈΠ½, ΠΠ΅Π½ΠΈΡΠΈΠ»Π»ΠΈΠ½).
2.
ΠΠ»Ρ ΡΠ½ΡΡΠΈΡ ΡΠΈΠ»ΡΠ½ΠΎΠ³ΠΎ Π·ΡΠ΄Π°, ΡΠΌΠ°Π·ΡΠ²Π°ΠΉΡΠ΅ ΡΡΠΈΡΠ΅ΠΌΡ ΠΊΠ°ΠΌΡΠ°ΡΠ½ΡΠΌ ΡΠΏΠΈΡΡΠΎΠΌ, ΠΌΠΎΠΆΠ½ΠΎ ΡΠΎΠΊΠΎΠΌ ΠΊΠ°Π»Π°Π½Ρ ΠΎΡ ΠΈΠ»ΠΈ ΠΏΠΎΠ΄ΠΎΡΠΎΠΆΠ½ΠΈΠΊΠ°.
3.
ΠΡΠΈ ΡΠΈΠ»ΡΠ½ΡΡ Π±ΠΎΠ»ΡΡ Π΄ΠΎΠ±Π°Π²ΡΡΠ΅ ΠΊ ΡΠΎΠΊΡ ΠΊΠ°Π»Π°Π½Ρ ΠΎΡ ΠΈΠ»ΠΈ ΠΏΠΎΠ΄ΠΎΡΠΎΠΆΠ½ΠΈΠΊΠ° 0,5% ΡΠ°ΡΡΠ²ΠΎΡ ΠΠΎΠ²ΠΎΠΊΠ°ΠΈΠ½Π° ΠΈΠ»ΠΈ «ΠΠΈΠΌΠ΅ΠΊΡΠΈΠ΄Π°» Π² ΠΏΡΠΎΠΏΠΎΡΡΠΈΠΈ 1:1.
4.
ΠΡΠΈ Π²ΡΠ΄Π΅Π»Π΅Π½ΠΈΠΈ Π³Π½ΠΎΡ ΠΈΡΠΏΠΎΠ»ΡΠ·ΡΠΉΡΠ΅ ΠΌΠ°ΡΠ»Π΅Π²ΠΎ-Π²Π°Π·Π΅Π»ΠΈΠ½ΠΎΠ²ΡΠ΅ ΠΏΠΎΠ²ΡΠ·ΠΊΠΈ Ρ «Π‘ΠΎΠ»ΠΊΠΎΡΠ΅ΡΠΈΠ»ΠΎΠΌ».
Π Π΅ΡΠ΅ΠΏΡΡ Π½Π°ΡΠΎΠ΄Π½ΡΡ ΡΡΠ΅Π΄ΡΡΠ² Π΄Π»Ρ Π»Π΅ΡΠ΅Π½ΠΈΡ ΡΠΎΠΆΠΈ
Π§ΡΠΎΠ±Ρ Π²Π°Ρ Π½Π΅ Π±Π΅ΡΠΏΠΎΠΊΠΎΠΈΠ»Π° ΡΠΎΠΆΠ°, Π»Π΅ΡΠ΅Π½ΠΈΠ΅ Π½Π°ΡΠΎΠ΄Π½ΡΠΌΠΈ ΡΡΠ΅Π΄ΡΡΠ²Π°ΠΌΠΈ β ΠΎΠ΄ΠΈΠ½ ΠΈΠ· ΡΠ°ΠΌΡΡ Π»ΡΡΡΠΈΡ Π²Π°ΡΠΈΠ°Π½ΡΠΎΠ², ΠΏΠΎΠΌΠΎΠ³Π°ΡΡΠΈΡ ΠΈΠ·Π±Π°Π²ΠΈΡΡΡΡ ΠΎΡ ΡΡΠΎΠΉ Π½Π΅ΠΏΡΠΈΡΡΠ½ΠΎΠΉ Π±ΠΎΠ»Π΅Π·Π½ΠΈ. ΠΠ»Ρ Π²Π°Ρ β Π½Π΅ΡΠΊΠΎΠ»ΡΠΊΠΎ, ΠΏΡΠΎΠ²Π΅ΡΠ΅Π½Π½ΡΡ Π³ΠΎΠ΄Π°ΠΌΠΈ ΡΠΏΠΎΡΠΎΠ±ΠΎΠ² Π»Π΅ΡΠ΅Π½ΠΈΡ ΡΠΎΠΆΠΈ:
1.
Π‘ΠΏΠΎΡΠΎΠ± ΠΏΠ΅ΡΠ²ΡΠΉ:
Π ΡΡΠΎΡΡΠ΅ΠΉ Π²ΠΎΠ΄Π΅ (Π»ΡΡΡΠ΅ Π²ΡΠ΅Π³ΠΎ Π² ΠΎΠ·Π΅ΡΠ΅ ΠΈΠ»ΠΈ ΡΡΠ°Π²ΠΊΠ΅) Π²Π΅ΡΠ½ΠΎΠΉ Π½Π΅ΠΎΠ±Ρ ΠΎΠ΄ΠΈΠΌΠΎ ΡΠΎΠ±ΡΠ°ΡΡ Π»ΡΠ³ΡΡΠ°ΡΡΡ ΠΈΠΊΡΡ. ΠΡ ΡΠ°ΡΠΊΠ»Π°Π΄ΡΠ²Π°ΡΡ ΡΠΎΠ½ΠΊΠΈΠΌ ΡΠ»ΠΎΠ΅ΠΌ Π½Π° ΡΡΡΠΏΠΎΡΠΊΠ΅ ΠΈΠ»ΠΈ ΠΆΠ΅ ΠΌΠ°ΡΠ»Π΅ ΠΈ Π²ΡΡΡΡΠΈΠ²Π°ΡΡ Π½Π° ΡΠΎΠ»Π½ΡΠ΅. ΠΠΊΡΡ ΡΠ°Π·ΠΌΠ°ΡΠΈΠ²Π°ΡΡ Π² ΠΊΠΈΠΏΡΡΡΠ½ΠΎΠΉ Π²ΠΎΠ΄Π΅ ΠΈ Π½Π°Π½ΠΎΡΡΡ Π½Π°ΡΠΎΠ΄Π½ΠΎΠ΅ ΡΡΠ΅Π΄ΡΡΠ²ΠΎ Π½Π° ΡΠΈΡΡΡΡ, Π»ΡΡΡΠ΅ Π²ΡΠ΅Π³ΠΎ Π»ΡΠ½ΡΠ½ΡΡ ΠΏΠΎΠ²ΡΠ·ΠΊΡ. ΠΠΎΠΌΠΏΡΠ΅ΡΡ ΠΏΡΠΈΠ²ΡΠ·ΡΠ²Π°ΡΡ ΠΊ ΠΌΠ΅ΡΡΡ ΠΏΠΎΡΠ°ΠΆΠ΅Π½ΠΈΡ ΠΊΠΎΠΆΠΈ. ΠΠ±ΡΡΠ½ΠΎ Π΄Π»Ρ ΠΏΠΎΠ»Π½ΠΎΠ³ΠΎ ΠΈΠ·Π»Π΅ΡΠ΅Π½ΠΈΡ ΡΠΎΠΆΠΈ Π½Π΅ΠΎΠ±Ρ ΠΎΠ΄ΠΈΠΌΠΎ ΠΎΡ ΡΡΡΡ Π΄ΠΎ ΠΏΡΡΠΈ ΡΠ°ΠΊΠΈΡ ΠΏΡΠΎΡΠ΅Π΄ΡΡ.
2.
Π‘ΠΏΠΎΡΠΎΠ± Π²ΡΠΎΡΠΎΠΉ.
ΠΡΠ΅Π½Ρ ΡΡΡΠ΅ΠΊΡΠΈΠ²Π½ΡΠΌ ΡΠ²Π»ΡΠ΅ΡΡΡ ΡΠ°ΠΊΠΆΠ΅ Π»Π΅ΡΠ΅Π½ΠΈΠ΅ ΡΠΎΠΆΠΈ Π΄ΠΎΠΌΠ°ΡΠ½ΠΈΠΌ ΡΠ²ΠΎΡΠΎΠ³ΠΎΠΌ. ΠΠ° ΠΏΠΎΡΠ°ΠΆΡΠ½Π½ΡΡ ΠΊΠΎΠ½Π΅ΡΠ½ΠΎΡΡΡ ΡΠΎΠ»ΡΡΡΠΌ ΡΠ»ΠΎΠ΅ΠΌ Π½Π°Π½ΠΎΡΠΈΡΡΡ ΡΠ²ΠΎΡΠΎΠ³, ΠΊΠΎΠ³Π΄Π° ΠΎΠ½ Π½Π°ΡΠ½ΡΡ Π²ΡΡΡΡ Π°ΡΡ, Π½Π΅ΠΎΠ±Ρ ΠΎΠ΄ΠΈΠΌΠΎ Π·Π°ΠΌΠ΅Π½ΠΈΡΡ Π΅Π³ΠΎ Π½Π° ΡΠ²Π΅ΠΆΠΈΠΉ.
3.
Π‘ΠΏΠΎΡΠΎΠ± ΡΡΠ΅ΡΠΈΠΉ.
ΠΡΠ»ΠΈ Π±ΡΠ°ΡΡ ΡΡΠ°Π²Ρ, ΠΊΠΎΡΠΎΡΡΠ΅ ΡΠΈΡΠΎΠΊΠΎ ΠΈΡΠΏΠΎΠ»ΡΠ·ΡΡΡΡΡ Π² ΠΊΠ°ΡΠ΅ΡΡΠ²Π΅ Π»Π΅ΡΠ΅Π±Π½ΡΡ ΡΡΠ΅Π΄ΡΡΠ² Π½Π°ΡΠΎΠ΄ΠΎΠΌ, ΡΠΎ Π»ΡΡΡΠ΅ Π²ΡΠ΅Π³ΠΎ ΡΠΏΡΠ°Π²ΠΈΡΡΡ Ρ Π·Π°Π±ΠΎΠ»Π΅Π²Π°Π½ΠΈΠ΅ΠΌ ΡΠΎΠΆΠΈ ΠΏΠΎΠ΄ΠΎΡΠΎΠΆΠ½ΠΈΠΊ. ΠΠ³ΠΎ Π»ΠΈΡΡΡΡ Π½Π΅ΠΎΠ±Ρ ΠΎΠ΄ΠΈΠΌΠΎ ΠΌΠ΅Π»ΠΊΠΎ ΠΏΠΎΡΠ΅Π·Π°ΡΡ, ΠΏΠΎΡΡΠΏΠ°ΡΡ ΠΌΠ΅Π»ΠΎΠΌ ΠΈ ΠΏΡΠΈΠ²ΡΠ·Π°ΡΡ ΠΊ Π²ΠΎΡΠΏΠ°Π»ΡΠ½Π½ΠΎΠΉ ΠΊΠΎΠΆΠ΅.
4.
Π‘ΠΏΠΎΡΠΎΠ± ΡΠ΅ΡΠ²ΡΡΡΡΠΉ.
ΠΠ΅ΠΏΠ»ΠΎΡ ΠΈΠΌ ΡΠΏΠΎΡΠΎΠ±ΠΎΠΌ ΡΠ²Π»ΡΠ΅ΡΡΡ ΡΠ°ΠΊΠΆΠ΅ ΠΌΠ°Π·Ρ, ΡΠ΄Π΅Π»Π°Π½Π½Π°Ρ ΠΈΠ· ΡΠΎΠΊΠ° ΡΠΎΠΌΠ°ΡΠΊΠΈ ΠΈ ΡΡΡΡΡΠ΅Π»ΠΈΡΡΠ½ΠΈΠΊΠ°. ΠΡΠ΅ΠΆΠ΄Π΅ Π²ΡΠ΅Π³ΠΎ, Π½Π΅ΠΎΠ±Ρ ΠΎΠ΄ΠΈΠΌΠΎ ΠΎΡΠΆΠ°ΡΡ ΡΠΎΠΊ ΠΈΠ· ΡΡΠΈΡ Π΄Π²ΡΡ ΡΠ°ΡΡΠ΅Π½ΠΈΠΉ, ΠΏΠΎΡΠΎΠΌ ΡΠΌΠ΅ΡΠ°ΡΡ Π΅Π³ΠΎ ΡΠΎ ΡΠ»ΠΈΠ²ΠΎΡΠ½ΡΠΌ ΠΌΠ°ΡΠ»ΠΎΠΌ. ΠΠΎΠ»ΡΡΠ΅Π½Π½ΠΎΠΉ ΡΠΌΠ΅ΡΡΡ ΠΌΠ°Π·Π°ΡΡ Π±ΠΎΠ»ΡΠ½ΠΎΠ΅ ΠΌΠ΅ΡΡΠΎ Π΄ΠΎ ΠΏΠΎΠ»Π½ΠΎΠ³ΠΎ Π·Π°ΠΆΠΈΠ²Π»Π΅Π½ΠΈΡ.
5.
Π‘ΠΏΠΎΡΠΎΠ± ΠΏΡΡΡΠΉ.
ΠΠΈΡΡΡΡ Π»ΠΎΠΏΡΡ Π° β Π΅ΡΡ ΠΎΠ΄Π½ΠΎ Π½Π°ΡΠΎΠ΄Π½ΠΎΠ΅ ΡΡΠ΅Π΄ΡΡΠ²ΠΎ, ΠΊΠΎΡΠΎΡΠΎΠ΅ ΠΏΠΎΠΌΠΎΠΆΠ΅Ρ Π²Π°ΠΌ ΠΈΠ·Π±Π°Π²ΠΈΡΡΡΡ ΠΎΡ ΡΠΎΠΆΠΈ. ΠΠ°ΡΠ²Π°Π½Π½ΡΠ΅ Π»ΠΈΡΡΡΡ Π»ΠΎΠΏΡΡ Π° ΠΎΡΠΏΠ°ΡΠΈΠ²Π°ΡΡ ΠΊΠΈΠΏΡΡΠΊΠΎΠΌ, ΠΏΠΎΡΠΎΠΌ Π½Π°ΠΌΠ°Π·ΡΠ²Π°ΡΡ ΡΠ»ΠΈΠ²ΠΎΡΠ½ΡΠΌ ΠΌΠ°ΡΠ»ΠΎΠΌ ΠΈΠ»ΠΈ ΠΆΠ΅ ΡΠΌΠ΅ΡΠ°Π½ΠΎΠΉ ΠΈ ΠΏΡΠΈΠ²ΡΠ·ΡΠ²Π°ΡΡ ΠΊ ΠΏΠΎΡΠ°ΠΆΡΠ½Π½ΠΎΠΉ ΠΊΠΎΠ½Π΅ΡΠ½ΠΎΡΡΠΈ.
6.
Π‘ΠΏΠΎΡΠΎΠ± ΡΠ΅ΡΡΠΎΠΉ.
Π ΠΆΠ°Π½Π°Ρ ΠΌΡΠΊΠ° ΡΠ°ΠΊΠΆΠ΅ Π΄ΠΎΡΡΠ°ΡΠΎΡΠ½ΠΎ Ρ ΠΎΡΠΎΡΠ° ΠΏΡΠΈ Π»Π΅ΡΠ΅Π½ΠΈΠΈ ΡΠΎΠΆΠΈ Π² Π΄ΠΎΠΌΠ°ΡΠ½ΠΈΡ ΡΡΠ»ΠΎΠ²ΠΈΡΡ . ΠΡ Π½Π΅ΠΎΠ±Ρ ΠΎΠ΄ΠΈΠΌΠΎ ΠΏΡΠΎΡΠ΅ΡΡΡ, Π° ΠΏΠΎΡΠ»Π΅ ΠΏΠΎΡΡΠΏΠ°ΡΡ Π½Π° Π±ΠΎΠ»ΡΠ½ΠΎΠ΅ ΠΌΠ΅ΡΡΠΎ ΠΈ ΠΎΠ±Π΅ΡΠ½ΡΡΡ Π±ΡΠΌΠ°Π³ΠΎΠΉ. ΠΠ°Π²Π΅ΡΡ Π½ΡΠΆΠ½ΠΎ ΠΏΡΠΈΠ²ΡΠ·Π°ΡΡ ΡΠΈΡΡΡΡ ΠΏΠΎΠ²ΡΠ·ΠΊΡ. Π’Π°ΠΊΠΈ ΠΊΠΎΠΌΠΏΡΠ΅ΡΡΡ ΡΡΠ΅Π±ΡΡΡ Π·Π°ΠΌΠ΅Π½Ρ ΠΊΠ°ΠΆΠ΄ΡΠΉ Π΄Π΅Π½Ρ.
7.
Π‘ΠΏΠΎΡΠΎΠ± ΡΠ΅Π΄ΡΠΌΠΎΠΉ.
ΠΡΠΈΠ½ΠΈΠΌΠ°ΠΉΡΠ΅ ΡΠΏΠΈΡΡΠΎΠ²ΡΠΉ ΠΈΠ»ΠΈ ΠΌΠ°ΡΠ»ΡΠ½ΡΠΉ ΡΠ°ΡΡΠ²ΠΎΡ «Π₯Π»ΠΎΡΠΎΡΠΈΠ»Π»ΠΈΠΏΡΠ°» ΠΏΠΎ 25 ΠΊΠ°ΠΏΠ΅Π»Ρ, ΡΠ°ΡΡΠ²ΠΎΡΠ΅Π½Π½ΡΡ Π² ΡΡΠΎΠ»ΠΎΠ²ΠΎΠΉ Π»ΠΎΠΆΠΊΠ΅ Π²ΠΎΠ΄Ρ, 3 ΡΠ°Π·Π° Π² Π΄Π΅Π½Ρ Π² ΡΠ΅ΡΠ΅Π½ΠΈΠ΅ 10 Π΄Π½Π΅ΠΉ.
8.
Π‘ΠΏΠΎΡΠΎΠ± Π²ΠΎΡΡΠΌΠΎΠΉ.
Π’Π°ΠΊΠΆΠ΅ ΡΡΡΠ΅ΠΊΡΠΈΠ²Π΅Π½ Π² Π»Π΅ΡΠ΅Π½ΠΈΠΈ ΡΠΎΠΆΠΈ «Π ΠΎΡΠΎΠΊΠ°Π½», ΠΈΡΠΏΠΎΠ»ΡΠ·ΡΠΉΡΠ΅ Π΅Π³ΠΎ Π½Π°ΡΡΠΆΠ½ΠΎ Π΄Π»Ρ ΠΏΡΠΈΠΌΠΎΡΠ΅ΠΊ Π½Π° ΠΏΡΠΎΠ±Π»Π΅ΠΌΠ½ΡΠ΅ ΡΡΠ°ΡΡΠΊΠΈ ΠΊΠΎΠΆΠΈ, ΡΠΌΠ΅ΡΠΈΠ²Π°Ρ ΠΏΠΎΠΏΠΎΠ»Π°ΠΌ Ρ ΡΠ±Π»ΠΎΡΠ½ΡΠΌ ΡΠΊΡΡΡΠΎΠΌ.
9.
Π‘ΠΏΠΎΡΠΎΠ± Π΄Π΅Π²ΡΡΡΠΉ.
Π§ΡΠΎΠ±Ρ Π»Π΅ΡΠΈΡΡ ΡΠΎΠΆΡ Π² Π΄ΠΎΠΌΠ°ΡΠ½ΠΈΡ ΡΡΠ»ΠΎΠ²ΠΈΡΡ , ΠΌΠΎΠΆΠ½ΠΎ ΠΈΡΠΏΠΎΠ»ΡΠ·ΠΎΠ²Π°ΡΡ ΡΠ°ΡΡΠΈΡΠ΅Π»ΡΠ½ΡΠ΅ ΠΌΠ°Π·ΠΈ. ΠΠ»Ρ ΠΏΡΠΈΠ³ΠΎΡΠΎΠ²Π»Π΅Π½ΠΈΡ Π²ΠΎΠ·ΡΠΌΠΈΡΠ΅ ΠΊΠ°Π»Π΅Π½Π΄ΡΠ»Ρ ΠΈΠ»ΠΈ ΡΠΎΠΌΠ°ΡΠΊΡ, ΠΌΠΎΠΆΠ½ΠΎ Π»ΠΈΡΡΡΡ ΠΊΠ°Π»Π°Π½Ρ ΠΎΡ. ΠΠ°Π»Π΅ΠΉΡΠ΅ Π»ΡΠ±ΠΎΠ΅ ΠΈΠ· ΠΏΠ΅ΡΠ΅ΡΠΈΡΠ»Π΅Π½Π½ΡΡ ΡΠ°ΡΡΠΈΡΠ΅Π»ΡΠ½ΠΎΠ΅ ΡΡΡΡΠ΅ ΠΌΠ°ΡΠ»ΠΎΠΌ (ΠΈΠ΄Π΅Π°Π»ΡΠ½ΠΎ — ΠΎΠ»ΠΈΠ²ΠΊΠΎΠ²ΡΠΌ) Π² ΠΏΡΠΎΠΏΠΎΡΡΠΈΠΈ 1:1 ΠΈ, ΠΏΠΎΡΡΠ°Π²ΡΡΠ΅ Π½Π° ΠΌΠ΅Π΄Π»Π΅Π½Π½ΠΎ ΠΊΠΈΠΏΡΡΡΡ Π²ΠΎΠ΄ΡΠ½ΡΡ Π±Π°Π½Ρ, Π²Π°ΡΠΈΡΠ΅ 2-3 ΡΠ°ΡΠ°. ΠΠ°ΡΡΠΎΡΠ² 48 ΡΠ°ΡΠΎΠ², ΠΏΡΠΎΡΠΈΠ»ΡΡΡΡΠΉΡΠ΅. Π‘ΠΌΠ°Π·ΡΠ²Π°ΠΉΡΠ΅ ΠΏΠΎΠ»ΡΡΠ΅Π½Π½ΡΠΌ Π½Π°ΡΠΎΠ΄Π½ΡΠΌ ΡΡΠ΅Π΄ΡΡΠ²ΠΎΠΌ 2-4 ΡΠ°Π·Π° Π² Π΄Π΅Π½Ρ ΡΠ°Π½Ρ.
ΠΠΎΠΏΡΠΎΠ±ΡΠΉΡΠ΅ ΡΠ΅ ΡΡΠ΅Π΄ΡΡΠ²Π°, ΡΡΠΎ ΡΠΊΠ°Π·Π°Π½Ρ Π² ΡΡΠ°ΡΡΠ΅, ΠΈ ΡΠΎΠΆΠ° Π½ΠΈΠΊΠΎΠ³Π΄Π° Π±ΠΎΠ»ΡΡΠ΅ Π½Π΅ ΠΏΡΠΈΡΠΈΠ½ΠΈΡ Π²Π°ΠΌ Π½Π΅ΡΠ΄ΠΎΠ±ΡΡΠ².
ΠΡΠΈΡΠΈΠ½Ρ ΠΈ ΠΏΡΠΎΡΠΈΠ»Π°ΠΊΡΠΈΠΊΠ° ΡΠΎΠΆΠΈΡΡΠΎΠ³ΠΎ Π²ΠΎΡΠΏΠ°Π»Π΅Π½ΠΈΡ
ΠΠ°ΡΠ°ΡΡΡΡ ΡΡΡΠ΅ΠΏΡΠΎΠΊΠΎΠΊΠΊΠΈ Π½Π°Ρ ΠΎΠ΄ΡΡΡΡ Π½Π° ΠΏΠΎΠ²Π΅ΡΡ Π½ΠΎΡΡΠΈ ΠΊΠΎΠΆΠΈ Π·Π΄ΠΎΡΠΎΠ²ΡΡ Π»ΡΠ΄Π΅ΠΉ, Π½ΠΎ ΠΏΡΠΈ Π½Π°ΡΡΡΠ΅Π½ΠΈΠΈ ΡΠ΅Π»ΠΎΡΡΠ½ΠΎΡΡΠΈ ΠΊΠΎΠΆΠΈ, ΡΠ°ΠΊΠΈΡ ΠΊΠ°ΠΊ ΠΎΠΏΡΠ΅Π»ΠΎΡΡΠΈ, ΡΡΠ°Π΄ΠΈΠ½Ρ, ΡΠ°ΡΡΠ΅ΡΡ, ΡΡΠ΅ΡΠΈΠ½Ρ, ΡΠ°ΡΠ°ΠΏΠΈΠ½Ρ, ΠΎΠ½ΠΈ ΠΏΠΎΠΏΠ°Π΄Π°ΡΡ Π² Π±Π»Π°Π³ΠΎΠΏΠΎΠ»ΡΡΠ½ΡΡ Π΄Π»Ρ ΠΈΡ ΠΎΠ±ΠΈΡΠ°Π½ΠΈΡ ΡΡΠ΅Π΄Ρ. ΠΠ°ΠΈΠ±ΠΎΠ»Π΅Π΅ ΡΠ°ΡΠΏΡΠΎΡΡΡΠ°Π½Π΅Π½Π½ΡΠΌΠΈ ΠΌΠ΅ΡΡΠ°ΠΌΠΈ ΠΏΠΎΡΠ°ΠΆΠ΅Π½ΠΈΡ ΡΠΎΠΆΠ΅ΠΉ ΠΌΠΎΠ³ΡΡ Π±ΡΡΡ Π½ΠΎΠ³ΠΈ, ΡΠ΅ΠΆΠ΅ ΡΡΠΊΠΈ, Π»ΠΈΡΠΎ ΠΈ Π³ΡΡΠ΄Ρ. ΠΠΎΠ΄Π²Π΅ΡΠΆΠ΅Π½Ρ ΡΠΎΠΆΠ΅ ΡΠ°ΡΠ΅ Π²ΡΠ΅Π³ΠΎ ΠΆΠ΅Π½ΡΠΈΠ½Ρ, ΠΈ Π»ΡΠ΄ΠΈ Π±ΠΎΠ»Π΅Π΅ ΠΏΠΎΠΆΠΈΠ»ΠΎΠ³ΠΎ Π²ΠΎΠ·ΡΠ°ΡΡΠ°.
Π€Π°ΠΊΡΠΎΡΠ°ΠΌΠΈ ΡΠΈΡΠΊΠ° ΡΠ²Π»ΡΡΡΡΡ:
1.
Π½Π°ΡΡΡΠ΅Π½ΠΈΡ Π»ΠΈΠΌΡΠΎΠΎΠ±ΡΠ°ΡΠ΅Π½ΠΈΡ,
3.
Ρ ΡΠΎΠ½ΠΈΡΠ΅ΡΠΊΠ°Ρ Π²Π΅Π½ΠΎΠ·Π½Π°Ρ Π½Π΅Π΄ΠΎΡΡΠ°ΡΠΎΡΠ½ΠΎΡΡΡ,
4.
Π³ΡΠΈΠ±ΠΊΠΎΠ²ΡΠ΅ Π·Π°Π±ΠΎΠ»Π΅Π²Π°Π½ΠΈΡ ΠΊΠΎΠΆΠΈ. ΠΠ»Ρ ΡΠΈΠΌΠΏΡΠΎΠΌΠΎΠ² ΡΠΎΠΆΠΈ ΡΠΈΠΏΠΈΡΠ½Π° Π»Π΅ΡΠ½Π΅-ΠΎΡΠ΅Π½Π½ΡΡ ΡΠ΅Π·ΠΎΠ½Π½ΠΎΡΡΡ.
ΠΡΠΎΡΠΈΠ»Π°ΠΊΡΠΈΠΊΠ° ΡΠΎΠΆΠΈ
ΠΡΠΎΡΠΈΠ»Π°ΠΊΡΠΈΠΊΠ° Π·Π°Π±ΠΎΠ»Π΅Π²Π°Π½ΠΈΡ Π·Π°ΠΊΠ»ΡΡΠ°Π΅ΡΡΡ Π² ΡΠΎΠ±Π»ΡΠ΄Π΅Π½ΠΈΠΈ Π»ΠΈΡΠ½ΠΎΠΉ Π³ΠΈΠ³ΠΈΠ΅Π½Ρ, ΠΏΡΠ΅Π΄ΡΠΏΡΠ΅ΠΆΠ΄Π΅Π½ΠΈΠΈ ΠΌΠΈΠΊΡΠΎΡΡΠ°Π²ΠΌ, ΠΎΠ±ΡΠ°Π±ΠΎΡΠΊΠ΅ ΡΡΠ°Π²ΠΌ Π°Π½ΡΠΈΡΠ΅ΠΏΡΠΈΠΊΠ°ΠΌΠΈ (Π½Π°ΠΏΡΠΈΠΌΠ΅Ρ, 5% ΡΠΏΠΈΡΡΠΎΠ²ΡΠΌ ΡΠ°ΡΡΠ²ΠΎΡΠΎΠΌ ΠΉΠΎΠ΄Π°, ΡΠ°ΡΡΠ²ΠΎΡΠΎΠΌ Π±ΡΠΈΠ»Π»ΠΈΠ°Π½ΡΠΎΠ²ΠΎΠ³ΠΎ Π·Π΅Π»Π΅Π½ΠΎΠ³ΠΎ), Π’Π°ΠΊΠΆΠ΅ ΠΏΡΠΎΡΠΈΠ»Π°ΠΊΡΠΈΠΊΠ° ΡΠΎΠΆΠΈ ΠΏΡΠ΅Π΄ΡΡΠΌΠ°ΡΡΠΈΠ²Π°Π΅Ρ Π»Π΅ΡΠ΅Π½ΠΈΠ΅ Π³ΡΠΈΠ±ΠΊΠΎΠ²ΡΡ ΠΏΠΎΡΠ°ΠΆΠ΅Π½ΠΈΠΉ ΠΊΠΎΠΆΠΈ, Π»ΠΈΠΌΡΠΎΠ²Π΅Π½ΠΎΠ·Π½ΠΎΠΉ Π½Π΅Π΄ΠΎΡΡΠ°ΡΠΎΡΠ½ΠΎΡΡΠΈ.
Π‘ΠΎΠ²Π΅ΡΡ ΠΏΠΎ ΠΏΡΠΎΡΠΈΠ»Π°ΠΊΡΠΈΠΊΠ΅ ΡΠΎΠΆΠΈ:
ΠΠ»Ρ ΡΠΎΠ³ΠΎ, ΡΡΠΎΠ±Ρ ΠΈΠ·Π±Π΅ΠΆΠ°ΡΡ Π·Π°ΡΠ°ΠΆΠ΅Π½ΠΈΡ Π½Π΅ΠΎΠ±Ρ ΠΎΠ΄ΠΈΠΌΠΎ ΠΏΡΠΈΠ΄Π΅ΡΠΆΠΈΠ²Π°ΡΡΡΡ Π½Π΅ΠΊΠΎΡΠΎΡΡΡ ΠΏΡΠ°Π²ΠΈΠ»:
1.
Π½Π΅ΠΎΠ±Ρ ΠΎΠ΄ΠΈΠΌΠΎ ΡΠΎΠ±Π»ΡΠ΄Π°ΡΡ ΡΠ°Π½ΠΈΡΠ°ΡΠ½ΠΎ-Π³ΠΈΠ³ΠΈΠ΅Π½ΠΈΡΠ΅ΡΠΊΠΈΠ΅ Π½ΠΎΡΠΌΡ Π² ΠΏΠ΅ΡΠ΅Π²ΡΠ·ΠΎΡΠ½ΡΡ , Π² ΠΠΠ£;
2.
ΡΠ²ΠΎΠ΅Π²ΡΠ΅ΠΌΠ΅Π½Π½ΠΎΠ΅ Π»Π΅ΡΠ΅Π½ΠΈΠ΅ ΡΠ΅Ρ Π·Π°Π±ΠΎΠ»Π΅Π²Π°Π½ΠΈΠΉ, ΠΊΠΎΡΠΎΡΡΠ΅ Π²ΡΠ·Π²Π°Π½Ρ ΡΡΡΠ΅ΠΏΡΠΎΠΊΠΎΠΊΠΊΠ°ΠΌΠΈ (ΠΊΠ°ΡΠΈΠ΅Ρ, ΡΠΎΠ½Π·ΠΈΠ»Π»ΠΈΡ) ;
3.
ΠΏΡΠΈ ΠΏΠΎΡΠ°ΠΆΠ΅Π½ΠΈΠΈ ΠΊΠΎΠΆΠΈ, ΠΈ Π½Π°ΡΡΡΠ΅Π½ΠΈΠΈ Π΅Π΅ ΡΠ΅Π»ΠΎΡΡΠ½ΠΎΡΡΠΈ Π½Π΅ΠΎΠ±Ρ ΠΎΠ΄ΠΈΠΌΠΎ ΠΎΠ±ΡΠ°Π±ΠΎΡΠ°ΡΡ ΡΠΏΠ΅ΡΠΈΠ°Π»ΡΠ½ΡΠΌΠΈ Π°Π½ΡΠΈΠ±Π°ΠΊΡΠ΅ΡΠΈΠ°Π»ΡΠ½ΡΠΌΠΈ ΡΡΠ΅Π΄ΡΡΠ²Π°ΠΌΠΈ.
www.astromeridian.ru
Π²ΠΈΠ΄Ρ, ΠΏΡΠΈΡΠΈΠ½Ρ, ΠΎΡΠ½ΠΎΠ²Π½ΡΠ΅ ΡΠΈΠΌΠΏΡΠΎΠΌΡ, Π»Π΅ΡΠ΅Π½ΠΈΠ΅
Π ΠΎΠΆΠ° ΠΈΠ»ΠΈ ΡΠΎΠΆΠΈΡΡΠΎΠ΅ Π²ΠΎΡΠΏΠ°Π»Π΅Π½ΠΈΠ΅ ΡΠ²Π»ΡΠ΅ΡΡΡ ΡΠ΅ΡΡΠ΅Π·Π½ΡΠΌ Π·Π°Π±ΠΎΠ»Π΅Π²Π°Π½ΠΈΠ΅ΠΌ ΠΈΠ½ΡΠ΅ΠΊΡΠΈΠΎΠ½Π½ΠΎΠΉ ΠΏΡΠΈΡΠΎΠ΄Ρ. ΠΠ½Π΅ΡΠ½Π΅Π΅ ΠΏΡΠΎΡΠ²Π»Π΅Π½ΠΈΠ΅ ΡΡΠΎΠΉ Π±ΠΎΠ»Π΅Π·Π½ΠΈ β ΠΏΡΠΎΠ³ΡΠ΅ΡΡΠΈΡΡΡΡΠ΅Π΅ ΠΏΠΎΡΠ°ΠΆΠ΅Π½ΠΈΠ΅ ΠΊΠΎΠΆΠ½ΠΎΠ³ΠΎ ΠΏΠΎΠΊΡΠΎΠ²Π°. Π ΠΌΠΎΠ»ΠΎΠ΄ΠΎΠΌ Π²ΠΎΠ·ΡΠ°ΡΡΠ΅, ΠΎΡ 20 Π΄ΠΎ 30 Π»Π΅Ρ, ΠΈΠΌ ΡΡΡΠ°Π΄Π°ΡΡ, ΡΠ°ΡΠ΅ Π²ΡΠ΅Π³ΠΎ, ΠΌΡΠΆΡΠΈΠ½Ρ, ΠΏΡΠΎΡΠ΅ΡΡΠΈΠΎΠ½Π°Π»ΡΠ½Π°Ρ Π΄Π΅ΡΡΠ΅Π»ΡΠ½ΠΎΡΡΡ ΠΊΠΎΡΠΎΡΡΡ ΡΠ²ΡΠ·Π°Π½Π° Ρ ΡΠ΅Π·ΠΊΠΈΠΌΠΈ ΡΠΌΠ΅Π½Π°ΠΌΠΈ ΡΠ΅ΠΌΠΏΠ΅ΡΠ°ΡΡΡΡ, Π·Π°Π³ΡΡΠ·Π½Π΅Π½ΠΈΠ΅ΠΌ ΠΊΠΎΠΆΠΈ, ΡΠ°ΡΡΡΠΌΠΈ Π½Π΅Π±ΠΎΠ»ΡΡΠΈΠΌΠΈ ΡΡΠ°Π²ΠΌΠ°ΠΌΠΈ ΡΠ΅Π»Π°. Π ΡΡΠ°ΡΡΠ΅ΠΌ Π²ΠΎΠ·ΡΠ°ΡΡΠ΅ Π±ΠΎΠ»Π΅Π·Π½Ρ ΡΠΎΠΆΠ° Ρ Π°ΡΠ°ΠΊΡΠ΅ΡΠ½Π°, Π² ΠΎΡΠ½ΠΎΠ²Π½ΠΎΠΌ, ΠΆΠ΅Π½ΡΠΈΠ½Π°ΠΌ.
ΠΡΠΈΡΠΈΠ½Ρ
ΠΡΠ½ΠΎΠ²Π½ΠΎΠΉ ΠΏΡΠΈΡΠΈΠ½ΠΎΠΉ Π²ΠΎΠ·Π½ΠΈΠΊΠ½ΠΎΠ²Π΅Π½ΠΈΡ Π·Π°Π±ΠΎΠ»Π΅Π²Π°Π½ΠΈΡ Π½Π°Π·ΡΠ²Π°ΡΡ ΠΏΡΠΎΠ½ΠΈΠΊΠ½ΠΎΠ²Π΅Π½ΠΈΠ΅ ΡΡΡΠ΅ΠΏΡΠΎΠΊΠΎΠΊΠΊΠΎΠ²ΠΎΠΉ ΠΈΠ½ΡΠ΅ΠΊΡΠΈΠΈ Π² ΠΎΡΠ³Π°Π½ΠΈΠ·ΠΌ ΡΠ΅Π»ΠΎΠ²Π΅ΠΊΠ° ΡΠ΅ΡΠ΅Π· ΠΏΠΎΠ²ΡΠ΅ΠΆΠ΄Π΅Π½ΠΈΡ ΠΊΠΎΠΆΠΈ β ΡΠ°ΡΠ°ΠΏΠΈΠ½Ρ, ΡΡΠ°Π΄ΠΈΠ½Ρ, ΠΎΠΏΡΠ΅Π»ΠΎΡΡΠΈ, ΠΏΠΎΡΠ΅ΡΡΠΎΡΡΠΈ.
ΠΡΠΈΠ±Π»ΠΈΠ·ΠΈΡΠ΅Π»ΡΠ½ΠΎ 15% Π»ΡΠ΄Π΅ΠΉ ΡΠ²Π»ΡΡΡΡΡ Π½ΠΎΡΠΈΡΠ΅Π»ΡΠΌΠΈ ΡΡΠΎΠΉ ΠΈΠ½ΡΠ΅ΠΊΡΠΈΠΈ, Π½ΠΎ ΠΏΡΠΈ ΡΡΠΎΠΌ Π½Π΅ Π±ΠΎΠ»Π΅ΡΡ. Π ΠΎΠΆΠ° ΡΠ°Π·Π²ΠΈΠ²Π°Π΅ΡΡΡ, ΠΏΡΠΈ Π½Π°Π»ΠΈΡΠΈΠΈ Π΄ΠΎΠΏΠΎΠ»Π½ΠΈΡΠ΅Π»ΡΠ½ΡΡ ΡΠ°ΠΊΡΠΎΡΠΎΠ² ΡΠΈΡΠΊΠ° ΠΈΠ»ΠΈ ΡΠ°ΡΠΏΠΎΠ»Π°Π³Π°ΡΡΠΈΡ Π·Π°Π±ΠΎΠ»Π΅Π²Π°Π½ΠΈΠΉ.
Π€Π°ΠΊΡΠΎΡΡ ΡΠΈΡΠΊΠ°, ΠΏΡΠΎΠ²ΠΎΡΠΈΡΡΡΡΠΈΠ΅ Π½Π°ΡΠ°Π»ΠΎ Π±ΠΎΠ»Π΅Π·Π½ΠΈ:
- ΠΏΠΎΠ²ΡΠ΅ΠΆΠ΄Π΅Π½ΠΈΠ΅ ΡΠ΅Π»ΠΎΡΡΠ½ΠΎΡΡΠΈ ΠΊΠΎΠΆΠ½ΠΎΠ³ΠΎ ΠΏΠΎΠΊΡΠΎΠ²Π° β ΡΠ°ΡΠ°ΠΏΠΈΠ½Ρ, ΡΡΠ°Π΄ΠΈΠ½Ρ, ΡΡΠ΅ΡΠΈΠ½Ρ, ΠΎΠΏΡΠ΅Π»ΠΎΡΡΡ, ΡΠ°ΡΡΠ΅ΡΡ, ΠΏΠΎΡΠ΅ΡΡΠΎΡΡΠΈ, ΡΠΊΠΎΠ»Ρ;
- ΡΠ΅Π·ΠΊΠΎΠ΅ ΠΏΠ΅ΡΠ΅ΠΎΡ Π»Π°ΠΆΠ΄Π΅Π½ΠΈΠ΅ ΠΈΠ»ΠΈ ΠΏΠ΅ΡΠ΅Π³ΡΠ΅Π² ΡΠ΅Π»Π°;
- ΡΡΠ΅Π·ΠΌΠ΅ΡΠ½ΡΠΉ Π·Π°Π³Π°Ρ;
- ΡΡΠ°Π²ΠΌΡ, ΡΡΠΈΠ±Ρ.
Π‘ΡΡΠ΅ΡΡΠ²ΡΡΡ Π·Π°Π±ΠΎΠ»Π΅Π²Π°Π½ΠΈΡ, ΠΏΡΠ΅Π΄ΡΠ°ΡΠΏΠΎΠ»Π°Π³Π°ΡΡΠΈΠ΅ ΠΊ Π½Π°ΡΠ°Π»Ρ ΡΠ°Π·Π²ΠΈΡΠΈΡ ΡΠΎΠΆΠΈ:
- ΡΠ°Ρ Π°ΡΠ½ΡΠΉ Π΄ΠΈΠ°Π±Π΅Ρ;
- Π³ΡΠΈΠ±ΠΎΠΊ ΡΡΠΎΠΏΡ;
- Π±ΠΎΠ»Π΅Π·Π½ΠΈ Π»ΠΈΠΌΡΠ°ΡΠΈΡΠ΅ΡΠΊΠΈΡ ΡΠΎΡΡΠ΄ΠΎΠ²;
- Π²Π°ΡΠΈΠΊΠΎΠ·Π½Π°Ρ Π±ΠΎΠ»Π΅Π·Π½Ρ Π²Π΅Π½;
- ΠΎΠΆΠΈΡΠ΅Π½ΠΈΠ΅;
- Π°Π»ΠΊΠΎΠ³ΠΎΠ»ΠΈΠ·ΠΌ;
- Π±ΠΎΠ»Π΅Π·Π½ΠΈ, ΠΏΡΠΈ ΠΊΠΎΡΠΎΡΡΡ Π½Π°Π±Π»ΡΠ΄Π°ΡΡΡΡ ΠΎΡΠ°Π³ΠΈ Ρ ΡΠΎΠ½ΠΈΡΠ΅ΡΠΊΠΎΠΉ ΡΡΡΠ΅ΠΏΡΠΎΠΊΠΎΠΊΠΊΠΎΠ²ΠΎΠΉ ΠΈΠ½ΡΠ΅ΠΊΡΠΈΠΈ β ΡΠΈΠ½ΡΡΠΈΡ, ΠΎΡΠΈΡ, ΡΠΎΠ½Π·ΠΈΠ»Π»ΠΈΡ, ΠΏΠ°ΡΠΎΠ΄ΠΎΠ½ΡΠΈΡ, ΠΊΠ°ΡΠΈΠ΅Ρ;
- ΡΡΠΎΡΠΈΡΠ΅ΡΠΊΠΈΠ΅ ΡΠ·Π²Ρ Π½Π° Π½ΠΎΠ³Π°Ρ , ΡΡΠΎΠΌΠ±ΠΎΡΠ»Π΅Π±ΠΈΡ;
- Ρ ΡΠΎΠ½ΠΈΡΠ΅ΡΠΊΠΈΠ΅ ΡΠΎΠΌΠ°ΡΠΈΡΠ΅ΡΠΊΠΈΠ΅ Π±ΠΎΠ»Π΅Π·Π½ΠΈ, ΠΊΠΎΡΠΎΡΡΠ΅ ΠΏΠΎΠ½ΠΈΠΆΠ°ΡΡ ΠΈΠΌΠΌΡΠ½ΠΈΡΠ΅Ρ ΠΎΡΠ³Π°Π½ΠΈΠ·ΠΌΠ°.
ΠΠΎΠ»Π΅Π·Π½Ρ ΡΠΎΠΆΠ° Π½Π°ΠΈΠ±ΠΎΠ»Π΅Π΅ ΡΠ°ΡΡΠΎ Π²ΠΎΠ·Π½ΠΈΠΊΠ°Π΅Ρ Π² Π»Π΅ΡΠ½Π΅-ΠΎΡΠ΅Π½Π½ΠΈΠΉ ΠΏΠ΅ΡΠΈΠΎΠ΄.
Π‘ΠΈΠΌΠΏΡΠΎΠΌΡ
ΠΠ°ΡΠ°Π»ΠΎ Π±ΠΎΠ»Π΅Π·Π½ΠΈ Ρ Π°ΡΠ°ΠΊΡΠ΅ΡΠΈΠ·ΡΠ΅ΡΡΡ ΠΎΠ·Π½ΠΎΠ±ΠΎΠΌ, Π³ΠΎΠ»ΠΎΠ²Π½ΠΎΠΉ Π±ΠΎΠ»ΡΡ, ΠΌΡΡΠ΅ΡΠ½ΡΠΌΠΈ Π±ΠΎΠ»ΡΠΌΠΈ, ΠΎΠ±ΡΠ΅ΠΉ ΡΠ»Π°Π±ΠΎΡΡΡΡ. ΠΠ½ΠΎΠ³Π΄Π° Π±ΡΠ²Π°Π΅Ρ ΡΡΠ°ΡΠ΅Π½ΠΈΠ΅ ΡΠ΅ΡΠ΄ΡΠ΅Π±ΠΈΠ΅Π½ΠΈΡ, ΡΠΎΡΠ½ΠΎΡΠ°, ΡΠ²ΠΎΡΠ°, ΠΏΠΎΠ²ΡΡΠ΅Π½ΠΈΠ΅ ΡΠ΅ΠΌΠΏΠ΅ΡΠ°ΡΡΡΡ ΡΠ΅Π»Π° Π΄ΠΎ 39-40 Β°C. ΠΡΠΈ ΡΡΠΆΠ΅Π»ΠΎΠΉ ΡΠΎΡΠΌΠ΅ ΡΠΎΠΆΠΈ ΡΠ΅Π»ΠΎΠ²Π΅ΠΊ ΠΌΠΎΠΆΠ΅Ρ Π±ΡΠ΅Π΄ΠΈΡΡ, Π½Π°Π±Π»ΡΠ΄Π°ΡΡΡΡ ΡΡΠ΄ΠΎΡΠΎΠ³ΠΈ, ΡΠ°Π·Π΄ΡΠ°ΠΆΠ΅Π½ΠΈΠ΅ ΠΌΠΎΠ·Π³ΠΎΠ²ΡΡ ΠΎΠ±ΠΎΠ»ΠΎΡΠ΅ΠΊ.
Π§Π΅ΡΠ΅Π· 12-24 ΡΠ°ΡΠ° ΠΏΠΎΡΠ»Π΅ Π·Π°ΡΠ°ΠΆΠ΅Π½ΠΈΡ ΠΏΡΠΎΡΠ²Π»ΡΡΡΡΡ ΠΌΠ΅ΡΡΠ½ΡΠ΅ ΡΠΈΠΌΠΏΡΠΎΠΌΡ Π±ΠΎΠ»Π΅Π·Π½ΠΈ. ΠΡΠΎ β ΠΎΡΠ΅ΠΊ, ΠΏΠΎΠΊΡΠ°ΡΠ½Π΅Π½ΠΈΠ΅, Π±ΠΎΠ»Ρ, ΠΆΠΆΠ΅Π½ΠΈΠ΅, ΡΡΠ²ΡΡΠ²ΠΎ Π½Π°ΠΏΡΡΠΆΠ΅Π½ΠΈΡ Π±ΠΎΠ»ΡΠ½ΠΎΠ³ΠΎ ΡΡΠ°ΡΡΠΊΠ° ΠΊΠΎΠΆΠΈ. Π ΠΎΠΆΠ° ΠΌΠΎΠΆΠ΅Ρ ΠΏΠΎΡΠ²ΠΈΡΡΡΡ Π½Π° ΠΊΠΎΠΆΠ΅ Π»ΠΈΡΠ°, ΠΊΠΎΠ½Π΅ΡΠ½ΠΎΡΡΠ΅ΠΉ, ΡΡΠ»ΠΎΠ²ΠΈΡΠ°, ΠΈΠ½ΠΎΠ³Π΄Π° β Π½Π° ΡΠ»ΠΈΠ·ΠΈΡΡΡΡ ΡΠΊΠ°Π½ΡΡ ΡΠ΅Π»Π°.
Π€ΠΎΡΠΌΡ Π·Π°Π±ΠΎΠ»Π΅Π²Π°Π½ΠΈΡ
Π‘ΡΡΠ΅ΡΡΠ²ΡΡΡ ΡΠ°Π·Π½ΡΠ΅ ΡΠΎΡΠΌΡ Π±ΠΎΠ»Π΅Π·Π½ΠΈ ΡΠΎΠΆΠ°, ΠΊΠΎΡΠΎΡΡΠ΅ ΠΎΡΠ»ΠΈΡΠ°ΡΡΡΡ ΠΎΡΠΎΠ±Π΅Π½Π½ΠΎΡΡΡΠΌΠΈ ΡΠΈΠΌΠΏΡΠΎΠΌΠΎΠ².
- ΠΡΠΈΡΠ΅ΠΌΠ°ΡΠΎΠ·Π½Π°Ρ ΡΠΎΡΠΌΠ°. ΠΠ»Ρ ΠΏΠΎΡΠ°ΠΆΠ΅Π½Π½ΠΎΠ³ΠΎ ΡΡΠ°ΡΡΠΊΠ° ΠΊΠΎΠΆΠΈ Ρ Π°ΡΠ°ΠΊΡΠ΅ΡΠ½Ρ ΠΏΠΎΠΊΡΠ°ΡΠ½Π΅Π½ΠΈΠ΅, ΠΎΡΠ΅ΠΊ, Π±ΠΎΠ»Π΅Π·Π½Π΅Π½Π½ΠΎΡΡΡ. ΠΡΠΈΡΠ΅ΠΌΠ° Π²ΠΎΠ·Π²ΡΡΠ°Π΅ΡΡΡ Π½Π°Π΄ ΠΊΠΎΠΆΠ΅ΠΉ, ΠΈΠΌΠ΅Π΅Ρ ΡΠ΅ΡΠΊΠΈΠ΅ Π³ΡΠ°Π½ΠΈΡΡ, ΡΡΠΊΡΡ ΠΎΠΊΡΠ°ΡΠΊΡ, ΡΠΊΠ»ΠΎΠ½Π½ΠΎΡΡΡ ΠΊ ΡΠ°ΡΡΠΈΡΠ΅Π½ΠΈΡ. ΠΠ΅ ΠΊΡΠ°Ρ ΠΈΠΌΠ΅ΡΡ Π½Π΅ΠΏΡΠ°Π²ΠΈΠ»ΡΠ½ΡΡ ΡΠΎΡΠΌΡ, Π½Π°ΠΏΡΠΈΠΌΠ΅Ρ, Π² Π²ΠΈΠ΄Π΅ ΡΠ·ΡΠΊΠΎΠ² ΠΏΠ»Π°ΠΌΠ΅Π½ΠΈ, Π·Π°Π·ΡΠ±ΡΠΈΠ½.
- ΠΡΠΈΡΠ΅ΠΌΠ°ΡΠΎΠ·Π½ΠΎ-Π±ΡΠ»Π»Π΅Π·Π½Π°Ρ ΡΠΎΡΠΌΠ°. ΠΠ° Π½Π°ΡΠ°Π»ΡΠ½ΠΎΠΉ ΡΡΠ°Π΄ΠΈΠΈ Π·Π°Π±ΠΎΠ»Π΅Π²Π°Π½ΠΈΡ ΡΡΠΎΠΉ ΡΠΎΡΠΌΠΎΠΉ ΡΠΎΠΆΠΈ ΡΠΈΠΌΠΏΡΠΎΠΌΡ ΡΠ°ΠΊΠΈΠ΅ ΠΆΠ΅, ΠΊΠ°ΠΊ ΠΈ ΠΏΡΠΈ ΡΡΠΈΡΠ΅ΠΌΠ°ΡΠΎΠ·Π½ΠΎΠΉ ΡΠΎΡΠΌΠ΅. ΠΠΎ ΡΠ΅ΡΠ΅Π· Π½Π΅ΡΠΊΠΎΠ»ΡΠΊΠΎ ΡΡΡΠΎΠΊ Π½Π° ΠΌΠ΅ΡΡΠ΅ ΡΡΠΈΡΡΠ΅ΠΌΡ Π½Π°Π±Π»ΡΠ΄Π°Π΅ΡΡΡ ΠΎΡΡΠ»ΠΎΠΉΠΊΠ° Π²Π΅ΡΡ Π½Π΅Π³ΠΎ ΡΠ»ΠΎΡ ΠΊΠΎΠΆΠΈ ΠΈ ΠΏΠΎΡΠ»Π΅Π΄ΡΡΡΠ΅Π΅ ΠΎΠ±ΡΠ°Π·ΠΎΠ²Π°Π½ΠΈΠ΅ ΠΏΡΠ·ΡΡΠ΅ΠΉ ΡΠ°Π·Π½ΠΎΠ³ΠΎ ΡΠ°Π·ΠΌΠ΅ΡΠ°. ΠΠΎΠ·ΠΆΠ΅ ΠΏΡΠ·ΡΡΠΈ Π»ΠΎΠΏΠ°ΡΡΡΡ, ΠΎΠ±ΡΠ°Π·ΡΡ ΠΊΠΎΡΠΈΡΠ½Π΅Π²ΡΠ΅ ΠΊΠΎΡΠΊΠΈ, ΠΏΠΎΠ΄ ΠΊΠΎΡΠΎΡΡΠΌΠΈ Π½Π°Ρ ΠΎΠ΄ΠΈΡΡΡ ΠΌΠΎΠ»ΠΎΠ΄Π°Ρ ΠΊΠΎΠΆΠ°. ΠΠ½ΠΎΠ³Π΄Π° Π½Π° ΠΌΠ΅ΡΡΠ΅ ΠΏΡΠ·ΡΡΠ΅ΠΉ ΠΌΠΎΠ³ΡΡ ΠΏΠΎΡΠ²ΠΈΡΡΡΡ ΡΡΠΎΠ·ΠΈΠΈ, ΠΊΠΎΡΠΎΡΡΠ΅ ΠΈΠ·ΡΠ΅Π΄ΠΊΠ° ΠΏΡΠ΅Π²ΡΠ°ΡΠ°ΡΡΡΡ Π² ΡΡΠΎΡΠΈΡΠ΅ΡΠΊΠΈΠ΅ ΡΠ·Π²Ρ.
- ΠΡΠΈΡΠ΅ΠΌΠ°ΡΠΎΠ·Π½ΠΎ-Π³Π΅ΠΌΠΎΡΡΠ°Π³ΠΈΡΠ΅ΡΠΊΠ°Ρ ΡΠΎΡΠΌΠ°. ΠΠΌΠ΅Π΅Ρ ΡΠ΅ ΠΆΠ΅ ΡΠΈΠΌΠΏΡΠΎΠΌΡ ΡΠΎΠΆΠΈ, ΡΡΠΎ ΠΈ ΡΡΠΈΡΠ΅ΠΌΠ°ΡΠΎΠ·Π½Π°Ρ. ΠΡΠΎΠΌΠ΅ ΡΠΎΠ³ΠΎ, Π½Π° ΠΏΠΎΡΠ°ΠΆΠ΅Π½Π½ΡΡ ΡΡΠ°ΡΡΠΊΠ°Ρ ΠΊΠΎΠΆΠΈ ΠΏΠΎΡΠ²Π»ΡΡΡΡΡ ΠΊΡΠΎΠ²ΠΎΠΈΠ·Π»ΠΈΡΠ½ΠΈΡ.
- ΠΡΠ»Π»Π΅Π·Π½ΠΎ-Π³Π΅ΠΌΠΎΡΡΠ°Π³ΠΈΡΠ΅ΡΠΊΠ°Ρ ΡΠΎΡΠΌΠ°. Π₯Π°ΡΠ°ΠΊΡΠ΅ΡΠΈΠ·ΡΠ΅ΡΡΡ ΠΏΡΠ°ΠΊΡΠΈΡΠ΅ΡΠΊΠΈ ΡΠ΅ΠΌΠΈ ΠΆΠ΅ ΡΠΈΠΌΠΏΡΠΎΠΌΠ°ΠΌΠΈ, ΡΡΠΎ ΠΈ ΡΡΠΈΡΠ΅ΠΌΠ°ΡΠΎΠ·Π½ΠΎ-Π±ΡΠ»Π»Π΅Π·Π½Π°Ρ ΡΠΎΡΠΌΠ°. ΠΠ΄Π½Π°ΠΊΠΎ ΠΏΡΠ·ΡΡΠΈ, ΠΊΠΎΡΠΎΡΡΠ΅ ΠΎΠ±ΡΠ°Π·ΡΡΡΡΡ Π² ΠΏΡΠΎΡΠ΅ΡΡΠ΅ Π·Π°Π±ΠΎΠ»Π΅Π²Π°Π½ΠΈΡ, ΠΈΠΌΠ΅ΡΡ Π½Π΅ ΠΏΡΠΎΠ·ΡΠ°ΡΠ½ΠΎΠ΅, Π° ΠΊΡΠΎΠ²ΡΠ½ΠΈΡΡΠΎΠ΅ (Π³Π΅ΠΌΠΎΡΡΠ°Π³ΠΈΡΠ΅ΡΠΊΠΎΠ΅) ΡΠΎΠ΄Π΅ΡΠΆΠΈΠΌΠΎΠ΅.
Π ΠΎΠΆΠ° Π½Π° Π½ΠΎΠ³Π΅
Π§Π°ΡΠ΅ Π²ΡΠ΅Π³ΠΎ ΡΠΎΠΆΠ° Π½Π° Π½ΠΎΠ³Π΅ ΠΏΠΎΡΠ²Π»ΡΠ΅ΡΡΡ Ρ ΠΎΡΠ»Π°Π±Π»Π΅Π½Π½ΡΡ
ΠΈΠ»ΠΈ ΠΏΠΎΠΆΠΈΠ»ΡΡ
Π»ΡΠ΄Π΅ΠΉ. ΠΠΌΠ΅Π½Π½ΠΎ ΠΎΠ½ΠΈ ΠΈΠΌΠ΅ΡΡ Π±ΠΎΠ»ΡΡΡΡ ΠΏΡΠ΅Π΄ΡΠ°ΡΠΏΠΎΠ»ΠΎΠΆΠ΅Π½Π½ΠΎΡΡΡ ΠΊ ΡΠ°ΠΊΠΈΠΌ Π±ΠΎΠ»Π΅Π·Π½ΡΠΌ, ΠΊΠ°ΠΊ Π²Π°ΡΠΈΠΊΠΎΠ·Π½ΠΎΠ΅ ΡΠ°ΡΡΠΈΡΠ΅Π½ΠΈΠ΅ Π²Π΅Π½ ΠΈ Π»ΠΈΠΌΡΠΎΠ·Π°ΡΡΠΎΠΉ. ΠΡΠΈ ΡΡΠΎΠΌ Π½Π° Π½ΠΎΠ³Π°Ρ
ΠΌΠΎΠ³ΡΡ Π²ΠΎΠ·Π½ΠΈΠΊΠ°ΡΡ ΡΠ·Π²ΠΎΡΠΊΠΈ, ΡΡΠ΅ΡΠΈΠ½ΠΊΠΈ, Π² ΠΊΠΎΡΠΎΡΡΡ
ΡΠ°Π·Π²ΠΈΠ²Π°Π΅ΡΡΡ ΡΡΡΠ΅ΠΏΡΠΎΠΊΠΎΠΊΠΊ, Π²ΡΠ·ΡΠ²Π°Ρ ΡΠΎΠΆΠΈΡΡΠΎΠ΅ Π²ΠΎΡΠΏΠ°Π»Π΅Π½ΠΈΠ΅.
ΠΠ½ΠΊΡΠ±Π°ΡΠΈΠΎΠ½Π½ΡΠΉ ΠΏΠ΅ΡΠΈΠΎΠ΄ Π·Π°Π±ΠΎΠ»Π΅Π²Π°Π½ΠΈΡ ΠΌΠΎΠΆΠ΅Ρ ΠΏΡΠΎΠ΄ΠΎΠ»ΠΆΠ°ΡΡΡΡ Π΄ΠΎ ΡΡΠ΅Ρ ΡΡΡΠΎΠΊ. ΠΠΎΡΠ»Π΅ ΡΡΠΎΠ³ΠΎ Ρ Π±ΠΎΠ»ΡΠ½ΠΎΠ³ΠΎ ΠΏΠΎΡΠ²Π»ΡΠ΅ΡΡΡ ΠΎΠ±ΡΠ°Ρ ΡΠ»Π°Π±ΠΎΡΡΡ, Π½Π΅Π΄ΠΎΠΌΠΎΠ³Π°Π½ΠΈΠ΅, ΡΠ°Π·Π±ΠΈΡΠΎΡΡΡ. ΠΠ΅ΠΎΠΆΠΈΠ΄Π°Π½Π½ΠΎ ΠΏΠΎΠ΄Π½ΠΈΠΌΠ°Π΅ΡΡΡ ΡΠ΅ΠΌΠΏΠ΅ΡΠ°ΡΡΡΠ° ΡΠ΅Π»Π°, ΠΏΠΎΡΠ²Π»ΡΠ΅ΡΡΡ Π³ΠΎΠ»ΠΎΠ²Π½Π°Ρ Π±ΠΎΠ»Ρ ΠΈ ΠΎΠ·Π½ΠΎΠ±. Π’Π΅ΠΌΠΏΠ΅ΡΠ°ΡΡΡΠ° Π² ΠΏΠ΅ΡΠ²ΡΠ΅ ΡΠ°ΡΡ ΠΏΡΠΎΡΠ²Π»Π΅Π½ΠΈΡ ΡΠΎΠΆΠΈ ΠΌΠΎΠΆΠ΅Ρ Π΄ΠΎΡΡΠΈΠ³Π°ΡΡ 40Β°C. ΠΠΎΡΠ²Π»ΡΠ΅ΡΡΡ Π±ΠΎΠ»Ρ Π² ΡΡΡΡΠ°Π²Π°Ρ , ΠΌΡΡΠ΅ΡΠ½Π°Ρ Π±ΠΎΠ»Ρ Π½ΠΎΠ³ ΠΈ ΠΏΠΎΡΡΠ½ΠΈΡΡ. ΠΠΎΠ³ΡΡ Π²ΠΎΡΠΏΠ°Π»ΠΈΡΡΡΡ Π»ΠΈΠΌΡΠ°ΡΠΈΡΠ΅ΡΠΊΠΈΠ΅ ΡΠ·Π»Ρ, ΡΠ°ΡΠΏΠΎΠ»ΠΎΠΆΠ΅Π½Π½ΡΠ΅ ΠΏΠΎΠ±Π»ΠΈΠ·ΠΎΡΡΠΈ.
ΠΠ° ΠΏΠΎΡΠ°ΠΆΠ΅Π½Π½ΠΎΠΌ ΡΡΠ°ΡΡΠΊΠ΅ Π½ΠΎΠ³ΠΈ ΡΡΠ²ΡΡΠ²ΡΠ΅ΡΡΡ ΠΆΠΆΠ΅Π½ΠΈΠ΅, Π±ΠΎΠ»Ρ, Π½Π°ΠΏΡΡΠΆΠ΅Π½Π½ΠΎΡΡΡ ΠΊΠΎΠΆΠΈ. Π§Π΅ΡΠ΅Π· ΠΊΠΎΡΠΎΡΠΊΠΎΠ΅ Π²ΡΠ΅ΠΌΡ ΠΏΠΎΡΠ²Π»ΡΠ΅ΡΡΡ ΠΊΡΠ°ΡΠ½ΠΎΠ΅ ΠΈΠ»ΠΈ ΡΠΎΠ·ΠΎΠ²ΠΎΠ΅ ΠΏΡΡΠ½ΠΎ Π½Π΅Π±ΠΎΠ»ΡΡΠΎΠ³ΠΎ ΡΠ°Π·ΠΌΠ΅ΡΠ°. Π ΠΎΠΆΠ° Π½Π° Π½ΠΎΠ³Π΅ Ρ Π°ΡΠ°ΠΊΡΠ΅ΡΠΈΠ·ΡΠ΅ΡΡΡ ΡΠ΅ΡΠΊΠΈΠΌΠΈ ΡΠ°Π·ΠΌΠ΅ΡΠ°ΠΌΠΈ ΠΈ ΠΏΠΎΡΡΠΎΡΠ½Π½ΡΠΌ ΡΠ°ΡΡΠΈΡΠ΅Π½ΠΈΠ΅ΠΌ Π³ΡΠ°Π½ΠΈΡ. ΠΠΎΠΆΠ° Π½Π° ΠΏΠΎΡΠ°ΠΆΠ΅Π½Π½ΠΎΠΌ ΡΡΠ°ΡΡΠΊΠ΅ Π½Π΅ΠΌΠ½ΠΎΠ³ΠΎ Π²ΠΎΠ·Π²ΡΡΠ΅Π½Π°, Π½Π°ΠΏΡΡΠΆΠ΅Π½Π½Π°Ρ, Π³ΠΎΡΡΡΠ°Ρ Π½Π° ΠΎΡΡΠΏΡ. ΠΠ½ΠΎΠ³Π΄Π° Π½Π° Π±ΠΎΠ»ΡΠ½ΠΎΠΌ ΡΡΠ°ΡΡΠΊΠ΅ ΠΊΠΎΠΆΠΈ ΠΏΠΎΡΠ²Π»ΡΡΡΡΡ ΠΊΡΠΎΠ²ΠΎΠΏΠΎΠ΄ΡΠ΅ΠΊΠΈ ΠΈ ΠΏΡΠ·ΡΡΡΠΊΠΈ, ΠΊΠΎΡΠΎΡΡΠ΅ ΠΏΡΠΎΡ ΠΎΠ΄ΡΡ ΡΠ΅ΡΠ΅Π· Π½Π΅ΠΊΠΎΡΠΎΡΡΠΉ ΠΏΠ΅ΡΠΈΠΎΠ΄ Π²ΡΠ΅ΠΌΠ΅Π½ΠΈ.
ΠΡΠ»ΠΎΠΆΠ½Π΅Π½ΠΈΠ΅ΠΌ ΡΠΎΠΆΠΈ Π½Π° Π½ΠΎΠ³Π΅ ΠΌΠΎΠ³ΡΡ Π±ΡΡΡ ΡΠ·Π²Ρ ΠΈ ΡΡΠΎΠ·ΠΈΠΈ.
ΠΠ΅ΡΠ΅Π½ΠΈΠ΅
ΠΠ΅ΡΠ΅Π½ΠΈΠ΅ ΡΠΎΠΆΠΈ Π² Π»Π΅Π³ΠΊΠΎΠΉ ΡΠΎΡΠΌΠ΅ ΠΏΡΠΎΠ²ΠΎΠ΄ΡΡ Π°ΠΌΠ±ΡΠ»Π°ΡΠΎΡΠ½ΠΎ. ΠΡΠΈ ΡΡΠ΅Π΄Π½Π΅ΠΉ ΠΈ ΡΡΠΆΠ΅Π»ΠΎΠΉ ΡΠΎΡΠΌΠ΅ Π·Π°Π±ΠΎΠ»Π΅Π²Π°Π½ΠΈΡ, Π½Π΅ΠΎΠ±Ρ ΠΎΠ΄ΠΈΠΌΠΎ ΠΏΡΠΎΠ²Π΅Π΄Π΅Π½ΠΈΠ΅ ΡΠ΅ΡΠ°ΠΏΠΈΠΈ Π² ΡΡΠ°ΡΠΈΠΎΠ½Π°ΡΠ΅. Π‘ΡΡΠ΅ΡΡΠ²ΡΡΡ ΠΏΠΎΠΊΠ°Π·Π°Π½ΠΈΡ Π΄Π»Ρ ΠΎΠ±ΡΠ·Π°ΡΠ΅Π»ΡΠ½ΠΎΠΉ Π³ΠΎΡΠΏΠΈΡΠ°Π»ΠΈΠ·Π°ΡΠΈΠΈ ΠΏΡΠΈ Π»Π΅ΡΠ΅Π½ΠΈΠΈ ΡΠΎΠΆΠΈ:
- Π΄Π΅ΡΡΠΊΠΈΠΉ ΠΈΠ»ΠΈ ΠΏΠΎΠΆΠΈΠ»ΠΎΠΉ Π²ΠΎΠ·ΡΠ°ΡΡ Π±ΠΎΠ»ΡΠ½ΡΡ ;
- ΡΡΠΆΠ΅Π»ΠΎΠ΅ ΡΠ΅ΡΠ΅Π½ΠΈΠ΅ Π·Π°Π±ΠΎΠ»Π΅Π²Π°Π½ΠΈΡ Ρ ΠΎΠ±ΡΠΈΡΠ½ΡΠΌ ΠΏΠΎΡΠ°ΠΆΠ΅Π½ΠΈΠ΅ΠΌ ΠΊΠΎΠΆΠΈ ΠΈΠ»ΠΈ ΡΠ΅Π·ΠΊΠΎ Π²ΡΡΠ°ΠΆΠ΅Π½Π½ΡΠΌΠΈ ΠΏΡΠΈΠ·Π½Π°ΠΊΠ°ΠΌΠΈ ΠΈΠ½ΡΠΎΠΊΡΠΈΠΊΠ°ΡΠΈΠΈ; ΡΠ°ΡΠ΅ Π²ΡΠ΅Π³ΠΎ ΡΡΠΎ Π½Π°Π±Π»ΡΠ΄Π°Π΅ΡΡΡ ΠΏΡΠΈ Π±ΡΠ»Π»Π΅Π·Π½ΠΎ-Π³Π΅ΠΌΠΎΡΡΠ°Π³ΠΈΡΠ΅ΡΠΊΠΎΠΉ ΡΠΎΡΠΌΠ΅ ΡΠΎΠΆΠΈ;
- Π½Π°Π»ΠΈΡΠΈΠ΅ Ρ Π±ΠΎΠ»ΡΠ½ΠΎΠ³ΠΎ ΡΠ΅ΡΡΠ΅Π·Π½ΡΡ ΡΠΎΠΏΡΡΡΡΠ²ΡΡΡΠΈΡ Π·Π°Π±ΠΎΠ»Π΅Π²Π°Π½ΠΈΠΉ;
- ΡΠ°ΡΡΡΠ΅ ΠΎΠ±ΠΎΡΡΡΠ΅Π½ΠΈΡ Π±ΠΎΠ»Π΅Π·Π½ΠΈ, Π½Π΅Π·Π°Π²ΠΈΡΠΈΠΌΠΎ ΠΎΡ Ρ Π°ΡΠ°ΠΊΡΠ΅ΡΠ° ΠΌΠ΅ΡΡΠ½ΠΎΠ³ΠΎ ΠΏΠΎΡΠ°ΠΆΠ΅Π½ΠΈΡ, ΡΡΠ΅ΠΏΠ΅Π½ΠΈ ΠΈΠ½ΡΠΎΠΊΡΠΈΠΊΠ°ΡΠΈΠΈ.
ΠΡΠ½ΠΎΠ²Π½ΠΎΠ΅ Π·Π½Π°ΡΠ΅Π½ΠΈΠ΅ Π² ΠΊΠΎΠΌΠΏΠ»Π΅ΠΊΡΠ½ΠΎΠΌ Π»Π΅ΡΠ΅Π½ΠΈΠΈ ΡΠΎΠΆΠΈ ΠΈΠΌΠ΅Π΅Ρ Π°Π½ΡΠΈΠ±Π°ΠΊΡΠ΅ΡΠΈΠ°Π»ΡΠ½Π°Ρ ΡΠ΅ΡΠ°ΠΏΠΈΡ. ΠΡΠΈ Π²ΡΡΠ°ΠΆΠ΅Π½Π½ΠΎΠΌ ΠΏΠΎΡΠ°ΠΆΠ΅Π½ΠΈΠΈ ΠΊΠΎΠΆΠΈ ΠΏΡΠΈΠΌΠ΅Π½ΡΡΡ Π½Π΅ΡΡΠ΅ΡΠΎΠΈΠ΄Π½ΡΠ΅ ΠΏΡΠΎΡΠΈΠ²ΠΎΠ²ΠΎΡΠΏΠ°Π»ΠΈΡΠ΅Π»ΡΠ½ΡΠ΅ ΠΏΡΠ΅ΠΏΠ°ΡΠ°ΡΡ. ΠΠΎΠ»ΡΠ½ΡΠΌ Π½Π°Π·Π½Π°ΡΠ°ΡΡ ΠΊΠΎΠΌΠΏΠ»Π΅ΠΊΡΡ Π²ΠΈΡΠ°ΠΌΠΈΠ½ΠΎΠ² Π, Π, Π°ΡΠΊΠΎΡΠ±ΠΈΠ½ΠΎΠ²ΡΡ ΠΊΠΈΡΠ»ΠΎΡΡ.
ΠΠ΅ΡΠ΅Π½ΠΈΠ΅ ΠΌΠ΅ΡΡΠ½ΡΡ ΡΠΈΠΌΠΏΡΠΎΠΌΠΎΠ² ΡΠΎΠΆΠΈ ΠΏΡΠΎΠ²ΠΎΠ΄ΡΡ ΡΠΎΠ»ΡΠΊΠΎ ΠΏΡΠΈ Π±ΡΠ»Π»Π΅Π·Π½ΡΡ ΡΠΎΡΠΌΠ°Ρ , ΠΏΡΠΈ ΠΊΠΎΡΠΎΡΡΡ ΠΏΠΎΡΠ°ΠΆΠ°Π΅ΡΡΡ ΠΊΠΎΠΆΠ° ΠΊΠΎΠ½Π΅ΡΠ½ΠΎΡΡΠ΅ΠΉ.
ΠΠ°ΠΊ Π΄ΠΎΠΏΠΎΠ»Π½Π΅Π½ΠΈΠ΅ ΠΊ ΠΎΡΠ½ΠΎΠ²Π½ΠΎΠΌΡ Π»Π΅ΡΠ΅Π½ΠΈΡ ΠΏΡΠΈΠΌΠ΅Π½ΡΡΡ ΡΠΈΠ·ΠΈΠΎΡΠ΅ΡΠ°ΠΏΠΈΡ. Π₯ΠΎΡΠΎΡΠΈΠ΅ ΡΠ΅Π·ΡΠ»ΡΡΠ°ΡΡ Π΄Π°Π΅Ρ ΠΌΠ΅ΡΡΠ½ΠΎΠ΅ ΡΠ»ΡΡΡΠ°ΡΠΈΠΎΠ»Π΅ΡΠΎΠ²ΠΎΠ΅ ΠΎΠ±Π»ΡΡΠ΅Π½ΠΈΠ΅, Π²ΠΎΠ·Π΄Π΅ΠΉΡΡΠ²ΠΈΠ΅ Π½Π΅Π±ΠΎΠ»ΡΡΠΈΠΌΠΈ ΡΠ°Π·ΡΡΠ΄Π°ΠΌΠΈ ΡΠ»Π΅ΠΊΡΡΠΈΡΠ΅ΡΠΊΠΎΠ³ΠΎ ΡΠΎΠΊΠ°, Π»Π°Π·Π΅ΡΠ½Π°Ρ ΡΠ΅ΡΠ°ΠΏΠΈΡ, ΠΏΡΠΈΠΌΠ΅Π½Π΅Π½ΠΈΠ΅ ΡΠΎΠΊΠ° Π²ΡΡΠΎΠΊΠΎΠΉ ΡΠ°ΡΡΠΎΡΡ.
ΠΠΎΠ»Π΅Π·Π½Ρ ΡΠΎΠΆΠ° Ρ Π°ΡΠ°ΠΊΡΠ΅ΡΠΈΠ·ΡΠ΅ΡΡΡ ΡΠ°ΡΡΡΠΌΠΈ ΡΠ΅ΡΠΈΠ΄ΠΈΠ²Π°ΠΌΠΈ. ΠΠ»Ρ Π±ΠΎΠ»ΡΠ½ΡΡ , ΠΊΠΎΡΠΎΡΡΠ΅ Π½Π΅ΠΎΠ΄Π½ΠΎΠΊΡΠ°ΡΠ½ΠΎ ΠΈΡΠΏΡΡΡΠ²Π°ΡΡ ΠΎΠ±ΠΎΡΡΡΠ΅Π½ΠΈΡ Π·Π°Π±ΠΎΠ»Π΅Π²Π°Π½ΠΈΡ, ΠΏΡΠΎΠ²ΠΎΠ΄ΡΡ ΠΌΠ΅Π΄ΠΈΠΊΠ°ΠΌΠ΅Π½ΡΠΎΠ·Π½ΡΡ ΠΏΡΠΎΡΠΈΠ»Π°ΠΊΡΠΈΠΊΡ.Β ΠΠ½Π° Π·Π°ΠΊΠ»ΡΡΠ°Π΅ΡΡΡ Π² ΠΏΡΠΈΠΌΠ΅Π½Π΅Π½ΠΈΠΈ ΡΠΏΠ΅ΡΠΈΠ°Π»ΡΠ½ΡΡ Π°Π½ΡΠΈΠ±ΠΈΠΎΡΠΈΠΊΠΎΠ² ΠΏΡΠΎΠ»ΠΎΠ½Π³ΠΈΡΠΎΠ²Π°Π½Π½ΠΎΠ³ΠΎ Π΄Π΅ΠΉΡΡΠ²ΠΈΡ. Π’Π°ΠΊΠΎΠ΅ Π½Π°Π·Π½Π°ΡΠ΅Π½ΠΈΠ΅ ΠΌΠΎΠΆΠ΅Ρ ΡΠ΄Π΅Π»Π°ΡΡ ΡΠΎΠ»ΡΠΊΠΎ Π²ΡΠ°Ρ.
dolgojit.net
Π ΠΎΠΆΠ°: ΠΏΡΠΈΡΠΈΠ½Ρ, ΡΠΈΠΌΠΏΡΠΎΠΌΡ, ΡΠΎΡΠΌΡ, Π»Π΅ΡΠ΅Π½ΠΈΠ΅
Π ΠΎΠΆΠ° (ΡΠΎΠΆΠΈΡΡΠΎΠ΅ Π²ΠΎΡΠΏΠ°Π»Π΅Π½ΠΈΠ΅) β Π΄ΠΎΡΡΠ°ΡΠΎΡΠ½ΠΎ ΡΠ΅ΡΡΠ΅Π·Π½ΠΎΠ΅ ΠΈΠ½ΡΠ΅ΠΊΡΠΈΠΎΠ½Π½ΠΎΠ΅ Π·Π°Π±ΠΎΠ»Π΅Π²Π°Π½ΠΈΠ΅, ΠΊΠΎΡΠΎΡΠΎΠ΅ ΠΎΠ±ΡΡΠ»ΠΎΠ²Π»Π΅Π½ΠΎ Π²ΠΎΡΠΏΠ°Π»ΠΈΡΠ΅Π»ΡΠ½ΡΠΌ ΠΏΠΎΡΠ°ΠΆΠ΅Π½ΠΈΠ΅ΠΌ ΠΊΠΎΠΆΠΈ ΠΈ ΠΎΠ±ΡΠ΅ΠΉ ΠΈΠ½ΡΠΎΠΊΡΠΈΠΊΠ°ΡΠΈΠ΅ΠΉ ΠΎΡΠ³Π°Π½ΠΈΠ·ΠΌΠ°.
ΠΠΎΠ·Π±ΡΠ΄ΠΈΡΠ΅Π»Π΅ΠΌ Π ΠΎΠΆΠΈ ΡΠ²Π»ΡΠ΅ΡΡΡ ΡΠΎΠΆΠΈΡΡΡΠΉ ΡΡΡΠ΅ΠΏΡΠΎΠΊΠΎΠΊΠΊ, ΡΡΡΠΎΠΉΡΠΈΠ²ΡΠΉ Π²Π½Π΅ ΠΎΡΠ³Π°Π½ΠΈΠ·ΠΌΠ° ΡΠ΅Π»ΠΎΠ²Π΅ΠΊΠ° (Π΄ΠΎΡΡΠ°ΡΠΎΡΠ½ΠΎ Ρ ΠΎΡΠΎΡΠΎ ΠΏΠ΅ΡΠ΅Π½ΠΎΡΠΈΡ Π½ΠΈΠ·ΠΊΡΡ ΡΠ΅ΠΌΠΏΠ΅ΡΠ°ΡΡΡΡ ΠΈ Π²ΡΡΡΡΠΈΠ²Π°Π½ΠΈΠ΅, ΠΏΠΎΠ³ΠΈΠ±Π°Π΅Ρ ΡΠΎΠ»ΡΠΊΠΎ ΠΏΡΠΈ Π½Π°Π³ΡΠ΅Π²Π°Π½ΠΈΠΈ Π² ΡΠ΅ΡΠ΅Π½ΠΈΠΈ 30 ΠΌΠΈΠ½ΡΡ Π΄ΠΎ 56*Π‘).
Π Π²ΠΎΠ·ΡΠ°ΡΡΠ΅ ΠΎΡ 20 Π΄ΠΎ 30 Π»Π΅Ρ Π ΠΎΠΆΠ΅ΠΉ ΡΡΡΠ°Π΄Π°ΡΡ ΠΏΡΠ΅ΠΈΠΌΡΡΠ΅ΡΡΠ²Π΅Π½Π½ΠΎ ΠΌΡΠΆΡΠΈΠ½Ρ, ΠΊΠΎΡΠΎΡΡΠ΅ Π² ΡΠΈΠ»Ρ ΡΠ²ΠΎΠ΅ΠΉ ΠΏΡΠΎΡΠ΅ΡΡΠΈΠΎΠ½Π°Π»ΡΠ½ΠΎΠΉ Π΄Π΅ΡΡΠ΅Π»ΡΠ½ΠΎΡΡΠΈ ΡΠ²ΡΠ·Π°Π½Ρ Ρ Π·Π°Π³ΡΡΠ·Π½Π΅Π½ΠΈΠ΅ΠΌ ΠΈ ΠΌΠΈΠΊΡΠΎΡΡΠ°Π²ΠΌΠ°ΡΠΈΠ·Π°ΡΠΈΠ΅ΠΉ ΠΊΠΎΠΆΠΈ (ΡΡΡΠΎΠΈΡΠ΅Π»ΠΈ, Π²ΠΎΠ΄ΠΈΡΠ΅Π»ΠΈ, Π³ΡΡΠ·ΡΠΈΠΊΠΈ ΠΈ ΠΏΡ.). Π Π²ΠΎΡ Π² ΡΡΠ°ΡΡΠ΅ΠΉ Π²ΠΎΠ·ΡΠ°ΡΡΠ½ΠΎΠΉ Π³ΡΡΠΏΠΏΠ΅ (ΠΏΠΎΡΠ»Π΅ 40 Π»Π΅Ρ) Π±ΠΎΠ»ΡΡΠ΅ΠΉ ΡΠ°ΡΡΡΡ Π±ΠΎΠ»ΡΠ½ΡΡ Π ΠΎΠΆΠ΅ΠΉ ΡΠ²Π»ΡΡΡΡΡ ΠΆΠ΅Π½ΡΠΈΠ½Ρ
ΠΡΠΈΡΠΈΠ½Ρ Π²ΠΎΠ·Π½ΠΈΠΊΠ½ΠΎΠ²Π΅Π½ΠΈΡ
ΠΡΠ½ΠΎΠ²Π½ΠΎΠΉ ΠΏΡΠΈΡΠΈΠ½ΠΎΠΉ Π²ΠΎΠ·Π½ΠΈΠΊΠ½ΠΎΠ²Π΅Π½ΠΈΡ Π΄Π°Π½Π½ΠΎΠ³ΠΎ Π·Π°Π±ΠΎΠ»Π΅Π²Π°Π½ΠΈΡ ΡΠ²Π»ΡΠ΅ΡΡΡ ΠΏΡΠΎΠ½ΠΈΠΊΠ½ΠΎΠ²Π΅Π½ΠΈΠ΅ ΡΡΡΠ΅ΠΏΡΠΎΠΊΠΎΠΊΠΊΠΎΠ²ΠΎΠΉ ΠΈΠ½ΡΠ΅ΠΊΡΠΈΠΈ ΡΠ΅ΡΠ΅Π· ΠΏΠΎΠ²ΡΠ΅ΠΆΠ΄Π΅Π½Π½ΡΡ (ΡΡΠ°Π΄ΠΈΠ½Ρ, ΠΎΠΏΡΠ΅Π»ΠΎΡΡΠΈ, ΡΠ°ΡΠ°ΠΏΠΈΠ½Ρ, ΠΏΠΎΡΠ΅ΡΡΠΎΡΡΠΈ) ΠΊΠΎΠΆΡ. ΠΠΎ ΡΡΠ°ΡΠΈΡΡΠΈΡΠ΅ΡΠΊΠΈΠΌ Π΄Π°Π½Π½ΡΠΌ ΠΏΠΎΡΡΠ΄ΠΊΠ° ΠΏΡΡΠ½Π°Π΄ΡΠ°ΡΠΈ ΠΏΡΠΎΡΠ΅Π½ΡΠΎΠ² Π»ΡΠ΄Π΅ΠΉ ΡΠ²Π»ΡΡΡΡΡ Π½ΠΎΡΠΈΡΠ΅Π»ΡΠΌΠΈ Π΄Π°Π½Π½ΠΎΠΉ ΠΈΠ½ΡΠ΅ΠΊΡΠΈΠΈ, Π½ΠΎ ΠΏΡΠΈ ΡΡΠΎ Π½Π΅ Π·Π°Π±ΠΎΠ»Π΅Π²Π°Ρ, ΡΠ°ΠΊ ΠΊΠ°ΠΊ ΡΠ°Π·Π²ΠΈΡΠΈΠ΅ Π ΠΎΠΆΠΈ Π΄ΠΎΠ»ΠΆΠ½ΠΎ Π±ΡΡΡ ΡΠΏΡΠΎΠ²ΠΎΡΠΈΡΠΎΠ²Π°Π½ΠΎ ΠΎΠΏΡΠ΅Π΄Π΅Π»Π΅Π½Π½ΡΠΌΠΈ ΡΠ°ΠΊΡΠΎΡΠ°ΠΌΠΈ ΠΈΠ»ΠΈ ΠΆΠ΅ ΠΏΡΠ΅Π΄ΡΠ°ΡΠΏΠΎΠ»Π°Π³Π°ΡΡΠΈΠΌΠΈ ΠΊ ΡΡΠΎΠΌΡ Π·Π°Π±ΠΎΠ»Π΅Π²Π°Π½ΠΈΡΠΌΠΈ.
Π€Π°ΠΊΡΠΎΡΡ ΠΏΡΠΎΠ²ΠΎΡΠΈΡΡΡΡΠΈΠ΅ Π²ΠΎΠ·Π½ΠΈΠΊΠ½ΠΎΠ²Π΅Π½ΠΈΠ΅ Π ΠΎΠΆΠΈ:
β Π Π΅Π·ΠΊΠ°Ρ ΠΏΠ΅ΡΠ΅ΠΌΠ΅Π½Π° ΡΠ΅ΠΌΠΏΠ΅ΡΠ°ΡΡΡΡ ΡΠ΅Π»Π° (ΠΏΠ΅ΡΠ΅Π³ΡΠ΅Π² ΠΈ ΠΏΠ΅ΡΠ΅ΠΎΡ Π»Π°ΠΆΠ΄Π΅Π½ΠΈΠ΅)
β ΠΠ°ΡΡΡΠ΅Π½ΠΈΠ΅ ΡΠ΅Π»ΠΎΡΡΠ½ΠΎΡΡΠΈ ΠΊΠΎΠΆΠ½ΡΡ ΠΏΠΎΠΊΡΠΎΠ²ΠΎΠ² (ΡΡΠ΅ΡΠΈΠ½Ρ, ΠΎΠΏΡΠ΅Π»ΠΎΡΡΠΈ, ΡΠ°ΡΠ°ΠΏΠΈΠ½Ρ, ΡΡΠ°Π΄ΠΈΠ½Ρ, ΠΏΠΎΡΠ΅ΡΡΠΎΡΡΠΈ, ΡΠΊΠΎΠ»Ρ)
β Π£ΡΠΈΠ±Ρ ΠΈ ΡΡΠ°Π²ΠΌΡ
β Π‘ΠΎΠ»Π½Π΅ΡΠ½ΡΠΉ Π·Π°Π³Π°Ρ
ΠΡΠ΅Π΄ΡΠ°ΡΠΏΠΎΠ»Π°Π³Π°ΡΡΠΈΠ΅ ΠΏΠΎΡΠ²Π»Π΅Π½ΠΈΡ Π ΠΎΠΆΠΈ Π·Π°Π±ΠΎΠ»Π΅Π²Π°Π½ΠΈΡ:
β Π‘Π°Ρ Π°ΡΠ½ΡΠΉ Π΄ΠΈΠ°Π±Π΅Ρ
β ΠΠ°ΡΠΈΠΊΠΎΠ·Π½ΠΎΠ΅ ΡΠ°ΡΡΠΈΡΠ΅Π½ΠΈΠ΅ Π²Π΅Π½
β ΠΠ°Π±ΠΎΠ»Π΅Π²Π°Π½ΠΈΡ Π»ΠΈΠΌΡΠ°ΡΠΈΡΠ΅ΡΠΊΠΈΡ ΡΠ·Π»ΠΎΠ²
β ΠΡΠΈΠ±ΠΎΠΊ ΡΡΠΎΠΏΡ
β Π₯ΡΠΎΠ½ΠΈΡΠ΅ΡΠΊΠΈΠ΅ ΡΠΎΠΌΠ°ΡΠΈΡΠ΅ΡΠΊΠΈΠ΅ Π·Π°Π±ΠΎΠ»Π΅Π²Π°Π½ΠΈΡ, ΠΊΠΎΡΠΎΡΡΠ΅ ΡΠ½ΠΈΠΆΠ°ΡΡ ΠΎΠ±ΡΠΈΠΉ ΠΈΠΌΠΌΡΠ½ΠΈΡΠ΅Ρ ΠΎΡΠ³Π°Π½ΠΈΠ·ΠΌΠ°
β ΠΡΠ°Π³ΠΈ Ρ ΡΠΎΠ½ΠΈΡΠ΅ΡΠΊΠΎΠΉ ΡΡΡΠ΅ΠΏΡΠΎΠΊΠΎΠΊΠΊΠΎΠ²ΠΎΠΉ ΠΈΠ½ΡΠ΅ΠΊΡΠΈΠΈ (ΠΏΠ°ΡΠΎΠ΄ΠΎΠ½ΡΠΈΡ, ΠΊΠ°ΡΠΈΠ΅Ρ, ΡΠΈΠ½ΡΡΠΈΡ, ΡΠΎΠ½Π·ΠΈΠ»Π»ΠΈΡ, ΠΎΡΠΈΡ β ΠΏΡΠΈ Π ΠΎΠΆΠ΅ Π»ΠΈΡΠ°; ΡΡΠΎΡΠΈΡΠ΅ΡΠΊΠΈΠ΅ ΡΠ·Π²Ρ ΠΈ ΡΡΠΎΠΌΠ±ΠΎΡΠ»Π΅Π±ΠΈΡ β ΠΏΡΠΈ Π ΠΎΠΆΠ΅ ΠΊΠΎΠ½Π΅ΡΠ½ΠΎΡΡΠ΅ΠΉ)
Π‘ΠΈΠΌΠΏΡΠΎΠΌΡ
ΠΡΠ°ΠΊΡΠΈΡΠ΅ΡΠΊΠΈ Π²ΠΎ Π²ΡΠ΅Ρ ΡΠ»ΡΡΠ°ΡΡ Π·Π°Π±ΠΎΠ»Π΅Π²Π°Π½ΠΈΠ΅ Π½Π°ΡΠΈΠ½Π°Π΅ΡΡΡ ΠΎΡΡΡΠΎ:
β ΠΠΎΡΠ²Π»ΡΠ΅ΡΡΡ ΠΎΠ±ΡΠ°Ρ ΡΠ»Π°Π±ΠΎΡΡΡ ΠΎΡΠ³Π°Π½ΠΈΠ·ΠΌΠ°
β ΠΠΎΠ·Π½ΠΈΠΊΠ°ΡΡ ΠΌΡΡΠ΅ΡΠ½ΡΠ΅ ΠΈ Π³ΠΎΠ»ΠΎΠ²Π½ΡΠ΅ Π±ΠΎΠ»ΠΈ
β ΠΠ΅ΡΠ΅Π΄ΠΊΠΎ ΠΏΡΠΈΡΡΡΡΡΠ²ΡΠ΅Ρ ΡΠΎΡΠ½ΠΎΡΠ° ΠΈ ΡΠ²ΠΎΡΠ°
β Π’Π΅ΠΌΠΏΠ΅ΡΠ°ΡΡΡΠ° ΡΠ΅Π»Π° ΠΏΠΎΠ²ΡΡΠ°Π΅ΡΡΡ Π΄ΠΎ 39*-40*Π‘
β ΠΠΎΡΠ²Π»ΡΠ΅ΡΡΡ ΠΎΠ·Π½ΠΎΠ±
Π ΡΡΠΆΠ΅Π»ΡΡ ΡΠ»ΡΡΠ°ΡΡ ΠΏΠΎΡΠ°ΠΆΠ΅Π½ΠΈΡ Π²ΠΎΠ·ΠΌΠΎΠΆΠ½ΠΎ ΠΏΠΎΡΠ²Π»Π΅Π½ΠΈΠ΅ ΡΡΠ΄ΠΎΡΠΎΠ³, Π±ΡΠ΅Π΄Π°, Π²ΠΎΠ·Π½ΠΈΠΊΠ°Π΅Ρ ΡΠ°Π·Π΄ΡΠ°ΠΆΠ΅Π½ΠΈΠ΅ ΠΌΠΎΠ·Π³ΠΎΠ²ΡΡ ΠΎΠ±ΠΎΠ»ΠΎΡΠ΅ΠΊ.
Π ΡΠ΅ΡΠ΅Π½ΠΈΠ΅ ΡΡΡΠΎΠΊ Ρ ΠΌΠΎΠΌΠ΅Π½ΡΠ° ΠΏΠ΅ΡΠ²ΡΡ ΠΏΡΠΎΡΠ²Π»Π΅Π½ΠΈΠΉ Π·Π°Π±ΠΎΠ»Π΅Π²Π°Π½ΠΈΡ ΠΏΡΠΈΡΠΎΠ΅Π΄ΠΈΠ½ΡΡΡΡΡ ΠΈ ΠΌΠ΅ΡΡΠ½ΡΠ΅ ΡΠΈΠΌΠΏΡΠΎΠΌΡ: ΠΏΠΎΠΊΡΠ°ΡΠ½Π΅Π½ΠΈΠ΅, ΠΆΠΆΠ΅Π½ΠΈΠ΅, ΠΎΡΠ΅ΠΊ ΠΈ Π±ΠΎΠ»Ρ ΠΏΠΎΡΠ°ΠΆΠ΅Π½Π½ΠΎΠ³ΠΎ ΡΡΠ°ΡΡΠΊΠ° ΠΊΠΎΠΆΠΈ.
ΠΠΎ Ρ Π°ΡΠ°ΠΊΡΠ΅ΡΡ ΠΏΠΎΡΠ°ΠΆΠ΅Π½ΠΈΡ Π ΠΎΠΆΠ° ΠΏΠΎΠ΄ΡΠ°Π·Π΄Π΅Π»ΡΠ΅ΡΡΡ:
β ΠΡΠΈΡΠ΅ΠΌΠ°ΡΠΎΠ·Π½Π°Ρ ΡΠΎΡΠΌΠ° (ΠΏΠΎΠΊΡΠ°ΡΠ½Π΅Π½ΠΈΡ ΠΈ ΠΎΡΠ΅ΡΠ½ΠΎΡΡΡ ΠΊΠΎΠΆΠΈ)
β ΠΠ΅ΠΌΠΎΡΡΠ°Π³ΠΈΡΠ΅ΡΠΊΠ°Ρ ΡΠΎΡΠΌΠ° (ΠΏΡΠΎΠ½ΠΈΡΠ°Π΅ΠΌΠΎΡΡΡ ΠΊΡΠΎΠ²Π΅Π½ΠΎΡΠ½ΡΡ ΡΠΎΡΡΠ΄ΠΎΠ² ΠΈ ΠΈΡ ΠΊΡΠΎΠ²ΠΎΡΠΎΡΠΈΠ²ΠΎΡΡΡ)
β ΠΡΠ»Π»Π΅Π·Π½Π°Ρ ΡΠΎΡΠΌΠ° (Π½Π° ΠΏΠΎΡΠ°ΠΆΠ΅Π½Π½ΠΎΠΉ ΠΊΠΎΠΆΠ΅ Π²ΠΎΠ·Π½ΠΈΠΊΠ°ΡΡ Π½Π°ΠΏΠΎΠ»Π½Π΅Π½Π½ΡΠ΅ ΡΠ΅ΡΠΎΠ·Π½ΡΠΌ ΡΠΊΡΡΡΠ΄Π°ΡΠΎΠΌ ΠΏΡΠ·ΡΡΠΈ)
ΠΠΎ ΡΡΠ΅ΠΏΠ΅Π½ΠΈ ΠΈΠ½ΡΠΎΠΊΡΠΈΠΊΠ°ΡΠΈΠΈ Π ΠΎΠΆΠ° ΠΏΠΎΠ΄ΡΠ°Π·Π΄Π΅Π»ΡΠ΅ΡΡΡ Π½Π°: Π»Π΅Π³ΠΊΡΡ, ΡΡΠ΅Π΄Π½Π΅ΡΡΠΆΠ΅Π»ΡΡ ΠΈ ΡΡΠΆΠ΅Π»ΡΡ.
ΠΠΎ ΠΊΡΠ°ΡΠ½ΠΎΡΡΠΈ Π²ΠΎΠ·Π½ΠΈΠΊΠ½ΠΎΠ²Π΅Π½ΠΈΡ Π ΠΎΠΆΠ° ΠΏΠΎΠ΄ΡΠ°Π·Π΄Π΅Π»ΡΠ΅ΡΡΡ Π½Π°: ΠΏΠ΅ΡΠ²ΠΈΡΠ½ΡΡ, ΡΠ΅ΡΠΈΠ΄ΠΈΠ²ΠΈΡΡΡΡΡΡ ΠΈ ΠΏΠΎΠ²ΡΠΎΡΠ½ΡΡ.
ΠΠΎ ΡΠ°ΡΠΏΡΠΎΡΡΡΠ°Π½Π΅Π½Π½ΠΎΡΡΠΈ ΠΌΠ΅ΡΡΠ½ΡΡ ΠΏΠΎΡΠ°ΠΆΠ΅Π½ΠΈΠΉ Π ΠΎΠΆΠ° ΠΏΠΎΠ΄ΡΠ°Π·Π΄Π΅Π»ΡΠ΅ΡΡΡ Π½Π°:
β ΠΠΎΠΊΠ°Π»ΠΈΠ·ΠΎΠ²Π°Π½Π½ΡΡ (Π³ΠΎΠ»ΠΎΠ²Π°, ΡΠΏΠΈΠ½Π°, Π»ΠΈΡΠΎ ΠΈ ΠΏΡ.)
β ΠΠ»ΡΠΆΠ΄Π°ΡΡΡΡ (ΠΏΠ΅ΡΠ΅Ρ ΠΎΠ΄ΠΈΡ Ρ ΠΎΠ΄Π½ΠΎΠ³ΠΎ Π½Π° Π΄ΡΡΠ³ΠΎΠ΅ ΠΌΠ΅ΡΡΠΎ)
β ΠΠ΅ΡΠ°ΡΡΠ°ΡΠΈΡΠ΅ΡΠΊΡΡ
ΠΡΠΈΡΠ΅ΠΌΠ°ΡΠΎΠ·Π½Π°Ρ ΡΠΎΡΠΌΠ° Π ΠΎΠΆΠΈ
ΠΠΎΡΠ°ΠΆΠ΅Π½Π½ΡΠΉ ΡΡΠ°ΡΡΠΎΠΊ ΠΊΠΎΠΆΠ½ΡΡ ΠΏΠΎΠΊΡΠΎΠ²ΠΎΠ² Ρ Π°ΡΠ°ΠΊΡΠ΅ΡΠΈΠ·ΡΠ΅ΡΡΡ ΠΏΠΎΠΊΡΠ°ΡΠ½Π΅Π½ΠΈΠ΅ΠΌ (ΡΡΠΈΡΠ΅ΠΌΠΎΠΉ), Π±ΠΎΠ»Π΅Π·Π½Π΅Π½Π½ΠΎΡΡΡΡ ΠΈ ΠΎΡΠ΅ΠΊΠΎΠΌ. ΠΠΎΠΊΡΠ°ΡΠ½Π΅Π½ΠΈΠ΅ ΠΏΡΠΈ ΡΡΠΎΠΌ ΠΈΠΌΠ΅Π΅Ρ ΡΠ°Π²Π½ΠΎΠΌΠ΅ΡΠ½ΡΡ ΡΡΠΊΡΡ ΠΎΠΊΡΠ°ΡΠΊΡ, ΡΠ΅ΡΠΊΠΈΠ΅ Π³ΡΠ°Π½ΠΈΡΡ ΠΈ ΡΠΊΠ»ΠΎΠ½Π½ΠΎ ΠΊ ΠΏΠ΅ΡΠΈΡΠ΅ΡΠΈΡΠ΅ΡΠΊΠΎΠΌΡ ΡΠ°ΡΠΏΡΠΎΡΡΡΠ°Π½Π΅Π½ΠΈΡ. ΠΠΎΡΠ°ΠΆΠ΅Π½Π½Π°Ρ ΠΎΠ±Π»Π°ΡΡΡ Π²ΠΎΠ·Π²ΡΡΠ°Π΅ΡΡΡ Π½Π°Π΄ ΠΊΠΎΠΆΠ΅ΠΉ ΠΈ ΠΈΠΌΠ΅Π΅Ρ ΠΊΡΠ°Ρ Π½Π΅ΠΏΡΠ°Π²ΠΈΠ»ΡΠ½ΠΎΠΉ ΡΠΎΡΠΌΡ
ΠΡΠΈΡΠ΅ΠΌΠ°ΡΠΎΠ·Π½ΠΎ-Π³Π΅ΠΌΠΎΡΡΠ°Π³ΠΈΡΠ΅ΡΠΊΠ°Ρ ΡΠΎΡΠΌΠ° Π ΠΎΠΆΠΈ
ΠΠ°Π½Π½Π°Ρ ΡΠΎΡΠΌΠ° Π·Π°Π±ΠΎΠ»Π΅Π²Π°Π½ΠΈΡ ΠΏΡΠΎΡΠ΅ΠΊΠ°Π΅Ρ ΠΏΡΠ°ΠΊΡΠΈΡΠ΅ΡΠΊΠΈ Ρ ΡΠ΅ΠΌΠΈ ΠΆΠ΅ ΠΏΡΠΎΡΠ²Π»Π΅Π½ΠΈΡΠΌΠΈ ΡΡΠΎ ΠΈ ΡΡΠΈΡΠ΅ΠΌΠ°ΡΠΎΠ·Π½Π°Ρ ΡΠΎΡΠΌΠ°, Π·Π° ΠΈΡΠΊΠ»ΡΡΠ΅Π½ΠΈΠ΅ΠΌ ΡΠΎΠ³ΠΎ, ΡΡΠΎ Π² ΠΎΡΠ΄Π΅Π»ΡΠ½ΡΡ ΡΠ»ΡΡΠ°ΡΡ Π½Π° ΠΌΠ΅ΡΡΠ΅ ΡΡΠΈΡΠ΅ΠΌΡ ΠΌΠΎΠ³ΡΡ Π½Π°Π±Π»ΡΠ΄Π°ΡΡΡΡ ΠΊΡΠΎΠ²ΠΎΠΈΠ·Π»ΠΈΡΠ½ΠΈΡ Π² ΠΏΠΎΡΠ°ΠΆΠ΅Π½Π½ΡΠ΅ Π·Π°Π±ΠΎΠ»Π΅Π²Π°Π½ΠΈΠ΅ΠΌ ΡΡΠ°ΡΡΠΊΠΈ ΠΊΠΎΠΆΠΈ
ΠΡΠΈΡΠ΅ΠΌΠ°ΡΠΎΠ·Π½ΠΎ-Π±ΡΠ»Π»Π΅Π·Π½Π°Ρ ΡΠΎΡΠΌΠ° Π ΠΎΠΆΠΈ
ΠΡΠ° ΡΠΎΡΠΌΠ° Π·Π°Π±ΠΎΠ»Π΅Π²Π°Π½ΠΈΡ Π½Π°ΡΠΈΠ½Π°Π΅ΡΡΡ ΡΠΎΡΠ½ΠΎ ΡΠ°ΠΊ ΠΆΠ΅ ΠΊΠ°ΠΊ ΠΈ ΡΡΠΈΡΠ΅ΠΌΠ°ΡΠΎΠ·Π½Π°Ρ ΡΠΎΡΠΌΠ°, ΠΎΠ΄Π½Π°ΠΊΠΎ Π½Π° ΠΏΡΠΎΡΡΠΆΠ΅Π½ΠΈΠΈ ΡΡΠ΅Ρ ΡΡΡΠΎΠΊ Ρ ΠΌΠΎΠΌΠ΅Π½ΡΠ° ΠΏΠΎΡΠ°ΠΆΠ΅Π½ΠΈΡ β Π½Π° ΠΌΠ΅ΡΡΠ΅ ΡΡΠΈΡΠ΅ΠΌΡ Π²ΠΎΠ·Π½ΠΈΠΊΠ°Π΅Ρ ΠΎΡΡΠ»ΠΎΠ΅Π½ΠΈΠ΅ Π²Π΅ΡΡ Π½Π΅Π³ΠΎ ΡΠ»ΠΎΡ ΠΊΠΎΠΆΠΈ ΠΈ Π½Π° ΡΡΠΎΠΌ ΠΌΠ΅ΡΡΠ΅ ΠΎΠ±ΡΠ°Π·ΡΡΡΡΡ Π·Π°ΠΏΠΎΠ»Π½Π΅Π½Π½ΡΠ΅ ΠΏΡΠΎΠ·ΡΠ°ΡΠ½ΡΠΌ ΡΠΎΠ΄Π΅ΡΠΆΠΈΠΌΡΠΌ ΡΠ°Π·Π»ΠΈΡΠ½ΡΡ ΡΠ°Π·ΠΌΠ΅ΡΠΎΠ² ΠΏΡΠ·ΡΡΠΈ. Π ΠΏΠΎΡΠ»Π΅Π΄ΡΡΠ²ΠΈΠΈ ΡΡΠΈ ΠΏΡΠ·ΡΡΠΈ Π»ΠΎΠΏΠ°ΡΡΡΡ ΠΈ Π½Π° ΠΌΠ΅ΡΡΠ°Ρ ΠΈΡ Π½Π°Ρ ΠΎΠΆΠ΄Π΅Π½ΠΈΡ ΠΎΠ±ΡΠ°Π·ΡΡΡΡΡ ΠΊΠΎΡΠΊΠΈ ΠΊΠΎΡΠΈΡΠ½Π΅Π²Π°ΡΠΎΠ³ΠΎ ΡΠ²Π΅ΡΠ°. Π Π½Π΅ΠΊΠΎΡΠΎΡΡΡ ΡΠ»ΡΡΠ°ΡΡ Π½Π° ΠΌΠ΅ΡΡΠ°Ρ ΠΏΡΠ·ΡΡΠ΅ΠΉ Π²ΠΎΠ·Π½ΠΈΠΊΠ°ΡΡ ΡΡΠΎΠ·ΠΈΠΈ, ΠΊΠΎΡΠΎΡΡΠ΅ Π²ΠΏΠΎΡΠ»Π΅Π΄ΡΡΠ²ΠΈΠΈ ΠΌΠΎΠ³ΡΡ ΡΡΠ°Π½ΡΡΠΎΡΠΌΠΈΡΠΎΠ²Π°ΡΡΡΡ Π² ΡΡΠΎΡΠΈΡΠ΅ΡΠΊΠΈΠ΅ ΡΠ·Π²Ρ
ΠΡΠ»Π»Π΅Π·Π½ΠΎ-Π³Π΅ΠΌΠΎΡΡΠ°Π³ΠΈΡΠ΅ΡΠΊΠ°Ρ ΡΠΎΡΠΌΠ° Π ΠΎΠΆΠΈ
ΠΡΠ° ΡΠΎΡΠΌΠ° ΠΏΠΎ ΡΠ²ΠΎΠΈΠΌ ΠΏΡΠΎΡΠ²Π»Π΅Π½ΠΈΡΠΌ ΠΏΡΠ°ΠΊΡΠΈΡΠ΅ΡΠΊΠΈ ΠΏΠΎΠ»Π½ΠΎΡΡΡΡ ΡΡ ΠΎΠΆΠ° Π½Π° ΡΡΠΈΡΠ΅ΠΌΠ°ΡΠΎΠ·Π½ΠΎ-Π±ΡΠ»Π»Π΅Π·Π½ΡΡ ΡΠΎΡΠΌΡ, Π·Π° ΡΠ΅ΠΌ Π»ΠΈΡΡ ΠΎΡΠ»ΠΈΡΠΈΠ΅ΠΌ, ΡΡΠΎ ΠΏΡΠ·ΡΡΠΈ Π½Π° ΠΌΠ΅ΡΡΠ΅ ΡΡΠΈΡΠ΅ΠΌΡ Π·Π°ΠΏΠΎΠ»Π½Π΅Π½Ρ ΠΊΡΠΎΠ²ΡΠ½ΠΈΡΡΡΠΌ (Π³Π΅ΠΌΠΎΡΡΠ°Π³ΠΈΡΠ΅ΡΠΊΠΈΠΌ), Π° Π½Π΅ ΠΏΡΠΎΠ·ΡΠ°ΡΠ½ΡΠΌ ΡΠΎΠ΄Π΅ΡΠΆΠΈΠΌΡΠΌ
ΠΠ΅ΡΠ²ΠΈΡΠ½Π°Ρ Π ΠΎΠΆΠ° ΡΠ°ΡΠ΅ Π²ΡΠ΅Π³ΠΎ Π»ΠΎΠΊΠ°Π»ΠΈΠ·ΡΠ΅ΡΡΡ Π½Π° Π»ΠΈΡΠ΅, Π° ΡΠ΅ΡΠΈΠ΄ΠΈΠ²ΠΈΡΡΡΡΠ°Ρ β Π½Π° Π½ΠΈΠΆΠ½ΠΈΡ ΠΊΠΎΠ½Π΅ΡΠ½ΠΎΡΡΡΡ .
Π Π΅ΡΠΈΠ΄ΠΈΠ²ΠΈΡΡΡΡΠ΅ΠΉ Π ΠΎΠΆΠ° ΡΡΠΈΡΠ°Π΅ΡΡΡ Π² ΡΠ»ΡΡΠ°Π΅ Π΅Π΅ ΠΏΠΎΠ²ΡΠΎΡΠ½ΠΎΠ³ΠΎ ΠΏΠΎΡΠ²Π»Π΅Π½ΠΈΡ Π½Π° ΠΏΡΠΎΡΡΠΆΠ΅Π½ΠΈΠΈ Π΄Π²ΡΡ Π»Π΅Ρ Π½Π° ΡΡΠ°ΡΡΠΊΠ΅ ΠΏΠ΅ΡΠ²ΠΎΠ½Π°ΡΠ°Π»ΡΠ½ΠΎΠ³ΠΎ ΠΏΠΎΡΠ°ΠΆΠ΅Π½ΠΈΡ. ΠΠΎΠ·Π½ΠΈΠΊΠ°Π΅Ρ Π²ΡΠ»Π΅Π΄ΡΡΠ²ΠΈΠ΅ Π½Π΅Π°Π΄Π΅ΠΊΠ²Π°ΡΠ½ΠΎΠ³ΠΎ Π»Π΅ΡΠ΅Π½ΠΈΡ ΠΈΠ» ΠΆΠ΅ Π½Π°Π»ΠΈΡΠΈΡ Π² ΠΎΡΠ³Π°Π½ΠΈΠ·ΠΌΠ΅ ΠΏΡΠΎΠ²ΠΎΡΠΈΡΡΡΡΠΈΡ ΡΠΎΠΏΡΡΡΡΠ²ΡΡΡΠΈΡ Π·Π°Π±ΠΎΠ»Π΅Π²Π°Π½ΠΈΠΉ (ΠΌΠΈΠΊΠΎΠ·Ρ, ΡΠ°Ρ Π°ΡΠ½ΡΠΉ Π΄ΠΈΠ°Π±Π΅Ρ, ΡΠΈΠ½ΡΡΠΈΡΡ, Π²Π°ΡΠΈΠΊΠΎΠ·Π½Π°Ρ Π±ΠΎΠ»Π΅Π·Π½Ρ Π²Π΅Π½, Ρ ΡΠΎΠ½ΠΈΡΠ΅ΡΠΊΠΈΠ΅ ΡΠΎΠ½Π·ΠΈΠ»Π»ΠΈΡΡ ΠΈ ΠΏΡ.).
ΠΠΎΠ²ΡΠΎΡΠ½Π°Ρ Π ΠΎΠΆΠ° ΡΠ°Π·Π²ΠΈΠ²Π°Π΅ΡΡΡ ΡΠ΅ΡΠ΅Π· Π΄Π²Π° (ΠΈ Π±ΠΎΠ»Π΅Π΅) Π³ΠΎΠ΄Π° ΠΏΠΎΡΠ»Π΅ ΠΏΡΠ΅Π΄ΡΠ΄ΡΡΠ΅Π³ΠΎ Π·Π°Π±ΠΎΠ»Π΅Π²Π°Π½ΠΈΡ
ΠΠ΅ΡΠ΅Π½ΠΈΠ΅
ΠΠ΅ΡΠ΅Π½ΠΈΠ΅ ΡΡΠΎΠ³ΠΎ Π·Π°Π±ΠΎΠ»Π΅Π²Π°Π½ΠΈΡ Π½Π°ΠΏΡΡΠΌΡΡ Π·Π°Π²ΠΈΡΠΈΡ ΠΎΡ ΡΠΎΡΠΌΡ ΠΈ ΠΊΡΠ°ΡΠ½ΠΎΡΡΠΈ Π±ΠΎΠ»Π΅Π·Π½ΠΈ, ΡΡΠ΅ΠΏΠ΅Π½ΠΈ ΠΈΠ½ΡΠΎΠΊΡΠΈΠΊΠ°ΡΠΈΠΈ ΠΈ Π½Π°Π»ΠΈΡΠΈΡ ΠΎΡΠ»ΠΎΠΆΠ½Π΅Π½ΠΈΠΉ. ΠΠΎΠ»ΡΡΠΈΠ½ΡΡΠ²ΠΎ Π±ΠΎΠ»ΡΠ½ΡΡ Ρ Π»Π΅Π³ΠΊΠΎΠΉ ΠΈ ΡΡΠ΅Π΄Π½Π΅ΡΡΠΆΠ΅Π»ΠΎΠΉ ΡΠΎΡΠΌΠΎΠΉ Π ΠΎΠΆΠΈ Π»Π΅ΡΠ°ΡΡΡ Π² ΠΏΠΎΠ»ΠΈΠΊΠ»ΠΈΠ½ΠΈΡΠ΅ΡΠΊΠΈΡ ΡΡΠ»ΠΎΠ²ΠΈΡΡ . Π ΠΎΠ±ΡΠ·Π°ΡΠ΅Π»ΡΠ½ΠΎΠΉ Π³ΠΎΡΠΏΠΈΡΠ°Π»ΠΈΠ·Π°ΡΠΈΠΈ Π² ΠΈΠ½ΡΠ΅ΠΊΡΠΈΠΎΠ½Π½ΠΎΠ΅ ΠΎΡΠ΄Π΅Π»Π΅Π½ΠΈΠ΅ Π½ΡΠΆΠ΄Π°ΡΡΡΡ ΠΏΠ°ΡΠΈΠ΅Π½ΡΡ Ρ ΡΠ°ΠΊΠΈΠΌΠΈ ΠΏΠΎΠΊΠ°Π·Π°Π½ΠΈΡΠΌΠΈ:
β ΠΠ΅ΡΡΠΊΠΈΠΉ ΠΈΠ»ΠΈ ΡΡΠ°ΡΡΠ΅ΡΠΊΠΈΠΉ Π²ΠΎΠ·ΡΠ°ΡΡ
β ΠΠ°Π»ΠΈΡΠΈΠ΅ ΡΠΎΠΏΡΡΡΡΠ²ΡΡΡΠΈΡ ΡΡΠΆΠ΅Π»ΡΡ Π·Π°Π±ΠΎΠ»Π΅Π²Π°Π½ΠΈΠΉ
β Π’ΡΠΆΠ΅Π»ΠΎΠ΅ ΡΠ΅ΡΠ΅Π½ΠΈΠ΅ Π·Π°Π±ΠΎΠ»Π΅Π²Π°Π½ΠΈΡ
β Π§Π°ΡΡΠΎ ΠΏΠΎΠ²ΡΠΎΡΡΡΡΠΈΠ΅ΡΡ ΡΠ΅ΡΠΈΠ΄ΠΈΠ²Ρ
Π ΠΊΠΎΠΌΠΏΠ»Π΅ΠΊΡΠ½ΠΎΠΌ Π»Π΅ΡΠ΅Π½ΠΈΠΈ ΠΏΠ°ΡΠΈΠ΅Π½ΡΠΎΠ² Π² Π΄ΠΈΠ°Π³Π½ΠΎΠ·ΠΎΠΌ Π ΠΎΠΆΠ° Π²Π°ΠΆΠ½Π΅ΠΉΡΠ΅Π΅ ΠΌΠ΅ΡΡΠΎ Π·Π°Π½ΠΈΠΌΠ°Π΅Ρ ΠΏΡΠΎΡΠΈΠ²ΠΎΠΌΠΈΠΊΡΠΎΠ±Π½Π°Ρ ΡΠ΅ΡΠ°ΠΏΠΈΡ. ΠΡΠΈ Π»Π΅ΡΠ΅Π½ΠΈΠΈ Π² ΠΏΠΎΠ»ΠΈΠΊΠ»ΠΈΠ½ΠΈΡΠ΅ΡΠΊΠΈΡ ΡΡΠ»ΠΎΠ²ΠΈΡΡ Π½Π°Π·Π½Π°ΡΠ°ΡΡΡΡ ΡΠ°Π±Π»Π΅ΡΠΈΡΠΎΠ²Π°Π½Π½ΡΠ΅ Π°Π½ΡΠΈΠ±ΠΈΠΎΡΠΈΠΊΠΈ:
β ΠΠ»Π΅ΡΠ΅ΡΡΠΈΠ½, Π΄ΠΎΠΊΡΠΈΡΠΈΠΊΠ»ΠΈΠ½, ΡΠΏΠΈΡΠ°ΠΌΠΈΡΠΈΠ½, ΡΡΠΈΡΡΠΎΠΌΠΈΡΠΈΠ½ (ΠΊΡΡΡ ΠΎΡ 7 Π΄ΠΎ 10 Π΄Π½Π΅ΠΉ)
β Π¦ΠΈΠΏΡΠΎΡΠ»ΠΎΠΊΡΠ°ΡΠΈΠ½ (ΠΊΡΡΡ ΠΎΡ 5 Π΄ΠΎ 7 Π΄Π½Π΅ΠΉ)
β ΠΠ·ΠΈΡΡΠΎΠΌΠΈΡΠΈΠ½
β Π ΠΈΡΠ°ΠΌΠΏΠΈΡΠΈΠ½ (ΠΊΡΡΡ ΠΎΡ 7 Π΄ΠΎ 10 Π΄Π½Π΅ΠΉ)
Π ΡΡΠ»ΠΎΠ²ΠΈΡΡ ΡΡΠ°ΡΠΈΠΎΠ½Π°ΡΠ°, Π»Π΅ΡΠ΅Π½ΠΈΠ΅ Π ΠΎΠΆΠΈ ΠΏΡΠΎΠ²ΠΎΠ΄ΠΈΡΡΡ Π±Π΅Π½Π·ΠΈΠ»ΠΏΠ΅Π½ΠΈΡΠΈΠ»Π»ΠΈΠ½ΠΎΠΌ ΠΊΡΡΡΠΎΠΌ ΠΎΡ 7 Π΄ΠΎ 10 Π΄Π½Π΅ΠΉ. Π ΡΠ»ΡΡΠ°Π΅ ΡΡΠΆΠ΅Π»ΠΎΠ³ΠΎ ΡΠ΅ΡΠ΅Π½ΠΈΡ Π·Π°Π±ΠΎΠ»Π΅Π²Π°Π½ΠΈΡ ΠΈ ΡΠ°Π·Π²ΠΈΡΠΈΡ ΠΎΡΠ»ΠΎΠΆΠ½Π΅Π½ΠΈΠΉ Π²ΠΎΠ·ΠΌΠΎΠΆΠ½ΠΎ ΡΠΎΡΠ΅ΡΠ°Π½ΠΈΠ΅ Π±Π΅Π½Π·ΠΈΠ»ΠΏΠ΅Π½ΠΈΡΠΈΠ»Π»ΠΈΠ½Π° ΠΈ Π³Π΅Π½ΡΠ°ΠΌΠΈΡΠΈΠ½Π°, Π° ΡΠ°ΠΊΠΆΠ΅ Π½Π°Π·Π½Π°ΡΠ΅Π½ΠΈΠ΅ ΡΠ΅ΡΠ°Π»ΠΎΡΠΏΠΎΡΠΈΠ½ΠΎΠ².
ΠΠΎΠ»ΡΠ½ΡΠΌ Π ΠΎΠΆΠ΅ΠΉ Π½Π°Π·Π½Π°ΡΠ°Π΅ΡΡΡ ΠΊΠΎΠΌΠΏΠ»Π΅ΠΊΡΠ½ΡΠΉ ΠΏΡΠΈΠ΅ΠΌ Π²ΠΈΡΠ°ΠΌΠΈΠ½ΠΎΠ² Π½Π° ΠΏΡΠΎΡΡΠΆΠ΅Π½ΠΈΠΈ ΠΎΡ Π΄Π²ΡΡ Π΄ΠΎ ΡΠ΅ΡΡΡΠ΅Ρ Π½Π΅Π΄Π΅Π»Ρ. ΠΡΠΈ ΡΡΠΆΠ΅Π»ΠΎΠΌ ΡΠ΅ΡΠ΅Π½ΠΈΠΈ Π±ΠΎΠ»Π΅Π·Π½ΠΈ ΠΏΡΠΎΠ²ΠΎΠ΄ΠΈΡΡΡ Π΄Π΅Π·ΠΈΠ½ΡΠΎΠΊΡΠΈΠΊΠ°ΡΠΈΠΎΠ½Π½Π°Ρ Π²Π½ΡΡΡΠΈΠ²Π΅Π½Π½Π°Ρ ΡΠ΅ΡΠ°ΠΏΠΈΡ (ΡΠΈΠ·ΠΈΠΎΠ»ΠΎΠ³ΠΈΡΠ΅ΡΠΊΠΈΠΉ ΡΠ°ΡΡΠ²ΠΎΡ + Π³Π΅ΠΌΠΎΠ΄Π΅Π· + 5% ΡΠ°ΡΡΠ²ΠΎΡ Π³Π»ΡΠΊΠΎΠ·Ρ + ΡΠ΅ΠΎΠΏΠΎΠ»ΠΈΠ³Π»ΡΠΊΠΈΠ½ + 5-10 ΠΌΠ» 5% ΡΠ°ΡΡΠ²ΠΎΡ Π°ΡΠΊΠΎΡΠ±ΠΈΠ½ΠΎΠ²ΠΎΠΉ ΠΊΠΈΡΠ»ΠΎΡΡ). Π’Π°ΠΊΠΆΠ΅ Π½Π°Π·Π½Π°ΡΠ°ΡΡΡΡ ΠΆΠ°ΡΠΎΠΏΠΎΠ½ΠΈΠΆΠ°ΡΡΠΈΠ΅, ΡΠ΅ΡΠ΄Π΅ΡΠ½ΠΎ β ΡΠΎΡΡΠ΄ΠΈΡΡΡΠ΅ ΠΈ ΠΌΠΎΡΠ΅Π³ΠΎΠ½Π½ΡΠ΅ ΡΡΠ΅Π΄ΡΡΠ²Π°.
ΠΠΎ Π²ΡΠ΅ΠΌΡ ΠΎΡΡΡΠΎΠ³ΠΎ ΠΏΠ΅ΡΠΈΠΎΠ΄Π° Π½Π° ΠΏΠΎΡΠ°ΠΆΠ΅Π½Π½ΡΠ΅ Π²ΠΎΡΠΏΠ°Π»Π΅Π½ΠΈΠ΅ΠΌ ΠΌΠ΅ΡΡΠ° Π½Π°Π·Π½Π°ΡΠ°ΡΡΡΡ Π£Π€Π ΠΈ Π£ΠΠ§ Ρ ΠΏΠΎΡΠ»Π΅Π΄ΡΡΡΠΈΠΌ ΠΏΡΠΈΠΌΠ΅Π½Π΅Π½ΠΈΠ΅ΠΌ Π½Π°ΡΡΠ°Π»Π°Π½Π° ΠΈΠ»ΠΈ ΠΏΠ°ΡΠ°ΡΠΈΠ½Π° (ΠΎΠ·ΠΎΠΊΠ΅ΡΠΈΡΠ°).
ΠΠ΅ΡΡΠ½ΠΎΠ΅ Π»Π΅ΡΠ΅Π½ΠΈΠ΅ ΠΏΡΠΎΠ²ΠΎΠ΄ΠΈΡΡΡ Π»ΠΈΡΡ ΠΏΡΠΈ Π±ΡΠ»Π»Π΅Π·Π½ΠΎΠΉ ΡΠΎΡΠΌΠ΅ Π ΠΎΠΆΠΈ. Π£ ΠΎΠ΄Π½ΠΎΠ³ΠΎ ΠΈΠ· ΠΊΡΠ°Π΅Π² Π±ΡΠ»Π»Π° Π½Π°Π΄ΡΠ΅Π·Π°Π΅ΡΡΡ ΠΈ Π½Π° ΠΎΡΠ°Π³ Π²ΠΎΡΠΏΠ°Π»Π΅Π½ΠΈΡ ΠΏΡΠΈΠΊΠ»Π°Π΄ΡΠ²Π°ΡΡΡΡ ΠΏΠΎΠ²ΡΠ·ΠΊΠΈ Ρ ΡΠ°ΡΡΠ²ΠΎΡΠΎΠΌ ΡΡΡΠ°ΡΠΈΠ»ΠΈΠ½Π° ΠΈΠ»ΠΈ ΡΠΈΠ²Π°Π½ΠΎΠ»Π°. Π ΠΏΠΎΡΠ»Π΅Π΄ΡΡΡΠ΅ΠΌ Π½Π°Π·Π½Π°ΡΠ°ΡΡΡΡ ΠΌΠ°ΡΠ³Π°Π½ΡΠ΅Π²ΠΎ β Π²Π°Π·Π΅Π»ΠΈΠ½ΠΎΠ²ΡΠ΅ ΠΏΠΎΠ²ΡΠ·ΠΊΠΈ, Π° ΡΠ°ΠΊΠΆΠ΅ ΠΏΠΎΠ²ΡΠ·ΠΊΠΈ Ρ Π±Π°Π»ΡΠ·Π°ΠΌΠΎΠΌ Π¨ΠΎΡΡΠ°ΠΊΠΎΠ²ΡΠΊΠΎΠ³ΠΎ ΠΈΠ»ΠΈ Ρ ΡΠΊΡΠ΅ΡΠΈΡΠΈΠ½ΠΎΠΌ. ΠΠ΅ΡΡΠ½ΠΎΠ΅ Π»Π΅ΡΠ΅Π½ΠΈΠ΅ ΡΠ»Π΅Π΄ΡΠ΅Ρ ΡΠ΅ΡΠ΅Π΄ΠΎΠ²Π°ΡΡ Ρ ΡΠΈΠ·ΠΈΠΎΡΠ΅ΡΠ°ΠΏΠ΅Π²ΡΠΈΡΠ΅ΡΠΊΠΈΠΌΠΈ ΠΏΡΠΎΡΠ΅Π΄ΡΡΠ°ΠΌΠΈ.
vlanamed.com
Π ΠΎΠΆΠ° — ΡΡΠΎ… Π§ΡΠΎ ΡΠ°ΠΊΠΎΠ΅ Π ΠΎΠΆΠ°?
ΠΈΠ½ΡΠ΅ΠΊΡΠΈΠΎΠ½Π½Π°Ρ Π±ΠΎΠ»Π΅Π·Π½Ρ, Ρ Π°ΡΠ°ΠΊΡΠ΅ΡΠΈΠ·ΡΡΡΠ°ΡΡΡ ΠΎΡΠ°Π³ΠΎΠ²ΡΠΌ ΡΠ΅ΡΠΎΠ·Π½ΡΠΌ ΠΈΠ»ΠΈ ΡΠ΅ΡΠΎΠ·Π½ΠΎ-Π³Π΅ΠΌΠΎΡΡΠ°Π³ΠΈΡΠ΅ΡΠΊΠΈΠΌ Π²ΠΎΡΠΏΠ°Π»Π΅Π½ΠΈΠ΅ΠΌ ΠΊΠΎΠΆΠΈ, Π»ΠΈΡ ΠΎΡΠ°Π΄ΠΊΠΎΠΉ ΠΈ ΠΈΠ½ΡΠΎΠΊΡΠΈΠΊΠ°ΡΠΈΠ΅ΠΉ. Π ΠΎΠΆΠ° ΡΠ°ΡΠΏΡΠΎΡΡΡΠ°Π½Π΅Π½Π° ΠΏΠΎΠ²ΡΠ΅ΠΌΠ΅ΡΡΠ½ΠΎ. ΠΠ°Π±ΠΎΠ»Π΅Π²Π°Π΅ΠΌΠΎΡΡΡ Π΅Ρ Π² ΡΠ°Π·Π»ΠΈΡΠ½ΡΡ ΠΊΠ»ΠΈΠΌΠ°ΡΠΈΡΠ΅ΡΠΊΠΈΡ Π·ΠΎΠ½Π°Ρ Π½Π°ΡΠ΅ΠΉ ΡΡΡΠ°Π½Ρ ΡΠΎΡΡΠ°Π²Π»ΡΠ΅Ρ 12β20 ΡΠ»ΡΡΠ°Π΅Π² Π½Π° 10 ΡΡΡ. Π½Π°ΡΠ΅Π»Π΅Π½ΠΈΡ Π² Π³ΠΎΠ΄. Π§Π°ΡΠ΅ Π±ΠΎΠ»Π΅ΡΡ ΠΆΠ΅Π½ΡΠΈΠ½Ρ. ΠΡΠΈΠΎΠ»ΠΎΠ³ΠΈΡ. ΠΠΎΠ·Π±ΡΠ΄ΠΈΡΠ΅Π»Ρ ΠΈΠ½ΡΠ΅ΠΊΡΠΈΠΈ β Π±Π΅ΡΠ°-Π³Π΅ΠΌΠΎΠ»ΠΈΡΠΈΡΠ΅ΡΠΊΠΈΠΉ ΡΡΡΠ΅ΠΏΡΠΎΠΊΠΎΠΊΠΊ Π³ΡΡΠΏΠΏΡ Π β Π½Π°Ρ ΠΎΠ΄ΠΈΡΡΡ Π² ΠΎΡΠ³Π°Π½ΠΈΠ·ΠΌΠ΅ Π±ΠΎΠ»ΡΠ½ΡΡ ΠΊΠ°ΠΊ Π² Π±Π°ΠΊΡΠ΅ΡΠΈΠ°Π»ΡΠ½ΠΎΠΉ, ΡΠ°ΠΊ ΠΈ Π² L-ΡΠΎΡΠΌΠ΅. ΠΠΏΠΈΠ΄Π΅ΠΌΠΈΠΎΠ»ΠΎΠ³ΠΈΡ. ΠΡΡΠΎΡΠ½ΠΈΠΊΠΎΠΌ Π²ΠΎΠ·Π±ΡΠ΄ΠΈΡΠ΅Π»Ρ ΠΈΠ½ΡΠ΅ΠΊΡΠΈΠΈ ΠΌΠΎΠΆΠ΅Ρ ΡΠ²Π»ΡΡΡΡΡ Π±ΠΎΠ»ΡΠ½ΠΎΠΉ Π»ΡΠ±ΡΠΌ ΡΡΡΠ΅ΠΏΡΠΎΠΊΠΎΠΊΠΊΠΎΠ²ΡΠΌ Π·Π°Π±ΠΎΠ»Π΅Π²Π°Π½ΠΈΠ΅ΠΌ (Π½Π°ΠΏΡΠΈΠΌΠ΅Ρ, Π°Π½Π³ΠΈΠ½ΠΎΠΉ, ΡΠΊΠ°ΡΠ»Π°ΡΠΈΠ½ΠΎΠΉ) ΠΈ Π½ΠΎΡΠΈΡΠ΅Π»Ρ ΡΡΡΠ΅ΠΏΡΠΎΠΊΠΎΠΊΠΊΠ°. ΠΡΠ½ΠΎΠ²Π½ΠΎΠΉ ΠΏΡΡΡ ΠΏΠ΅ΡΠ΅Π΄Π°ΡΠΈ Π²ΠΎΠ·Π±ΡΠ΄ΠΈΡΠ΅Π»Ρ β ΠΊΠΎΠ½ΡΠ°ΠΊΡΠ½ΠΎ-Π±ΡΡΠΎΠ²ΠΎΠΉ. ΠΠ°ΡΠ°ΠΆΠ΅Π½ΠΈΠ΅ ΠΏΡΠΎΠΈΡΡ ΠΎΠ΄ΠΈΡ ΡΠ΅ΡΠ΅Π· ΠΏΠΎΠ²ΡΠ΅ΠΆΠ΄Π΅Π½Π½ΡΡ ΠΊΠΎΠΆΡ β ΠΎΠ±ΡΡΠ½ΠΎ Π½Π΅Π·Π½Π°ΡΠΈΡΠ΅Π»ΡΠ½ΡΠ΅ ΠΌΠΈΠΊΡΠΎΡΡΠ°Π²ΠΌΡ. ΠΠΎΠΏΠΎΠ»Π½ΠΈΡΠ΅Π»ΡΠ½ΠΎΠ΅ Π·Π½Π°ΡΠ΅Π½ΠΈΠ΅ ΠΈΠΌΠ΅Π΅Ρ Π²ΠΎΠ·Π΄ΡΡΠ½ΠΎ-ΠΊΠ°ΠΏΠ΅Π»ΡΠ½ΡΠΉ ΠΏΡΡΡ ΠΏΠ΅ΡΠ΅Π΄Π°ΡΠΈ (ΠΎΡΠΎΠ±Π΅Π½Π½ΠΎ ΠΏΡΠΈ Π²ΠΎΠ·Π½ΠΈΠΊΠ½ΠΎΠ²Π΅Π½ΠΈΠΈ Π . Π½Π° Π»ΠΈΡΠ΅). ΠΠΎΠ»ΡΠ½ΡΠ΅ ΠΌΠ°Π»ΠΎ Π·Π°ΡΠ°Π·Π½Ρ. ΠΡΠ΅Π΄ΡΠ°ΡΠΏΠΎΠ»Π°Π³Π°ΡΡΠΈΠΌΠΈ ΡΠ°ΠΊΡΠΎΡΠ°ΠΌΠΈ ΡΠ²Π»ΡΡΡΡΡ ΡΡΠΎΠΉΠΊΠΈΠ΅ Π½Π°ΡΡΡΠ΅Π½ΠΈΡ Π»ΠΈΠΌΡΠΎΠΎΠ±ΡΠ°ΡΠ΅Π½ΠΈΡ, Ρ ΡΠΎΠ½ΠΈΡΠ΅ΡΠΊΠ°Ρ Π²Π΅Π½ΠΎΠ·Π½Π°Ρ Π½Π΅Π΄ΠΎΡΡΠ°ΡΠΎΡΠ½ΠΎΡΡΡ, Π³ΡΠΈΠ±ΠΊΠΎΠ²ΡΠ΅ Π·Π°Π±ΠΎΠ»Π΅Π²Π°Π½ΠΈΡ ΠΊΠΎΠΆΠΈ. Π’ΠΈΠΏΠΈΡΠ½Π° Π»Π΅ΡΠ½Π΅-ΠΎΡΠ΅Π½Π½ΡΡ ΡΠ΅Π·ΠΎΠ½Π½ΠΎΡΡΡ. ΠΠ°ΡΠΎΠ³Π΅Π½Π΅Π·. Π Π°Π·Π»ΠΈΡΠ°ΡΡ ΠΏΠ΅ΡΠ²ΠΈΡΠ½ΡΡ, ΠΏΠΎΠ²ΡΠΎΡΠ½ΡΡ (Ρ ΠΈΠ½ΠΎΠΉ Π»ΠΎΠΊΠ°Π»ΠΈΠ·Π°ΡΠΈΠ΅ΠΉ ΠΏΡΠΎΡΠ΅ΡΡΠ°) ΠΈ ΡΠ΅ΡΠΈΠ΄ΠΈΠ²ΠΈΡΡΡΡΡΡ ΡΠΎΠΆΡ. ΠΠ΅ΡΠ²ΠΈΡΠ½Π°Ρ ΠΈ ΠΏΠΎΠ²ΡΠΎΡΠ½Π°Ρ Π . ΡΠ²Π»ΡΠ΅ΡΡΡ ΠΎΡΡΡΠΎΠΉ ΡΡΡΠ΅ΠΏΡΠΎΠΊΠΎΠΊΠΊΠΎΠ²ΠΎΠΉ ΠΈΠ½ΡΠ΅ΠΊΡΠΈΠ΅ΠΉ. Π₯Π°ΡΠ°ΠΊΡΠ΅ΡΠ½Ρ ΡΠΊΠ·ΠΎΠ³Π΅Π½Π½ΡΠΉ Ρ Π°ΡΠ°ΠΊΡΠ΅Ρ Π·Π°ΡΠ°ΠΆΠ΅Π½ΠΈΡ ΠΈ ΡΠΈΠΊΠ»ΠΈΡΠ΅ΡΠΊΠΎΠ΅ ΡΠ΅ΡΠ΅Π½ΠΈΠ΅ ΠΈΠ½ΡΠ΅ΠΊΡΠΈΠΎΠ½Π½ΠΎΠ³ΠΎ ΠΏΡΠΎΡΠ΅ΡΡΠ°. Π‘ΡΡΠ΅ΠΏΡΠΎΠΊΠΎΠΊΠΊΠΈ Π»ΠΎΠΊΠ°Π»ΠΈΠ·ΡΡΡΡΡ Π² Π»ΠΈΠΌΡΠ°ΡΠΈΡΠ΅ΡΠΊΠΈΡ ΠΊΠ°ΠΏΠΈΠ»Π»ΡΡΠ°Ρ ΡΠΎΡΠΎΡΠΊΠΎΠ²ΠΎΠ³ΠΎ ΠΈ ΡΠ΅ΡΡΠ°ΡΠΎΠ³ΠΎ ΡΠ»ΠΎΠ΅Π² Π΄Π΅ΡΠΌΡ, Π³Π΄Π΅ Π²ΠΎΠ·Π½ΠΈΠΊΠ°Π΅Ρ ΠΎΡΠ°Π³ ΠΈΠ½ΡΠ΅ΠΊΡΠΈΠΎΠ½Π½ΠΎ-Π°Π»Π»Π΅ΡΠ³ΠΈΡΠ΅ΡΠΊΠΎΠ³ΠΎ Π²ΠΎΡΠΏΠ°Π»Π΅Π½ΠΈΡ ΠΈΠΌΠ΅ΡΡΠ΅Π³ΠΎ ΡΠ΅ΡΠΎΠ·Π½ΡΠΉ ΠΈΠ»ΠΈ ΡΠ΅ΡΠΎΠ·Π½ΠΎ-Π³Π΅ΠΌΠΎΡΡΠ°Π³ΠΈΡΠ΅ΡΠΊΠΈΠΉ Ρ Π°ΡΠ°ΠΊΡΠ΅Ρ. Π ΡΠ΅Π°Π»ΠΈΠ·Π°ΡΠΈΠΈ Π²ΠΎΡΠΏΠ°Π»Π΅Π½ΠΈΡ ΡΡΡΠ΅ΡΡΠ²Π΅Π½Π½ΡΡ ΡΠΎΠ»Ρ ΠΈΠ³ΡΠ°ΡΡ ΠΈΠΌΠΌΡΠ½ΠΎΠΏΠ°ΡΠΎΠ»ΠΎΠ³ΠΈΡΠ΅ΡΠΊΠΈΠ΅ ΠΏΡΠΎΡΠ΅ΡΡΡ Ρ ΠΎΠ±ΡΠ°Π·ΠΎΠ²Π°Π½ΠΈΠ΅ΠΌ ΠΈΠΌΠΌΡΠ½Π½ΡΡ ΠΊΠΎΠΌΠΏΠ»Π΅ΠΊΡΠΎΠ² Π² Π΄Π΅ΡΠΌΠ΅, Π² Ρ.Ρ. ΠΈ ΠΏΠ΅ΡΠΈΠ²Π°ΡΠΊΡΠ»ΡΡΠ½ΠΎ. Π Π΅ΡΠΈΠ΄ΠΈΠ²ΠΈΡΡΡΡΠ°Ρ Π . ΡΠ²Π»ΡΠ΅ΡΡΡ Ρ ΡΠΎΠ½ΠΈΡΠ΅ΡΠΊΠΎΠΉ ΡΡΡΠ΅ΠΏΡΠΎΠΊΠΎΠΊΠΊΠΎΠ²ΠΎΠΉ ΠΈΠ½ΡΠ΅ΠΊΡΠΈΠ΅ΠΉ, Π΅Π΅ ΡΠ½Π΄ΠΎΠ³Π΅Π½Π½ΡΠ΅ ΠΎΡΠ°Π³ΠΈ ΡΠΎΡΠΌΠΈΡΡΡΡΡΡ Π² ΠΊΠΎΠΆΠ΅ ΠΈ ΡΠ΅Π³ΠΈΠΎΠ½Π°ΡΠ½ΡΡ Π»ΠΈΠΌΡΠ°ΡΠΈΡΠ΅ΡΠΊΠΈΡ ΡΠ·Π»Π°Ρ . ΠΡΠΈ ΡΡΠΎΠΌ Π½Π°Π±Π»ΡΠ΄Π°Π΅ΡΡΡ ΡΠΌΠ΅ΡΠ°Π½Π½ΠΎΠ΅ ΠΈΠ½ΡΠΈΡΠΈΡΠΎΠ²Π°Π½ΠΈΠ΅ ΠΎΡΠ³Π°Π½ΠΈΠ·ΠΌΠ° Π±ΠΎΠ»ΡΠ½ΡΡ Π±Π°ΠΊΡΠ΅ΡΠΈΠ°Π»ΡΠ½ΠΎΠΉ ΠΈ L-ΡΠΎΡΠΌΠΎΠΉ ΡΡΡΠ΅ΠΏΡΠΎΠΊΠΎΠΊΠΊΠ°. L-ΡΠΎΡΠΌΠ° Π΄Π»ΠΈΡΠ΅Π»ΡΠ½ΠΎ ΠΏΠ΅ΡΡΠΈΡΡΠΈΡΡΠ΅Ρ Π² ΠΌΠ΅ΠΆΡΠ΅ΡΠΈΠ΄ΠΈΠ²Π½ΠΎΠΌ ΠΏΠ΅ΡΠΈΠΎΠ΄Π΅ Π±ΠΎΠ»Π΅Π·Π½ΠΈ Π² ΠΌΠ°ΠΊΡΠΎΡΠ°Π³Π°Ρ ΠΊΠΎΠΆΠΈ ΠΈ ΠΎΡΠ³Π°Π½Π°Ρ ΠΌΠ°ΠΊΡΠΎΡΠ°Π³Π°Π»ΡΠ½ΠΎΠΉ ΡΠΈΡΡΠ΅ΠΌΡ. ΠΡΠΌΠ΅ΡΠ°ΡΡΡΡ Π³Π»ΡΠ±ΠΎΠΊΠΎΠ΅ Π½Π°ΡΡΡΠ΅Π½ΠΈΠ΅ ΠΈΠΌΠΌΡΠ½Π½ΠΎΠ³ΠΎ ΡΡΠ°ΡΡΡΠ° Π±ΠΎΠ»ΡΠ½ΡΡ , ΠΈΡ ΡΠ΅Π½ΡΠΈΠ±ΠΈΠ»ΠΈΠ·Π°ΡΠΈΡ ΠΈ Π°ΡΡΠΎΡΠ΅Π½ΡΠΈΠ±ΠΈΠ»ΠΈΠ·Π°ΡΠΈΡ. ΠΠ»ΠΈΠ½ΠΈΡΠ΅ΡΠΊΠ°Ρ ΠΊΠ°ΡΡΠΈΠ½Π°. ΠΠ½ΠΊΡΠ±Π°ΡΠΈΠΎΠ½Π½ΡΠΉ ΠΏΠ΅ΡΠΈΠΎΠ΄ β ΠΎΡ Π½Π΅ΡΠΊΠΎΠ»ΡΠΊΠΈΡ ΡΠ°ΡΠΎΠ² Π΄ΠΎ 3β5 ΡΡΡ. ΠΠΎ Ρ Π°ΡΠ°ΠΊΡΠ΅ΡΡ ΠΌΠ΅ΡΡΠ½ΡΡ ΠΏΡΠΎΡΠ²Π»Π΅Π½ΠΈΠΉ ΡΠ°Π·Π»ΠΈΡΠ°ΡΡ ΡΡΠΈΡΠ΅ΠΌΠ°ΡΠΎΠ·Π½ΡΡ, ΡΡΠΈΡΠ΅ΠΌΠ°ΡΠΎΠ·Π½ΠΎ-Π±ΡΠ»Π»Π΅Π·Π½ΡΡ, ΡΡΠΈΡΠ΅ΠΌΠ°ΡΠΎΠ·Π½ΠΎ-Π³Π΅ΠΌΠΎΡΡΠ°Π³ΠΈΡΠ΅ΡΠΊΡΡ, Π±ΡΠ»Π»Π΅Π·Π½ΠΎ-Π³Π΅ΠΌΠΎΡΡΠ°Π³ΠΈΡΠ΅ΡΠΊΡΡ ΡΠΎΠΆΡ. Π Π·Π°Π²ΠΈΡΠΈΠΌΠΎΡΡΠΈ ΠΎΡ ΡΡΠΆΠ΅ΡΡΠΈ Π·Π°Π±ΠΎΠ»Π΅Π²Π°Π½ΠΈΡ Π²ΡΠ΄Π΅Π»ΡΡΡ Π»Π΅Π³ΠΊΠΎΠ΅ ΡΠ΅ΡΠ΅Π½ΠΈΠ΅, ΡΡΠ΅Π΄Π½Π΅ΡΡΠΆΠ΅Π»ΠΎΠ΅ ΠΈ ΡΡΠΆΠ΅Π»ΠΎΠ΅. Π§Π°ΡΠ΅ ΠΏΡΠΎΡΠ΅ΡΡ Π»ΠΎΠΊΠ°Π»ΠΈΠ·ΡΠ΅ΡΡΡ Π½Π° Π½ΠΈΠΆΠ½ΠΈΡ ΠΊΠΎΠ½Π΅ΡΠ½ΠΎΡΡΡΡ , ΡΠ΅ΠΆΠ΅ β Π½Π° Π»ΠΈΡΠ΅, Π²Π΅ΡΡ Π½ΠΈΡ ΠΊΠΎΠ½Π΅ΡΠ½ΠΎΡΡΡΡ , ΠΎΡΠ΅Π½Ρ ΡΠ΅Π΄ΠΊΠΎ β Π² ΠΎΠ±Π»Π°ΡΡΠΈ ΡΡΠ»ΠΎΠ²ΠΈΡΠ°, ΠΏΠΎΠ»ΠΎΠ²ΡΡ ΠΎΡΠ³Π°Π½ΠΎΠ². ΠΠΎΠ»Π΅Π·Π½Ρ Π½Π°ΡΠΈΠ½Π°Π΅ΡΡΡ ΠΎΡΡΡΠΎ. ΠΡΠΈ Π½Π°ΠΈΠ±ΠΎΠ»Π΅Π΅ ΡΠΈΠΏΠΈΡΠ½ΠΎΠΌ ΡΡΠ΅Π΄Π½Π΅ΡΡΠΆΠ΅Π»ΠΎΠΌ ΡΠ΅ΡΠ΅Π½ΠΈΠΈ Π²ΠΎΠ·Π½ΠΈΠΊΠ°ΡΡ Π³ΠΎΠ»ΠΎΠ²Π½Π°Ρ Π±ΠΎΠ»Ρ, ΡΡΠ²ΡΡΠ²ΠΎ ΠΆΠ°ΡΠ° ΠΎΠ±ΡΠ°Ρ ΡΠ»Π°Π±ΠΎΡΡΡ, ΠΎΠ·Π½ΠΎΠ±, ΠΌΡΡΠ΅ΡΠ½ΡΠ΅ Π±ΠΎΠ»ΠΈ. Π’Π΅ΠΌΠΏΠ΅ΡΠ°ΡΡΡΠ° ΡΠ΅Π»Π° Π·Π° Π½Π΅ΡΠΊΠΎΠ»ΡΠΊΠΎ ΡΠ°ΡΠΎΠ² ΠΏΠΎΠ²ΡΡΠ°Π΅ΡΡΡ Π΄ΠΎ 38β39,5Β°. Π ΡΡΠ΄Π΅ ΡΠ»ΡΡΠ°Π΅Π² Π½Π°Π±Π»ΡΠ΄Π°ΡΡΡΡ ΡΠΎΡΠ½ΠΎΡΠ° ΠΈ ΡΠ²ΠΎΡΠ°. ΠΠΎΠ»Π΅Π΅ ΡΠ΅ΠΌ Ρ ΠΏΠΎΠ»ΠΎΠ²ΠΈΠ½Ρ Π±ΠΎΠ»ΡΠ½ΡΡ ΠΏΠΎΡΠ²Π»Π΅Π½ΠΈΠ΅ ΡΠΈΠΌΠΏΡΠΎΠΌΠΎΠ² ΠΈΠ½ΡΠΎΠΊΡΠΈΠΊΠ°ΡΠΈΠΈ Π½Π° 12β48 Ρ ΠΎΠΏΠ΅ΡΠ΅ΠΆΠ°Π΅Ρ ΡΠ°Π·Π²ΠΈΡΠΈΠ΅ ΠΎΡΠ°Π³Π° Π²ΠΎΡΠΏΠ°Π»Π΅Π½ΠΈΡ, ΠΎΡΠΎΠ±Π΅Π½Π½ΠΎ ΠΏΡΠΈ Π»ΠΎΠΊΠ°Π»ΠΈΠ·Π°ΡΠΈΠΈ ΠΏΡΠΎΡΠ΅ΡΡΠ° Π½Π° Π½ΠΈΠΆΠ½ΠΈΡ ΠΊΠΎΠ½Π΅ΡΠ½ΠΎΡΡΡΡ . ΠΡΠ½ΠΎΠ²Π½ΡΠΌ ΠΏΡΠΈΠ·Π½Π°ΠΊΠΎΠΌ ΡΠΎΠΆΠΈΡΡΠΎΠ³ΠΎ Π²ΠΎΡΠΏΠ°Π»Π΅Π½ΠΈΡ ΡΠ²Π»ΡΠ΅ΡΡΡ ΡΡΠΈΡΠ΅ΠΌΠ° Ρ ΡΠ΅ΡΠΊΠΎ ΠΎΡΠ³ΡΠ°Π½ΠΈΡΠ΅Π½Π½ΡΠΌΠΈ ΠΎΡ Π½Π΅ΠΏΠΎΡΠ°ΠΆΠ΅Π½Π½ΠΎΠΉ ΠΊΠΎΠΆΠΈ Π½Π΅ΡΠΎΠ²Π½ΡΠΌΠΈ ΠΊΡΠ°ΡΠΌΠΈ Π² Π²ΠΈΠ΄Π΅ ΠΈΠ·Π²ΠΈΠ»ΠΈΡΡΠΎΠΉ Π»ΠΈΠ½ΠΈΠΈ, Π΄ΡΠ³ ΠΈ ΡΠ·ΡΠΊΠΎΠ². ΠΠ»Ρ ΡΡΠΈΡΠ΅ΠΌΠ°ΡΠΎΠ·Π½ΠΎΠΉ Π . Ρ Π°ΡΠ°ΠΊΡΠ΅ΡΠ½ΠΎ Π½Π°Π»ΠΈΡΠΈΠ΅ ΠΏΠ΅ΡΠΈΡΠ΅ΡΠΈΡΠ΅ΡΠΊΠΎΠ³ΠΎ Π²Π°Π»ΠΈΠΊΠ° Π² Π²ΠΈΠ΄Π΅ Π²ΠΎΠ·Π²ΡΡΠ°ΡΡΠ΅Π³ΠΎΡΡ ΠΊΡΠ°Ρ ΡΡΠΈΡΠ΅ΠΌΡ. ΠΠΎΠΆΠ° Π² ΠΎΠ±Π»Π°ΡΡΠΈ ΡΡΠΈΡΠ΅ΠΌΡ ΠΈΠ½ΡΠ΅Π½ΡΠΈΠ²Π½ΠΎ Π³ΠΈΠΏΠ΅ΡΠ΅ΠΌΠΈΡΠΎΠ²Π°Π½Π°, ΠΏΡΠΈ ΠΏΠ°Π»ΡΠΏΠ°ΡΠΈΠΈ Π±ΠΎΠ»ΠΈ ΠΎΠ±ΡΡΠ½ΠΎ Π½Π΅Π·Π½Π°ΡΠΈΡΠ΅Π»ΡΠ½Ρ, Π² ΠΎΡΠ½ΠΎΠ²Π½ΠΎΠΌ ΠΏΠΎ ΠΏΠ΅ΡΠΈΡΠ΅ΡΠΈΠΈ ΡΡΠΈΡΠ΅ΠΌΡ. ΠΠΎΠΆΠ° Π½Π°ΠΏΡΡΠΆΠ΅Π½Π°, Π³ΠΎΡΡΡΠ°Ρ Π½Π° ΠΎΡΡΠΏΡ ΠΈΠ½ΡΠΈΠ»ΡΡΡΠΈΡΠΎΠ²Π°Π½Π°. ΠΠ΄Π½ΠΎΠ²ΡΠ΅ΠΌΠ΅Π½Π½ΠΎ Π²ΠΎΠ·Π½ΠΈΠΊΠ°Π΅Ρ ΠΎΡΠ΅ΠΊ ΠΊΠΎΠΆΠΈ, ΡΠ°ΡΠΏΡΠΎΡΡΡΠ°Π½ΡΡΡΠΈΠΉΡΡ Π·Π° ΠΏΡΠ΅Π΄Π΅Π»Ρ ΡΡΠΈΡΠ΅ΠΌΡ (ΡΠΈΡ. 1). ΠΡΠΌΠ΅ΡΠ°Π΅ΡΡΡ ΡΠ΅Π³ΠΈΠΎΠ½Π°ΡΠ½ΡΠΉ Π»ΠΈΠΌΡΠ°Π΄Π΅Π½ΠΈΡ. ΠΡΠΈ ΡΡΠΈΡΠ΅ΠΌΠ°ΡΠΎΠ·Π½ΠΎ-Π±ΡΠ»Π»Π΅Π·Π½ΠΎΠΉ Π . Π½Π° ΡΠΎΠ½Π΅ ΡΡΠΈΡΠ΅ΠΌΡ ΠΏΠΎΡΠ²Π»ΡΡΡΡΡ ΠΏΡΠ·ΡΡΠΈ (Π±ΡΠ»Π»Ρ), ΡΠΎΠ΄Π΅ΡΠΆΠ°ΡΠΈΠ΅ ΠΏΡΠΎΠ·ΡΠ°ΡΠ½ΡΡ ΠΆΠ΅Π»ΡΠΎΠ²Π°ΡΡΡ ΠΆΠΈΠ΄ΠΊΠΎΡΡΡ. ΠΡΠΈ ΡΡΠΈΡΠ΅ΠΌΠ°ΡΠΎΠ·Π½ΠΎ-Π³Π΅ΠΌΠΎΡΡΠ°Π³ΠΈΡΠ΅ΡΠΊΠΎΠΉ Π . Π²ΠΎΠ·Π½ΠΈΠΊΠ°ΡΡ Π³Π΅ΠΌΠΎΡΡΠ°Π³ΠΈΠΈ ΡΠ°Π·Π½ΡΡ ΡΠ°Π·ΠΌΠ΅ΡΠΎΠ² β ΠΎΡ ΠΌΠ΅Π»ΠΊΠΎΡΠΎΡΠ΅ΡΠ½ΡΡ ΠΊΡΠΎΠ²ΠΎΠΈΠ·Π»ΠΈΡΠ½ΠΈΠΉ Π΄ΠΎ ΠΎΠ±ΡΠΈΡΠ½ΡΡ ΠΈ ΡΠ»ΠΈΠ²Π½ΡΡ , ΡΠ°ΡΠΏΡΠΎΡΡΡΠ°Π½ΡΡΡΠΈΡ ΡΡ Π½Π° Π²ΡΡ ΡΡΠΈΡΠ΅ΠΌΡ (ΡΠΈΡ. 2). ΠΡΠ»Π»Π΅Π·Π½ΠΎ-Π³Π΅ΠΌΠΎΡΡΠ°Π³ΠΈΡΠ΅ΡΠΊΠ°Ρ ΡΠΎΠΆΠ° Ρ Π°ΡΠ°ΠΊΡΠ΅ΡΠΈΠ·ΡΠ΅ΡΡΡ Π½Π°Π»ΠΈΡΠΈΠ΅ΠΌ Π³Π΅ΠΌΠΎΡΡΠ°Π³ΠΈΡΠ΅ΡΠΊΠΎΠ³ΠΎ ΠΈ ΡΠΈΠ±ΡΠΈΠ½ΠΎΠ·Π½ΠΎΠ³ΠΎ ΡΠΊΡΡΡΠ΄Π°ΡΠ° Π² ΠΏΡΠ·ΡΡΡΡ (ΡΠΈΡ. 3). ΠΡΠ·ΡΡΠΈ ΠΌΠΎΠ³ΡΡ ΡΠΎΠ΄Π΅ΡΠΆΠ°ΡΡ ΠΈ ΠΏΡΠ΅ΠΈΠΌΡΡΠ΅ΡΡΠ²Π΅Π½Π½ΠΎ ΡΠΈΠ±ΡΠΈΠ½ΠΎΠ·Π½ΡΠΉ ΡΠΊΡΡΡΠ΄Π°Ρ, ΠΈΠΌΠ΅ΡΡ ΡΠΏΠ»ΠΎΡΠ΅Π½Π½ΡΠΉ Ρ Π°ΡΠ°ΠΊΡΠ΅Ρ ΠΈ Π±ΡΡΡ ΠΏΠ»ΠΎΡΠ½ΡΠΌΠΈ ΠΏΡΠΈ ΠΏΠ°Π»ΡΠΏΠ°ΡΠΈΠΈ. ΠΡΠΈ Π»Π΅Π³ΠΊΠΎΠΌ ΡΠ΅ΡΠ΅Π½ΠΈΠΈ Π±ΠΎΠ»Π΅Π·Π½ΠΈ ΡΠ΅ΠΌΠΏΠ΅ΡΠ°ΡΡΡΠ° Π² ΠΏΡΠ΅Π΄Π΅Π»Π°Ρ 38,5Β°, ΡΠΌΠ΅ΡΠ΅Π½Π½Π°Ρ Π³ΠΎΠ»ΠΎΠ²Π½Π°Ρ Π±ΠΎΠ»Ρ. ΠΡΠΈ ΡΡΠΆΠ΅Π»ΠΎΠΌ ΡΠ΅ΡΠ΅Π½ΠΈΠΈ Π±ΠΎΠ»Π΅Π·Π½ΠΈ ΡΠ΅ΠΌΠΏΠ΅ΡΠ°ΡΡΡΠ° Π΄ΠΎΡΡΠΈΠ³Π°Π΅Ρ 40Β° ΠΈ Π²ΡΡΠ΅, ΠΎΡΠΌΠ΅ΡΠ°ΡΡΡΡ ΠΏΠΎΡΡΡΡΠ°ΡΡΠΈΠΉ ΠΎΠ·Π½ΠΎΠ±, ΡΠ²ΠΎΡΠ°, Π±ΡΠ΅Π΄, ΡΠ°ΡΡΡΡΠΎΠΉΡΡΠ²Π° ΡΠΎΠ·Π½Π°Π½ΠΈΡ, ΠΌΠ΅Π½ΠΈΠ½Π³Π΅Π°Π»ΡΠ½ΡΠΉ ΡΠΈΠ½Π΄ΡΠΎΠΌ (ΡΠΌ. ΠΠ΅Π½ΠΈΠ½Π³ΠΈΠ·ΠΌ) Π²ΡΡΠ°ΠΆΠ΅Π½Π½Π°Ρ ΡΠ°Ρ ΠΈΠΊΠ°ΡΠ΄ΠΈΡ, Π³ΠΈΠΏΠΎΡΠΎΠ½ΠΈΡ. ΠΠΈΡ ΠΎΡΠ°Π΄ΠΎΡΠ½ΡΠΉ ΠΏΠ΅ΡΠΈΠΎΠ΄ Ρ Π±ΠΎΠ»ΡΠ½ΡΡ Π . ΠΏΡΠΎΠ΄ΠΎΠ»ΠΆΠ°Π΅ΡΡΡ Π² ΡΡΠ΅Π΄Π½Π΅ΠΌ 4β5 ΡΡΡ. ΠΡΡΡΡΠ΅ Π²ΠΎΡΠΏΠ°Π»ΠΈΡΠ΅Π»ΡΠ½ΡΠ΅ ΠΈΠ·ΠΌΠ΅Π½Π΅Π½ΠΈΡ Π² ΠΎΡΠ°Π³Π΅ ΠΈΡΡΠ΅Π·Π°ΡΡ Π² ΡΡΠΎΠΊΠΈ Π΄ΠΎ 5β7 ΡΡΡ. ΠΏΡΠΈ ΡΡΠΈΡΠ΅ΠΌΠ°ΡΠΎΠ·Π½ΠΎΠΉ ΡΠΎΠΆΠ΅, Π΄ΠΎ 10β12 ΡΡΡ. ΠΈ Π±ΠΎΠ»Π΅Π΅ ΠΏΡΠΈ Π±ΡΠ»Π»Π΅Π·Π½ΠΎ-Π³Π΅ΠΌΠΎΡΡΠ°Π³ΠΈΡΠ΅ΡΠΊΠΎΠΉ ΡΠΎΠΆΠ΅. Π‘ΠΎΡ ΡΠ°Π½ΡΡΡΠΈΠ΅ΡΡ Π²ΠΎ Π²ΡΠ΅ΠΌΡ ΡΠ΅ΠΊΠΎΠ½Π²Π°Π»Π΅ΡΡΠ΅Π½ΡΠΈΠΈ ΡΠ²Π΅Π»ΠΈΡΠ΅Π½Π½ΡΠ΅ ΡΠ΅Π³ΠΈΠΎΠ½Π°ΡΠ½ΡΠ΅ Π»ΠΈΠΌΡΠ°ΡΠΈΡΠ΅ΡΠΊΠΈΠ΅ ΡΠ·Π»Ρ, ΠΈΠ½ΡΠΈΠ»ΡΡΡΠ°ΡΠΈΡ ΠΊΠΎΠΆΠΈ Π½Π° ΠΌΠ΅ΡΡΠ΅ ΠΎΡΠ°Π³Π° Π²ΠΎΡΠΏΠ°Π»Π΅Π½ΠΈΡ, ΡΡΠ±ΡΠ΅Π±ΡΠΈΠ»ΡΠ½Π°Ρ ΡΠ΅ΠΌΠΏΠ΅ΡΠ°ΡΡΡΠ° ΡΠ²Π»ΡΡΡΡΡ ΠΏΡΠΎΠ³Π½ΠΎΡΡΠΈΡΠ΅ΡΠΊΠΈ Π½Π΅Π±Π»Π°Π³ΠΎΠΏΡΠΈΡΡΠ½ΡΠΌΠΈ Π΄Π»Ρ ΡΠ°Π·Π²ΠΈΡΠΈΡ ΡΠ°Π½Π½ΠΈΡ ΡΠ΅ΡΠΈΠ΄ΠΈΠ²ΠΎΠ². ΠΠΎΠ²ΡΠΎΡΠ½Π°Ρ Π . Π²ΠΎΠ·Π½ΠΈΠΊΠ°Π΅Ρ ΡΠΏΡΡΡΡ 2 Π³ΠΎΠ΄Π° ΠΈ Π±ΠΎΠ»Π΅Π΅ ΠΏΠΎΡΠ»Π΅ ΠΏΡΠ΅Π΄ΡΠ΄ΡΡΠ΅Π³ΠΎ Π·Π°Π±ΠΎΠ»Π΅Π²Π°Π½ΠΈΡ ΠΈ ΠΈΠΌΠ΅Π΅Ρ Π΄ΡΡΠ³ΡΡ Π»ΠΎΠΊΠ°Π»ΠΈΠ·Π°ΡΠΈΡ. Π Π΅ΡΠΈΠ΄ΠΈΠ²ΠΈΡΡΡΡΠ°Ρ Π . Π½Π°Π±Π»ΡΠ΄Π°Π΅ΡΡΡ ΠΎΠ±ΡΡΠ½ΠΎ ΠΏΡΠΈ Π»ΠΎΠΊΠ°Π»ΠΈΠ·Π°ΡΠΈΠΈ ΠΎΡΠ°Π³Π° Π²ΠΎΡΠΏΠ°Π»Π΅Π½ΠΈΡ Π½Π° Π½ΠΈΠΆΠ½ΠΈΡ ΠΊΠΎΠ½Π΅ΡΠ½ΠΎΡΡΡΡ . ΠΠ΅ΡΠ΅Ρ ΠΎΠ΄Ρ ΠΏΠ΅ΡΠ²ΠΈΡΠ½ΠΎΠΉ Π . Π² ΡΠ΅ΡΠΈΠ΄ΠΈΠ²ΠΈΡΡΡΡΡΡ ΡΠΏΠΎΡΠΎΠ±ΡΡΠ²ΡΡΡ Ρ ΡΠΎΠ½ΠΈΡΠ΅ΡΠΊΠΈΠ΅ Π·Π°Π±ΠΎΠ»Π΅Π²Π°Π½ΠΈΡ ΠΊΠΎΠΆΠΈ, ΠΎΡΠΎΠ±Π΅Π½Π½ΠΎ Π³ΡΠΈΠ±ΠΊΠΎΠ²ΡΠ΅ (ΡΠΏΠΈΠ΄Π΅ΡΠΌΠΎΡΠΈΡΠΈΡ, ΡΡΠ±ΡΠΎΡΠΈΡΠΈΡ), ΠΏΡΠ΅Π΄ΡΠ΅ΡΡΠ²ΡΡΡΠ°Ρ Π²Π΅Π½ΠΎΠ·Π½Π°Ρ Π½Π΅Π΄ΠΎΡΡΠ°ΡΠΎΡΠ½ΠΎΡΡΡ, Π»ΠΈΠΌΡΠΎΡΡΠ°Π·, Π½Π°Π»ΠΈΡΠΈΠ΅ ΠΎΡΠ°Π³ΠΎΠ² Ρ ΡΠΎΠ½ΠΈΡΠ΅ΡΠΊΠΎΠΉ ΡΡΡΠ΅ΠΏΡΠΎΠΊΠΎΠΊΠΊΠΎΠ²ΠΎΠΉ ΠΈΠ½ΡΠ΅ΠΊΡΠΈΠΈ. Π Π΅ΡΠΈΠ΄ΠΈΠ²Ρ ΡΠ°Π·Π²ΠΈΠ²Π°ΡΡΡΡ Π² ΡΡΠΎΠΊΠΈ ΠΎΡ Π½Π΅ΡΠΊΠΎΠ»ΡΠΊΠΈΡ Π΄Π½Π΅ΠΉ ΠΈ Π½Π΅Π΄Π΅Π»Ρ Π΄ΠΎ 1β2 Π»Π΅Ρ, ΡΠΈΡΠ»ΠΎ ΠΈΡ ΠΌΠΎΠΆΠ΅Ρ Π΄ΠΎΡΡΠΈΠ³Π°ΡΡ Π½Π΅ΡΠΊΠΎΠ»ΡΠΊΠΈΡ Π΄Π΅ΡΡΡΠΊΠΎΠ². Π§Π°ΡΡΡΠ΅ ΡΠ΅ΡΠΈΠ΄ΠΈΠ²Ρ ΠΏΡΠΈΠ²ΠΎΠ΄ΡΡ ΠΊ Π²ΡΡΠ°ΠΆΠ΅Π½Π½ΡΠΌ Π½Π°ΡΡΡΠ΅Π½ΠΈΡΠΌ Π»ΠΈΠΌΡΠΎΠΎΠ±ΡΠ°ΡΠ΅Π½ΠΈΡ. ΠΡΠ»ΠΎΠΆΠ½Π΅Π½ΠΈΡ ΠΎΠ±ΡΡΠ½ΠΎ Π½ΠΎΡΡΡ ΠΌΠ΅ΡΡΠ½ΡΠΉ Ρ Π°ΡΠ°ΠΊΡΠ΅Ρ: Π½Π΅ΠΊΡΠΎΠ·Ρ ΠΊΠΎΠΆΠΈ (ΡΠΈΡ. 4), Π°Π±ΡΡΠ΅ΡΡΡ, ΡΠ»Π΅Π³ΠΌΠΎΠ½Ρ, ΡΡΠΎΠΌΠ±ΠΎΡΠ»Π΅Π±ΠΈΡΡ, Π»ΠΈΠΌΡΠ°Π½Π³ΠΈΠΈΡΡ, ΠΏΠ΅ΡΠΈΠ°Π΄Π΅Π½ΠΈΡΡ (ΡΠΈΡ. 5). ΠΡΠΈ ΡΠΎΠΏΡΡΡΡΠ²ΡΡΡΠΈΡ ΡΡΠΆΠ΅Π»ΡΡ Π·Π°Π±ΠΎΠ»Π΅Π²Π°Π½ΠΈΡΡ ΠΈ ΠΏΠΎΠ·Π΄Π½ΠΎ Π½Π°ΡΠ°ΡΠΎΠΌ Π»Π΅ΡΠ΅Π½ΠΈΠΈ ΠΌΠΎΠΆΠ΅Ρ ΡΠ°Π·Π²ΠΈΡΡΡΡ Π‘Π΅ΠΏΡΠΈΡ, ΠΠ½ΡΠ΅ΠΊΡΠΈΠΎΠ½Π½ΠΎ-ΡΠΎΠΊΡΠΈΡΠ΅ΡΠΊΠΈΠΉ ΡΠΎΠΊ. ΠΡΠΈ ΡΠ°ΡΡΡΡ ΡΠ΅ΡΠΈΠ΄ΠΈΠ²Π°Ρ Π²ΠΎΠ·ΠΌΠΎΠΆΠ½Ρ Π»ΠΈΠΌΡΠ°ΡΠΈΡΠ΅ΡΠΊΠΈΠΉ ΠΎΡΠ΅ΠΊ (Π»ΠΈΠΌΡΠ΅Π΄Π΅ΠΌΠ°) ΠΈ Π²ΡΠΎΡΠΈΡΠ½Π°Ρ Π‘Π»ΠΎΠ½ΠΎΠ²ΠΎΡΡΡ. ΠΠΈΠ°Π³Π½ΠΎΠ· ΡΡΡΠ°Π½Π°Π²Π»ΠΈΠ²Π°ΡΡ Π½Π° ΠΎΡΠ½ΠΎΠ²Π°Π½ΠΈΠΈ ΠΊΠ»ΠΈΠ½ΠΈΡΠ΅ΡΠΊΠΎΠΉ ΠΊΠ°ΡΡΠΈΠ½Ρ. Π ΠΊΡΠΎΠ²ΠΈ Π±ΠΎΠ»ΡΡΠΈΠ½ΡΡΠ²Π° Π±ΠΎΠ»ΡΠ½ΡΡ ΠΎΡΠΌΠ΅ΡΠ°ΡΡΡΡ ΡΠΌΠ΅ΡΠ΅Π½Π½ΡΠΉ Π½Π΅ΠΉΡΡΠΎΡΠΈΠ»ΡΠ½ΡΠΉ Π»Π΅ΠΉΠΊΠΎΡΠΈΡΠΎΠ· Ρ ΠΏΠ°Π»ΠΎΡΠΊΠΎΡΠ΄Π΅ΡΠ½ΡΠΌ ΡΠ΄Π²ΠΈΠ³ΠΎΠΌ, Π½Π΅Π·Π½Π°ΡΠΈΡΠ΅Π»ΡΠ½ΠΎ ΠΏΠΎΠ²ΡΡΠ΅Π½Π½Π°Ρ Π‘ΠΠ. ΠΠΈΡΡΠ΅ΡΠ΅Π½ΡΠΈΠ°Π»ΡΠ½ΡΠΉ Π΄ΠΈΠ°Π³Π½ΠΎΠ· ΠΏΡΠΎΠ²ΠΎΠ΄ΡΡ Ρ ΡΠ»Π΅Π³ΠΌΠΎΠ½ΠΎΠΉ, ΡΡΠΎΠΌΠ±ΠΎΡΠ»Π΅Π±ΠΈΡΠΎΠΌ, ΡΠΊΠ·Π΅ΠΌΠΎΠΉ, Π΄Π΅ΡΠΌΠ°ΡΠΈΡΠΎΠΌ, ΠΎΠΏΠΎΡΡΡΠ²Π°ΡΡΠΈΠΌ Π»ΠΈΡΠ°Π΅ΠΌ, ΡΠ·Π»ΠΎΠ²Π°ΡΠΎΠΉ ΡΡΠΈΡΠ΅ΠΌΠΎΠΉ, ΡΡΠΈΠ·ΠΈΠΏΠ΅Π»ΠΎΠΈΠ΄ΠΎΠΌ, ΠΊΠΎΠΆΠ½ΠΎΠΉ ΡΠΎΡΠΌΠΎΠΉ ΡΠΈΠ±ΠΈΡΡΠΊΠΎΠΉ ΡΠ·Π²Ρ ΠΈ Π΄Ρ. ΠΡΠΈ ΡΠ»Π΅Π³ΠΌΠΎΠ½Π΅ ΠΌΠ°ΠΊΡΠΈΠΌΠ°Π»ΡΠ½Π°Ρ Π³ΠΈΠΏΠ΅ΡΠ΅ΠΌΠΈΡ, ΠΈΠ½ΡΠΈΠ»ΡΡΡΠ°ΡΠΈΡ ΠΈ Π±ΠΎΠ»Π΅Π·Π½Π΅Π½Π½ΠΎΡΡΡ Π½Π°ΠΈΠ±ΠΎΠ»Π΅Π΅ Π²ΡΡΠ°ΠΆΠ΅Π½Ρ Π² ΡΠ΅Π½ΡΡΠ΅ ΠΎΡΠ°Π³Π° ΠΏΠΎΡΠ°ΠΆΠ΅Π½ΠΈΡ, ΠΊΠΎΡΠΎΡΡΠΉ Π½Π΅ ΠΈΠΌΠ΅Π΅Ρ ΡΠ΅ΡΠΊΠΈΡ Π³ΡΠ°Π½ΠΈΡ, ΠΌΠ΅ΡΡΠ½ΡΠ΅ ΡΠΈΠΌΠΏΡΠΎΠΌΡ ΠΏΡΠ΅Π΄ΡΠ΅ΡΡΠ²ΡΡΡ ΠΏΠΎΡΠ²Π»Π΅Π½ΠΈΡ Π»ΠΈΡ ΠΎΡΠ°Π΄ΠΊΠΈ. ΠΡΠΈ ΠΏΠΎΠ²Π΅ΡΡ Π½ΠΎΡΡΠ½ΠΎΠΌ ΡΡΠΎΠΌΠ±ΠΎΡΠ»Π΅Π±ΠΈΡΠ΅ ΠΈΠΌΠ΅ΡΡΡΡ ΠΊΡΠ°ΡΠ½ΡΠ΅ ΠΏΠΎΠ»ΠΎΡΡ ΠΏΠΎ Ρ ΠΎΠ΄Ρ Π²Π΅Π½, ΠΊΠΎΡΠΎΡΡΠ΅ ΠΏΠ°Π»ΡΠΏΠΈΡΡΡΡΡΡ Π² Π²ΠΈΠ΄Π΅ ΠΏΠ»ΠΎΡΠ½ΡΡ Π±ΠΎΠ»Π΅Π·Π½Π΅Π½Π½ΡΡ ΡΡΠΆΠ΅ΠΉ. ΠΠ»Ρ ΡΠΊΠ·Π΅ΠΌΡ Ρ Π°ΡΠ°ΠΊΡΠ΅ΡΠ½Ρ Π³ΠΈΠΏΠ΅ΡΠ΅ΠΌΠΈΡ ΠΊΠΎΠΆΠΈ, ΠΎΠ±ΡΠ°Π·ΠΎΠ²Π°Π½ΠΈΠ΅ ΠΌΠ΅Π»ΠΊΠΈΡ ΡΠ΅ΡΠΎΠ·Π½ΡΡ ΠΏΡΠ·ΡΡΡΠΊΠΎΠ², ΠΌΠΎΠΊΠ½ΡΡΠΈΠ΅, Π²ΡΡΠ°ΠΆΠ΅Π½Π½ΡΠΉ ΠΊΠΎΠΆΠ½ΡΠΉ Π·ΡΠ΄. ΠΠΎΠΊΠ°Π»ΡΠ½Π°Ρ Π±ΠΎΠ»Π΅Π·Π½Π΅Π½Π½ΠΎΡΡΡ, Π»ΠΈΡ ΠΎΡΠ°Π΄ΠΊΠ°, ΠΈΠ½ΡΠΎΠΊΡΠΈΠΊΠ°ΡΠΈΡ Π½Π΅ Π½Π°Π±Π»ΡΠ΄Π°ΡΡΡΡ. ΠΡΠΈ ΠΎΠΏΠΎΡΡΡΠ²Π°ΡΡΠ΅ΠΌ Π»ΠΈΡΠ°Π΅ ΠΎΠΏΡΠ΅Π΄Π΅Π»ΡΡΡΡΡ ΡΡΠ°ΡΡΠΊΠΈ Π³ΠΈΠΏΠ΅ΡΠ΅ΠΌΠΈΠΈ ΠΏΠΎ Ρ ΠΎΠ΄Ρ Π½Π΅ΡΠ²ΠΎΠ², Π²ΡΡΡΠΏΠ°Π½ΠΈΠ΅ ΡΠ³ΡΡΠΏΠΏΠΈΡΠΎΠ²Π°Π½Π½ΡΡ ΡΠ΅ΡΠΎΠ·Π½ΡΡ ΠΏΡΠ·ΡΡΡΠΊΠΎΠ², ΡΠ΅Π·ΠΊΠ°Ρ Π±ΠΎΠ»Π΅Π·Π½Π΅Π½Π½ΠΎΡΡΡ, Π½Π΅Π²ΡΠ°Π»Π³ΠΈΠΈ, Π»ΠΈΡ ΠΎΡΠ°Π΄ΠΊΠ°. Π£Π·Π»ΠΎΠ²Π°ΡΠ°Ρ ΡΡΠΈΡΠ΅ΠΌΠ° Ρ Π°ΡΠ°ΠΊΡΠ΅ΡΠΈΠ·ΡΠ΅ΡΡΡ ΠΏΠΎΡΠ²Π»Π΅Π½ΠΈΠ΅ΠΌ Π±Π°Π³ΡΠΎΠ²ΠΎ-ΠΊΡΠ°ΡΠ½ΡΡ ΡΠΌΠ΅ΡΠ΅Π½Π½ΠΎ Π±ΠΎΠ»Π΅Π·Π½Π΅Π½Π½ΡΡ ΠΈΠ½ΡΠΈΠ»ΡΡΡΠ°ΡΠΎΠ², Π»ΠΎΠΊΠ°Π»ΠΈΠ·ΡΡΡΠΈΡ ΡΡ ΠΏΡΠ΅ΠΈΠΌΡΡΠ΅ΡΡΠ²Π΅Π½Π½ΠΎ Π²Π±Π»ΠΈΠ·ΠΈ ΠΊΡΡΠΏΠ½ΡΡ ΡΡΡΡΠ°Π²ΠΎΠ². ΠΡΠΈΠ·ΠΈΠΏΠ΅Π»ΠΎΠΈΠ΄ (ΡΠ²ΠΈΠ½Π°Ρ ΡΠΎΠΆΠ°) ΠΏΡΠΎΡΠ΅ΠΊΠ°Π΅Ρ Ρ Π½Π΅Π·Π½Π°ΡΠΈΡΠ΅Π»ΡΠ½ΠΎΠΉ ΡΠ΅ΠΌΠΏΠ΅ΡΠ°ΡΡΡΠ½ΠΎΠΉ ΡΠ΅Π°ΠΊΡΠΈΠ΅ΠΉ. ΠΡΡΠΏΡΡΠ½ΠΎ-ΠΊΡΠ°ΡΠ½ΡΠ΅ ΡΡΠ°ΡΡΠΊΠΈ ΡΡΠΈΡΠ΅ΠΌΡ ΠΏΠΎΡΠ²Π»ΡΡΡΡΡ Π½Π° ΡΡΠ»ΡΠ½ΠΎΠΉ ΠΏΠΎΠ²Π΅ΡΡ Π½ΠΎΡΡΠΈ ΠΏΠ°Π»ΡΡΠ΅Π² ΠΈ ΠΊΠΈΡΡΠ΅ΠΉ, ΠΎΡΠΌΠ΅ΡΠ°ΡΡΡΡ ΠΈΠ½ΡΠ΅Π½ΡΠΈΠ²Π½ΠΎΠ΅ ΠΆΠΆΠ΅Π½ΠΈΠ΅ ΠΈ Π·ΡΠ΄ ΠΊΠΎΠΆΠΈ. ΠΡΠΈ ΠΊΠΎΠΆΠ½ΠΎΠΉ ΡΠΎΡΠΌΠ΅ ΡΠΈΠ±ΠΈΡΡΠΊΠΎΠΉ ΡΠ·Π²Ρ ΠΎΠ±ΡΠ°Π·ΡΠ΅ΡΡΡ ΠΊΠ°ΡΠ±ΡΠ½ΠΊΡΠ», ΠΏΠΎΠΊΡΡΡΡΠΉ ΡΠ΅ΡΠ½ΡΠΌ ΡΡΡΡΠΏΠΎΠΌ Ρ ΡΠ΅Π·ΠΊΠΎ Π²ΡΡΠ°ΠΆΠ΅Π½Π½ΡΠΌ ΡΠ°ΡΠΏΡΠΎΡΡΡΠ°Π½Π΅Π½Π½ΡΠΌ ΠΎΡΠ΅ΠΊΠΎΠΌ Π±Π΅Π· Π³ΠΈΠΏΠ΅ΡΠ΅ΠΌΠΈΠΈ ΠΈ ΠΏΠΎΠ»Π½ΡΠΌ ΠΎΡΡΡΡΡΡΠ²ΠΈΠ΅ΠΌ ΠΌΠ΅ΡΡΠ½ΠΎΠΉ Π±ΠΎΠ»Π΅Π·Π½Π΅Π½Π½ΠΎΡΡΠΈ. ΠΠ΅ΡΠΌΠ°ΡΠΈΡ ΠΏΡΠΎΡΠ²Π»ΡΠ΅ΡΡΡ ΡΡΠΈΡΠ΅ΠΌΠΎΠΉ, Π²ΡΡΡΠΏΠ°Π½ΠΈΡΠΌΠΈ ΡΠ°Π·Π»ΠΈΡΠ½ΠΎΠ³ΠΎ Ρ Π°ΡΠ°ΠΊΡΠ΅ΡΠ° (ΠΏΠ°ΠΏΡΠ»Ρ, ΠΏΡΠ·ΡΡΡΠΊΠΈ, ΠΏΡΡΡΡΠ»Ρ), ΠΎΠ±ΡΠ°Π·ΠΎΠ²Π°Π½ΠΈΠ΅ΠΌ ΠΊΠΎΡΠΎΡΠ΅ΠΊ, Π·ΡΠ΄ΠΎΠΌ, ΡΠ΅Π»ΡΡΠ΅Π½ΠΈΠ΅ΠΌ ΠΊΠΎΠΆΠΈ. ΠΠΎΡΠ°ΠΆΠ°ΡΡΡΡ ΡΠ°Π·Π»ΠΈΡΠ½ΡΠ΅ ΡΡΠ°ΡΡΠΊΠΈ ΠΊΠΎΠΆΠΈ, ΡΠ°ΡΡΠΎ ΡΠΈΠΌΠΌΠ΅ΡΡΠΈΡΠ½ΡΠ΅. ΠΠΈΡ ΠΎΡΠ°Π΄ΠΊΠ° ΠΈ ΠΈΠ½ΡΠΎΠΊΡΠΈΠΊΠ°ΡΠΈΡ Π½Π΅ Π½Π°Π±Π»ΡΠ΄Π°ΡΡΡΡ. ΠΠ΅ΡΠ΅Π½ΠΈΠ΅ Π² Π±ΠΎΠ»ΡΡΠΈΠ½ΡΡΠ²Π΅ ΡΠ»ΡΡΠ°Π΅Π² ΠΏΡΠΎΠ²ΠΎΠ΄ΡΡ Π½Π° Π΄ΠΎΠΌΡ ΠΈ Π°ΠΌΠ±ΡΠ»Π°ΡΠΎΡΠ½ΠΎ. ΠΠΎΠΊΠ°Π·Π°Π½ΠΈΡΠΌΠΈ Π΄Π»Ρ Π³ΠΎΡΠΏΠΈΡΠ°Π»ΠΈΠ·Π°ΡΠΈΠΈ ΡΠ²Π»ΡΡΡΡΡ ΡΡΠΆΠ΅Π»ΠΎΠ΅ ΡΠ΅ΡΠ΅Π½ΠΈΠ΅ Π±ΠΎΠ»Π΅Π·Π½ΠΈ, ΡΠ°ΡΠΏΡΠΎΡΡΡΠ°Π½Π΅Π½Π½ΡΠΉ ΠΌΠ΅ΡΡΠ½ΡΠΉ ΠΏΡΠΎΡΠ΅ΡΡ, Π΅Π³ΠΎ Π±ΡΠ»Π»Π΅Π·Π½ΠΎ-Π³Π΅ΠΌΠΎΡΡΠ°Π³ΠΈΡΠ΅ΡΠΊΠΈΠΉ Ρ Π°ΡΠ°ΠΊΡΠ΅Ρ ΠΈ ΡΠ΅ΡΠΈΠ΄ΠΈΠ²ΠΈΡΡΡΡΠ°Ρ ΡΠΎΠΆΠ°. ΠΡΠΈ Π»Π΅ΡΠ΅Π½ΠΈΠΈ Π±ΠΎΠ»ΡΠ½ΡΡ Π½Π° Π΄ΠΎΠΌΡ ΠΈ Π½Π° Π΄ΠΎΠ³ΠΎΡΠΏΠΈΡΠ°Π»ΡΠ½ΠΎΠΌ ΡΡΠ°ΠΏΠ΅ Π½Π°Π·Π½Π°ΡΠ°ΡΡ Π² ΡΠ΅ΡΠ΅Π½ΠΈΠ΅ 7β10 Π΄Π½Π΅ΠΉ Π°Π½ΡΠΈΠ±ΠΈΠΎΡΠΈΠΊΠΈ Π² ΡΠ°Π±Π»Π΅ΡΠΊΠ°Ρ ΠΈ ΠΊΠ°ΠΏΡΡΠ»Π°Ρ : ΠΎΠ»Π΅ΡΠ΅ΡΡΠΈΠ½ ΠΏΠΎ 0,25 Π³ 4β6 ΡΠ°Π· Π² ΡΡΡΠΊΠΈ, ΠΌΠ΅ΡΠ°ΡΠΈΠΊΠ»ΠΈΠ½Π° Π³ΠΈΠ΄ΡΠΎΡ Π»ΠΎΡΠΈΠ΄ ΠΏΠΎ 0,3 Π³ 2β3 ΡΠ°Π·Π° Π² ΡΡΡΠΊΠΈ, ΡΡΠΈΡΡΠΎΠΌΠΈΡΠΈΠ½ ΠΈΠ»ΠΈ ΠΎΠ»Π΅Π°Π½Π΄ΠΎΠΌΠΈΡΠΈΠ½Π° ΡΠΎΡΡΠ°Ρ Π² ΡΡΡΠΎΡΠ½ΡΡ Π΄ΠΎΠ·Π°Ρ Π΄ΠΎ 2 Π³, ΠΊΠΎΠΌΠ±ΠΈΠ½ΠΈΡΠΎΠ²Π°Π½Π½ΡΠΉ Ρ ΠΈΠΌΠΈΠΎΠΏΡΠ΅ΠΏΠ°ΡΠ°Ρ Π±Π°ΠΊΡΡΠΈΠΌ (Π±ΠΈΡΠ΅ΠΏΡΠΎΠ»), ΡΡΠ»ΡΡΠ°ΡΠΎΠ½ β ΠΏΠΎ 2 ΡΠ°Π±Π»Π΅ΡΠΊΠΈ 2 ΡΠ°Π·Π° Π² Π΄Π΅Π½Ρ ΡΡΡΠΎΠΌ ΠΈ Π²Π΅ΡΠ΅ΡΠΎΠΌ ΠΏΠΎΡΠ»Π΅ Π΅Π΄Ρ. Π ΡΡΠ»ΠΎΠ²ΠΈΡΡ ΡΡΠ°ΡΠΈΠΎΠ½Π°ΡΠ° ΠΈ ΠΏΡΠΈ ΡΡΠΆΠ΅Π»ΠΎΠΌ ΡΠ΅ΡΠ΅Π½ΠΈΠΈ Π±ΠΎΠ»Π΅Π·Π½ΠΈ ΠΏΠΎΠΊΠ°Π·Π°Π½ΠΎ Π²Π½ΡΡΡΠΈΠΌΡΡΠ΅ΡΠ½ΠΎΠ΅ Π²Π²Π΅Π΄Π΅Π½ΠΈΠ΅ Π±Π΅Π½Π·ΠΈΠ»ΠΏΠ΅Π½ΠΈΡΠΈΠ»Π»ΠΈΠ½Π°, ΠΏΡΠΈ ΡΠ΅ΡΠΈΠ΄ΠΈΠ²ΠΈΡΡΡΡΠ΅ΠΉ Π . β ΡΠ΅ΡΠ°Π»ΠΎΡΠΏΠΎΡΠΈΠ½ΠΎΠ² (ΡΠ΅ΡΠ°Π·ΠΎΠ»ΠΈΠ½, ΠΊΠ»Π°ΡΠΎΡΠ°Π½ ΠΈ Π΄Ρ.), Π»ΠΈΠ½ΠΊΠΎΠΌΠΈΡΠΈΠ½Π° Π³ΠΈΠΏΠΎΡ Π»ΠΎΡΠΈΠ΄Π°. ΠΡΡΡ Π°Π½ΡΠΈΠ±ΠΈΠΎΡΠΈΠΊΠΎΡΠ΅ΡΠ°ΠΏΠΈΠΈ β 8β10 Π΄Π½Π΅ΠΉ. ΠΠ°ΡΠΎΠ³Π΅Π½Π΅ΡΠΈΡΠ΅ΡΠΊΠΎΠ΅ Π»Π΅ΡΠ΅Π½ΠΈΠ΅ Π²ΠΊΠ»ΡΡΠ°Π΅Ρ Π½Π΅ΡΡΠ΅ΡΠΎΠΈΠ΄Π½ΡΠ΅ ΠΏΡΠΎΡΠΈΠ²ΠΎΠ²ΠΎΡΠΏΠ°Π»ΠΈΡΠ΅Π»ΡΠ½ΡΠ΅ ΠΏΡΠ΅ΠΏΠ°ΡΠ°ΡΡ, Π°ΡΠΊΠΎΡΡΡΠΈΠ½, ΠΊΠΎΠΌΠΏΠ»Π΅ΠΊΡ Π²ΠΈΡΠ°ΠΌΠΈΠ½ΠΎΠ². ΠΡΠΈ ΡΠ°ΡΡΡΡ ΡΠ΅ΡΠΈΠ΄ΠΈΠ²Π°Ρ Π . ΠΏΠΎΠΊΠ°Π·Π°Π½Π° Π½Π΅ΡΠΏΠ΅ΡΠΈΡΠΈΡΠ΅ΡΠΊΠ°Ρ ΡΡΠΈΠΌΡΠ»ΠΈΡΡΡΡΠ°Ρ ΠΈ ΠΈΠΌΠΌΡΠ½ΠΎΠΊΠΎΡΡΠΈΠ³ΠΈΡΡΡΡΠ°Ρ ΡΠ΅ΡΠ°ΠΏΠΈΡ (ΠΏΠ΅Π½ΡΠΎΠΊΡΠΈΠ», ΠΌΠ΅ΡΠΈΠ»ΡΡΠ°ΡΠΈΠ», Π½ΡΠΊΠ»Π΅ΠΈΠ½Π°Ρ Π½Π°ΡΡΠΈΡ), Π° ΡΠ°ΠΊΠΆΠ΅ ΠΏΡΠΎΠ΄ΠΈΠ³ΠΈΠΎΠ·Π°Π½, Π»Π΅Π²Π°ΠΌΠΈΠ·ΠΎΠ». ΠΠ²Π° ΠΏΠΎΡΠ»Π΅Π΄Π½ΠΈΡ ΠΏΡΠ΅ΠΏΠ°ΡΠ°ΡΠ° Π½Π°Π·Π½Π°ΡΠ°ΡΡ ΡΠΎΠ»ΡΠΊΠΎ Π² ΡΡΠ°ΡΠΈΠΎΠ½Π°ΡΠ΅. ΠΡΠΈ ΡΠ΅ΡΠΈΠ΄ΠΈΠ²ΠΈΡΡΡΡΠ΅ΠΉ Π . Π² ΡΡΠ΄Π΅ ΡΠ»ΡΡΠ°Π΅Π² ΠΏΡΠΈΠΌΠ΅Π½ΡΡΡ Π°ΡΡΠΎΠ³Π΅ΠΌΠΎΡΠ΅ΡΠ°ΠΏΠΈΡ. ΠΠ΅ΡΡΠ½ΠΎΠ΅ Π»Π΅ΡΠ΅Π½ΠΈΠ΅ ΡΠΎΠΆΠΈ ΠΏΡΠΎΠ²ΠΎΠ΄ΠΈΡΡΡ Π»ΠΈΡΡ ΠΏΡΠΈ Π΅Π΅ Π±ΡΠ»Π»Π΅Π·Π½ΡΡ ΡΠΎΡΠΌΠ°Ρ ΠΈ Π»ΠΎΠΊΠ°Π»ΠΈΠ·Π°ΡΠΈΠΈ ΠΏΡΠΎΡΠ΅ΡΡΠ° Π½Π° ΠΊΠΎΠ½Π΅ΡΠ½ΠΎΡΡΡΡ . ΠΡΠ·ΡΡΠΈ Π½Π°Π΄ΡΠ΅Π·Π°ΡΡ Ρ ΠΎΠ΄Π½ΠΎΠ³ΠΎ ΠΈΠ· ΠΊΡΠ°Π΅Π² ΠΈ Π½Π° ΠΎΡΠ°Π³ Π²ΠΎΡΠΏΠ°Π»Π΅Π½ΠΈΡ Π½Π°ΠΊΠ»Π°Π΄ΡΠ²Π°ΡΡ ΠΏΠΎΠ²ΡΠ·ΠΊΠΈ Ρ ΡΠ°ΡΡΠ²ΠΎΡΠΎΠΌ ΡΡΠ°ΠΊΡΠΈΠ΄ΠΈΠ½Π° Π»Π°ΠΊΡΠ°ΡΠ° (1:1000) ΠΈΠ»ΠΈ ΡΡΡΠ°ΡΠΈΠ»ΠΈΠ½Π° (1:5000), ΠΌΠ΅Π½ΡΡ ΠΈΡ Π½Π΅ΡΠΊΠΎΠ»ΡΠΊΠΎ ΡΠ°Π· Π² Π΄Π΅Π½Ρ. Π ΠΏΠΎΡΠ»Π΅Π΄ΡΡΡΠ΅ΠΌ ΠΏΡΠΈΠΌΠ΅Π½ΡΡΡΡΡ ΠΏΠΎΠ²ΡΠ·ΠΊΠΈ Ρ ΡΠΊΡΠ΅ΡΠΈΡΠΈΠ΄ΠΎΠΌ, Π²ΠΈΠ½ΠΈΠ»ΠΈΠ½ΠΎΠΌ. Π ΠΎΡΡΡΠΎΠΌ ΠΏΠ΅ΡΠΈΠΎΠ΄Π΅ Π±ΠΎΠ»Π΅Π·Π½ΠΈ ΠΌΠΎΠΆΠ½ΠΎ ΠΈΡΠΏΠΎΠ»ΡΠ·ΠΎΠ²Π°ΡΡ Π£Π€-ΠΎΠ±Π»ΡΡΠ΅Π½ΠΈΠ΅ ΠΈ Π£ΠΠ§-ΡΠ΅ΡΠ°ΠΏΠΈΡ, Π° ΠΏΠΎΡΠ»Π΅ ΡΡΠΈΡ Π°Π½ΠΈΡ ΠΎΡΡΡΠΎΠ³ΠΎ Π²ΠΎΡΠΏΠ°Π»ΠΈΡΠ΅Π»ΡΠ½ΠΎΠ³ΠΎ ΠΏΡΠΎΡΠ΅ΡΡΠ° ΠΏΠΎΠ²ΡΠ·ΠΊΠΈ Ρ Π½Π°ΡΡΠ°Π»Π°Π½Π½ΠΎΠΉ ΠΌΠ°Π·ΡΡ, Π°ΠΏΠΏΠ»ΠΈΠΊΠ°ΡΠΈΠΈ Ρ ΠΏΠ°ΡΠ°ΡΠΈΠ½ΠΎΠΌ ΠΈ ΠΎΠ·ΠΎΠΊΠ΅ΡΠΈΡΠΎΠΌ, ΡΠ°Π΄ΠΎΠ½ΠΎΠ²ΡΠ΅ Π²Π°Π½Π½Ρ, ΡΠ»Π΅ΠΊΡΡΠΎΡΠΎΡΠ΅Π· Π»ΠΈΠ΄Π°Π·Ρ ΠΈΠ»ΠΈ Ρ Π»ΠΎΡΠΈΡΡΠΎΠ³ΠΎ ΠΊΠ°Π»ΡΡΠΈΡ Π΄Π»Ρ ΠΏΡΠ΅Π΄ΡΠΏΡΠ΅ΠΆΠ΄Π΅Π½ΠΈΡ ΡΡΠΎΠΉΠΊΠΎΠ³ΠΎ Π»ΠΈΠΌΡΠΎΡΡΠ°Π·Π°. ΠΠΎΠ»ΡΠ½ΡΡ Π²ΡΠΏΠΈΡΡΠ²Π°ΡΡ Π½Π΅ ΡΠ°Π½Π΅Π΅ 7-Π³ΠΎ Π΄Π½Ρ ΠΏΠΎΡΠ»Π΅ Π½ΠΎΡΠΌΠ°Π»ΠΈΠ·Π°ΡΠΈΠΈ ΡΠ΅ΠΌΠΏΠ΅ΡΠ°ΡΡΡΡ ΡΠ΅Π»Π°. ΠΠ΅ΡΠ΅Π½Π΅ΡΡΠΈΠ΅ Π . Π½Π°Ρ ΠΎΠ΄ΡΡΡΡ Π½Π° ΡΡΠ΅ΡΠ΅ Π² ΠΊΠ°Π±ΠΈΠ½Π΅ΡΠ΅ ΠΈΠ½ΡΠ΅ΠΊΡΠΈΠΎΠ½Π½ΡΡ Π±ΠΎΠ»Π΅Π·Π½Π΅ΠΉ Π² ΡΠ΅ΡΠ΅Π½ΠΈΠ΅ 3 ΠΌΠ΅Ρ., Π° ΡΡΡΠ°Π΄Π°ΡΡΠΈΠ΅ ΡΠ΅ΡΠΈΠ΄ΠΈΠ²ΠΈΡΡΡΡΠ΅ΠΉ Π . Π½Π΅ ΠΌΠ΅Π½Π΅Π΅ 2 Π»Π΅Ρ. Π₯ΠΈΡΡΡΠ³ΠΈΡΠ΅ΡΠΊΠΎΠ΅ Π»Π΅ΡΠ΅Π½ΠΈΠ΅ ΠΎΡΠ»ΠΎΠΆΠ½Π΅Π½ΠΈΠΉ ΠΏΡΠΈ ΡΠΎΠΆΠ΅. ΠΡΠΈ Π½Π΅ΠΊΡΠΎΠ·Π°Ρ ΠΊΠΎΠΆΠΈ ΠΏΠΎΡΠ»Π΅ ΠΎΡΠ³ΡΠ°Π½ΠΈΡΠ΅Π½ΠΈΡ ΠΎΡΠ°Π³Π° ΠΈ ΡΠ»ΡΡΡΠ΅Π½ΠΈΡ ΠΎΠ±ΡΠ΅Π³ΠΎ ΡΠΎΡΡΠΎΡΠ½ΠΈΡ ΠΏΠ°ΡΠΈΠ΅Π½ΡΠ° ΠΏΡΠΎΠΈΠ·Π²ΠΎΠ΄ΠΈΡΡΡ Π½Π΅ΠΊΡΡΠΊΡΠΎΠΌΠΈΡ. Π Π°Π½Ρ ΠΏΠΎΠΊΡΡΠ²Π°ΡΡ Π΄Π°Π»ΡΡΠ΅ΠΊΡ-ΡΡΠΈΠΏΡΠΈΠ½ΠΎΠΌ Ρ Π°Π½ΡΠΈΡΠ΅ΠΏΡΠΈΠΊΠΎΠΌ, ΡΠ΅ΡΠ°Π»Π³ΠΈΠ½ΠΎΠΌ, Π°Π»ΡΠ³ΠΈΠΏΠΎΡΠΎΠΌ, ΠΌΠ°Π·ΡΡ Π½Π° Π³ΠΈΠ΄ΡΠΎΡΠΈΠ»ΡΠ½ΠΎΠΉ ΠΎΡΠ½ΠΎΠ²Π΅ (Π»Π΅Π²ΠΎΠΌΠ΅ΠΊΠΎΠ»Ρ) ΠΈΠ»ΠΈ Ρ ΠΈΠΌΠΈΠΎΡΠ΅ΡΠ°ΠΏΠ΅Π²ΡΠΈΡΠ΅ΡΠΊΠΈΠΌΠΈ ΡΡΠ΅Π΄ΡΡΠ²Π°ΠΌΠΈ (Π΄ΠΈΠΌΠ΅ΠΊΡΠΈΠ΄, ΠΉΠΎΠ΄ΠΎΠΏΠΈΡΠΎΠ½ ΠΈ Ρ.Π΄.). ΠΡΠΈ Π΄Π΅ΡΠ΅ΠΊΡΠ°Ρ Π±ΠΎΠ»ΡΡΠΈΡ ΡΠ°Π·ΠΌΠ΅ΡΠΎΠ², ΠΏΠΎΡΠ»Π΅ ΠΏΠΎΡΠ²Π»Π΅Π½ΠΈΡ ΠΏΠ»ΠΎΡΠ½ΡΡ Π·Π΅ΡΠ½ΠΈΡΡΡΡ Π³ΡΠ°Π½ΡΠ»ΡΡΠΈΠΉ ΠΈ Π»ΠΈΠΊΠ²ΠΈΠ΄Π°ΡΠΈΠΈ ΠΎΡΡΡΡΡ ΡΠ²Π»Π΅Π½ΠΈΠΉ ΠΏΡΠΎΠ²ΠΎΠ΄ΡΡ ΠΏΠΎΠ²ΡΠΎΡΠ½ΡΡ ΠΎΠΏΠ΅ΡΠ°ΡΠΈΡ β Π°ΡΡΠΎ-Π΄Π΅ΡΠΌΠΎΠΏΠ»Π°ΡΡΠΈΠΊΡ. ΠΡΠΈ ΡΠ»Π΅Π³ΠΌΠΎΠ½Π°Ρ ΠΈ Π°Π±ΡΡΠ΅ΡΡΠ°Ρ ΡΠ°Π·ΡΠ΅Π· ΠΏΡΠΎΠ²ΠΎΠ΄ΡΡ ΠΏΠΎ ΠΊΡΠ°ΡΡΠ°ΠΉΡΠ΅ΠΌΡ ΠΏΡΡΠΈ, ΡΠ°ΡΡΠ΅ΠΊΠ°ΡΡ ΠΊΠΎΠΆΡ, ΠΏΠΎΠ΄ΠΊΠΎΠΆΠ½ΡΡ ΠΊΠ»Π΅ΡΡΠ°ΡΠΊΡ ΠΈ Π²ΡΠΊΡΡΠ²Π°ΡΡ ΠΏΠΎΠ»ΠΎΡΡΡ Π³Π½ΠΎΠΉΠ½ΠΈΠΊΠ°. ΠΠΎΡΠ»Π΅ ΡΠ²Π°ΠΊΡΠ°ΡΠΈΠΈ Π΄Π΅ΡΡΠΈΡΠ° ΠΏΠΎΠ»ΠΎΡΡΡ ΠΏΡΠΎΠΌΡΠ²Π°ΡΡ Π°Π½ΡΠΈΡΠ΅ΠΏΡΠΈΠΊΠ°ΠΌΠΈ, ΠΎΡΡΡΠ°ΡΡ, ΡΠ°Π·Π²ΠΎΠ΄ΡΡ ΠΊΡΠ°Ρ ΡΠ°Π½Ρ ΠΊΡΡΡΠΊΠ°ΠΌΠΈ ΠΈ Π²ΡΠΏΠΎΠ»Π½ΡΡΡ ΡΠ΅Π²ΠΈΠ·ΠΈΡ. ΠΡΡΠ΅ΠΊΠ°ΡΡ Π²ΡΠ΅ Π½Π΅ΠΆΠΈΠ·Π½Π΅ΡΠΏΠΎΡΠΎΠ±Π½ΡΠ΅ ΡΠΊΠ°Π½ΠΈ. Π Π°Π½Ρ, ΠΊΠ°ΠΊ ΠΏΡΠ°Π²ΠΈΠ»ΠΎ, Π½Π΅ ΡΡΠΈΠ²Π°ΡΡ, Π½Π°ΠΊΠ»Π°Π΄ΡΠ²Π°ΡΡ ΡΡΠ΅ΡΠΈΠ»ΡΠ½ΡΡ ΠΏΠΎΠ²ΡΠ·ΠΊΡ. ΠΠ½ΠΎΠΉΠ½ΡΠ΅ Π»ΠΈΠΌΡΠ°Π΄Π΅Π½ΠΈΡΡ, Π°Π±ΡΡΠ΅Π΄ΠΈΡΡΡΡΠΈΠ΅ΡΡ ΡΠ»Π΅Π±ΠΈΡΡ ΠΈ ΠΏΠ°ΡΠ°ΡΠ»Π΅Π±ΠΈΡΡ ΠΈ Π΄ΡΡΠ³ΠΈΠ΅ ΠΎΡΠ°Π³ΠΈ Π³Π½ΠΎΠΉΠ½ΠΎ-Π²ΠΎΡΠΏΠ°Π»ΠΈΡΠ΅Π»ΡΠ½ΠΎΠ³ΠΎ Ρ Π°ΡΠ°ΠΊΡΠ΅ΡΠ° Π»Π΅ΡΠ°Ρ ΠΏΠΎ ΠΎΠ±ΡΡΠ½ΠΎΠΉ ΠΌΠ΅ΡΠΎΠ΄ΠΈΠΊΠ΅ β ΠΏΡΠΎΠΈΠ·Π²ΠΎΠ΄ΡΡ Π²ΡΠΊΡΡΡΠΈΠ΅ ΡΠΊΠΎΠΏΠ»Π΅Π½ΠΈΠΉ Π³Π½ΠΎΡ, ΡΠ΄Π°Π»Π΅Π½ΠΈΠ΅ Π½Π΅ΠΊΡΠΎΡΠΈΠ·ΠΈΡΠΎΠ²Π°Π½Π½ΡΡ ΡΠΊΠ°Π½Π΅ΠΉ, Π΄ΡΠ΅Π½ΠΈΡΠΎΠ²Π°Π½ΠΈΠ΅ ΡΠ°Π½Ρ.ΠΡΠΎΠ³Π½ΠΎΠ· Π΄Π»Ρ ΠΆΠΈΠ·Π½ΠΈ Π±Π»Π°Π³ΠΎΠΏΡΠΈΡΡΠ½ΡΠΉ. Π§Π°ΡΡΡΠ΅ ΡΠ΅ΡΠΈΠ΄ΠΈΠ²Ρ Π . Ρ ΡΠΎΡΠΌΠΈΡΠΎΠ²Π°Π½ΠΈΠ΅ΠΌ Π²ΡΠΎΡΠΈΡΠ½ΠΎΠΉ ΡΠ»ΠΎΠ½ΠΎΠ²ΠΎΡΡΠΈ ΠΌΠΎΠ³ΡΡ ΠΏΡΠΈΠ²Π΅ΡΡΠΈ ΠΊ ΠΈΠ½Π²Π°Π»ΠΈΠ΄Π½ΠΎΡΡΠΈ.
ΠΡΠΎΡΠΈΠ»Π°ΠΊΡΠΈΠΊΠ° Π·Π°ΠΊΠ»ΡΡΠ°Π΅ΡΡΡ Π² ΡΡΠ°ΡΠ΅Π»ΡΠ½ΠΎΠΌ ΡΠΎΠ±Π»ΡΠ΄Π΅Π½ΠΈΠΈ Π»ΠΈΡΠ½ΠΎΠΉ Π³ΠΈΠ³ΠΈΠ΅Π½Ρ, ΠΏΡΠ΅Π΄ΡΠΏΡΠ΅ΠΆΠ΄Π΅Π½ΠΈΠΈ ΠΌΠΈΠΊΡΠΎΡΡΠ°Π²ΠΌ, ΠΎΠ±ΡΠ°Π±ΠΎΡΠΊΠ΅ ΠΌΠΈΠΊΡΠΎΡΡΠ°Π²ΠΌ Π°Π½ΡΠΈΡΠ΅ΠΏΡΠΈΠΊΠ°ΠΌΠΈ (Π½Π°ΠΏΡΠΈΠΌΠ΅Ρ, 5% ΡΠΏΠΈΡΡΠΎΠ²ΡΠΌ ΡΠ°ΡΡΠ²ΠΎΡΠΎΠΌ ΠΉΠΎΠ΄Π°, ΡΠ°ΡΡΠ²ΠΎΡΠΎΠΌ Π±ΡΠΈΠ»Π»ΠΈΠ°Π½ΡΠΎΠ²ΠΎΠ³ΠΎ Π·Π΅Π»Π΅Π½ΠΎΠ³ΠΎ), ΡΠ°Π½Π°ΡΠΈΠΈ ΠΎΡΠ°Π³ΠΎΠ² Ρ ΡΠΎΠ½ΠΈΡΠ΅ΡΠΊΠΎΠΉ ΡΡΡΠ΅ΠΏΡΠΎΠΊΠΎΠΊΠΊΠΎΠ²ΠΎΠΉ ΠΈΠ½ΡΠ΅ΠΊΡΠΈΠΈ. ΠΡΠΎΡΠΈΠ»Π°ΠΊΡΠΈΠΊΠ° ΡΠ΅ΡΠΈΠ΄ΠΈΠ²ΠΈΡΡΡΡΠ΅ΠΉ Π . ΠΏΡΠ΅Π΄ΡΡΠΌΠ°ΡΡΠΈΠ²Π°Π΅Ρ Π»Π΅ΡΠ΅Π½ΠΈΠ΅ ΠΏΡΠ΅Π΄ΡΠ°ΡΠΏΠΎΠ»Π°Π³Π°ΡΡΠΈΡ ΠΊ ΡΠ΅ΡΠΈΠ΄ΠΈΠ²Π°ΠΌ Π·Π°Π±ΠΎΠ»Π΅Π²Π°Π½ΠΈΠΉ (Π³ΡΠΈΠ±ΠΊΠΎΠ²ΡΡ ΠΏΠΎΡΠ°ΠΆΠ΅Π½ΠΈΠΉ ΠΊΠΎΠΆΠΈ, Π»ΠΈΠΌΡΠΎΠ²Π΅Π½ΠΎΠ·Π½ΠΎΠΉ Π½Π΅Π΄ΠΎΡΡΠ°ΡΠΎΡΠ½ΠΎΡΡΠΈ). ΠΡΠΈ ΡΠ°ΡΡΡΡ , ΡΠΏΠΎΡΠ½ΡΡ ΡΠ΅ΡΠΈΠ΄ΠΈΠ²Π°Ρ Ρ ΠΏΡΠΎΡΠΈΠ»Π°ΠΊΡΠΈΡΠ΅ΡΠΊΠΎΠΉ ΡΠ΅Π»ΡΡ Π²Π²ΠΎΠ΄ΡΡ Π±ΠΈΡΠΈΠ»Π»ΠΈΠ½-5 ΠΏΠΎ 1 500 000 ΠΠ Π²Π½ΡΡΡΠΈΠΌΡΡΠ΅ΡΠ½ΠΎ ΠΊΠ°ΠΆΠ΄ΡΠ΅ 3β5 Π½Π΅Π΄. Π½Π° ΠΏΡΠΎΡΡΠΆΠ΅Π½ΠΈΠΈ Π΄Π²ΡΡ -ΡΡΠ΅Ρ Π»Π΅Ρ. Π ΡΠ»ΡΡΠ°ΡΡ Π²ΡΡΠ°ΠΆΠ΅Π½Π½ΠΎΠΉ ΡΠ΅Π·ΠΎΠ½Π½ΠΎΡΡΠΈ ΡΠ΅ΡΠΈΠ΄ΠΈΠ²ΠΎΠ² ΠΈ ΠΏΡΠΈ Π·Π½Π°ΡΠΈΡΠ΅Π»ΡΠ½ΡΡ ΠΎΡΡΠ°ΡΠΎΡΠ½ΡΡ ΡΠ²Π»Π΅Π½ΠΈΡΡ ΡΠ΅ΠΊΠΎΠΌΠ΅Π½Π΄ΡΠ΅ΡΡΡ Π½Π°Π·Π½Π°ΡΠ΅Π½ΠΈΠ΅ Π±ΠΈΡΠΈΠ»Π»ΠΈΠ½Π°-5 ΠΏΡΠΎΡΠΈΠ»Π°ΠΊΡΠΈΡΠ΅ΡΠΊΠΈΠΌΠΈ ΠΊΡΡΡΠ°ΠΌΠΈ ΠΏΡΠΎΠ΄ΠΎΠ»ΠΆΠΈΡΠ΅Π»ΡΠ½ΠΎΡΡΡΡ 3β4 ΠΌΠ΅ΡΡΡΠ°. ΠΠΈΠ±Π»ΠΈΠΎΠ³Ρ.: ΠΠ°Π»ΡΠΏΠ΅ΡΠΈΠ½ Π.Π. ΠΈ Π ΡΡΠΊΠΈΠ½Π΄ Π .Π . Π ΠΎΠΆΠ°, Π., 1976; Π ΡΠΊΠΎΠ²ΠΎΠ΄ΡΡΠ²ΠΎ ΠΏΠΎ ΠΈΠ½ΡΠ΅ΠΊΡΠΈΠΎΠ½Π½ΡΠΌ Π±ΠΎΠ»Π΅Π·Π½ΡΠΌ, ΠΏΠΎΠ΄ ΡΠ΅Π΄. Π.Π. ΠΠΎΠΊΡΠΎΠ²ΡΠΊΠΎΠ³ΠΎ ΠΈ Π.Π. ΠΠΎΠ±Π°Π½Π°, Ρ. 391, Π., 1986; Π€ΡΠΎΠ»ΠΎΠ² Π.Π. ΠΈ Π ΡΡΠ½Π΅Π² Π.Π. ΠΠ°ΡΠΎΠ³Π΅Π½Π΅Π· ΠΈ Π΄ΠΈΠ°Π³Π½ΠΎΡΡΠΈΠΊΠ° ΡΠΎΠΆΠΈΡΡΠΎΠΉ ΠΈΠ½ΡΠ΅ΠΊΡΠΈΠΈ, ΠΠΎΡΠΎΠ½Π΅ΠΆ, 1986; Π§Π΅ΡΠΊΠ°ΡΠΎΠ² Π.Π. Π ΠΎΠΆΠ°, Π., 1986.
Π ΠΈΡ. 2. ΠΡΠΈΡΠ΅ΠΌΠ°ΡΠΎΠ·Π½ΠΎ-Π³Π΅ΠΌΠΎΡΡΠ°Π³ΠΈΡΠ΅ΡΠΊΠ°Ρ ΡΠΎΠΆΠ° Π½ΠΈΠΆΠ½Π΅ΠΉ ΠΊΠΎΠ½Π΅ΡΠ½ΠΎΡΡΠΈ.

Π ΠΈΡ. 1. ΠΡΠΈΡΠ΅ΠΌΠ°ΡΠΎΠ·Π½Π°Ρ ΡΠΎΠΆΠ° Π½ΠΈΠΆΠ½Π΅ΠΉ ΠΊΠΎΠ½Π΅ΡΠ½ΠΎΡΡΠΈ.

Π ΠΈΡ. 4. ΠΠ΅ΠΊΡΠΎΠ· ΠΊΠΎΠΆΠΈ ΠΏΡΠΈ Π±ΡΠ»Π»Π΅Π·Π½ΠΎ-Π³Π΅ΠΌΠΎΡΡΠ°Π³ΠΈΡΠ΅ΡΠΊΠΎΠΉ ΡΠΎΠΆΠ΅.

Π ΠΈΡ. 3. ΠΡΠ»Π»Π΅Π·Π½ΠΎ-Π³Π΅ΠΌΠΎΡΡΠ°Π³ΠΈΡΠ΅ΡΠΊΠ°Ρ ΡΠΎΠΆΠ° Π½ΠΈΠΆΠ½Π΅ΠΉ ΠΊΠΎΠ½Π΅ΡΠ½ΠΎΡΡΠΈ.

Π ΠΈΡ. 5. ΠΠ΅ΡΠΈΠ°Π΄Π΅Π½ΠΈΡ Π² ΠΎΠ±Π»Π°ΡΡΠΈ ΠΏΠ°Ρ ΠΎΠ²ΡΡ Π»ΠΈΠΌΡΠ°ΡΠΈΡΠ΅ΡΠΊΠΈΡ ΡΠ·Π»ΠΎΠ² ΠΏΡΠΈ ΡΠΎΠΆΠ΅ Π³ΠΎΠ»Π΅Π½ΠΈ.
ΠΈΠ½ΡΠ΅ΠΊΡΠΈΠΎΠ½Π½Π°Ρ Π±ΠΎΠ»Π΅Π·Π½Ρ, Π²ΡΠ·ΡΠ²Π°Π΅ΠΌΠ°Ρ Π³Π΅ΠΌΠΎΠ»ΠΈΡΠΈΡΠ΅ΡΠΊΠΈΠΌ ΡΡΡΠ΅ΠΏΡΠΎΠΊΠΎΠΊΠΊΠΎΠΌ, Ρ Π°ΡΠ°ΠΊΡΠ΅ΡΠΈΠ·ΡΡΡΠ°ΡΡΡ ΡΠ΅ΡΠΊΠΎ ΠΎΡΠ³ΡΠ°Π½ΠΈΡΠ΅Π½Π½ΡΠΌ ΠΎΡΡΡΡΠΌ Π²ΠΎΡΠΏΠ°Π»Π΅Π½ΠΈΠ΅ΠΌ ΠΊΠΎΠΆΠΈ, Π»ΠΈΡ ΠΎΡΠ°Π΄ΠΊΠΎΠΉ, ΡΠ²Π»Π΅Π½ΠΈΡΠΌΠΈ ΠΎΠ±ΡΠ΅ΠΉ ΠΈΠ½ΡΠΎΠΊΡΠΈΠΊΠ°ΡΠΈΠΈ.
Π ΠΎΜΠΆΠ° Π±Π»ΡΠΆΠ΄Π°ΜΡΡΠ°Ρ (Π΅. migrans) β ΡΠΌ. Π ΠΎΠΆΠ° ΠΌΠΈΠ³ΡΠΈΡΡΡΡΠ°Ρ.
Π ΠΎΜΠΆΠ° Π±ΡΠ»Π»ΡΠ·Π½Π°Ρ (Π΅. bullosum; ΡΠΈΠ½. Π . ΠΏΡΠ·ΡΡΡΠ°ΡΠ°Ρ) β P., ΠΏΡΠΎΡΠ΅ΠΊΠ°ΡΡΠ°Ρ Ρ ΠΎΠ±ΡΠ°Π·ΠΎΠ²Π°Π½ΠΈΠ΅ΠΌ ΡΠΏΠΈΠ΄Π΅ΡΠΌΠ°Π»ΡΠ½ΡΡ ΠΏΡΠ·ΡΡΠ΅ΠΉ, Π½Π°ΠΏΠΎΠ»Π½Π΅Π½Π½ΡΡ ΡΠ΅ΡΠΎΠ·Π½ΡΠΌ ΡΠΊΡΡΡΠ΄Π°ΡΠΎΠΌ. Π ΠΎΜΠΆΠ° Π²ΡΠΎΡΠΈΜΡΠ½Π°Ρ (Π΅. secundarium; ΡΠΈΠ½.: Π . Π»ΠΎΠΆΠ½Π°Ρ β ΡΡΡΠ°Ρ., ΡΠ»Π΅Π³ΠΌΠΎΠ½Π° ΡΠΎΠΆΠΈΡΡΠ°Ρ) β P., Π²ΠΎΠ·Π½ΠΈΠΊΡΠ°Ρ ΠΊΠ°ΠΊ ΠΎΡΠ»ΠΎΠΆΠ½Π΅Π½ΠΈΠ΅ Π½Π°Π³Π½ΠΎΠΈΠ²ΡΠ΅ΠΉΡΡ ΡΠ°Π½Ρ ΠΈΠ»ΠΈ Π΄ΡΡΠ³ΠΎΠ³ΠΎ ΠΎΡΠ°Π³Π° Π³Π½ΠΎΠΉΠ½ΠΎΠ³ΠΎ Π²ΠΎΡΠΏΠ°Π»Π΅Π½ΠΈΡ. Π ΠΎΜΠΆΠ° Π³Π°Π½Π³ΡΠ΅Π½ΠΎΜΠ·Π½Π°Ρ (Π΅. gangraenosum) β P., ΠΏΡΠΎΡΠ΅ΠΊΠ°ΡΡΠ°Ρ Ρ Π½Π΅ΠΊΡΠΎΠ·ΠΎΠΌ ΡΡΠ°ΡΡΠΊΠΎΠ² ΠΊΠΎΠΆΠΈ; Π½Π°Π±Π»ΡΠ΄Π°Π΅ΡΡΡ Π² ΠΎΠ±Π»Π°ΡΡΡΡ ΡΠ΅Π»Π°, Π±ΠΎΠ³Π°ΡΡΡ ΡΡΡ Π»ΠΎΠΉ ΠΏΠΎΠ΄ΠΊΠΎΠΆΠ½ΠΎΠΉ ΠΊΠ»Π΅ΡΡΠ°ΡΠΊΠΎΠΉ (Π²Π΅ΠΊΠΈ, ΠΌΠΎΡΠΎΠ½ΠΊΠ°), ΡΠ΅ΠΆΠ΅ ΠΊΠ°ΠΊ ΠΎΡΠ»ΠΎΠΆΠ½Π΅Π½ΠΈΠ΅ ΡΠ»Π΅Π³ΠΌΠΎΠ½ΠΎΠ·Π½ΠΎΠΉ Π . Π ΠΎΜΠΆΠ° Π³ΠΎΡΡΠ°ΜΠ½ΠΈ (Π΅. laryngis) β ΡΠΌ. ΠΠ°ΡΠΈΠ½Π³ΠΈΡ ΡΠΎΠΆΠΈΡΡΡΠΉ.Π ΠΎΜΠΆΠ° Π»ΠΎΜΠΆΠ½Π°Ρ (ΡΡΡΠ°Ρ.; Π΅. spurium) β ΡΠΌ. Π ΠΎΠΆΠ° Π²ΡΠΎΡΠΈΡΠ½Π°Ρ.
Π ΠΎΜΠΆΠ° ΠΌΠΈΠ³ΡΠΈΜΡΡΡΡΠ°Ρ (Π΅. migrans; ΡΠΈΠ½. Π . Π±Π»ΡΠΆΠ΄Π°ΡΡΠ°Ρ) β P., ΠΏΡΠΈ ΠΊΠΎΡΠΎΡΠΎΠΉ ΡΡΠΈΡ Π°Π½ΠΈΠ΅ Π²ΠΎΡΠΏΠ°Π»ΠΈΡΠ΅Π»ΡΠ½ΠΎΠ³ΠΎ ΠΏΡΠΎΡΠ΅ΡΡΠ° Π½Π° ΠΏΠ΅ΡΠ²ΠΎΠ½Π°ΡΠ°Π»ΡΠ½ΠΎ ΠΏΠΎΡΠ°ΠΆΠ΅Π½Π½ΠΎΠΌ ΡΡΠ°ΡΡΠΊΠ΅ ΠΊΠΎΠΆΠΈ ΡΠΎΠΏΡΠΎΠ²ΠΎΠΆΠ΄Π°Π΅ΡΡΡ Π΅Π³ΠΎ Π²ΠΎΠ·Π½ΠΈΠΊΠ½ΠΎΠ²Π΅Π½ΠΈΠ΅ΠΌ Π½Π° Π΄ΡΡΠ³ΠΈΡ ΡΡΠ°ΡΡΠΊΠ°Ρ ΠΊΠΎΠΆΠΈ.
Π ΠΎΜΠΆΠ° ΠΏΠ΅ΡΠ²ΠΈΜΡΠ½Π°Ρ (Π΅. primarium) β P., Π²ΠΎΠ·Π½ΠΈΠΊΠ°ΡΡΠ°Ρ ΠΏΡΠΈ ΠΎΡΡΡΡΡΡΠ²ΠΈΠΈ Π² ΠΎΡΠ³Π°Π½ΠΈΠ·ΠΌΠ΅ ΠΎΡΠ°Π³ΠΎΠ² Π³Π½ΠΎΠΉΠ½ΠΎΠ³ΠΎ Π²ΠΎΡΠΏΠ°Π»Π΅Π½ΠΈΡ.
Π ΠΎΜΠΆΠ° ΠΏΠΎΠ»Π·ΡΜΡΠ°Ρ β P., ΠΏΡΠΈ ΠΊΠΎΡΠΎΡΠΎΠΉ Π²ΠΎΡΠΏΠ°Π»ΠΈΡΠ΅Π»ΡΠ½ΡΠΉ ΠΏΡΠΎΡΠ΅ΡΡ ΠΏΠΎΡΡΠ΅ΠΏΠ΅Π½Π½ΠΎ ΡΠ°ΡΠΏΡΠΎΡΡΡΠ°Π½ΡΠ΅ΡΡΡ Π·Π° ΠΏΡΠ΅Π΄Π΅Π»Ρ ΠΏΠ΅ΡΠ²ΠΎΠ½Π°ΡΠ°Π»ΡΠ½ΡΡ Π³ΡΠ°Π½ΠΈΡ ΠΏΠΎΡΠ°ΠΆΠ΅Π½ΠΈΡ ΠΊΠΎΠΆΠΈ.
Π ΠΎΜΠΆΠ° ΠΏΡΠΈΠ²ΡΜΡΠ½Π°Ρ β ΡΠΌ. Π ΠΎΠΆΠ° ΡΠ΅ΡΠΈΠ΄ΠΈΠ²ΠΈΡΡΡΡΠ°Ρ.
Π ΠΎΜΠΆΠ° ΠΏΡΠ·ΡΜΡΡΠ°ΡΠ°Ρ (Π΅. bullosum) β ΡΠΌ. Π ΠΎΠΆΠ° Π±ΡΠ»Π»Π΅Π·Π½Π°Ρ.
Π ΠΎΜΠΆΠ° ΠΏΡΡΡΡΠ»ΡΠ·Π½Π°Ρ (Ρ. pustulosum) β P., ΠΏΡΠΎΡΠ΅ΠΊΠ°ΡΡΠ°Ρ Ρ ΠΎΠ±ΡΠ°Π·ΠΎΠ²Π°Π½ΠΈΠ΅ΠΌ ΡΠΏΠΈΠ΄Π΅ΡΠΌΠ°Π»ΡΠ½ΡΡ ΠΏΡΠ·ΡΡΠ΅ΠΉ, Π½Π°ΠΏΠΎΠ»Π½Π΅Π½Π½ΡΡ Π³Π½ΠΎΠΉΠ½ΡΠΌ ΡΠΎΠ΄Π΅ΡΠΆΠΈΠΌΡΠΌ.
Π ΠΎΜΠΆΠ° ΡΠ΅ΡΠΈΠ΄ΠΈΠ²ΠΈΜΡΡΡΡΠ°Ρ (Π΅. recurrens; ΡΠΈΠ½. Π . ΠΏΡΠΈΠ²ΡΡΠ½Π°Ρ) β P., ΠΏΡΠΎΡΠ΅ΠΊΠ°ΡΡΠ°Ρ Π² Π²ΠΈΠ΄Π΅ ΠΏΠΎΠ²ΡΠΎΡΠ½ΡΡ Π²ΡΠΏΡΡΠ΅ΠΊ Π²ΠΎΡΠΏΠ°Π»ΠΈΡΠ΅Π»ΡΠ½ΠΎΠ³ΠΎ ΠΏΡΠΎΡΠ΅ΡΡΠ°, ΠΎΠ±ΡΡΠ½ΠΎ ΠΎΠ΄Π½ΠΎΠΉ ΠΈ ΡΠΎΠΉ ΠΆΠ΅ Π»ΠΎΠΊΠ°Π»ΠΈΠ·Π°ΡΠΈΠΈ, ΡΡΠΎ ΠΎΠ±ΡΡΠ»ΠΎΠ²Π»Π΅Π½ΠΎ Π½Π°Π»ΠΈΡΠΈΠ΅ΠΌ ΠΎΡΠ°Π³ΠΎΠ² Π΄ΡΠ΅ΠΌΠ»ΡΡΠ΅ΠΉ ΠΈΠ½ΡΠ΅ΠΊΡΠΈΠΈ ΠΈ Π²ΠΎΠ·Π½ΠΈΠΊΠ½ΠΎΠ²Π΅Π½ΠΈΠ΅ΠΌ ΡΠΏΠ΅ΡΠΈΡΠΈΡΠ΅ΡΠΊΠΎΠΉ ΡΠ΅Π½ΡΠΈΠ±ΠΈΠ»ΠΈΠ·Π°ΡΠΈΠΈ ΠΎΡΠ³Π°Π½ΠΈΠ·ΠΌΠ°.
Π ΠΎΜΠΆΠ° ΡΠ»Π΅Π³ΠΌΠΎΠ½ΠΎΜΠ·Π½Π°Ρ (Π΅. phlegmonosum) β P., ΠΏΡΠΎΡΠ΅ΠΊΠ°ΡΡΠ°Ρ Ρ ΡΠ°Π·Π²ΠΈΡΠΈΠ΅ΠΌ ΡΠ»Π΅Π³ΠΌΠΎΠ½Ρ ΠΏΠΎΠ΄ΠΊΠΎΠΆΠ½ΠΎΠΉ ΠΊΠ»Π΅ΡΡΠ°ΡΠΊΠΈ.
Π ΠΎΜΠΆΠ° ΡΡΠΈΡΠ΅ΠΌΠ°ΡΠΎΜΠ·Π½Π°Ρ (Π΅. erythematosum) β P., ΠΏΡΠΈ ΠΊΠΎΡΠΎΡΠΎΠΉ Π½Π°Π±Π»ΡΠ΄Π°ΡΡΡΡ Π³ΠΈΠΏΠ΅ΡΠ΅ΠΌΠΈΡ ΠΈ ΠΎΡΠ΅ΡΠ½ΠΎΡΡΡ ΠΊΠΎΠΆΠΈ; ΠΎΠ±ΡΡΠ½ΠΎ β Π½Π°ΡΠ°Π»ΡΠ½Π°Ρ ΡΡΠ°Π΄ΠΈΡ ΡΠ°Π·Π²ΠΈΡΠΈΡ Π .dic.academic.ru